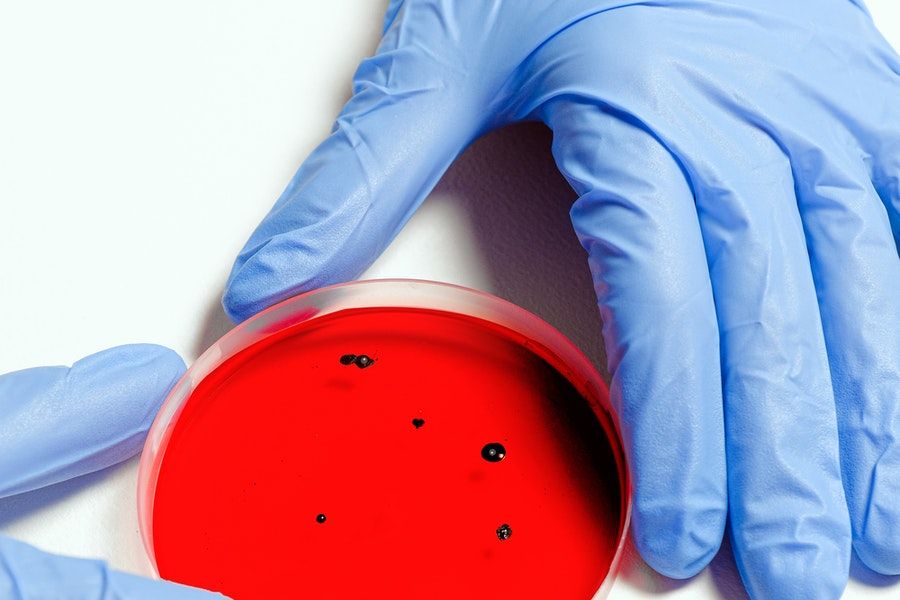

Blogs & Nieuws

Op weg naar een behandeling op maat voor vrouwen met eierstokkanker
januari 11, 2023
Eindhoven, 11 januari 2023 | Om de behandeling van kanker te verbeteren, is het belangrijk om te begrijpen hoe tumoren ontstaan. Onderzoekster Phyllis van der Ploeg heeft in het Catharina Ziekenhuis onderzoek gedaan naar de processen achter het ontstaan van eierstokkanker. Een vorm van kanker waarvan de overlevingskansen de afgelopen dertig jaar nauwelijks zijn verbeterd. […]

Nu maatregelen nodig zodat wetenschappers paraat staan voor volgende pandemie
januari 9, 2023
Om goed voorbereid te zijn op toekomstige grootschalige infectieziektenuitbraken moeten Nederlandse wetenschappers beter samenwerken, binnen en buiten hun eigen vakgebied. Ook moeten ze onderzoeksgegevens vaker met elkaar delen. De Koninklijke Nederlandse Akademie van Wetenschappen (KNAW) stelt in een nieuw advies dat beleidsmakers en kennisinstellingen een belangrijke taak hebben om dit mogelijk te maken. Door nu […]

31 maart – Care.Connect & Basketbal
januari 7, 2023
31 maart – Care.Connect & Basketbal Op vrijdag 31 maart 2023 vindt het tweede Care.Connect event plaats. Deze keer wordt het netwerken gecombineerd met de sport basketbal. Datum: 31 maart 2023 Tijd: 14.30 – 18.00 uur Locatie: Rotterdam Registreren kan hier!

Rotterdams eHealth Ontbijt – 16 februari 2023
januari 7, 2023
Rotterdams eHealth Ontbijt – 16 februari 2023 Datum: Donderdag 16 februari 2023 Tijd plenaire sessie: 08.00 – 09.30 Locatie: Rotterdam Na afloop vindt er een eHealth Festival plaats en kunt u deelnemen aan de eHealth Safari. Registratie: opent binnenkort

Innovation for Health – 6 april
januari 7, 2023
Innovation for Health – 6 april Op 6 april 2023 vindt de 10e editie van Innovation for Health – het toonaangevende congres voor key players in Health & Life Sciences in Nederland – weer plaats in Rotterdam.Rotterdam Square is uiteraard ook aanwezig en organiseert – samen met Life Sciences & Health 010 en het Erasmus […]

Ontmoet de koplopers van de volgende economie – 23-25 mei 2023
januari 7, 2023
Ontmoet de koplopers van de volgende economie – 23-25 mei 2023 In 2023 transformeert de Metropoolregio Rotterdam opnieuw tot dé plek waar startups, scale-ups, investeerders, doortastende bedrijven, beleidsmakers en studenten samenkomen om een positieve impact te maken in de wereld.Upstream biedt toegang tot kapitaal, nieuwe markten en talent voor ondernemers die hun bedrijf willen opschalen. […]

Rotterdam Square zomer borrel – 22 juni 2023
januari 7, 2023
Rotterdam Square zomer borrel– 22 Juni 2023 Datum: 22 juni 2023 Tijd: 16.00 – 18.00 uur Bron: Rotterdam Square

Kick off Rotterdam Square – 22 maart 2023
januari 7, 2023
Kick off Rotterdam Square – 22 maart 2023 Save the date: 22 maart 2023 Locatie: Erasmus MC Tijd: 11.00 – 12.30 uur Bron: Rotterdam Square

Alle medisch specialisten ETZ verenigd in nieuwe Coöperatie
januari 4, 2023
De VMS*, de VMSD*, het TSB* en het MSB* gaan vanaf 1 januari 2023 samen op in de Coöperatie Medisch Specialisten Midden-Brabant, kortweg CMS M-B. Alle vrijgevestigde specialisten en alle specialisten in dienstverband van het ETZ (Elisabeth-TweeSteden Ziekenhuis) integreren in de CMS M-B.

Horrornacht: inmiddels al 17 slachtoffers met oogletsel door vuurwerk
januari 4, 2023
Inmiddels zijn er 25 patiënten bij Het Oogziekenhuis binnengekomen. 5 patiënten zijn jonger dan 17 jaar. 20 volwassen patiënten. Inmiddels is één oog volledig blind. Dit oog was dusdanig beschadigd dat het helemaal verwijderd moest worden. Bij 7 patiënten was het letsel dusdanig ernstig dat zij geopereerd zijn.

GEVAARLIJKE VUURWERKTRADITIE MOET NU ECHT ANDERS
januari 2, 2023
Na wederom een Oud & Nieuw met een tsunami aan letsels en geweld tegen burgers en hulpverleners door legaal en illegaal vuurwerk, is het volgens het Vuurwerkmanifest nú echt tijd voor een algeheel vuurwerkverbod. Het Vuurwerkmanifest roept de Tweede Kamer op zo snel mogelijk te stemmen over het wetsvoorstel dat oproept tot een vuurwerkverbod. Alleen dan kan de politie effectief handhaven en zullen – net als tijdens de twee vorige jaarwisselingen mét een vuurwerkverbod voor particulieren – veel minder burgers letsel oplopen door vuurwerk.

Twee nieuwe topklinische zorgfuncties voor VieCuri
januari 2, 2023
VieCuri heeft haar basis als topklinisch ziekenhuis verder verstevigd. Afgelopen week zijn maar liefst twee nieuwe zorgfuncties als topklinisch beoordeeld door STZ (Samenwerkende Topklinische opleidingsZiekenhuizen). Dit betreft het Expertisecentrum mammareconstructies en het Bovenregionaal wervelkolomcentrum Noord- en Midden-Limburg.

Nieuwjaars borrel (K)LINKT
januari 2, 2023
Kom maandag 23 januari 2023 ook naar de Rotterdam Science Tower. dan organiseren we onze nieuwjaarsborrel: de (k)LINKT. Sinds twee jaar weer eindelijk live! Het begint van af 17.00 uur. Ben jij er bij?

Populair vers kinderfruit gevaarlijk vervuild, handhaving blijft uit
december 22, 2022
De overheid wil ‘nagenoeg geen residuen’ van pesticiden op land- en tuinbouwproducten, maar dat schiet niet op bij fruit. Uit cijfers van de NVWA over 2021 blijkt dat 9 van de 10 geteste fruitproducten bestrijdingsmiddelen bevatten: gemiddeld maar liefst 4 residuen per product. Van de soorten vers fruit die door kinderen het meeste worden gegeten in Nederland komen mandarijnen en sinaasappelen in 2021 het slechtste uit de bus. Er is door de NVWA geen enkele keer opgetreden bij acute gezondheidsrisico’s bij appelen, sinaasappelen en tafeldruiven. Het fruit is niet uit de handel gehaald. Ook zijn er verboden middelen gevonden op appelen en peren van Nederlandse bodem, zonder opvolging om vast te stellen of het daadwerkelijk om illegaal gebruik ging. Deze resultaten komen uit het nieuwe onderzoek van voedselwaakhond Foodwatch, die elk jaar de residu-cijfers van groente en fruit van de NVWA analyseert.

Eerste rookvrije tramhalte van Rotterdam
december 22, 2022
Op woensdag 14 december opende wethouder Achbar de eerste rookvrije tramhalte van Rotterdam. Samen met RET directeur Maurice Unck, Bianca Buijck van Rotterdam Stroke Service en kinderarts Jasper Been (Erasmus MC) plaatste hij een ‘Rookvrije Generatie tegel’ bij de halte Museumpark. Met de tegel wordt aandacht gevraagd voor het belang van een rookvrije omgeving voor toekomstige generaties.

40 miljoen voor technologische innovaties gericht op maatschappelijke uitdagingen
december 22, 2022
Negen consortia van onderzoekers, bedrijven, overheden en maatschappelijke organisaties gaan met een budget van bijna 40 miljoen euro werken aan technologische innovaties, gericht op urgente maatschappelijke uitdagingen. De Perspectief-programma’s gaan onder andere aan de slag met effectievere behandelingen tegen kanker, het verbeteren van optische eigenschappen van hightech apparatuur en slimmere vormen van mobiliteit in steden.

World Health Organization
december 22, 2022
The World Health Organization announced that Dr Jeremy Farrar will become its new Chief Scientist. Currently, Director of the Wellcome Trust, Dr Farrar will join WHO in the second quarter of 2023.

Slimme software voorspelt cognitieve problemen bij patiënten
december 22, 2022
Vaatschade aan de witte stof in de hersenen kan voor allerlei problemen zorgen, bijvoorbeeld in de taal of het geheugen van mensen. Onderzoekers van het UMC Utrecht hebben slimme software ontwikkeld die aan de hand van hersenscans van dit soort schade kan voorspellen met welke problemen patiënten te maken gaan krijgen. Het model is in eerste instantie vooral bruikbaar voor patiënten die op de geheugenpoli komen, en die dus vaak al klachten hebben. Later hopen de onderzoekers de software ook toe te kunnen passen op mensen die nog nergens last van hebben.

Chemotherapie thuis’ van start
december 22, 2022
In het IJsselland Ziekenhuis is op 8 december het project ‘Chemotherapie thuis’ van start gegaan. Dit project heeft als doel om patiënten thuis met chemotherapie te behandelen indien dit wenselijk is en bijdraagt aan betere zorg op maat. Het project sluit hiermee aan op een van de strategische doelstellingen van het ziekenhuis, namelijk “Zorg dichtbij als het kan, in het ziekenhuis als het moet”.

Afspraak via videoconsult? Oefen met ons!
december 22, 2022
Videoconsult is niet meer weg te denken uit de zorg. Bij videoconsult belt de patiënt met beeld, via een eigen computer/laptop/smartphone of tablet met de zorgverlener. Met videoconsult kunnen we onze patiënten zorg en advies dichtbij huis bieden, mits dit aansluit bij de zorgvraag en de situatie van de patiënt. Met een videoconsult is er persoonlijk contact met de zorgverlener, maar dan gewoon vanuit de eigen vertrouwde omgeving. Als Noordwest begrijpen wij dat videoconsult lastig kan zijn voor patiënten die niet veel met een computer of laptop werken. Zij kunnen vanaf nu een videoconsult oefenen met medewerkers van onze patiëntenservice.

Zorgverzekeraars en Ikazia Ziekenhuis bereiken akkoord op herstelplan
december 22, 2022
De vijf grootste zorgverzekeraars hebben aangegeven dat het herstelplan van het Ikazia Ziekenhuis er goed uitziet. Daarom is er een akkoord met elkaar bereikt. Dit betekent dat het Ikazia Ziekenhuis de komende jaren verzekerd is van voldoende financiële steun. Daarmee krijgt het ziekenhuis weer een positief toekomstscenario als belangrijke zorgpartner in Rotterdam.

Ziekenhuis Rivierenland opnieuw geslaagd voor JCI, keurmerk voor kwaliteit en veiligheid
december 22, 2022
Na een uitvoerige en kritisch onderzoek van 3 auditoren heeft Ziekenhuis Rivierenland opnieuw het hoogst haalbare internationale kwaliteitskeurmerk voor ziekenhuizen gekregen. Een fantastisch resultaat en compliment voor de continue aandacht die er is voor het verbeteren van de kwaliteit en veiligheid van zorg voor onze patiënten en de werksituatie van de medewerkers.

Rozijnen zwaarder dan ooit vervuild met landbouwgif
december 8, 2022
Rozijnen blijken nog zwaarder besmet met pesticiden dan in voorgaande jaren. Er zijn zelfs veelvuldig sporen van illegale middelen aangetroffen. Ondanks gezondheidsrisico’s voor consumenten is er niet opgetreden door de NVWA. Dat blijkt uit nieuw onderzoek van voedselwaakhond Foodwatch die jaarlijks de controlecijfers van de Nederlandse Voedsel- en Warenautoriteit (NVWA) heeft opgevraagd. “Het zijn schrikbarende resultaten die heel duidelijk maken dat er rigoureuze ingrepen nodig zijn om ons voedsel veilig en eerlijk te maken. Supermarkten en overheden moeten nu eindelijk eens hun verantwoordelijkheid nemen”, aldus campaigner Anke Bakker van Foodwatch.

Blue Light Ride: blauw verlichte stoet voertuigen brengt bezoek aan zorginstellingen
december 8, 2022
Ziek zijn heeft een enorme impact op iemand zijn leven. Om mensen die zorg nodig hebben in de donkere dagen voor kerst letterlijk in het licht te zetten, wordt de Blue Light Ride georganiseerd. Op woensdag 14 december 2022 start een groot aantal hulpverleningsvoertuigen in Horst. Onderweg passeert men verschillende zorginstellingen om de bewoners te laten genieten van de blauw verlichte stoet. Via Horst, Sevenum en Maasbree rijdt men naar het eindpunt: ziekenhuis VieCuri. Een groot aantal voertuigen neemt deel. Denk aan de ambulance, politie, brandweer, ProRail, het Rode Kruis en Rijkswaterstaat. Allemaal voertuigen met blauw zwaailicht, die niets liever willen dan mensen die ziek zijn dat even te laten vergeten.

Hartchirurg Verberkmoes ontwikkelt nieuwe eenvoudigere techniek voor complexe hartoperatie
december 7, 2022
Hartchirurg Niels Verberkmoes van het Catharina Hart- en Vaatcentrum heeft een bestaande openhartoperatie doorontwikkeld naar een eenvoudige kijkoperatie. Daardoor is het voor meer hartchirurgen mogelijk om deze operatie veilig en in kortere tijd uit te voeren. Bovendien komen door de technische aanpassingen en de vereenvoudiging van de oorspronkelijke techniek meer patiënten in aanmerking voor deze behandeling. Verberkmoes promoveert op vrijdag 9 december aan de Technische Universiteit Eindhoven onder meer op deze nieuwe techniek.

Financiering rond voor investeringen VieCuri Venlo en Venray
december 6, 2022
VieCuri Medisch Centrum heeft een lening van €160 miljoen afgesloten met de Europese Investeringsbank (EIB), de Rabobank en het Waarborgfonds voor de Zorgsector (WfZ). De financiering ondersteunt een groot investeringsplan van VieCuri. Dat bevat onder meer de vernieuwing en uitbreiding van het OK-complex en de Medische Beeldvorming in Venlo, de nieuwbouw in Venray, investeringen op het gebied van duurzaamheid en ICT-vernieuwingen die nodig zijn, bijvoorbeeld op het gebied van het elektronisch patiënten dossier.

Minister Kuipers opent kinder MRI OK UMC Utrecht en Màxima
december 6, 2022
Tijdens een feestelijke opening door minister Ernst Kuipers van Volksgezondheid, Welzijn en Sport is de intra-operatieve MRI operatiekamer in het Wilhelmina Kinderziekenhuis (WKZ) officieel in gebruik genomen. De IO MRI-OK is een samenwerking tussen het UMC Utrecht en het Prinses Máxima Centrum voor kinderoncologie. Het UMC Utrecht is het enige ziekenhuis in Nederland met deze combinatie van MRI en OK, die vooral gebruikt zal worden voor het opereren van hersentumoren bij kinderen.

Lenn & Leyla zorgen voor kindvriendelijke en ontspannen sfeer in LangeLand Ziekenhuis
december 5, 2022
Jonge patiëntjes van het LangeLand Ziekenhuis lanceerden vandaag Lenn & Leyla op de kinderafdeling van het ziekenhuis. In het bijzijn van wethouder zorg & welzijn Ingeborg ter Laak en directeur bedrijfsvoering Toine Hazen knipten zij het lint door waarna ze kennismaakten met de kindermascottes. Lenn & Layla zijn speciaal voor het ziekenhuis ontworpen personages. Ze helpen om stress en angst te verlagen bij kinderen die het ziekenhuis bezoeken en creëren een veilig hechtingsklimaat voor kind en ouder.

Klachten in de mond niet altijd herkend als probleem
december 5, 2022
Ouderen en mantelzorgers zijn zich veelal bewust van het belang van dagelijkse mondverzorging en een goede mondgezondheid, maar het lukt ze minder goed hun weg te vinden bij problemen met de mondgezondheid. Om in deze informatiebehoefte te voorzien bundelt de Stichting De Mond Niet Vergeten! daarom alle informatie rondom mondproblemen en mondverzorging bij kwetsbare ouderen op de vernieuwde website demondnietvergeten.nl. Een verzamelplaats van informatie, preventiemogelijkheden, video’s, instructies en ervaringsverhalen.

Nieuwe hoogleraar Catharina Ziekenhuis: ‘Slimme camera’s en pleisters zijn oplossingen voor de uitdagingen in de zorg’
december 5, 2022
Anesthesioloog dr. Arthur Bouwman is benoemd tot hoogleraar aan de Technische Universiteit Eindhoven (TU/e). Zijn leerstoel is ‘peri-operatieve patiëntbewaking en klinische beslissingsondersteuning’. Bouwman is de 16e hoogleraar in het Catharina Ziekenhuis.

Eerste operatie in ETZ met robot Hugo
december 2, 2022
“Spannend”, vond ETZ-gynaecoloog Petra Janssen de eerste ingreep met operatierobot Hugo in de OK van het Elisabeth-TweeSteden Ziekenhuis (ETZ) in Tilburg. Ze kende de operatierobot uiteraard al van de intensieve trainingen die zij en haar collega’s de maanden daarvoor hadden gevolgd. “Het was fijn om nu eindelijk alle vaardigheden in de praktijk te kunnen toepassen. De operatie ging heel goed, ik ben enthousiast over de mogelijkheden die Hugo biedt.”

Noordwest en HKN ondertekenen samenwerking overeenkomst voor spoedplein
november 30, 2022
Op 21 november 2022 ondertekenden Noordwest Ziekenhuisgroep en Huisartsenorganisatie Kop van Noord-Holland (HKN) een samenwerkingsovereenkomst. Een belangrijke stap voor de realisatie van het spoedplein in Den Helder, dat in het voorjaar van 2023 zijn deuren opent. Met het spoedplein geven Noordwest en HKN invulling aan de ambitie voor een geïntegreerde aanpak van de spoedzorg in de Kop van Noord-Holland.

Helm verplicht op snorfiets na landelijke studie van Alexander Leijdesdorff
november 30, 2022
Alexander Leijdesdorff verdedigt op 24 november zijn promotieonderzoek naar slachtoffers van verkeersongevallen. De traumachirurg van HMC analyseerde in zijn proefschrift verschillende soorten verkeersslachtoffers in Nederland, in het bijzonder patiënten die een levensbedreigend ongeval hebben meegemaakt. “Als jonge motorrijders en oudere snorfietsers in het ziekenhuis belanden hebben zij een hoge kans op ernstig letsel én overlijden.”

Impuls voor fase 1 onderzoek van nieuwe geneesmiddelen in UMC Utrecht
november 30, 2022
In het UMC Utrecht komt een voorziening voor fase 1 onderzoek naar geneesmiddelen bij mensen. Hier wordt een nieuw geneesmiddel voor het eerst toegediend aan (gezonde) mensen. Met deze nieuwe door U-TRIAL geleide Fase 1 Unit krijgt het vroege fase onderzoek binnen de 6 onderzoekspeerpunten van het UMC Utrecht een enorme impuls. Daarmee kan het UMC Utrecht voorzien in het volledige onderzoekstraject voor nieuwe geneesmiddelen. UMC Utrecht wordt zo aantrekkelijker voor vervolgonderzoek waarbij het geneesmiddel ook bij patiënten onderzocht wordt.

Resultaten Covid-onderzoek over reuk bekend
november 30, 2022
Tijdens de coronapandemie merkten steeds meer mensen dat zij minder goed of helemaal niet meer konden ruiken of proeven na een besmetting met het virus. Daarom startten onderzoekers van verschillende universiteiten en ziekenhuizen vorig jaar een grootschalig onderzoek naar reuk- en smaakverlies als gevolg van COVID-19. Deze week werden de eerste resultaten gepubliceerd in BMC Medicine.

Ikazia organiseert Opleidingen- en Beroepenmarkt
november 24, 2022
Voor het eerst sinds corona organiseert het Ikazia Ziekenhuis, op donderdag 24 november a.s., weer een opleidingen- en beroepenmarkt. Van 15.00 uur tot 18.30 uur komen geïnteresseerden meer te weten over het werken in de zorg en leren zij Ikazia als opleider en werkgever kennen.

Geclusterde, zorg geschikte woningen sleutel naar beschikbare zorg
november 24, 2022
Corporaties verwachten een tekort aan zorggeschikte woningen. Hoewel acht op de tien corporaties het aantal zorggeschikte woningen in de komende vijf jaar wil laten stijgen, is betere samenwerking nodig om ook daadwerkelijk tot realisatie te komen. Naast de financiële tekorten op dit type woningen zien corporaties vooral een gebrek aan (vastgoed)visie en sturing bij gemeenten en zorginstellingen als risico. Dit blijkt uit de resultaten van het onderzoek ‘Wonen en zorg bij woningcorporaties. Een onderzoek naar visie, voorkeuren en de stand van samenwerking met zorginstellingen’.

Betere zorg en meer flexibiliteit met nieuwe GE-patiënt bewakingsapparatuur in CWZ
november 24, 2022
Het Canisius Wilhelmina Ziekenhuis (CWZ) in Nijmegen en GE Healthcare gaan intensief samenwerken in het testen, toepassen en invoeren van nieuwe bewakingsapparatuur op basis van slimme technologie om de vitale waarden van patiënten te monitoren. Patiënten in het ziekenhuis krijgen hierdoor meer vrijheid en flexibiliteit, omdat de apparatuur voortaan eenmalig, met minder kabels en plakkers, op de patiënt wordt aangesloten. Voor zorgverleners werkt dit efficiënter en sneller. In 2023 voeren GE en CWZ bovendien een proef uit met mobiele bewakingsapparatuur in het ziekenhuis.

Ruim 18 miljoen voor extra energiebesparende maatregelen voor Rotterdamse minima
november 24, 2022
Steeds meer Rotterdammers kampen met hoge energierekeningen door de stijgende energieprijzen. Om huurders en woningeigenaren met een laag inkomen tegemoet te komen biedt de gemeente extra maatregelen gericht op het energiezuiniger maken van hun woning. Hiervoor is 18,6 miljoen euro Rijksgeld beschikbaar.

Noordwest, huisartsen en de bibliotheken slaan ‘handen ineen’
november 24, 2022
De digitale ontwikkelingen in de zorg gaan razendsnel en dat kan best ingewikkeld zijn voor patiënten. Als Noordwest vinden wij het belangrijk hier oog voor te hebben en onze patiënten daarbij te ondersteunen. Daarom hebben Noordwest, de huisartsenverenigingen HONK en HKN en de Bibliotheek Kennemerwaard en KopGroep Bibliotheken de handen ineen geslagen. Zij gaan nauw samenwerken voor ondersteuning van patiënten bij digitale zorg. Naast onze eigen patiëntenservice, is deze samenwerking een mooie uitbreiding van service voor digitale ondersteuning.

UMC Utrecht bestraalt eerste patiënten op locatie bij St. Antonius Utrecht
november 24, 2022
Het UMC Utrecht heeft een nieuwe behandellocatie voor het bestralen van patiënten bij het St. Antonius Ziekenhuis in Utrecht. Vandaag werd Cees Peek als allereerste patiënt bestraald. ‘Ik ben het proefkonijn’, zegt hij lachend. Hij is lovend over de nieuwe locatie. ‘Het is schoon en steriel met moderne apparaten. En ook hier zijn de laboranten geweldig’.

DE TOEKOMST VAN FOOD & TECHNOLOGY: 1 DECEMBER 2022
november 23, 2022
Dat gepersonaliseerd voeding en een gezonde levensstijl de druk op de zorg kunnen verlagen en gezonde jaren opleveren is aangetoond; maar hoe kunnen we een daadwerkelijke gedragsverandering in gang zetten. Hoe kunnen we met food & technology gaan versnellen en opschalen? En wat zijn de huidige mogelijkheden en nieuwste ontwikkelingen?

SCIENCE, EDUCATION AND INNOVATION FESTIVAL
november 23, 2022
On December the 8th the annual Science, Education and Innovation festival will take place. The festival provides an open platform to celebrate and share projects and achievements with the community, and to co-create solutions to sustain the future of healthcare. The Festival will take place on Thursday 8 December at the iconic Van Nelle Fabriek in Rotterdam (11:30 – 18:00, plenary programme from 12:30).

ETZ-kinderarts Jan Erik Bunt 11 uur in couveuse
november 23, 2022
Kinderarts-neonatoloog dr. Jan Erik Bunt van het ETZ gaat de landelijke Couveuse Challenge aan. Hij stapt donderdagochtend 17 november om 06.00 uur in de couveuse en blijft daar tot 17.15 uur in liggen. Dat alles is voor iedereen te zien in de hoofdgang van ETZ Elisabeth (Hilvarenbeekseweg 60 in Tilburg).

Kinderen met een aangeboren hartafwijking nóg beter kunnen behandelen dankzij nieuwe 3D-apparatuur
november 23, 2022
11 jaar na de eerste 3D hartkatheterisatie in het Wilhelmina Kinderziekenhuis van het UMC Utrecht is daar deze week het nieuwe, meest moderne katheterisatietoestel in gebruik genomen. Met hogere beeldkwaliteit, verbeterde 3D mogelijkheden en minder straling kunnen de specialisten van het kinderhartcentrum het hart nog beter in kaart brengen en behandelen. Dat betekent minder belasting voor de patiënt. Het Wilhelmina Kinderziekenhuis is hiermee het enige medisch centrum in Nederland waar 3D-opnamen worden gemaakt van kinderen met een aangeboren hartafwijking.

LSH010 ONTBIJT: DONDERDAG 1 DECEMBER 2022
november 23, 2022
Op donderdagochtend 1 december zijn we met het LSH010 innovatieontbijt te gast tijdens het Immersive Tech Week 2022 in De Doelen! Het thema van deze ochtend: The Amazing Possibilities of the Metaverse.

Voor baby’s met RS-virusinfectie is een oplossing nabij
november 22, 2022
Eén op de 56 gezonde, voldragen baby’s in Europa wordt in het ziekenhuis opgenomen vanwege een infectie met het Respiratoir Syncytieel Virus (RSV), zo blijkt uit een nieuwe studie onder leiding van Prof. Dr. Louis Bont van het UMC Utrecht. Dit onderzoek is gepubliceerd in het vooraanstaande wetenschappelijke blad The Lancet Respiratory Medicine. Een eerste vaccin tegen RSV is door de Europese Unie op 4 november goedgekeurd en diverse vaccins zijn in ontwikkeling; een oplossing voor baby’s met RSV is nabij.

Laat je bloedsuiker meten via een vingerprik
november 22, 2022
Maandag 14 november was het Wereld Diabetes Dag. Veel mensen weten niet dat zij diabetes (suikerziekte) hebben. Daarom kon iedereen op deze dag tussen 10.00 en 15.30 uur via een vingerprik zijn bloedsuiker laten meten in de centrale hal op locatie Elisabeth (Hilvarenbeekseweg 60) van het ETZ (Elisabeth-TweeSteden Ziekenhuis).

3 miljoen voor 46 innovatieve Rotterdamse plannen
november 21, 2022
De gemeente Rotterdam steunt met CityLab010 Rotterdamse initiatiefnemers met een vernieuwend plan voor de stad. Dit jaar alweer voor de achtste keer. Er zijn ruim 275 plannen aangemeld, waarvan er 127 na een coachingtraject een aanvraag hebben ingediend. Daarvan zijn uiteindelijk 46 initiatieven door de onafhankelijke Stadsjury van CityLab010 uitgekozen. Deze plannenmakers ontvangen bij elkaar een startbudget van ruim €3 miljoen.

Betere controle van HIV-behandeling met beperkte middelen
november 18, 2022
Wanneer een HIV-behandeling niet meer werkt (therapiefalen) is dat een bedreiging voor de gezondheid van mensen met HIV, vooral onder omstandigheden waar weinig middelen voorhanden zijn. Initiatieven om therapiefalen te verminderen, zoals strengere afkapwaarden voor onderdrukking van het HIV-virus, betere klinische begeleiding en betere controle van de HIV-behandeling kunnen therapiefalen sterk verminderen. Dit zijn de belangrijkste conclusies van Lucas Hermans van UMC Utrecht in zijn proefschrift dat hij op 15 november 2022 zal verdedigen.

Wetenschaps communicatie: volwaardig onderdeel van academisch takenpakket
november 9, 2022
Voor veel wetenschappers is wetenschapscommunicatie iets dat ze ‘erbij’ moeten doen. Terwijl verbinding met de samenleving steeds belangrijker wordt, heeft deze taak nog geen volwaardige plaats binnen een academisch takenpakket. Binnen het programma Wetenschapscommunicatie door wetenschappers: Gewaardeerd! zijn behoeften en belemmeringen van wetenschappers op dit vlak geïnventariseerd en is een handreiking samengesteld. Deze handreiking, met concrete aanbevelingen voor kennisinstellingen, werd vandaag aangeboden aan minister Dijkgraaf van OCW.

Onderzoek werking psilocybine in New England Journal of Medicine
november 3, 2022
Op donderdag 3 november is onderzoek naar de werking van psilocybine, de werkzame stof in sommige paddenstoelen en truffels gepubliceerd in het gezaghebbende tijdschrift ‘the New England Journal of Medicine’. Uit dit onderzoek blijkt dat psilocybine therapie met psychologische ondersteuning kan helpen bij behandelingsresistente depressie. Het UMC Utrecht is één van de instellingen die de experimentele behandelingen samen met het Britse bedrijf Compass Pathways uitvoerde binnen deze internationale fase 2b-studie. In deze fase van onderzoek is gekeken naar de werkzaamheid en veiligheid van het geneesmiddel. Ook het UMC Groningen en het LUMC deden aan het onderzoek mee.

ETZ opent expositie met textiel in hoofdrol
november 1, 2022
Op vrijdag 4 november 2022 opent de kunstcommissie van het ETZ (Elisabeth-TweeSteden Ziekenhuis) de kunstexpositie: ‘Bij hoofdpijn, neem een samba’. Kunstenaars Sangmin Oh, Sanne Bax en Phlox van Oppen presenteren die dag om 15.30 uur hun textielcreaties in het Leanplein (route 74) op locatie ETZ Elisabeth, Hilvarenbeekseweg 60. De werken zijn tot en met 24 februari 2023 in de Piet Hein Eek-vitrines in de centrale hal te bewonderen.

Het SKB nodigt patiënten uit de gratis app BeterDichtbij te gebruiken voor makkelijk en veilig digitaal contact
november 1, 2022
Het Streekziekenhuis Koningin Beatrix (SKB) biedt zorg zo dichtbij mogelijk. Thuis als het kan, in het ziekenhuis als het moet. Daarom nodigt het ziekenhuis vanaf 1 november 2022 alle patiënten, die onder behandeling zijn bij een polikliniek, uit om de gratis app BeterDichtbij te gebruiken. Via BeterDichtbij kunnen patiënten bijvoorbeeld een vraag stellen of beeldbellen met hun zorgverlener. “Dankzij BeterDichtbij kunnen we onze vertrouwde, regionale zorg ook digitaal aanbieden. Dat is heel belangrijk, omdat wij hierdoor nóg dichter bij onze patiënten zijn. Op het moment dat het hen uitkomt. Zo wordt veilig digitaal contact met het ziekenhuis nóg makkelijker”, vertelt Inge de Wit, bestuurder van Streekziekenhuis Koningin B

Start campagne ‘Oordeel niet’
oktober 31, 2022
Met sexting is niks mis. Met ‘shamen’ wel! Op 31 oktober start de gemeente Rotterdam in samenwerking met het Centrum Seksueel Geweld (CSG) regio Rotterdam met Oordeel niet, een campagne tegen online shaming en victim blaming. De campagne verschijnt op social media, in de stad en op scholen. Om jongeren die slachtoffer worden te steunen en hen de route naar hulp te tonen. Maar vooral om andere jongeren, en ook ouders en professionals, bewust te maken van hun rollen bij het delen én (ver)oordelen.

Populaire prostaatkanker check nu ook in Nederland
oktober 31, 2022
Mannen praten niet graag over gezondheidsklachten en al helemaal niet over hun prostaat. ‘Ik voel me prima dus er is niets aan de hand’, maar dat geldt helaas niet voor prostaatkanker. ‘Een beginnende prostaatkanker kan je zelf niet herkennen’, vertelt dr. Paul Kil, medisch directeur en uroloog bij Andros Clinics. ‘Daarom is het van belang dat mannen laagdrempelig kunnen ontdekken welke risico’s er voor hen zijn. In Groot Brittannië konden mannen al online een risicocheck doen. Deze check is nu ook beschikbaar voor de Nederlandse man.’

Catharina Ziekenhuis boekt aanzienlijke tijdwinst voor patiënten met een beroerte
oktober 31, 2022
Als mensen een beroerte krijgen, telt elke seconde. Medisch specialisten moeten zo snel mogelijk weten of het gaat om een herseninfarct of een hersenbloeding. Wanneer die diagnose helder is, kan worden gestart met de juiste behandeling.

Eeuwenoud geneesmiddel uit herfsttijloos voorkomt nieuwe hartinfarcten
oktober 28, 2022
Het slikken van een goedkoop, eeuwenoud geneesmiddel is een goede manier om een nieuw hartinfarct te voorkomen. Dat blijkt uit onderzoek van de Alkmaarse cardioloog in opleiding Tjerk Opstal. Hij won hiermee de Pieter van Foreestprijs van 2022.

40% van de zorginstellingen verwacht negatief resultaat voor 2022
oktober 21, 2022
Het vertrouwen in het toekomstig financieel resultaat in de zorg heeft als gevolg van recente macro-economische ontwikkelingen een nieuw dieptepunt bereikt. 40% van de zorgfinancials verwacht voor 2022 een negatief resultaat te rapporteren. Voor een deel van de instellingen leidt dit naar verwachting tot een breach van de convenanten. Daarnaast verwacht een meerderheid dat broodnodige investeringen verder worden uitgesteld of in versoberde vorm doorgang vinden. Dit blijkt uit resultaten van de Financiële Zorgthermometer die is uitgestuurd naar ongeveer 800 zorgfinancials.

Belangen voedselindustrie wegen zwaarder dan consumentenbescherming
oktober 20, 2022
Uit onderzoek blijkt dat consumenten in Nederland onvoldoende worden beschermd tegen de negatieve invloed van reclames voor voedingsmiddelen. Voedselwaakhond Foodwatch presenteert hierover een nieuw rapport dat is uitgevoerd door onderzoeksbureau Panteia. Het rapport ‘Regulering van reclame voor voedingsmiddelen’ concludeert dat door de scheve verhoudingen binnen de Stichting Reclame Code de belangen van de industrie zwaarder wegen dan die van de consument. Consumenten worden hierdoor maar beperkt beschermd tegen de gevolgen van blootstelling aan reclames voor (ongezonde) voedingsmiddelen.

Opening fysiek punt in ziekenhuis en Bibliotheek ETZ en Bibliotheek Midden-Brabant maken patiënt digivaardig
oktober 20, 2022
Het ETZ (Elisabeth-TweeSteden Ziekenhuis) en de Bibliotheek Midden-Brabant bundelen hun krachten om patiënten van het ETZ digitaal vaardiger te maken. Op fysieke punten in het ziekenhuis en de Bibliotheek LocHal kunnen patiënten van het ETZ terecht met vragen over patiëntportaal MijnETZ en digitale patiëntfolders. Het betreft een pilot die tot eind december loopt.

Noordwest werkt de komende jaren samen met Defensie
oktober 18, 2022
Noordwest Ziekenhuisgroep gaat de komende jaren samenwerken met het ministerie van Defensie. Dit betekent concreet dat militair medisch personeel van Defensie bij Noordwest komt werken als zij niet op uitzending zijn. Als tegenprestatie levert Noordwest medische professionals aan Defensie die worden opgeleid tot reservist. Noordwest pakt hiermee haar maatschappelijke verantwoordelijkheid als topklinisch ziekenhuis en biedt op deze manier de betrokken medewerkers professionele verbreding van hun vak. Ook past de samenwerking bij de lange historie die wij al hebben met de Koninklijke Marine in Den Helder. Het officiële tekenmoment tussen Noordwest/MSNW en Defensie vond maandag 17 oktober jl. plaats.

Henrietta Lacks’ family appointed World Health Organization Goodwill Ambassadors for Cervical Cancer Elimination
oktober 17, 2022
WHO’s Director-General Dr Tedros Adhanom Ghebreyesus today appointed the Lacks family as WHO Goodwill Ambassadors for Cervical Cancer Elimination. The appointment recognizes their efforts to champion cervical cancer prevention and to preserve the memory of Henrietta Lacks, who died from cervical cancer in 1951.

Nationaal Vergiftigingen Informatie Centrum van het UMC Utrecht: Pas op met paddenstoelen
oktober 14, 2022
Het is weer paddenstoelentijd. Dat levert niet alleen fraaie beelden op, maar is voor menigeen ook aanleiding ze te plukken en te eten. Dat kan gevaarlijk zijn: sommige zijn giftig en veroorzaken lichamelijke klachten en in het uiterste geval de dood. “Pluk en eet daarom geen paddenstoelen als je er onvoldoende verstand van hebt”, adviseert Henneke Mulder-Spijkerboer van het Nationaal Vergiftigingen Informatie Centrum (NVIC)

Het Oogziekenhuis Rotterdam implanteert voor het eerst in Nederland chip in oog van bijna blinde patiënt
oktober 13, 2022
In Het Oogziekenhuis Rotterdam is voor het eerst in Nederland een draadloze chip geïmplanteerd onder het netvlies van een zeer slechtziende patiënt met droge Leeftijdsgebonden Maculadegeneratie (LMD). Met deze chip zal hij in combinatie met bijbehorende speciale bril hopelijk weer letters en woorden kunnen herkennen.

Reactie foodwatch op besluit Van Ooijen stopzetten overlegtafel met drankindustrie
oktober 13, 2022
Vandaag heeft de staatsecretaris van Volksgezondheid Van Ooijen besloten het overleg met de drankindustrie in het kader van het Nationaal Preventieakkoord te stoppen. Voedselwaakhond Foodwatch is blij met het besluit en roept de regering op nu door te pakken. Het preventieakkoord faalt en het is tijd voor wettelijke regels, zonder invloed van de drank- én voedingsindustrie.

UMC Utrecht opent vernieuwde spoedeisende hulp
oktober 13, 2022
Jaarlijks melden zich 20.000 patiënten op de SEH van het UMC Utrecht. Er zijn negen high care-bedden, waarvan twee traumakamers, en negen low care-bedden. Na een half jaar is het zover: de SEH is weer in bedrijf op de bekende plek in het UMC Utrecht. In de afgelopen maanden zijn aanpassingen doorgevoerd om patiënten nóg beter van dienst te kunnen zijn. De CT-scanner is hiervan een prachtvoorbeeld. Kijk hier voor een impressie van de SEH UMC Utrecht

Noordwest contracteert bouwpartijen nieuwbouw fase 1 Alkmaar
oktober 11, 2022
Op 6 oktober ondertekenden Noordwest Ziekenhuisgroep, MedicomZes en ULC Installatietechniek de uitvoeringsovereenkomst voor nieuwbouw fase 1 op Noordwest locatie Alkmaar. Dit betekent dat de realisatie van het nieuwe ziekenhuisgebouw gaat starten. De nieuwbouw met een omvang van 35.000 m² bestaat uit de ‘acute as’ met o.a. operatiekamers, spoedplein met SEH, intensive care en verpleegafdelingen voor complexe zorg. Daaronder komt een ondergrondse parkeergarage.

Agnes Klaren nieuw lid raad van toezicht Maasstad Ziekenhuis
oktober 11, 2022
Het Maasstad Ziekenhuis verwelkomt Agnes Klaren met ingang van 16 oktober 2022 als nieuw lid van de raad van toezicht. Daarmee is invulling gegeven aan de opvolging van drs. Desiree Burger, die na acht jaar haar maximale zittingstermijn heeft bereikt.

EIT Health, de Europese innovatieversneller
oktober 10, 2022
Op acht plekken in Europa is een EIT Health gevestigd: een European Institute of Innovation and Technology. Eén van die plekken is Rotterdam. “De stad staat internationaal echt op de kaart als één van de kerngebieden op het gebied van health en technologie,” zegt Menno Kok, directeur van EIT Health België en Nederland.

Plannen voor regionaal gezondheidscentrum en woningbouw Ziekenhuisterrein locatie ETZ Waalwijk verkocht
oktober 10, 2022
Het terrein en de gebouwen van het Elisabeth-TweeSteden Ziekenhuis (ETZ) aan de Kasteellaan in Waalwijk zijn verkocht. Op termijn komen op deze plek een nieuw regionaal gezondheidscentrum en 195 woningen.

Het Nationale Voorleesboek in gesproken vorm en braille beschikbaar
oktober 10, 2022
Vandaag werd tijdens de Nationale Voorleeslunch in heel Nederland voorgelezen aan ouderen. Met zichtbaar plezier genoten in Maison Gaspard de Coligny in Den Haag ouderen van de verhalen die door Yvonne Keuls werden voorgelezen. Op initiatief van Passend Lezen werd de Nationale Voorleeslunch in deze woonzorgvoorziening georganiseerd. Passend Lezen draagt de Nationale Voorleeslunch een warm hart toe. Als geen ander weten wij hoe luisteren naar verhalen mensen uit hun isolement kan halen. Voorlezen, zelf lezen en genieten van verhalen moet voor iedereen en altijd mogelijk zijn, daarom is het Nationale Voorleesboek, waar alle Nationale Voorleeslunchverhalen van de afgelopen 10 jaar in gebundeld zijn, ook in gesproken vorm en braille beschikbaar voor mensen met een leesbeperking.

Erwin van Santen nieuwe bestuurder WZA
oktober 10, 2022
De vacature in het bestuur van het WZA (Wilhelmina Ziekenhuis Assen) wordt per 1 januari 2023 ingevuld door Erwin van Santen. Van Santen, momenteel werkzaam in Tergooi MC, vormt dan samen met zittend bestuurder Hans Mulder de raad van bestuur van het Wilhelmina Ziekenhuis Assen.

Oogvereniging, NS en ProRail vragen aandacht voor blinde en slechtziende reizigers op de Dag van de Witte Stok
oktober 6, 2022
Mensen die blind of slechtziend zijn ervaren regelmatig onzekere momenten bij het reizen met het openbaar vervoer. De Oogvereniging, NS en ProRail lanceren daarom samen de campagne ‘Oog voor een ander’. Treinreizigers in heel Nederland krijgen handige tips hoe zij blinde en slechtziende medereizigers kunnen helpen tijdens hun reis. De campagne activiteiten zijn op zaterdag 15 oktober, de internationale Dag van de Witte Stok.

15-jarig Jubileum Passend Lezen gevierd tijdens de ZieZo-Beurs
oktober 6, 2022
Op vrijdag 30 september vierde Bibliotheekservice Passend Lezen op feestelijke wijze haar 15-jarig jubileum tijdens de ZieZo-beurs in Utrecht. In aanwezigheid van klanten en partners van Passend Lezen ontving Tweede Kamerlid Daan de Kort, zelf slechtziend, 15 boeken die 15 jaar geleden in de collectie beschikbaar kwamen. Deze overhandiging markeerde het bestaan van de voorziening in de huidige vorm en waar Passend Lezen voor staat; het toegankelijk maken van lectuur voor mensen met een leesbeperking.

Steunhart: operatie in Rotterdam, controles in Eindhoven
oktober 4, 2022
Het Erasmus MC in Rotterdam en het Catharina Ziekenhuis in Eindhoven zijn een samenwerking gestart bij de zorg voor patiënten met een steunhart. De operatie gebeurt in Rotterdam. De nazorg en controles vinden afwisselend plaats in Eindhoven en Rotterdam.

Samen beslissen; Ikazia start met keuzehulp dikke darm kanker
oktober 4, 2022
Het Oncologisch Centrum van het Ikazia Ziekenhuis is gestart met het gebruik van een digitale keuzehulp voor dikke darm kanker. Zo kunnen arts en patiënt ‘samen beslissen’. Vaak zijn er bij kanker meerdere behandelingen mogelijk. Elke behandeling heeft zijn eigen voor- en nadelen die veel invloed kunnen hebben op het leven van patiënten. Ikazia vindt het belangrijk deze beslissingen samen met de patiënt te nemen. De keuzehulp helpt patiënten en zorgverleners daarbij.

Noordwest verstevigt e-health aanbod
oktober 3, 2022
Noordwest verstevigt het e-health aanbod voor haar patiënten. Ten eerste met de keuze voor Luscii als leverancier voor thuismonitoring. Daarnaast is er een gloednieuwe integratie gemaakt tussen de online keuzehulpen van PatientPlus en het elektronisch patiëntendossier van Noordwest. Tot slot starten de spoedeisende hulp en het traumateam Noordwest met de ‘Virtual Fracture Care’ app. Hiermee kunnen patiënten met eenvoudig letsel per direct met ontslag en is een controleafspraak niet langer noodzakelijk. Patiënten kiezen altijd zelf of zij gebruik willen maken van deze digitale mogelijkheden.

JAARCONGRES: ONDERSTROOM
oktober 3, 2022
Kom je ook naar ons jaarcongres? Het centrale thema is onderstroom. We kijken naar de (leef)wereld van gedachten en gevoelens die minder zichtbaar zijn. Naar wat iedereen onbewust wel voelt en ervaart, maar niet altijd doordringt tot stelsels, structuren en systemen. De vraag is hoe we hier een samenhangend geheel van maken en daarbij de beweging stimuleren naar een gezonder Nederland. Met minder spanning, meer verbindingen, nieuwe gevoelens en ander gedrag. Ook bij jezelf.

Onderzoekers: ‘Help ons om resistente bacterie te stoppen’
september 30, 2022
Onderzoekers van het Erasmus MC zoeken Rotterdammers die willen meehelpen om de resistente Pseudomonas-bacterie de wereld uit te krijgen. Door lichaamskweekjes te onderzoeken, hopen de wetenschappers meer te weten te komen over deze bacterie die bezig is aan een wereldwijde opmars. De bacterie kan voor levensbedreigende infecties zorgen, vooral bij mensen met een zwakkere gezondheid.

MS-symposium 17 oktober 2022
september 30, 2022
Op maandag 17 oktober organiseert Gedeelde Zorg in samenwerking met diverse sponsoren het MS-symposium ‘Zicht op Multiple Sclerose anno 2022’ voor MS-patiënten, hun naasten en andere geïnteresseerden. Diverse sprekers zullen aan het woord zijn. Voorafgaand aan het programma in de zaal en in de pauze is er een informatiemarkt, zodat u na afloop precies weet bij welke organisaties u terechtkunt met uw vragen over MS.

Sander Dekker nieuw lid raad van bestuur Maasstad Ziekenhuis per 1 januari 2023
september 28, 2022
Per 1 januari 2023 treedt Sander Dekker aan als nieuwe bestuurder van het Maasstad Ziekenhuis. Samen met bestuurder Wietske Vrijland vormt Dekker de raad van bestuur en gaat hij verder invulling geven aan de strategie en de ambities van het ziekenhuis. Daarbij is bewust gekozen voor collegiaal bestuur, waarin de twee bestuurders elkaar qua profiel en achtergronden goed aanvullen. Tot de komst van Dekker zal Jaap van den Heuvel ad interim lid blijven van de raad van bestuur.

Borstkankercafé WZA online en in het echt te bezoeken
september 28, 2022
Het WZA (Wilhelmina Ziekenhuis Assen) houdt op maandag 31 oktober een borstkankercafé bij grandcafé Zusjes de Boer in Assen. Er zijn twee thema’s deze avond: de mogelijkheden bij borstreconstructies en werken met of na kanker.

Het ergo- Onderzoek, de grootschalige Rotterdamse studie naar het voorkomen van dementie
september 27, 2022
De bekende uitdrukking zegt het al: voorkomen is beter dan genezen. Maar dat gebeurt veel te weinig, stelt Arfan Ikram, hoogleraar Epidemiologie aan de Erasmus Universiteit. Met een grootschalig onderzoek naar de oorsprong van dementie en de ziekte van Alzheimer richt Arfan zich op preventie. “Er wordt op dit moment meer geïnvesteerd in genezen bij hoog-risico groepen dan voorkomen in de algemene bevolking.”

Voorlichting over niet-aangeboren hersenletsel
september 27, 2022
Gedeelde Zorg organiseert een informatiebijeenkomst over omgaan met gevolgen van een herseninfarct, hersenbloeding, TIA, ongeluk met hoofdletsel of hersenoperatie. Tevens gelegenheid tot lotgenotencontact en het stellen van vragen.

Bob Pinedo Cancer Care Award 2022 voor Laurence Zitvogel
september 27, 2022
De Franse oncologe Laurence Zitvogel onderzoekt al dertig jaar het verband tussen het immuunsysteem en het succes van therapieën om kanker te bestrijden. Zo ontdekte zij onder meer dat micro-organismen in de darm de effectiviteit van de behandeling van kanker beïnvloeden. Voor haar baanbrekende wetenschappelijke werk op dat gebied en haar gedreven inzet om daarmee de behandeling van en de zorg voor kankerpatiënten te verbeteren, ontvangt zij dit jaar de Bob Pinedo Cancer Care Award.

Hoe weerbaar is jouw organisatie tegen een cyberaanval?
september 23, 2022
Hoe weerbaar is de LS&H sector tegen aanvallen van buitenaf? Meld je aan voor een gratis quick-scan. De Life Science & Health sector kan niet zonder vernieuwende, digitale technologie. Maar is de sector weerbaar tegen digitale aanvallen van buitenaf? Harm Blankers, oprichter van IT-security bedrijf REQON ziet nog wel verbeterpunten. “We zien dat er echt zaken zijn waaraan gewerkt moet worden.” In opdracht van de provincie Zuid-Holland doen hij en zijn team onderzoek. En bedrijven uit de LS&H sector kunnen gratis meedoen.

Digitale voorlichting verlaagt zorgkosten bij hartpatiënten
september 23, 2022
Hartpatiënten die na een omleidingsoperatie toegang hebben tot digitale voorlichting (e-Health) gebruiken na deze ingreep minder vaak zorg. Ook voelen patiënten zich sneller beter. Dat blijkt uit onderzoek van de Nederlandse Hartstichting en het Catharina Ziekenhuis onder bijna 300 patiënten. Deze onderzoeksresultaten tonen voor het eerst aan dat digitale voorlichting de zorg kan verbeteren én de zorgkosten kan verlagen.

Norm risicoanalyse in sport en recreatie open voor commentaar
september 22, 2022
Vanuit ISO is er gewerkt aan een norm waarin verschillende risicoanalyses worden beschreven om de voordelen en risico’s bij sport en recreatieve activiteiten te bepalen. Belanghebbenden kunnen tot 3 november 2022 commentaar geven op deze norm.

Beste Optiekstudent 2022
september 21, 2022
Houten, dinsdag 20 september 2022 – Zenja Looijmans is de Beste Optiekstudent 2022! Uit zeven genomineerden koos de vakjury Zenja. Dit optiektalent startte als gastvrouw in een optiekwinkel maar wilde doorgroeien en begon daarom de opleiding tot opticien. “Ondanks dat Zenja volledig nieuw was in onze mooie optiekbranche, was dit op de winkelvloer nauwelijks te merken.”

Nederlandse oogarts wint prestigieuze Champalimaud Award
september 20, 2022
Dr Melles heeft in 2000 het Netherlands Institute for Innovative Ocular Surgery (‘NIIOS’) opgericht voor de ontwikkeling en introductie van nieuwe operatietechnieken, die inmiddels wereldwijd navolging genieten en waarmee meer dan 20 miljoen patiënten zijn geopereerd.

Ziekenhuis VieCuri regelt kleding en toiletartikelen voor patiënt zonder naasten?
september 15, 2022
Regelmatig komen er patiënten in het ziekenhuis zonder enig sociaal netwerk. Vaak gaat het om ouderen, seizoenarbeiders of mensen zonder vaste woon- of verblijfplaats. Deze patiënten kunnen niemand bellen voor schone kleding of producten voor de persoonlijke verzorging. VieCuri heeft samen met vriendenstichting VieAmi het initiatief genomen om deze mensen te helpen. Er is nu een aantal basissets kleding beschikbaar en er zijn toilettasjes met producten voor de persoonlijke verzorging en hygiëne.

Spoedpatiënt profiteert van slimmere samenwerking Huisartsenorganisatie Kop van Noord-Holland en Noordwest Ziekenhuisgroep
september 14, 2022
Patiënten die via Huisartsenorganisatie Kop van Noord-Holland naar de spoedeisende hulp (SEH) van Noordwest Ziekenhuisgroep worden verwezen, hoeven niet langer met een papieren verwijzing op pad. Sinds kort vindt de verwijzing van de huisartsenpost naar de spoedeisende hulp digitaal plaats. Dit beperkt administratieve handelingen en komt de snelheid ten goede, wat in de spoedzorg van groot belang is. De samenwerking is onderdeel van de realisatie van het spoedplein op Noordwest locatie Den Helder, waarbij de huisartsenpost en SEH volledig zijn geïntegreerd.

Euronitrile werkt aan een duurzaam én hoogwaardig alternatief voor de medische wegwerphandschoen.
september 13, 2022
Dat er in een ziekenhuis veel verschillende producten worden gebruikt zal niemand verbazen. Maar dat het er tienduizenden zijn en dan ook nog uniek bovendien, is toch wel heel bijzonder. Eén van die producten is de medische wegwerphandschoen. En die handschoenen blijken ook nog eens één van de meest belastende voor het milieu. Dat moet anders kunnen, dachten Michiel Kuijpers en Daan Lamens. Met hun bedrijf Euronitrile zitten ze in de laatste fases naar een duurzame medische wegwerphandschoen.

Rik Riemens benoemd tot lid Raad van Bestuur ad interim bij Ikazia Ziekenhuis
september 13, 2022
Rik Riemens is met ingang van 14 september 2022 benoemd tot lid Raad van Bestuur ad interim bij het Ikazia Ziekenhuis in Rotterdam. Deze benoeming is met instemming van de ondernemingsraad, de cliëntenraad en in nauw overleg met het MSBI. Rik Riemens en Rob Kievit vormen samen de Raad van Bestuur. Rob Kievit is voorzitter van de Raad van Bestuur, wat betekent dat hij eindverantwoordelijk is voor de organisatie. Rik Riemens zal zich, in zijn nieuwe functie, richten op de financiële crisis waar het Ikazia Ziekenhuis op dit moment in zit, het herstelplan en de executie van de op het financiële vlak te nemen maatregelen.

Huisbankier ING en zorgverzekeraars geven Ikazia Ziekenhuis vertrouwen
september 9, 2022
Huisbankier ING en de vijf grootste zorgverzekeraars hebben aangegeven dat zij het Ikazia Ziekenhuis rust en ruimte willen geven om het herstelplan, waar op dit moment aan gewerkt wordt, verder uit te werken. ING heeft aangegeven dat de kredietfaciliteiten per 1 oktober tot het einde van het jaar worden verlengd. Dat doet ING omdat Ikazia de nodige verbeteringen in gang heeft gezet; constructief samenwerkt met zorgverzekeraars aan een toekomstbestendig plan; en heeft Ikazia aangegeven meer tijd nodig te hebben om het plan goed te onderbouwen. Ook de zorgverzekeraars stellen zich constructief op en ondersteunen het ziekenhuis.

‘Klimaatonderzoek Initiatief Nederland’ nodig voor realisatie klimaat-neutrale samenleving
september 9, 2022
Klimaatwetenschappers, verenigd in een tijdelijk adviesorgaan ingesteld door NWO en KNAW, adviseren om zo snel mogelijk het ‘Klimaatonderzoek Initiatief Nederland’ – KIN – op te richten. Doel van het nieuwe KIN is om een substantiële bijdrage te leveren aan het versnellen van de transformaties die nodig zijn om in 2050 een duurzame, klimaat-neutrale samenleving te realiseren. In het vandaag verschenen rapport van de taskforce staat uitgewerkt hoe het KIN eruit zou kunnen zien en functioneren.

Blik op de toekomst tijdens het Nationale Oogcongres 2022
september 9, 2022
Als we niets doen loopt de zorg over een aantal jaar helemaal vast, stelt Zorginstituut Nederland. Zo ver is het gelukkig nog niet. Volgens de Oogvereniging kunnen we zelf helpen om de zorg goed, toegankelijk en betaalbaar te houden voor iedereen. Hoe dat kan is te horen tijdens het Nationale Oogcongres 2022 op zaterdag 5 november.

Brabants Boek Present Zo hoog de zon stond in gesproken vorm en braille beschikbaar
september 6, 2022
Voor het tweede jaar op rij is het Brabants Boek Present ook beschikbaar voor mensen met een leesbeperking. De gesproken versie van Zo hoog de zon stond is door auteur Simone Atangana Bekono zelf ingesproken. Daarnaast is Zo hoog de zon stond ook te lezen in braille.

SATELLIETBIJEENKOMST MENTAAL GEZOND
september 5, 2022
Na de succesvolle sessie over ‘prestatiedruk’ organiseert Gezond010 op maandagmiddag 17 oktober de volgende bijeenkomst van de satelliet Mentaal Gezond. Het thema is dit keer: ‘Hoe effectief zijn preventieve interventies op het gebied van mentale gezondheid?’

KNO-artsen delen oordoppen en zonnebrandcrème uit aan bezoekers van de Formula 1 Heineken Dutch Grand Prix
september 2, 2022
Tijdens de Formula 1 Heineken Dutch Grand Prix op 2-4 september in Zandvoort delen KNO-artsen van onder andere het UMC Utrecht oordoppen en zonnebrandcrème uit. Ze gaan herkenbaar in een witte jas in gesprek met de bezoekers over het effect van geluid op het gehoor en het gevaar van te veel zonexpositie. Het doel is om mensen bewust te maken van het belang van het dragen van oordoppen bij harde geluiden om zo gehoorschade eenvoudig te voorkomen en het gebruik van zonnebrandcrème.

Eerstelijns Centrum Tiel en Ziekenhuis Rivierenland werken samen aan digitale vaardigheid van patiënten
september 2, 2022
Van 8 t/m 14 september 2022 vindt de Week van Lezen en Schrijven plaats. Zo’n 2,5 miljoen volwassenen in Nederland hebben moeite met lezen, schrijven en/of rekenen. Vaak missen zij ook digitale vaardigheden om goed om te gaan met een computer, smartphone en tablet. Ondertussen kunnen en moeten zij steeds meer online regelen. Ook in de zorg. Ruim één op de drie Nederlanders van 18 jaar en ouder vindt het moeilijk om informatie over hun gezondheid te begrijpen. In Tiel werken het Eerstelijns Centrum Tiel (ECT) en Ziekenhuis Rivierenland samen om deze mensen zo goed mogelijk te helpen om informatie te vinden en begrijpen.

AYA-team helpt jonge kankerpatiënten in Ikazia
september 1, 2022
In Nederland horen jaarlijks bijna 4.000 jongvolwassenen in de leeftijd van 18 t/m 39 jaar dat zij kanker hebben. Zij worden AYA’s genoemd, dat staat voor Adolescents and Young Adults. Deze jonge kankerpatiënten zijn in de bloei van hun leven en hebben baat bij leeftijdsspecifieke zorg. In Ikazia staat een AYA-team voor hen klaar.

Dit zijn de hoogtepunten op de VeggieWorld beurs in Nederland
augustus 31, 2022
Op 3 en 4 september 2022 vindt de volgende VeggieWorld beurs in Nederland plaats. Op het terrein van de Expo Houten bij Utrecht laten de organisatoren van de Messe Dortmund zien hoe kleurrijk, veelzijdig, lekker en eenvoudig een veganistische manier van leven zijn kan.

Feestelijke opening Geriatrische Trauma Unit Ikazia
augustus 30, 2022
Op de vijfde verdieping van het Ikazia Ziekenhuis wordt dinsdag 30 augustus een Geriatrische Trauma Unit (GTU) feestelijk geopend. Deze GTU is van grote waarde voor oudere patiënten en mede mogelijk gemaakt door de stichting Vrienden van Ikazia. De afdeling is sfeervol aangekleed en er is een gezellige huiskamer waar patiënten eten, spelletjes doen en met elkaar kunnen praten. Zo hebben ze een huiselijker gevoel, meer contact met elkaar en zijn ze actiever. Daardoor herstellen patiënten sneller.

Patiënten met spierziekte blij met digitale zorg
augustus 30, 2022
De afgelopen vijf jaar hebben revalidatiezorgverleners met behulp van een online zorgplatform het ziekteverloop van een groep patiënten met een spierziekte zoals ALS in de gaten gehouden. Promovendus Jochem Helleman van het UMC Utrecht onderzocht wat patiënten van deze digitale zorg vinden. Zijn conclusie: patiënten vinden zorg op afstand prettiger dan de traditionele zorg, met relatief veel afspraken op locatie. Ze voelen zich ook veiliger, omdat ze het gevoel hebben dat hun behandelteam voortdurend een oogje in het zeil houdt. Helleman promoveert op woensdag 31 augustus op dit onderwerp.

Vergroening Hofplein zorgt voor koelere binnenstad
augustus 26, 2022
De gemeente Rotterdam heeft onderzoek laten doen naar het effect van de toekomstig nieuwe groene inrichting van het Hofplein op de hittestress in de binnenstad.

Tweeduizendste bevalling in het Ikazia Ziekenhuis?
augustus 26, 2022
Op maandag 22 augustus beviel mevrouw Koenraads van haar eerste kindje in het Moeder en Kind Centrum van het Ikazia Ziekenhuis. Met de komst van baby Jayvë viert het Rotterdamse ziekenhuis haar tweeduizendste bevalling van dit jaar. Moeder en zoon werden donderdag verrast met een kinderstoeltje en een knuffel.

Eerste kinderen doen mee aan Europees onderzoek van UMC Utrecht: werkt één coronavaccinatie ook
augustus 26, 2022
Kinderen van 5 tot en met 11 jaar oud beschermen tegen corona? UMC Utrecht onderzoekt of één prik van het Pfizer-BioNTech vaccin evengoed beschermt als twee prikken bij kinderen die corona hebben gehad. Kinderen die gevaccineerd willen worden kunnen zich aanmelden voor dit onderzoek. Elsa van zeven is het eerste kind dat recent aan dit CoVacc onderzoek mee heeft gedaan.

Beijerinck Prijzen voor virologie 2023
augustus 25, 2022
De Koninklijke Nederlandse Akademie van Wetenschappen (KNAW) kent tweejaarlijks de M.W. Beijerinck Virologie Prijs en jaarlijks de Beijerinck Premie toe.

SPECIAL EVENT: THE FUTURE OF QUANTUM TECH
augustus 23, 2022
VENTURE SCHOOL AUGUST 25, 2022 Erasmus Enterprise & Venture Café Rotterdam are teaming up to bring you a special event on “The Future of Quantum Tech” on August 25th from 4:00-6:00pm! During this vibrant event we aim to get you properly introduced to the quantum technology and get you inspired about the possibilities it offers. Key players and […]

Beslishulp voor verbetering diagnose bij vrouwen met hartklachten
augustus 23, 2022
Utrecht, 23 augustus – Onderzoekers van het UMC Utrecht, de Tilburg University en het Amsterdam UMC ontvingen een subsidie van 300.000 euro van ZonMw om de diagnose en behandeling bij vrouwen met mogelijke hartklachten te verbeteren. De onderzoekers gaan een keuzehulp doorontwikkelen om vrouwen met hartklachten te helpen op tijd naar de huisarts te gaan en hen te ondersteunen bij het gesprek met de huisarts. Daarnaast brengen de onderzoekers een software-beslishulp naar de praktijk die helpt om te bepalen of extra beeldvormend onderzoek nodig is.

Ikazia werkt samen met banken en zorgverzekeraars aan herstelplan na verliesjaar
augustus 22, 2022
Vandaag publiceert Ikazia Ziekenhuis haar jaarrekening 2021. Na het verliesjaar 2020 is er voor het Rotterdamse ziekenhuis in 2021 opnieuw sprake van een fors verlies (8,5 miljoen euro). Ook in 2022 loopt de verliessituatie vooralsnog door. Momenteel werkt het Ikazia Ziekenhuis nauw samen met zorgverzekeraars en banken aan een gezamenlijk herstelplan.

Lotgenotencontact niet-aangeboren hersenletsel?
augustus 18, 2022
We organiseren een lotgenotenbijeenkomst over omgaan met de gevolgen van een herseninfarct, hersenbloeding, TIA, ongeluk met hoofdletsel of hersenoperatie. Tevens is er gelegenheid tot het stellen van vragen.

Start van innovatief geneesmiddelenonderzoek bij patiënten met zeldzame auto-immuunziekten
augustus 18, 2022
18 augustus 2022 – Stichting ARCH, Galapagos, en het UMC Utrecht starten met financiële steun van ReumaNederland en Health Holland onder de naam DRIMID een patient-public-private consortium. DRIMID heeft als doel de toegang tot innovatieve geneesmiddelen voor patiënten met zeldzame immunologische aandoeningen te versnellen. Deze groep patiënten komt meestal niet in aanmerking voor klinische studies en heeft daardoor geen of beperkte toegang tot innovatieve middelen.

Dutch Sport Tech Fund investeert in wielrenapp Link My Ride
augustus 9, 2022
Dutch Sport Tech Fund, investeert in Link My Ride, een app die het voor wielrenners en wielrenclubs makkelijker wil maken om groepsritten te organiseren. Een van de oprichters van het bedrijf is Tom Pidcock, winnaar van een etappe uit de recente Tour de France. Dutch Sport Tech Fund is het enige fonds in Nederland dat zich exclusief richt op sporttechnologie start- en scale-ups.

Immersive Tech Week 2022 reveals first speakers, conference tracks and partners
augustus 8, 2022
Immersive Tech Week is gearing up for its 8th edition and will be back IRL from November 28 to December 2 in de Doelen, Rotterdam. The team is excited to reveal the first line-up of speakers, featuring some of the brightest minds and global visionaries from the immersive technology field and beyond.

Transitiepoli draagt kinderen met downsyndroom goed over
augustus 1, 2022
Kinderen met het syndroom van down en hun ouders zijn gebaat bij een goede, duidelijke en veilige transitie (overgang) van de kindergeneeskunde naar de volwassenenzorg. Dat maakt het ETZ (Elisabeth-TweeSteden Ziekenhuis) mogelijk met de transitiepoli, waar de zorgprofessionals ruim de tijd nemen om de kinderen zorgvuldig over te dragen.

Generatie-fotowand Geboortecentrum IJsselland feestelijk onthuld!
juli 28, 2022
Sinds anderhalf jaar heeft het IJsselland Ziekenhuis een prachtig nieuw Geboortecentrum, waar ze topfaciliteiten en deskundigheid bieden aan zwangere en barende vrouwen. Denk onder andere aan 24 uur mogelijkheid van pijnstilling, en op één van de zes verloskamers is het zelfs mogelijk om in bad te bevallen. Eén van de belangrijkste eisen die het IJsselland […]

Duurzame vis en ecologische honing
juli 28, 2022
De betekenis van de labels op voedingsverpakkingen Je neemt een zak chips uit de rekken in de supermarkt en ziet één grote warboel van verschillende labels en informatie. En hoewel ze bedoeld zijn om ons groener en gezonder te laten consumeren, maken ze het er vaak niet eenvoudiger op. Hoe kan je die labels lezen […]

1000e baby van 2022 geboren in Geboortecentrum IJsselland
juli 28, 2022
Woensdagochtend 27 juli is de 1000e baby van 2022 geboren in Geboortecentrum IJsselland! Het meisje heet Xenna en is het eerste kindje voor mw. Van den Herik, en het tweede kindje voor dhr. Van den Herik uit Krimpen aan den IJssel. Namens het IJsselland Ziekenhuis reikte co-bestuurder en dermatoloog R. Nellen een knuffel en een […]

Burgemeester Aboutaleb naar Ho Chi Minhstad en Singapore
juli 25, 2022
Dinsdag 26 juli begint het werkbezoek van burgemeester Aboutaleb aan Ho Chi Minhstad in Vietnam. Daar spreekt hij met lokale autoriteiten, ondernemers, studenten en investeerders over havenontwikkeling, duurzaamheid en klimaatadaptatie. De Vietnamese miljoenenstad heeft net als Rotterdam te maken met de gevolgen van klimaatverandering zoals droogte, overstromingen en zeespiegelstijging. Vrijdag 29 juli reist hij door […]

Nederlandse wetenschappelijke expeditie van uitersten ten einde
juli 25, 2022
De Nederlandse wetenschappelijke expeditie rond Spitsbergen, SEES, is ten einde. Vrijdagmorgen 22 juli is het schip de Ortelius met aan boord 50 wetenschappers en 40 toeristen aangemeerd in Longyearbyen. De deelnemers hadden de eerste dagen te maken met ontberingen, waardoor het geplande veldwerk in enkele gebieden in het geding kwam. “Hier staat een zeer gelukkig […]

Drukte huisartsenspoedposten: bel alleen de spoedlijn indien noodzakelijk
juli 22, 2022
De druk op de huisartsenspoedposten is ook in de regio Utrecht enorm hoog. Daarom roepen de huisartsen mensen op om begrip te hebben voor langere wachttijden. En – belangrijker nog – om alleen te bellen als een vraag medisch gezien niet kan wachten tot de volgende werkdag. Reden voor de langere wachttijden zijn de uitval […]

Vakantiegangers gezocht!
juli 22, 2022
Ga je binnenkort op vakantie? Het UMC Utrecht is op zoek naar vakantiegangers die mee willen doen aan het One Health Travel onderzoek. Dit onderzoek is een onderdeel van een groot Nederlands project genaamd One Health PACT. We onderzoeken in Nederland de opkomst van door muggen overdraagbare infecties en de factoren die hierop van invloed […]

Internationaal FIP RISE padeltoernooi naar Rotterdam
juli 20, 2022
‘Padel Rotterdam Open’ vindt plaats van 22 tot en met 28 augustus Rotterdam, 27 juni 2022 – Het internationale padeltoernooi FIP RISE wordt dit jaar van 22 tot en met 28 augustus gehouden bij Lake7 in Zevenhuizen bij Rotterdam. Het evenement vindt plaats onder de naam Invint Padel Rotterdam Open* en er zijn wedstrijden voor mannen en […]

Positieve resultaten vermindering erectieproblemen door nieuwe techniek bestraling prostaatkanker
juli 14, 2022
Utrecht, 14 juli 2022, Een nieuwe techniek om prostaatkanker nog preciezer te bestralen. Met deze techniek op de MR-Linac brengen klinisch fysici en radiotherapeut-oncologen in het UMC Utrecht de prostaat nu niet alleen voorafgaand, maar ook tijdens de bestraling real-time in beeld. En dat is een doorbraak: veel minder gezond weefsel wordt zo mee bestraald, […]

Nederlandse wetenschappelijke expeditie klaar voor vertrek
juli 13, 2022
De Nederlandse wetenschappelijke expeditie rond Spitsbergen, SEES, is klaar voor vertrek. Vanmiddag om 18 uur vaart het schip de Ortelius af vanaf Longyearbyen met aan boord 50 klimaatwetenschappers, biologen, sociologen en andere wetenschappers. Afgelopen week was het spannend of iedereen tijdig op Spitsbergen zou arriveren door de staking van de piloten van luchtvaartmaatschappij SAS. “Afgelopen […]

IC-patiënten aan beademing communiceren via oogbesturing
juli 13, 2022
IC-verpleegkundige Arné van Hees maakt een patiënt vertrouwd met het systeem voor oogbesturing. Patiënten die op de Intensive Care (IC) aan de beademing liggen, kunnen niet praten en vanwege lichamelijke zwakte of een aandoening niet volledig bewegen. Om te zorgen dat zij tóch kunnen communiceren, maakt het ETZ (Elisabeth-TweeSteden Ziekenhuis) in Tilburg als eerste ziekenhuis […]

Mannen van 31-50 jaar hebben al genoeg zout op voor heel 2022
juli 13, 2022
14 juli is de eerste Zoutmaxdag van 2022. Voedselwaakhond foodwatch heeft berekend dat Nederlandse mannen tussen 31 en 50 jaar op 14 juli al hun maximale hoeveelheid zout binnen hebben gekregen voor een heel jaar. Dit betekent dat elke gram zout die ze gemiddeld vanaf vrijdag tot het eind van 2022 innemen, nog vijf maanden […]

Koen Willemsen promoveert cum laude en bouwt verder aan 3D Lab
juli 13, 2022
Met zijn ‘boekje’ van maar liefst 19 hoofdstukken promoveerde Koen Willemsen cum laude aan het UMC Utrecht. Zijn werk heeft de basis gelegd voor het 3D Lab van het UMC Utrecht, dat tot de wereldtop behoort en waarbij Willemsen als coördinator van de afdeling fungeert. Inmiddels profiteren zo’n 200 patiënten per jaar van het 3D […]

MRI ingetakeld in nieuwe operatiekamer Wilhelmina Kinderziekenhuis
juli 12, 2022
Innovatieve operaties voor kinderen met een hersentumor vanaf eind 2022 Utrecht, 12 juli 2022. Vanmorgen is met een grote kraan de 6300 kilogram zware magneet van de MRI-scan het gebouw van het WKZ ingetakeld. Het apparaat is door een gat in de gevel van de nieuwe aanbouw bij het Wilhelmina Kinderziekenhuis naar binnen geschoven. Een hoogtepunt voor […]

Corona-zelftests minder nauwkeurig bij afname mensen zonder klachten
juli 11, 2022
Utrecht, 11 juli 2022 Nederlands onderzoek heeft uitgewezen dat tijdens de periode dat de Omicron variant van het coronavirus dominant werd, de nauwkeurigheid van drie commercieel beschikbare corona-zelftests waarbij mensen zonder Covid-19 klachten zelf een monster met een wattenstaafje uit de neus afnemen, laag is. Uit het onderzoek blijkt dat als mensen die geen klachten […]

Jonge kinderen eten dagelijks twee keer zoveel suiker als aanbevolen
juli 11, 2022
Zaterdag 9 juli was de eerste Suikermaxdag van 2022. Nederlandse kinderen tussen 4-8 jaar oud hebben op deze dag gemiddeld hun suikerlimiet voor een heel jaar gehaald. Dit betekent dat ze nu al hun totale suikerinname voor het hele jaar op hebben. En dat terwijl we nog bijna een half jaar hebben te gaan. De Wereldgezondheidsorganisatie (WHO) raadt […]

Oogarts De Faber benoemd tot Officier in de Orde van Oranje Nassau
juli 7, 2022
Uitreiking koninklijke onderscheiding aan oogarts De Faber op 1 juli 2022 door Burgemeester Aboutaleb. Fotograaf: Tridib Das Rotterdam – 1 juli – Drs. Tjeerd de Faber, kinderoogarts in Het Oogziekenhuis Rotterdam, is benoemd tot Officier in de Orde van Oranje Nassau. De Faber kreeg de koninklijke onderscheiding op 1 juli 2022 uitgereikt door Burgemeester Aboutaleb. Oogarts […]

Kwalitatief snel en veilig dunnedarmonderzoek dankzij de PowerSpiral endoscoop
juli 7, 2022
Bij de afdeling Maag-, Darm- en Leverziekten (MDL) van het Maasstad Ziekenhuis worden patiënten met dunnedarmproblematiek voortaan onderzocht en behandeld met een gemotoriseerde endoscoop: de PowerSpiral. “Dankzij de vernieuwde techniek is de ingreep veiliger voor de patiënt en kan deze kwalitatief efficiënter uitgevoerd worden door de specialisten”, stelt Patrick Molendijk, zorgmanager van afdeling MDL. Het […]

‘Wetenschap werkt!’ NWO maakt nieuwe strategie 2023 – 2026 bekend
juli 7, 2022
Het moet makkelijker worden om een aanvraag bij NWO te doen met minder werklast voor onderzoekers, de doorlooptijd van aanvraagprocedures moet worden versneld en de slagingspercentages in de open competitie en het talentprogramma moeten minimaal 25% zijn. Drie van de 38 ambities uit het nieuwe strategisch plan 2023 – 2026 van NWO. De nieuwe NWO-strategie ‘Wetenschap […]

ETZ en VGZ tekenen meerjarencontract
juli 7, 2022
De meerjarenovereenkomst wordt ondertekend door (v.l.n.r.) Cas Ceulen (Chief Health Officer van Coöperatie VGZ), Marjo Vissers – Kuijpers (CEO a.i. van Coöperatie VGZ) en ETZ-bestuursvoorzitterBart Berden. Het ETZ (Elisabeth-TweeSteden Ziekenhuis) en Coöperatie VGZ hebben een nieuw strategisch samenwerkingsverband voor een periode van vijf jaar (2022 – 2026) ondertekend. Beide alliantiepartners zijn erg tevreden over de […]

NWO-Vidi van 800.000 euro voor 101 ervaren onderzoekers
juli 1, 2022
De Nederlandse Organisatie voor Wetenschappelijk Onderzoek (NWO) heeft 101 ervaren onderzoekers een Vidi-financiering van 800.000 euro toegekend. Hiermee kunnen zij de komende vijf jaar een eigen, vernieuwende onderzoekslijn ontwikkelen en een onderzoeksgroep opzetten. De laureaten gaan met het geldbedrag onder andere onderzoeken hoe sterk (langdurig) reukverlies, zoals we dat bij COVID-19 hebben gezien, de kwaliteit […]

Ikazia start met ‘walking epidural’
juni 30, 2022
v.l.n.r. Gynaecoloog Liv Freeman en Anesthesioloog Marjolein van den Nieuwenhuyzen. Dankzij een slimme infuuspomp zijn zwangere vrouwen tijdens hun bevalling in Ikazia niet meer urenlang gebonden aan hun bed. Gynaecoloog Liv Freeman vertelt: “Door de walking epidural ben je tijdens de bevalling niet meer gebonden aan bed en kun je blijven bewegen. Niet alleen het […]

EU-Landbouw kan in 2035 esticidenvrij zijn
juni 30, 2022
Nieuw foodwatch-rapport hekelt de destructieve afhankelijkheid van bestrijdingsmiddelen in de EU. De consumentenorganisatie presenteert een strategie voor pesticidenvrije EU-landbouw in 2035 en dringt aan op een EU-brede belasting op bestrijdingsmiddelen. Foodwatch wil een einde aan de afhankelijkheid van Europa van pesticiden. De voedselwaakhond streeft naar een Europa zonder pesticiden in 2035. De eerste en belangrijkste […]

Gratis zonnebrand voor patiënten en bezoekers Spaarne Gasthuis
juni 29, 2022
Foto: Marije Kruis (founder Spot The Dot) Vanaf 1 juli biedt het Spaarne Gasthuis haar patiënten en bezoekers gratis zonnebrand bij de hoofdingangen van het ziekenhuis. Onder het mom van ‘Geniet van de zon, maar vergeet niet te smeren’ wil het Spaarne Gasthuis benadrukken dat het gebruik van zonnebrandcrème een van de beste manieren blijft […]

Ondersteuning door Loss-App voor ouders bij miskraam en verlies van baby
juni 29, 2022
Het overlijden van een baby tijdens of vlak na de zwangerschap of geboorte is een intens verdrietige en ingrijpende gebeurtenis. Om ouders hierbij te ondersteunen wordt vandaag de Loss-App geïntroduceerd. De app biedt informatie, inzicht en oefeningen die kunnen helpen bij het omgaan met het verlies. De inhoud van de app is onder meer gebaseerd […]

Aantal bedrijfsongevallen met gevaarlijke stoffen blijft hoog
juni 29, 2022
Ook meer vergiftigingen met nieuwe psychoactieve stoffen en nicotinezakjes Utrecht, 28 juni 2022 – Het aantal bedrijfsongevallen met gevaarlijke stoffen blijft hoog. Dit blijkt uit het Jaaroverzicht 2021 van het Nationaal Vergiftigingen Informatie Centrum (NVIC), onderdeel van het UMC Utrecht. Ook opvallend is de verdubbeling van het aantal vergiftigingen met nieuwe psychoactieve stoffen (zoals 3-methylmethcathinon (3-MMC) […]

Appels en prei: BTW-vrij
juni 21, 2022
De prijs voor groente en fruit in het restaurant is van maandag 20 t/m vrijdag 24 juni voor bezoekers en medewerkers van Wilhelmina Ziekenhuis Assen en Martini Ziekenhuis Groningen tijdelijk lager. Om precies te zijn: 9%. Dat is de BTW die over groenten en fruit betaald wordt. De ziekenhuislocaties van Treant in Emmen, Hoogeveen en […]

Dringend bloeddonors gezocht in Midden-Brabant
juni 21, 2022
Je hoeft geen dokter te zijn om levens te redden. Sanquin zoekt dit jaar 2.800 nieuwe bloed- en plasmadonors in Midden-Brabant. Om die te vinden, werkt Sanquin samen met organisaties in de regio. Zowel Tilburg University als het ETZ (Elisabeth-TweeSteden Ziekenhuis) zet zich in om mensen te enthousiasmeren over doneren. De nieuwe donors zijn nodig om […]

HONGER IS GEEN VERDIENMODEL
juni 21, 2022
Voedselwaakhond eist rem op voedselspeculatie richting G7-top In de aanloop naar de G7-top in Duitsland roept voedselwaakhond foodwatch op tot strikte regulering van speculatie met landbouwgrondstoffen. Tijdens de top zouden staatshoofden het eens moeten worden over strengere internationale regels om beleggingen op grondstoffenbeurzen aan banden te leggen. Volgens foodwatch is buitensporige speculatie de oorzaak van de huidige […]

Limburger, Brabanders en Noord-Hollanders winnen Taalheldenprijs
juni 21, 2022
“Wat een kampioen. Hij ontwikkelde zichzelf van laaggeletterde tot taalstrijder in hart en nieren. Door zijn grote inzet en enthousiasme gingen veel mensen die moeite hadden met lezen, schrijven, rekenen en digitale vaardigheden op cursus. Hij is al tientallen jaren actief. Maar zijn énorme betrokkenheid daalt niet. Hij is het ultieme voorbeeld van een Taalheld.” […]

Nieuwe behandeling bij vergrote prostaat
juni 21, 2022
Introductie van Rezum stoom behandeling in Nederland Bij het ouder worden van de man kunnen plasklachten ontstaan. Vaak is een vergrote prostaat de oorzaak. Het behandelen van deze klachten gebeurt in eerste instantie met medicijnen en leefstijlveranderingen. Als daarmee onvoldoende resultaat wordt bereikt is een TURP of laser operatie mogelijk. Sinds kort is er ook […]

Margot Scheltema nieuwe voorzitter Oogvereniging
juni 20, 2022
Houten, 18 juni 2022 – Vandaag is Margot Scheltema beëdigd als nieuwe voorzitter van de Oogvereniging. Margot Scheltema is een van de invloedrijkste vrouwen van het Nederlandse bedrijfsleven. Margot Scheltema volgt Jan Vreeburg op, van wie de maximale termijn er na 9 jaar op zit. Margot Scheltema: “Iedereen moet kunnen meedoen met de maatschappij. Maar […]

Apotheken WZA en Martini Ziekenhuis nemen apotheek Lentis over
juni 17, 2022
Assen – Het Wilhelmina Ziekenhuis Assen (WZA) en het Martini Ziekenhuis nemen vanaf maandag 20 juni de farmaceutische dienstverlening van Lentis over. De apotheek van Lentis gaat sluiten. Donderdag 16 juni zetten alle betrokken partijen hun handtekening onder de dienstverleningsovereenkomst. De Lentis-apotheek verleende tot nu toe farmaceutische op het gebied van ggz-zorg, forensische zorg (FPC Dr. […]

Zes onderzoekers beloond met hoogste onderscheidingen in de Nederlandse wetenschap
juni 17, 2022
Zes wetenschappers ontvangen dit jaar de hoogste onderscheidingen in de Nederlandse wetenschap, de Spinoza- en Stevinpremies. Thea Hilhorst, Klaas Landsman, Corné Pieterse en Ignas Snellen ontvangen dit jaar de Spinozapremie. De Stevinpremies gaan naar Bas Bloem en Tanja van der Lippe. De laureaten krijgen ieder 2,5 miljoen euro, te besteden aan wetenschappelijk onderzoek en activiteiten […]

Digitale tijdschriften, lees- en luisterboeken beschikbaar in Ziekenhuis Rivierenland
juni 14, 2022
Ziekenhuis Rivierenland biedt patiënten vanaf nu een nieuwe service: lezen en luisteren met de Wait app. De Wait app staat vol populaire tijdschriften, lees- en luisterboeken. Dat kan een prettige afleiding bieden tijdens het wachten voor een afspraak of langdurige opname. Tijdens corona is afscheid genomen van de papieren leesmap vanwege de aangescherpte hygiëneregels. Wait […]

Catharina Ziekenhuis koploper in temperatuurwetenschap?
juni 10, 2022
Eindhoven, 10 juni 2022 – Het koelen van de hersenen, het plaatselijk afkoelen van het hart en het verhitten van kwaadaardige tumoren. En zijn de adviezen van Wim Hof, beter bekend als The Iceman, wel zo gezond? Twee dagen lang, op donderdag 16 en vrijdag 17 juni is de Philips Lichttoren in Eindhoven het decor […]

Skihelling, autoparcours, rolstoelskating, silent disco; in de Jaarbeurs is tijdens Support ondanks een bewegingsbeperking veel mogelijk
juni 9, 2022
Marleen Rompen, Projectmanager van Support: “Deze editie staat in het teken van ‘ik kan wonen, reizen, recreëren, leren, werken, spelen en sporten’. We hebben dan ook een compleet sportveld in de Jaarbeurs, verzorgd door de Johan Cruyff Foundation samen met de Esther Vergeerfoundation. Er is een Ski-slope en een inclusieve speeltuin van Eibe. Voor iedereen […]

‘Geef zeldzame ziekten een plek in het Nederlandse overheidsbeleid’
juni 9, 2022
Hoogleraar Ludo van der Pol pleit in zijn oratie voor nieuw beleid rondom dure geneesmiddelen Nieuwe technologieën, zoals RNA- en gentherapie, leiden steeds vaker tot medicijnen voor zeldzame ziekten. Helaas vraagt de farmaceutische industrie meestal exorbitant hoge bedragen voor dit soort medicijnen. Een eenmalige behandeling van een kind met de spierziekte SMA kost bijvoorbeeld zo’n […]

Rooi Pannen en Catharina Ziekenhuis werken samen voor mensen met maagverkleining
juni 8, 2022
Eindhoven, 08 juni 2022 – De Rooi Pannen en het Catharina Ziekenhuis werken sinds enige tijd samen om patiënten met een maagverkleining een goede start te geven na hun ingreep. Speciaal voor deze doelgroep heeft De Rooi Pannen de workshop ‘Lekker en gezond leren koken’ opgezet. Patiënten leren in drie bijeenkomsten om voedzame, gezonde maaltijden te maken. […]

Boeken Leven met macula-degeneratie en Het oog wil ook wat ook in gesproken vorm en braille beschikbaar
juni 8, 2022
Den Haag – 7 juni 2022 – De twee verschenen boeken in het kader van de Maand van de Macula zijn vanaf nu ook beschikbaar bij Passend Lezen, de bibliotheek voor mensen met een leesbeperking. Door het beschikbaar stellen van de titels in gesproken vorm en braille, worden de ervaringsverhalen en tips toegankelijk voor iedereen die moeite heeft […]

Infoavond endometriose in ETZ TweeSteden
juni 8, 2022
Het multidisciplinair endometrioseteam met op de voorgrond de ETZ-gynaecologen Petra Janssen (l) en Femke Wilms (r). Pijnlijke menstruaties in combinatie met darm- en blaasklachten, seksuele problemen en vermoeidheid, die de kwaliteit van leven drastisch verminderen en bovendien de kans op zwangerschap verkleinen. Verschijnselen die verbonden zijn met de goedaardige aandoening endometriose, die jarenlang onder de […]

Is een valpartij van een 70-plusser in een ziekenhuis te voorspellen
juni 8, 2022
Eindhoven, 06 juni 2022 – Onderzoekers van het Catharina Ziekenhuis willen achterhalen of een val van een 70-plusser in een ziekenhuis te voorspellen is. Ze gebruiken daarvoor de notities die meerdere keren per dag door verpleegkundigen in het dossier van een patiënt worden toegevoegd. Onderzoekster Wendy Leurs: “We stelden onszelf de vraag: kun je waardevolle […]

Dagbesteding voor kwetsbare, oudere patiënten in VieCuri
juni 8, 2022
Op de verpleegafdeling interne geneeskunde van ziekenhuis VieCuri worden veel oudere patiënten opgenomen. Deze oudere patiënten zijn kwetsbaar. De mobiliteit en zelfstandigheid kunnen tijdens een ziekenhuisopname snel achteruit gaan en er is een verhoogde kans op verwardheid. Om achteruitgang te voorkomen en meer welzijn te bieden aan deze groep, start VieCuri met een proef. Twee […]

Omnihis B.V. en Promedico gaan samen verder
juni 8, 2022
Omnihis B.V. en Promedico bundelen hun krachten. Met ingang van 1 juni 2022 zijn de ontwikkelaars en leveranciers van IT-zorgsystemen voor de eerstelijnszorg gefuseerd. De twee partijen werkten al vele jaren succesvol samen. Op basis van de klantgroep, historie, DNA én gedeelde visie op de toekomst bouwen zij vanaf nu als een organisatie verder aan […]

Marc Schellekens
juni 3, 2022
Begin volgend jaar start de bouw van het Beagle Building Marconi, vlak naast de Lee Towers. Speciaal ontworpen voor bedrijven in de (bio)technologische sector, dus inclusief hoogwaardige laboratorium- en kantoorruimtes. “Er is een enorme vraag naar dit soort gebouwen,” zegt mede-initiatiefnemer Marc Schellekens. “We hebben het in feite al verkocht voordat het klaar is.”

Sport en tandheelkunde: veel meer dan preventie
juni 2, 2022
Met uiteindelijk het WK voetbal in het najaar in Qatar gaan we een lange sportzomer tegemoet met daarin hoofdrollen voor de Tour de France, Wimbledon, WK Hockey, EK Vrouwenvoetbal en WK Atletiek. TandartsPraktijk, onafhankelijke vaktitel voor de tandarts, belicht de relatie tussen sporter en mondgezondheid in het themanummer sporttandheelkunde en ontdekt dat die specialisatie veel […]

Met knieprothese weer sneller aan het werk
juni 1, 2022
Veel patiënten met een nieuwe knie hebben moeite om weer aan het werk te gaan. Het ETZ gaat deze patiënten voortaan beter begeleiden na de operatie, via het nieuwe zorgpad Back At Work After Sugery (BAAS). Hiermee wordt de patiënt actief betrokken bij zijn herstel. De meeste patiënten met een knieprothese lukt het niet om – […]

Catharina Ziekenhuis sluit uitdagend jaar af met een positief resultaat
juni 1, 2022
Eindhoven, 01 juni 2022 – Vandaag is het jaaroverzicht 2021 van het Catharina Ziekenhuis gepubliceerd. Het was het tweede jaar waarin de Covid-19 pandemie een grote invloed had op de patiëntenzorg. We kwamen tot het besef dat corona niet meer verdwijnt. Een jaar van ‘wederopbouw’ waarin we onze medewerkers konden vaccineren, de maatregelen werden versoepeld […]

Ruim 2500 Rotterdamse kinderen uit groep 7 doen mee aan fietsexamen
mei 31, 2022
Vandaag is het startsein gegeven voor het Praktisch Verkeersexamen in Rotterdam. De komende anderhalve maand leggen ruim 2500 Rotterdamse basisschool scholieren uit groep 7 het fietsexamen af. Dit jaar zijn er 69 basisscholen in Rotterdam die meedoen. Vanaf het schoolplein van het Minister Marga Klompéschool vertrekken de hele dag basisschoolleerlingen op de fiets. Wethouder Judith […]

Social Sofa onthult als symbool voor Pandemie in Ziekenhuis Rivierenland
mei 31, 2022
Rechts: Emilie Schreuder, SEH Verpleegkundige en Aad Schreuder, Corona patiënt (vader en dochter) Links: Bart (Corona patiënt) en Nathalie en dochter Amber Jansen – Heimans Op maandag 30 mei is voor de hoofdingang van Ziekenhuis Rivierenland een ‘social sofa’ (bankje van mozaïek) onthuld. Het bankje is een herinnering aan twee jaar Corona Pandemie. Gemaakt door en […]

Stadspenning de Rotterdammert voor Ernst Kuipers
mei 31, 2022
Hij ontving de gemeentelijke onderscheiding op maandag 30 mei op zijn afscheidsbijeenkomst van het Erasmus Medisch Centrum (Erasmus MC) uit handen van burgemeester Ahmed Aboutaleb. De voormalig voorzitter Raad van Bestuur kreeg de Rotterdammert vanwege zijn bijzondere verdiensten voor de zorgsector in Rotterdam en omgeving. Prof. dr. E. J. Kuipers (1959) werkte 21 jaar bij […]

Ziekenhuis VieCuri deelt gratis zonnebrandcrème uit
mei 30, 2022
Dermatoloog Karen van Poppelen Huidkanker is de meest voorkomende vorm van kanker, ongeveer 1 op de 6 Nederlanders krijgt het. Melanoom, de meest agressieve vorm, is bovendien de snelst stijgende kanker in de leeftijdsgroep 30 tot 60 jaar. Het baart artsen grote zorgen. Zo ook Karen van Poppelen, dermatoloog bij ziekenhuis VieCuri. Haar motto: “Bescherm […]

Irmgard Borghouts nieuw lid raad van toezicht ETZ
mei 30, 2022
Prof. dr. I.W.C.M. (Irmgard) Borghouts (48) is met ingang van 1 juni 2022 benoemd als nieuw lid van de raad van toezicht van het ETZ (Elisabeth-TweeSteden Ziekenhuis) in Tilburg/Waalwijk. Irmgard Borghouts is hoogleraar HRM en Sociale Zekerheid aan Tilburg University. Daarvoor was ze senior onderzoeker bij onderzoeksinstituut ReflecT en principal consultant bij Ecorys. Ze wordt […]

Bibliotheek en ziekenhuis bieden samen cursus DigiVitaler aan
mei 30, 2022
Digitale toepassingen in de zorg komen steeds meer voor. Beeldbellen met de arts, je dossier bekijken in een patiëntenportaal, online medicijnen aanvragen: het is steeds gewoner. Om patiënten te helpen bij deze mogelijkheden, is er nu de cursus Digivitaler. Hiervoor hebben Ziekenhuis Rivierenland en Bibliotheek Rivierenland de handen ineen geslagen. Mensen krijgen steeds meer mogelijkheden […]

Noordwest selecteert MedicomZes en ULC voor nieuwbouw fase 1
mei 24, 2022
Noordwest Ziekenhuisgroep selecteert voor de realisatie van nieuwbouw fase 1 op haar locatie in Alkmaar MedicomZes en ULC Installatietechniek. MedicomZes is verantwoordelijk voor de bouwkundige werkzaamheden en coördinatie. ULC Installatietechniek verzorgt de aanleg van alle installaties. Peter Geerlings, projectdirecteur nieuwbouw: “Het komt in deze turbulente tijd, die grote impact heeft op de markt, aan op […]

Feestelijke opening buitenpoli WZA
mei 20, 2022
Met een knal en veel confetti heeft het WZA donderdag 19 mei feestelijk zijn nieuwe buitenpoli geopend. Deze is gevestigd in het geheel verbouwde Gezondheidscentrum Noorderpark aan de Molenstraat 262 in Assen. Voor het WZA is de moderne en ruime locatie een mooie stap richting ‘de juiste zorg op de juiste plek’. De buitenpoli is […]

Ikazia kleurt paars
mei 20, 2022
Op donderdagavond 19 mei, Wereld IBD-Dag, kleurt de toren van het Rotterdamse Ikazia Ziekenhuis paars. Daarmee vragen we aandacht voor de vele mensen die lijden aan IBD (Inflammatory Bowel Disease). IBD is een verzamelnaam voor mensen met de chronische darmontstekingsziekten colitis ulcerosa en de ziekte van Crohn. Wereldwijd krijgen gebouwen vandaag paarse schijnwerpers op zich gericht om […]

Gratis webinar: de Oogvereniging en Passend lezen
mei 19, 2022
Op dinsdag 28 juni van 16.00 – 17.00 uur geven de Oogvereniging en Passend Lezen een gratis webinar. Het webinar is ter gelegenheid van de gesproken versie van het boek Gezien dat vanaf nu beschikbaar is. Tijdens het webinar komt Marijke Osinga aan het woord over de totstandkoming van dit bijzondere boek. Daarnaast ontdekken deelnemers de mogelijkheden van […]

IC terugkomdagen voor ex-covid patiënten
mei 19, 2022
De intensive care in Haarlem Zuid organiseert de komende periode 2 terugkomdagen voor patiënten die de afgelopen 2 jaar opgenomen zijn geweest met of door corona. De terugkomdagen staan gepland op vrijdag 27 mei en vrijdag 3 juni. Wegens het grote aantal patiënten dat verwacht wordt staan op beide dagen staan 2 sessies gepland. Een sessie van 11:00 […]

Laserablatie bij epilepsie voor het eerst in Nederland uitgevoerd
mei 19, 2022
Afgelopen week is in het UMC Utrecht, voor het eerst in Nederland, bij twee patiënten met epilepsie een MRI-geleide laserablatie in de hersenen uitgevoerd. Patiënten uit Nederland die deze behandeling moeten ondergaan, waren tot voor kort aangewezen op Houston (USA) of Londen (UK). Vanwege de hoge kosten kwam hiervoor een minimaal aantal patiënten in aanmerking. […]

Jaarverslag 2021: Ondanks corona goede resultaten geboekt
mei 19, 2022
Het Maasstad Ziekenhuis heeft 2021 opnieuw afgesloten met positieve cijfers ondanks corona. Het resultaat van 8,6 miljoen euro is boven het begrote resultaat uitgekomen. Hierdoor komt het eigen vermogen van het ziekenhuis op 112 miljoen euro en de solvabiliteit op 32,04%. Daarmee heeft het ziekenhuis wederom een sterke financiele positie weten te bereiken. Peter Langenbach, […]

HappySoaps start met het opschudden van de Zweedse cosmeticamarkt!
mei 19, 2022
HappySoaps, het grootste 100% plasticvrije verzorgingsmerk van Nederland, is vanaf vandaag beschikbaar op de Zweedse markt. De recente crowdfundig waarbij er in recordtempo 1 miljoen euro werd ‘opgehaald’ maakt deze stap mogelijk. Naast Nederland en Vlaams België is dit het derde land waar de plasticvrije verzorgingsproducten worden aangeboden. De producten van HappySoaps zijn vanaf nu online beschikbaar […]

Jaap van den Heuvel nieuwe bestuurder ad interim Maasstad Ziekenhuis
mei 18, 2022
De raad van toezicht van het Maasstad Ziekenhuis heeft Jaap van den Heuvel per 23 mei 2022 benoemd als bestuurder a.i. voor een half jaar. Hij vormt daarmee samen met Wietske Vrijland de raad van bestuur. Jaap van den Heuvel volgt Peter Langenbach op, die per 1 juli start als directeur Zorginkoop bij zorgverzekeraar Zilveren Kruis. De […]

Noordwest Tour de Friends. Fiets mee voor een Magic Carpet en breng patiënten in het ziekenhuis in beweging
mei 17, 2022
Noordwest Ziekenhuisgroep organiseert, samen met Vrienden van Noordwest, op woensdag 13 juli de 1e editie van Noordwest Tour de Friends. Een uniek fietsevent in het ziekenhuis in Alkmaar om geld in te zamelen voor een Magic Carpet. Iedereen kan meefietsen. Beweeg je beter! met Magic Carpet Magic Carpet is een interactieve vloer- en tafelprojectie die […]
Ruime aandacht voor Duurzaamheid, Digitale Zorg en Gezondheid op vakbeurs Zorg & ICT tijdens Dutch Health Week
mei 17, 2022
Utrecht, 17 mei 2022 – Duurzaamheid, Digitale Zorg en Gezondheid; dat zijn de leidende thema’s tijdens de Dutch Health Week in Utrecht. Op de vakbeurs Zorg & ICT, die van 14 tot en met 16 juni in de Jaarbeurs wordt gehouden, is de Dutch Health Hub Arena ingericht, waar drie dagen lang sessies worden georganiseerd […]

Lectoraat onderzoekt hoe verpleegkundigen zich blijvend kunnen ontwikkelen
mei 17, 2022
Annemarie de Vos hoopt dat de onderzoekresultaten tot ver buiten de ziekenhuismuren van het ETZ reiken. De coronacrisis legde een nijpend probleem in de zorg bloot: een hoge uitstroom van verpleegkundigen in combinatie met een groeiend tekort. Een van de oorzaken is het gebrek aan ontwikkelingsmogelijkheden. Met de oprichting van het lectoraat ‘Continue professionele ontwikkeling […]

Innovatieve Revalidatie: Rijndam kijkt naar de toekomst EIT Health, de Europese innovatieversneller
mei 13, 2022
Dat technologie een volwaardig onderdeel is van revalidatiezorg bewijzen ze bij Rijndam. Onder het motto VerBaas Jezelf! biedt de instelling medisch specialistische revalidatiezorg aan. Met de bouw van een nieuw pand voor kinderrevalidatie wil Rijndam een stap maken met innovatieve oplossingen op het gebied van revalidatiezorg. Arjan van den Boom, divisiemanager kinderrevalidatie en projectleider van een nieuwbouwlocatie in Schiebroek, vertelt er meer over. ‘De realisatie van de nieuwbouw gaat gepaard met een groot project dat we technologiesprong noemen.’

Paddenstoelen lekker duurzaam
mei 12, 2022
Voor een duurzame en gezonde toekomst van ons voedsel zou de exotische paddenstoel weleens een grote rol kunnen spelen. De teelt is tegenwoordig lokaal, volledig biologisch en circulair. Het product is smaakvol, gezond, caloriearm en vegan. Bovendien kan je er alle kanten mee op: als alternatief voor vlees of vis, als groente of ingrediënt in […]

Hersenschade bij pasgeboren is veilig te behandelen met stamcellen
mei 12, 2022
Onderzoekers en artsen van het UMC Utrecht hebben een nieuwe vorm van stamceltherapie ontwikkeld voor pasgeborenen met hersenschade na een herseninfarct. De behandeling is erop gericht om het natuurlijke herstelvermogen van het babybrein te ondersteunen. Uit de studie blijkt dat stamcellen via neusdruppels veilig aan pasgeborenen kunnen worden toegediend. De bevindingen van de onderzoeksgroepen van […]

Psychische klachten grote onbekende bij schildklieraandoeningen
mei 10, 2022
Schildklier Organisatie Nederland (SON) vraagt in de Week van de Schildklier (19 t/m 25 mei) aandacht voor psychische klachten die kunnen optreden bij schildklieraandoeningen. Veel mensen met een te snel, te traag of niet werkende/verwijderde schildklier weten niet dat je, naast lichamelijke klachten, ook psychische klachten kunt hebben. Het gaat dan om angstaanvallen, stemmingswisselingen (kort lontje), […]

Voorlichtingsbijeenkomst niet-aangeboren hersenletsel
mei 10, 2022
We organiseren een informatiebijeenkomst over omgaan met gevolgen van een herseninfarct, hersenbloeding, TIA, ongeluk met hoofdletsel of hersenoperatie. Tevens gelegenheid tot lotgenotencontact en het stellen van vragen. Het thema is deze keer: Depressieve gevoelens bij NAH. Sanne Pelser (neuropsycholoog, Basalt) gaat in op dit onderwerp en zal uw vragen beantwoorden. Ad van Dongen, (ervaringsdeskundige) zal ook aanwezig zijn. Het is voor […]

Grote stap gezet in het vroegtijdig ontdekken van een glaucoom
mei 9, 2022
Onderzoekers zijn er, op initiatief van Het Oogziekenhuis Rotterdam, in geslaagd om met behulp van artificial intelligence (AI) de diagnose ‘glaucoom’ 35% beter te stellen. Glaucoom is een oogziekte die het gezichtsvermogen onherstelbaar aantast, soms zelfs leidend tot blindheid. Behandeling kan alleen zorgen dat het oog in het beste geval niet verder achteruitgaat. De ziekte […]

10 Mei – Pint of Science: Our Living World – From Cells, to Bats, to Humans?
mei 9, 2022
Pint of Science brengt onderzoekers naar de kroeg om te vertellen over de wetenschap van morgen. Pint of Science is een internationaal festival dat dit jaar in 25+ landen tegelijkertijd wordt georganiseerd. Het brengt onderzoekers naar de kroeg bij jou om de hoek, waar ze je vertellen over het laatste nieuws uit hun wetenschappelijke wereld. […]

Rijndam helpt vluchtelingen met medische achtergrond aan een baan
mei 3, 2022
In Nederland komen vluchtelingen met ervaring in de zorg nauwelijks aan een baan binnen deze sector ondanks de grote personeelstekorten. Rijndam wil statushouders met een medische achtergrond graag de kans geven om aan de slag te gaan. In samenwerking met VluchtelingenWerk Nederland benaderen zij gevluchte zorgprofessionals die graag weer in hun vak willen werken. Het […]

Superkleine hartritme-monitor werkt samen met patiënt via app
mei 2, 2022
Onlangs implanteerde de afdeling cardiologie van het Canisius Wilhelmina Ziekenhuis een nieuwe generatie onderhuidse hartritme-monitoren. Deze is superklein (45 x 7 mm), gaat langer mee dan zijn voorganger én geeft de patiënt zelf meer invloed. Als deze klachten heeft of iets niet vertrouwt, kan hij via een gekoppelde app zelf gegevens invoeren en naar het […]

Help mee politiek inclusief te maken
mei 2, 2022
De situatie in Oekraïne laat ons zien dat democratie en deelname aan de politiek niet vanzelfsprekend zijn. Zeker niet voor mensen met een beperking. Slechts 0,5% van de mensen die actief zijn in de politiek heeft een beperking terwijl 12% van de bevolking een beperking heeft. De deelname van mensen met een oogaandoening aan de […]

Maasstad Ziekenhuis gestart met hormoontherapie voor transgenderpersonen met genderdysforie
april 28, 2022
De afdeling Interne Geneeskunde van het Maasstad Ziekenhuis is in samenwerking met een aantal geestelijke gezondheidszorg (GGZ) instellingen gestart met het aanbieden van transgenderzorg. Volwassenen* waarbij de genderidentiteit niet overeenkomt met het biologisch geslacht, kunnen met een juiste diagnose en verwijzing van een ggz-instelling terecht in het Maasstad Ziekenhuis voor hormoontherapie en advies over vruchtbaarheid. […]

Met nieuwste technologie sneller zicht op jicht
april 25, 2022
Met de Raman spectroscoop gaat VieCuri onderzoek verrichten om betere diagnoses te kunnen stellen en behandeling te kunnen bieden bij kristalziekten zoals jicht. VieCuri Medisch Centrum beschikt als eerste ziekenhuis ter wereld over een Raman spectroscoop voor medische toepassingen. Het onderzoek dat hiermee start kan een impuls geven aan alle kristalziekten zoals bijvoorbeeld jicht. Doel […]

Interview Cathy van Beek
april 22, 2022
Tijdens het LSH010 ontbijt op 10 maart kwam naar voren dat de zorgsector verantwoordelijk is voor 7% van de landelijke CO2 uitstoot. Een aanzienlijk percentage. “Kortom, veel te winnen,” stelt Cathy van Beek strijdbaar. De ervaren zorgbestuurder en voorzitter van de recent opgerichte Rotterdamse Klimaattafel Gezondheidszorg ziet vooral veel kansen op het gebied van circulariteit. […]

Al bijna 400 Europese fitnesscentra committeren zich aan FITcert
april 22, 2022
Bijna 400 Europese fitnesscentra hebben in de afgelopen maanden de eerste twee stappen van het FITcert-programma succesvol afgerond. Hiermee tonen ze, in een zelfbeoordeling, dat ze aan de basiseisen van de Europese norm EN 17229:2019 voldoen. Certificerende instellingen voeren binnenkort de eerste onafhankelijke beoordelingen uit. Zo kunnen deze fitnesscentra het FITcert-certificaat krijgen. NEN heeft, in samenwerking […]

ETZ pakt depressie aan met magnetische hersenstimulatie
april 22, 2022
Samen met collega Dirk de Knijff voert psychiater Dieuwertje de Waardt een rTMS-behandeling uit. Veilig, pijnloos, effectief en vrijwel zonder bijwerkingen. Kenmerken van rTMS (Repetitieve Transcraniële Magnetische Stimulatie), een vrij nieuwe behandeling in het ETZ (Elisabeth-TweeSteden Ziekenhuis) voor mensen met een depressie, bij wie medicatie niet goed aanslaat. Bij een rTMS-behandeling plaatst de zorgprofessional een […]

Tweederde van de Nederlanders weet niets over separatorvlees: Foodwatch wil nieuwe voedselschandalen voorkomen.
april 22, 2022
Staat past regels voedselveiligheid niet toe. Een nieuwe opiniepeiling in opdracht van voedselwaakhond Foodwatch wijst uit dat 72% van de consumenten niet weet wat separatorvlees is. 74% van de respondenten weet niet in welke producten separatorvlees zit. Diepgravend onderzoek door Foodwatch wijst bovendien uit dat de Staat haar zaken niet op orde heeft als het gaat om […]

Rotterdams Klimaatfonds helpt non-profit organisaties met verduurzamen
april 22, 2022
Veel sportclubs, verenigingen en scholen willen energie besparen of schone energie opwekken en kunnen hierbij ondersteuning (advies of financiering) goed gebruiken. Speciaal daarvoor is er het Rotterdams Klimaatfonds. Met dit fonds wil de gemeente Rotterdam uiterlijk volgend jaar 4500 nieuwe zonnepanelen op daken van Rotterdamse non-profit organisaties hebben gerealiseerd. Goed voor een besparing van 8.600 […]

Bestuursvoorzitter WZA treedt af
april 22, 2022
Na drie intensieve jaren heeft Paul van der Wijk besloten om af te treden als bestuursvoorzitter van het WZA. De reden is dat hij een betere balans zoekt tussen werk en privé. Eduard Klasen, voorzitter raad van toezicht: “De raad van toezicht betreurt het zeer dat Paul het besluit heeft genomen om het WZA te […]

HappySoaps haalt in recordtempo 1 miljoen euro op met crowdfunding
april 19, 2022
HappySoaps, het grootste 100% plasticvrije verzorgingsmerk van Nederland heeftin record tempo 1 miljoen euro opgehaald dankzij een crowdfunding via het platform CrowdAboutNow. Met het benodigde geld wil HappySoaps nieuwe producten ontwikkelen en definitief doorbreken in Europa, startend met Scandinavië. Het doel is om HappySoaps verkrijgbaar te maken in twaalf Europese landen. In totaal zijn al […]

Blijven bewegen in Ikazia
april 12, 2022
In het Rotterdamse Ikazia Ziekenhuis weten ze het zeker, bewegen heeft een positief effect op lichaam en geest. Voor en na een operatie of tijdens het ziek zijn is bewegen vaak het laatste waaraan gedacht wordt. Toch vindt Ikazia dat bewegen juist een belangrijke bijdrage levert aan het herstel van een patiënt.Tijdens een ziekenhuisverblijf liggen […]

Nog eens 78 onderzoekers ontvangen NWO-Venibeurs
april 11, 2022
Nog eens 78 veelbelovende jonge wetenschappers ontvangen van NWO Veni-financiering van maximaal 280.000 euro. Het gaat om zestig onderzoekers uit het domein Sociale en Geesteswetenschappen (SGW) en achttien uit de Toegepaste en Technische Wetenschappen (TTW), die de komende drie jaar hun eigen onderzoeksideeën verder kunnen ontwikkelen. Hoe heeft olie de verhoudingen in de wereld veranderd? […]

“Ik wil nog wel wat jaren mee”
april 7, 2022
Meneer De Groen (60) is ondernemer en Bosschenaar in hart en nieren. Hij is er graag voor anderen en houdt van positieve mensen om zich heen. Een bourgondisch leven en de nodige stress spelen hem echter parten. Wanneer hij op de eerste hulp terecht komt en opgenomen wordt in het Jeroen Bosch Ziekenhuis (JBZ), realiseert […]

HappySoaps haalt vier ton op voor uitbreiding 100% plasticvrije en natuurlijke verzorgingsproducten
april 5, 2022
Utrecht, 5 april 2022 – HappySoaps, de producent van 100% plasticvrije en natuurlijke verzorgingsproducten, heeft 400.000 euro opgehaald dankzij een crowdfunding via het platform CrowdAboutNow. In een week tijd hebben ruim 380 mensen in het bedrijf geïnvesteerd. Hoewel het streefbedrag is behaald, kan er nog tot maximaal 800.000 euro worden geïnvesteerd. Met het bedrag dat ze […]

Campagne ‘Grip op je Geld’ van start met actieplan voor speciale energiehulproute
april 5, 2022
ROTTERDAM – Maandag 28 maart lanceerde Hare Majesteit Koningin Máxima, erevoorzitter van SchuldenlabNL, de campagne ‘Grip op je geld’. De landelijke campagne heeft tot doel om mensen grip op hun geld te geven, via het platform Geldfit.nl. Daarnaast presenteerden energiebedrijven Eneco, Essent, Greenchoice en Vattenfall samen met NSR (Nederlandse Schuldhulproute) en SchuldenLabNL een actieplan voor een speciale ‘energiehulproute’. […]

De overgang op de werkvloer: grote impact, weinig besproken
april 4, 2022
Opvliegers en vermoeidheid, maar wij vrouwen gaan door. Alle balletjes in de lucht houden. Ook op de werkvloer. Onafhankelijk onderzoeksbureau Markteffect deed in opdracht van A.Vogel uitgebreid onderzoek naar de invloed van de overgang op de werkende vrouw. Bijna de helft (47%) van de werkende vrouwen tussen 45 en 60 jaar met overgangsverschijnselen beaamt het: […]

Ikazia publiceert sociaal jaarverslag 2021
april 1, 2022
Het Rotterdamse Ikazia Ziekenhuis publiceert haar sociaal jaarverslag 2021 in de vorm van een online magazine met interviews, podcasts en filmpjes. In het sociaal jaarverslag 2021 van Ikazia wordt teruggeblikt op een hectisch jaar. Een jaar waarin COVID een grote rol speelde maar dat ook mooie momenten kende, zoals de toekenning van het Qualicor-certificaat Goud. […]

Interview Marylou van der Klooster – Health innovation school Rotterdam 2022
maart 30, 2022
Een innovatieve opleiding om te leren innoveren. Vijftig gedreven mensen uit alle lagen van de zorg innoveerden samen zes maanden lang in actieprojecten om zo de fijne kneepjes van innovatie te leren. De Health Innovation School Rotterdam bood net als in 2020 ook afgelopen jaar weer een opleiding vol met actie, kennis en inspiratie.

ETZ versterkt medezeggenschap Cliëntenraad
maart 30, 2022
De nieuwe Medezeggenschapsregeling wordt ondertekend door (v.l.n.r.) Esther Donga, Marijke Megens en Bart Berden. De Cliëntenraad van het ETZ, de Raad van Bestuur en het MSB hebben onlangs de nieuwe Medezeggenschapsregeling ondertekend. Hierdoor gaat één Cliëntenraad zowel de Raad van Bestuur als het MSB adviseren. Het ETZ heeft – net als elk ziekenhuis in Nederland […]

Hulp voor Oekraïense vluchtelingen met een oogaandoening van start
maart 30, 2022
Een oorlog ontvluchten en je weg vinden in een ander land: het is altijd een sprong in het diepe, en al helemaal als je ogen niet goed meewerken. Naar verwachting komen in Nederland meer dan duizend vluchtelingen uit Oekraïne die blind of slechtziend zijn en nog eens duizenden met andere oogproblemen. Samen met Nina Spodina, […]

Erasmus MC en Rijndam gaan samenwerken aan innovaties voor zorgpersoneel
maart 29, 2022
Johanneke Mulder, themadirecteur Erasmus MC (links) en Evelyn Lindeman, bestuursvoorzitter Rijndam Revalidatie (rechts) ondertekenen de intentieverklaring. Rijndam Revalidatie en Erasmus MC-Create4Care hebben een intentieverklaring getekend om samen te werken aan oplossingen voor praktijkproblemen die zorgverleners (op)merken tijdens hun dagelijkse werk. Create4Care is een ‘prototyping’ studio van het Erasmus MC op het gebied van zorginnovaties. De samenwerking […]

Noordwest locatie Alkmaar start met gezonde en duurzame voeding vanuit eigen keuken
maart 29, 2022
Foto: Pierre Mettes Na de locatie Den Helder is nu ook locatie Alkmaar van Noordwest Ziekenhuisgroep gestart met aantrekkelijke, gezonde en lekkere voeding in het ziekenhuis. Goede voeding draagt bij aan de kwaliteit van het verblijf en een sneller herstel van de patiënt. Daarom worden de avondmaaltijden voor patiënten op ook op locatie Alkmaar vanaf […]

Peter Langenbach neemt afscheid als voorzitter raad van bestuur Maasstad Ziekenhuis
maart 29, 2022
Na ruim 6,5 jaar voorzitter van de raad van bestuur van het Maasstad Ziekenhuis te zijn geweest, start Peter Langenbach per 1 juli als directeur Zorginkoop bij zorgverzekeraar Zilveren Kruis, onderdeel van Achmea. Peter: “Voor mij is dit een hele moeilijke beslissing geweest want ik heb met heel veel plezier in het Maasstad Ziekenhuis gewerkt. […]

Louey (10) is de eerste kinderburgemeester van Rotterdam!
maart 25, 2022
Op vrijdag 25 maart 2022 vond de selectiedag plaats van de kinderburgemeester in het Stadhuis van Rotterdam. Uit 100 aanmeldingen werden 5 kandidaten gekozen. Zij gingen in de raadszaal in gesprek met een deskundige jury over verschillende thema’s die de stad bezighouden. Hoewel alle kandidaten fantastisch waren, heeft de 10-jarige Louey Zerourou uit groep 7 […]

Dr. Laura Baams ontvangt de prestigieuze Van Emde Boas van Ussel Prijs
maart 25, 2022
Op het NVVS Voorjaarscongres 2022 Seksualiteit in the Spotlight te Utrecht heeft de Nederlandse Wetenschappelijke Vereniging Voor Seksuologie (NVVS) vrijdag 25 maart 2022 de Van Emde Boas – Van Ussel-Prijs uitgereikt aan dr. Laura Baams, universitair docent bij de afdeling Pedagogiek en Pedagogische Wetenschappen aan de Rijksuniversiteit Groningen. “Na rijp beraad heeft de jury besloten […]

Corona-zelftests nauwkeuriger bij monsterafname uit neus én keel
maart 25, 2022
Nederlands onderzoek heeft uitgewezen dat tijdens de periode dat de Omicron variant van het coronavirus dominant werd, de nauwkeurigheid afnam van drie corona-zelftests waarbij een monster met een wattenstaafje uit de neus wordt afgenomen. Echter, het zelf afnemen van een monster uit zowel de neus- als keelholte leidde tot een duidelijke toename van de nauwkeurigheid […]

ETZ bouwt op locatie Elisabeth ziekenhuis van de toekomst
maart 24, 2022
Deze impressie laat zien hoe de nieuwbouw aan de achterzijde van ETZ Elisabeth via een gang verbonden kan worden met het bestaande gebouw. In de nieuwbouw van het ETZ (Elisabeth-TweeSteden Ziekenhuis) in Tilburg komen onder meer een beddenhuis met zes verdiepingen en zes extra operatiekamers. De eerste fase van de nieuwbouw op locatie ETZ Elisabeth wordt […]

Heel Rotterdam gezonder met de VITR Vitaalscan
maart 23, 2022
Rotterdam, 23 maart 2022 – Rotterdam heeft een primeur met stadsbrede leefstijlinterventie: met de online VITR Vitaalscan kunnen alle Rotterdammers vanaf nu meer inzicht krijgen in hun eigen gezondheid en gezondheidsrisico’s De VITR Vitaalscan, ontwikkeld door SmartVitaal, wordt gratis aangeboden aan alle Rotterdammers. De scan heeft een Nederlandse, Engelse, Arabische, Turkse en Spaanse versie en kan in die […]

ETZ eerste ziekenhuis in Nederland dat intekent voor operatierobot ‘Hugo’
maart 23, 2022
Bestuurder Anita Wydoodt zet samen met Benelux directeur Henk Westendorp van Medtronic haar handtekening onder de overeenkomst voor de aanschaf van de Hugo. Medtronic is een gespecialiseerd bedrijf op het gebied van medische technologie. Op de achtergrond staan v.l.n.r.: Karl van Ginderdeuren – Business developer Surgical Robotics Benelux – Medtronic Hoofd afdeling Inkoop Kim Boots, Richard […]

Veel 50-plussers hebben nog net zo veel zin in seks als vroeger
maart 22, 2022
‘De schaamte voorbij. Geen taboes meer’ Zin Magazine hield een seksenquête onder haar lezers met opzienbarende resultaten. Van soloseks tot multiseks, van tantra tot seksspeeltjes: er gebeurt nog heel wat in het seniorenbed. Zin, hét magazine voor de tijd van je leven, verrijkt, inspireert en blijft verbazen. Zin Magazine 5, met het grote Zin Seksdossier, […]

Vernieuwd elektronisch patiëntendossier voor Streekziekenhuis Koningin Beatrix
maart 22, 2022
Winterswijk, 22 maart 2022 Streekziekenhuis Koningin Beatrix (SKB) vernieuwt het huidige elektronisch patiëntendossier (EPD), HiX van softwareleverancier ChipSoft. Op dinsdag 22 maart zette SKB bestuurder Inge de Wit samen met de directie van ChipSoft haar handtekening onder een upgrade die veel voordelen biedt voor patiënten. Ook maakt het vernieuwde EPD de samenwerking met ketenpartners, zoals […]

TU Delft en Maasstad Ziekenhuis maken eerste medisch product van ziekenhuisafval
maart 16, 2022
Instrumentenopener Delftse onderzoekers onderzochten samen met het Maasstad Ziekenhuis hoe ze van afval uit operatiekamers nieuwe medische producten kunnen vervaardigen. Het resultaat is de productie van een instrumentenopener. Het is het eerste medische product ter wereld dat volledig gemaakt is van ziekenhuisafval. De wetenschappers van TU Delft en het Maasstad Ziekenhuis leveren hiermee een bijdrage […]

Nieuwe grensverleggende contactlens
maart 15, 2022
Bausch + Lomb introduceert innovatieve ULTRA®ONE DAY daglens Voor de nieuwe Bausch + Lomb ULTRA®ONE DAY daglens is een speciaal lensmateriaal ontwikkeld. Dit materiaal bevat twee innovatieve, met elkaar samenwerkende, technologieën. Ze zorgen ervoor dat de lens tenminste 16 uur lang 96% van het vocht vasthoudt en dat er gedurende het dragen, naar behoefte, stoffen afgegeven worden voor […]

22 Vici-beurzen voor vooraanstaande wetenschappers
maart 15, 2022
EMBARGO tot dinsdag 15 maart 2022 – 9 am Van onderzoek naar de hersenen van mensen in stressvolle situaties naar het stress management van planten: zomaar twee voorbeelden van onderzoeksprojecten die voortgang krijgen door de NWO-Vici-beurzen. In totaal zijn er 22 vooraanstaande wetenschappers uit de wetenschapsdomeinen Exacte en Natuurwetenschappen (ENW) en Sociale Geesteswetenschappen (SGW) die […]

Health Technology Sessie
maart 14, 2022
Vrijdagmiddag 1 april organiseert de Rotterdam eHealth Agenda in samenwerking met de gemeente Rotterdam een verdiepende werksessie HTA (Health Technology Assessment). Deze sessie wordt geleid door Silvia Evers (Professor of Public Health Technology Assessment) en Ruben Drost (Assistent professor en HTA deskundige); beiden verbonden aan de Universiteit van Maastricht. In deze exclusieve werksessie is er […]

Rotterdam start samenwerking zorgpreventie in de wijk
maart 14, 2022
Fotograaf: David Rozing Op donderdag 10 maart trapten Rijnmond dokters, stichting DOCK, SOL Welzijn, Pit010, zorgverzekeraar Zilveren Kruis en de gemeente Rotterdam de samenwerking preventie in de wijken af. De professionele zorg- en hulpverleners in de wijk gaan op het gebied van gezondheid en leefstijl intensiever samenwerken. Met als doel Rotterdammers eerder ondersteuning te bieden […]


22 september – Pitch Masterclass
maart 11, 2022
Thursday 22 September Want to learn to pitch better? Attend the Healthy Funding Pitch Masterclass! Thursday September 22, from 15.00 to 17.00. After the great succes of the Pitch masterclass from David Beckett @best3minutes last November, we have immediately planned new dates for 2022! On Thursday September 22, David Beckett will give the Pitch masterclass again! Register now for […]

10 mei – Masterclass Early Stage Funding
maart 11, 2022
Tuesday 10 May – 15.00 – 17.00 You are most welcome to join us and learn about funding options for your company. For companies in Life Sciences this involves particular challenges. Three speakers will share their expertise and experience to introduce you to various forms of early stage funding: typically grants, private investors and loans. You […]

Toon Hermans Huis opent vestiging in VieCuri Venray
maart 11, 2022
Vanaf 14 maart start het Toon Hermans Huis met een locatie in VieCuri Venray. Deze vestiging biedt als eerste in Nederland volledige ambulante zorg. Mensen met kanker uit Venray en omgeving en hun naasten krijgen thuis ondersteuning aangeboden in plaats van in een inloophuis. Het Toon Hermans Huis in Venlo merkt dat mensen uit omliggende […]

Wereld Slaapdag 2022: Hoe ademhaling de oplossing kan zijn voor alle slechte slapers
maart 10, 2022
Bijna een kwart van de Nederlanders kampt met slaapproblemen. 40 procent hiervan zegt zelfs zó slecht te slapen dat het het dagelijks functioneren belemmert. En terwijl de slaapmiddelen als warme broodjes over de toonbank vliegen, gaan we voorbij aan de grootste oorzaak: stress en angst. Hoe kan je ademhaling hiervoor een oplossing bieden? Vrijdag 18 […]

IJzertekort opgespoord door algoritme
maart 10, 2022
Steef Kurstjens, klinisch chemicus in opleiding in het JBZ en ontwikkelaar van het algoritme. Wereldwijd hebben 1,2 miljard mensen last van bloedarmoede. Vooral kinderen en vrouwen in hun vruchtbare levensjaren. Klachten zijn onder meer hoofdpijn, moeheid, duizeligheid en kortademigheid. In veruit de meeste gevallen van bloedarmoede is ijzergebrek de boosdoener. Dit tekort kan leiden tot ontwikkelingsstoornissen […]

Gemeenteraadsverkiezingen: blinden en slechtzienden willen kiezen hoe ze kiezen
maart 10, 2022
Van toegankelijke naar inclusieve verkiezingen Op 16 maart 2022 gaat Nederland weer naar de stembus voor de Gemeenteraadsverkiezingen. Voor de meeste mensen is dit de normaalste zaak van de wereld. Voor veel blinden en slechtzienden is stemmen nog altijd erg lastig. De Oogvereniging zet zich in voor inclusieve verkiezingen met keuzevrijheid. Niet alleen voor de […]

Rotterdamse fondsen en gemeente bekrachtigen samenwerking
maart 9, 2022
De gemeente Rotterdam en de Vereniging Rotterdamse Fondsen hebben hun streven om Rotterdam mooier, beter en socialer te maken herbevestigd. Dat gebeurde gistermiddag met de gezamenlijke ondertekening van een convenant in de Burgerzaal van het Rotterdamse stadhuis. Het convenant was eind 2019 al tot stand gekomen, maar vanwege de coronamaatregelen was er nog geen gelegenheid […]

Plannen voor nieuw regionaal gezondheidscentrum en woningbouw op ziekenhuisterrein ETZ Waalwijk
maart 8, 2022
Tilburg, 8 maart 2022 Op het terrein van het Elisabeth-TweeSteden Ziekenhuis (ETZ) aan de Kasteellaan in Waalwijk komen op termijn een nieuw regionaal gezondheidscentrum en maximaal 195 woningen (sociale huur en koop), exclusief zorgwoningen. Het college legt het omgevingsplan te zijner tijd voor aan de gemeenteraad. Het ETZ en Mijzo willen met de Nota van Uitgangspunten […]

Lancering verfilming Hechting tegen vrouwelijke genitale verminking
maart 8, 2022
Om vrouwelijke genitale verminking (meisjesbesnijdenis) bespreekbaar te maken, spelen ervaringsdeskundige acteurs het theaterstuk Hechting in scholen, buurthuizen en voor professionals in en rond Rotterdam en Den Haag. Om de boodschap nog intensiever te kunnen verspreiden is er nu ook een filmversie van het toneelstuk. De film is gemaakt in opdracht van de gemeente Rotterdam in […]

Studie toont aan: heupoperatie niet altijd winst voor zeer kwetsbare oudere
maart 7, 2022
Het opereren van een gebroken heup bij zeer kwetsbare ouderen die in een verpleeghuis wonen is niet altijd van toegevoegde waarde. Dat blijkt uit de FRAIL-HIP studie die werd verricht in 25 ziekenhuizen, onder leiding van een projectgroep bestaande uit Noordwest Ziekenhuisgroep, het Erasmus MC, Amsterdam UMC, Elisabeth-Tweesteden Ziekenhuis, Leids Universitair Medisch Centrum, Isala Klinieken […]

Joris Uges start als nieuwe bestuurder Rijndam
maart 7, 2022
Jorig Uges is per 1 april 2022 nieuw lid Raad van Bestuur bij Rijndam Revalidatie. De Raad van Toezicht benoemt Joris Uges per 1 april als bestuurder van Rijndam Revalidatie. De Raad van Toezicht is ervan overtuigd in Joris Uges de juiste bestuurder te hebben gevonden die verder invulling kan geven aan de strategische koers […]

Rotterdamse Qauntib kan wereld veroveren na overname door Radnet
maart 3, 2022
‘Een snellere diagnose en betere behandeling van kanker en dementie, dát is ons doel’ Erasmus MC ‘spin-out’ Quantib ontwikkelt geavanceerde software om beeldmateriaal als MRI-scans van de hersenen en prostaat snel en objectief te analyseren. Tien jaar na de oprichting is het Rotterdamse bedrijf overgenomen door Radnet, Amerika’s grootste leverancier van poliklinische radiologische beeldvorming. Hierdoor […]

Glaucoom: Krijg geen spijt, check op tijd
maart 2, 2022
Hoge oogdruk, verminderd gezichtsveld; het zijn gevolgen van de oogaandoening glaucoom. In 2020 waren er bij de huisarts 338.500 mensen bekend met glaucoom. Het is daarmee de meest voorkomende oogziekte in Nederland. 25% van de glaucoom patiënten is bij overlijden blind aan één oog, 10% aan beide ogen. Tijdige opsporing en behandeling kan blijvende schade […]

12 wetenschappers ontvangen NWO-Vici
februari 28, 2022
Den Haag, 28 februari 2022 12 vooraanstaande wetenschappers uit de wetenschapsdomeinen Toegepaste en Technische wetenschappen (TTW) en Gezondheidsonderzoek en Zorginnovatie (ZonMw) ontvangen een Vici-financiering van maximaal 1,5 miljoen euro. Hiermee kunnen de laureaten gedurende vijf jaar een vernieuwende onderzoekslijn ontwikkelen en een eigen onderzoeksgroep opbouwen. Vici is een van de grootste persoonsgebonden wetenschappelijke premies van […]

Foodwatch vs. McDonald’s: kinderidolen op insta en website mogen niet
februari 25, 2022
Commissie wil zich niet uitspreken over grijsgebied kindermarketing In juni afgelopen jaar heeft foodwatch een klacht ingediend bij de Reclame Code Commissie (RCC) tegen de online kindermarketing van McDonald’s op Instagram, YouTube, TikTok en de website van het bedrijf. Zo heeft de voedselwaakhond McDonald’s betrapt op reclame voor Happy Meals op Instagram met bekende kinderidolen […]

MET ‘GEDEELDE ZORG’ DE TOEKOMST TEGEMOET
februari 25, 2022
*huisartsencoöperatie Mediis, Apotheken Coöperatie Samenwerkende Apotheken Midden-Holland, ZorgBrug, Basalt revalidatie, Kwintes, Kernkracht, stichting Kwadraad, Coöperatie Fysiotherapeuten Midden-Holland, Lelie zorggroep, Cedrah, De Zellingen, Huize Winterdijk en Sanare zorg & welzijn. Onder de noemer Gedeelde Zorg slaan de zorgaanbieders en gemeenten uit Midden-Holland de handen ineen. Het moet dé oplossing bieden voor de stijgende vraag naar zorg […]

Potentiële verontreiniging met giftige minerale olie Foodwatch haalt door heel Europa Knorr bouillonblokjes uit de schappen
februari 23, 2022
Voedselwaakhond foodwatch heeft in verschillende Europese supermarkten de schappen van Knorr bouillonblokjes leeggehaald om consumenten te beschermen tegen gevaarlijke minerale oliën. Foodwatch beschuldigt Knorr-fabrikant Unilever ervan de producten te blijven verkopen ondanks dat laboratoriumtests een verontreiniging met zogenaamde aromatische minerale oliën (MOAH) hebben aangetoond. Deze minerale oliën zijn potentieel kankerverwekkend en genotoxisch. Foto: Videostill van foodwatch-actie […]

Hart voor de Stad: HMC en HagaZiekenhuis intensiveren samenwerking cardiologische zorg in Den Haag
februari 22, 2022
DEN HAAG – Onder het motto ‘Hart voor de stad’ gaan HMC en het HagaZiekenhuis nauwer samenwerken om de cardiologische zorg voor patiënten in de regio doelmatig en kwalitatief hoogwaardig te organiseren. Dankzij de topklinische samenwerking kunnen hartpatiënten voor alle cardiologische zorg ook in hun eigen stad terecht. Voordelen voor hartpatiënten Hartpatiënten merken op verschillende […]

Antibiotica direct na de geboorte bij baby’s ongunstig voor gezonde darmbacteriën
februari 18, 2022
Dit blijkt uit recent onderzoek, mede uitgevoerd door kinderarts en hoofdonderzoeker Marlies van Houten van het Spaarne Gasthuis. De behandeling van pasgeborenen met antibiotica in de eerste week van het leven zorgt voor een daling in gezonde bacteriën die nodig zijn voor onder andere het verteren van melk. Dit blijkt uit recent onderzoek, mede uitgevoerd […]

Programma 22 februari Webinar Trauma
februari 15, 2022
Locatie: OnlineDatum: Dinsdag 22 februariTijd: 13.30 – 14.15 Trauma, wat is de impact op iemand en hoe kun je helpen. Een schokkende gebeurtenis kan iedereen zomaar overkomen. De impact ervan kan groot zijn. Je krijgt te maken met allerlei lichamelijke, emotionele en mentale reacties. Als leidinggevende, collega of vrijwilliger wil […]

Oud-Olympiër lanceert nieuwe app tegen vermoeidheid
februari 14, 2022
Valentijnsdag: zorg goed voor jezelf met deze nieuwe app Menselijke stem in app helpt jou om vermoeidheid en burn-out tegen te gaan Rotterdam, 14 februari 2022 – Geen nee kunnen zeggen, regelmatig overwerken, een druk sociaal leven en de constante prikkels van sociale media. Het zijn allemaal factoren die activiteit opleveren voor je lichaam en geest. […]

Winactie: win 3 lifestyle boeken
februari 10, 2022
Het is 2022! Na de drukte van de feestdagen is het nieuwe jaar het perfecte moment om nieuwe voornemens te maken. Wat is er beter dan de tijd nemen voor je mentale gezondheid, mindfulness en fysieke gezondheid? Wij geven samen met de uitgever: Gottmer Uitgevers Groep maar liefst 3 lifestyle, mindfulness en gezondheid boeken weg! […]

REGISTER for the Water Summit for Global Development – 15 March, TU Delft Aula
februari 9, 2022
Join us on 15 March 2022 for a small-scale** but high level “Water Summit for Global Development 2022” in the Delft University of Technology Aula. We invite researchers, practitioners, policy makers, students, and volunteers to discuss how multidisciplinary science, technology, policy and innovation can improve access to water, and how we can achieve this together. ** […]

Patiënten met obesitas vervroegd naar huis met slimme sensor van Philips
februari 9, 2022
De Nederlandse Obesitas Kliniek (NOK) start in samenwerking met het Groene Hart Ziekenhuis en Philips met thuismonitoring van patiënten na een maagverkleining. Dit gebeurt met de draagbare Healthdot sensor. Hierdoor kunnen patiënten sneller naar huis om in hun vertrouwde omgeving verder te herstellen. Ook kan de NOK zorg blijven geven aan deze patiënten. “Samen met […]

HappySoaps gaat de strijd aan met gevestigde orde in het schoonmaakkastje
februari 7, 2022
‘Cleaning Tabs’ moeten aankoop van 20 plastic schoonmaakflessen per huishouden voorkomen Apeldoorn, 3 februari 2022 HappySoaps, het grootste 100% plasticvrije verzorgingsmerk van Nederland komt met een compleet nieuwe schoonmaaklijn en gaat daarmee de strijd aan met gevestigde schoonmaakmiddelen. Na de badkamer wil het bedrijf nu het gehele huishouden plasticvrij maken. Alles-, glas-, sanitair- en keukenreiniger zijn […]

Tijdelijke vaccinatielocatie GGD bij VieCuri Venlo
februari 7, 2022
VieCuri is het eerste ziekenhuis in Limburg waar de GGD een ‘pop-up-vaccinatielocatie’ opent. De GGD Limburg-Noord gaat in samenwerking met VieCuri coronavaccinaties aanbieden aan patiënten en bezoekers. Daartoe opent de GGD op maandag 7 februari een tijdelijke vaccinatiepost in de hal van het ziekenhuis in Venlo. De vaccinatielocatie is geopend op werkdagen van 9.00-16.00u. De […]

Rotterdamse eHealth Week van start Kom eHealth ervaren in Rotterdam
februari 7, 2022
Rotterdam, 4 februari 2022 – Van maandag 7 februari tot en met vrijdag 11 februari organiseert de Rotterdam eHealth Agenda samen met diverse partners uit de stad de Rotterdamse eHealth Week. Tijdens deze week kan je door de gehele stad heen kennismaken met allerlei inspirerende toepassingen van eHealth. Ga bijvoorbeeld op dinsdag 8 februari naar […]

Digitaal contact helpt patiënt in een onzekere tijd
februari 3, 2022
Digitalisering in de zorg wordt steeds belangrijker voor onze gezondheidszorg en de ontwikkelingen blijven doorgaan. Zo werkt het Rotterdamse Ikazia Ziekenhuis al enige tijd met verschillende apps om zorg op afstand te verlenen en de informatievoorziening beter bij de patiënt aan te laten sluiten. Daar is nu aan toegevoegd dat patiënten, die na hartfalen ontslagen […]

Ziekenhuis Rivierenland start buddyproject bij kanker
februari 3, 2022
Wie de diagnose kanker krijgt, kan overspoeld raken door gevoelens van angst en onzekerheid. Hoe verwerk je de diagnose, wat staat je te wachten en hoe ga je om met de gevolgen van een behandeling? Contact met een ervaringsdeskundige of lotgenoot kan dan heel waardevol zijn. Om zo iemand te vinden, kunnen mensen met kanker […]

Nieuwe Erasmus MC Campus gaat samen met gezonde en groene leefomgeving
februari 3, 2022
Het Erasmus MC krijgt een campus. De campus wordt een levendige plek waar gezondheidszorg, technologie en ondernemerschap samenkomen en ruimte vinden in (nieuwe) gebouwen. Zorgorganisaties, innovatieve bedrijven op het gebied van gezondheid en technologie, onderwijs- en onderzoeksinstellingen werken hier in de toekomst samen om de nieuwste technologische ontwikkelingen in de praktijk te brengen. Dit staat […]

Betere samenwerking palliatieve zorg leidt tot minder ziekenhuis- en IC-opnames
januari 31, 2022
Utrecht, 25 januari – In regio’s waar zorgaanbieders, zoals wijkverpleging, huisarts, hospices en ziekenhuis in de palliatieve fase intensief samenwerken ontvangen patiënten vaker passende zorg, wat leidt tot minder ziekenhuisopnames. Patiënten en naasten ervaren daarmee een waardiger afscheid, terwijl de zorgkosten niet stijgen. Dat blijkt uit onderzoek van Palliatieve Zorg Nederland (PZNL) waarin patiëntdata van […]

Specialisten ouderengeneeskunde versterken SEH van HMC
januari 31, 2022
Den Haag – De Spoedeisende Hulp van Haaglanden Medisch Centrum (HMC) wordt vanaf 1 februari versterkt met twee specialisten ouderengeneeskunde. De specialisten beoordelen met hun expertise of vaak langdurige ziekenhuisopnames voor kwetsbare ouderen kunnen worden voorkomen. Een extra hulpmiddel dat HMC heeft ontwikkeld ondersteunt de artsen en verpleegkundigen hierbij. De Spoedeisende Hulp van HMC Westeinde […]

Biocheck en Matrix fitness: krachtig partnership
januari 31, 2022
Alle fitnesstoestellen die bij BioCheck in de trainingsruimte staan, zijn geleverd door Matrix Fitness. Maar het bedrijf is veel meer dan een leverancier; het is een strategisch partner die vanaf het begin betrokken is. Daarmee versterkt Matrix Fitness zowel de positie van BioCheck als die van zichzelf, vertellen Anne-Marie Kuiper en Bastiaan Pieroelie van Matrix. […]

Zorg patiënten Jeroen Bosch Ziekenhuis op andere locatie ingehaald
januari 27, 2022
In de afgelopen periode is door corona voor veel patiënten de operatie uitgesteld. Zo ook voor patiënten van het Jeroen Bosch Ziekenhuis (JBZ). Dat is erg vervelend voor hen, zeker omdat dit betekent dat zij langer met klachten rondlopen. De zorgprofessionals van het Jeroen Bosch Ziekenhuis (JBZ) zoeken dan ook voortdurend naar creatieve oplossingen om […]

RIVM-schijnwerper op Voel je goed! voor laaggeletterden met ongezonde leefstijl
januari 27, 2022
Het RIVM zet de aanpak Voel je goed! in de schijnwerpers. Deze aanpak van Stichting Lezen en Schrijven richt zich op mensen die gezonder willen leven en moeite hebben met lezen, schrijven, rekenen en/of digitale vaardigheden. Voel je goed! combineert daarom gezondheidsvaardigheden met basisvaardigheden. Het RIVM zet in totaal 10 door hen erkende interventies in de schijnwerpers. Dat betekent dat ze?van goede kwaliteit zijn […]

International Conference on Ophthalmic Photography (ICOP) 2023
januari 27, 2022
Interested in ophthalmic photography, ophthalmic imaging or medical and biological illustration? Attend ICOP2023! ICOP, the International Conference on Ophthalmic Photography, will take place in April 2023, hosted by The Rotterdam Eye Hospital and the Dutch Ophthalmic Photographers Society, in the beautiful city of Rotterdam, The Netherlands! Read more.

Wetenschapsagenda 24 – 28 januari
januari 26, 2022
Jorn Meekel: Biomechanics of Living Aortic Tissue to Predict Aneurysm Progression Promotie (VU), 11:45 u, Auditorium Van Meekel stelde met zijn onderzoek een nieuw experimenteel onderzoeksprotocol vast om levend, menselijk, aortaweefsel te bestuderen. Met als doel beter inzicht te krijgen in de onbekende oorzaken van verwijde buikslagaders, zogenaamde abdominale aorta-aneurysma’s (AAA). De precieze wegen die […]

Rotterdamse eHealth Week
januari 25, 2022
Ook in 2022 organiseren we weer een Rotterdamse eHealth Week als onderdeel van de landelijke Slimme Zorgestafette. Door de gehele stad heen worden gedurende de week van 7 t/m 11 februari diverse activiteiten georganiseerd. Zo ook het Rotterdams eHealth Ontbijt op donderdag 10 februari! Bekijk de activiteiten tijdens de landelijke Slimme Zorgestafette hier: slimmezorgestafette2022.nl Organiseer jij […]

GHZ heeft onlangs stap gezet in integratie van ondersteuning zorgprocessen in EPD
januari 25, 2022
Het Groene Hart Ziekenhuis (GHZ) heeft onlangs weer een stap gezet in de integratie van ondersteuning van zorgprocessen in het EPD. In december vorige jaar zijn de OK en de CSA en alle plannings- en controle processen die daarbij horen overgegaan op de NEXUS-suite. Door de implementatie van Workspace OK, WorkSpace Anesthesie en de CSA […]

Rotterdams eHealth Ontbijt
januari 25, 2022
Hoe mooi is het als alle Rotterdammers in 2030 eenvoudig en makkelijk gezond (kunnen) blijven? Welke transitie is noodzakelijk om de zorg van de toekomst betaalbaar en kwalitatief van hoog niveau te houden? Welke rol speelt eHealth daarbij? Op donderdag 10 februari organiseren we weer voor de vierde keer het Rotterdams eHealth Ontbijt. Vele miljoenen […]

Long- en oncologisch chirurg Hermien Schreurs ontvangt bijzondere onderscheiding
januari 25, 2022
Onze long- en oncologisch chirurg Hermien Schreurs heeft de Zilveren Legpenning van de Nederlandse Vereniging voor Heelkunde (NVvH) ontvangen. Een bijzondere onderscheiding die wordt toegekend aan chirurgen die nationaal of internationaal van bijzondere betekenis of invloed zijn geweest voor de ontwikkeling van de Nederlandse Heelkunde. Uitreiking Hermien Schreurs kreeg deze legpenning onder andere voor het werk […]

ETZ start spreekuur voor complexe knieproblemen
januari 25, 2022
De orthopedisch chirurgen in het ETZ starten – in samenwerking met het SMC Tilburg – een speciaal spreekuur voor volwassenen met complexe knieproblemen. Elke patiënt in de leeftijd tot 60 jaar krijgt direct na de zorgvuldige diagnose een op maat gemaakt behandeltraject aangeboden. “Hiermee krijgen patiënten weer de regie terug over de knie en hun […]

Maasstad Ziekenhuis sluit aan bij Rotterdams Klimaatakkoord
januari 25, 2022
Samen met Erasmus MC, Ikazia, Oogziekenhuis Rotterdam, Franciscus Gasthuis & Vlietland en de zorginstelling Rijndam Revalidatiecentrum sluit het Maasstad Ziekenhuis zich aan bij het Rotterdams Klimaatakkoord. De zorginstellingen bundelen de krachten in een nieuwe klimaattafel Gezondheidszorg voor het versneld verduurzamen van de sector met als doel: minder milieuvervuiling en minder CO2-uitstoot. De deelnemende ziekenhuizen werken […]

Spaarne Gasthuis en Streeklab Haarlem bestendigen samenwerking in regio
januari 25, 2022
Het Spaarne Gasthuis en Streeklab Haarlem hebben deze week hun samenwerking voor vijf jaar verlengd. Hiermee bestendigen zij de zorg voor diagnostiek en behandeling van infectieziekten voor de patiënten in de regio. Volgens Joris van der Putten, zorgmanager van het Spaarne Gasthuis is tijdens de pandemie nog duidelijker geworden dat Streeklab Haarlem een geschikte partner is […]

Wie wordt de allereerste kinderburgemeester van Rotterdam?
januari 25, 2022
Burgemeester Aboutaleb zoekt er een belangrijke helper bij: een kinderburgemeester. Toespraken houden, lintjes doorknippen en natuurlijk aandacht vragen voor belangrijke onderwerpen die kinderen aangaan. Alle kinderen in Rotterdam die nu in groep 7 zitten mogen solliciteren op de baan van Kinderburgemeester. Waarom een kinderburgemeester Kinderen denken anders dan volwassenen. Ook weten ze beter dan volwassenen […]

Betere samenwerking palliatieve zorg leidt tot minder ziekenhuis- en IC-opnames
januari 25, 2022
Utrecht, 25 januari – In regio’s waar zorgaanbieders, zoals wijkverpleging, huisarts, hospices en ziekenhuis in de palliatieve fase intensief samenwerken ontvangen patiënten vaker passende zorg, wat leidt tot minder ziekenhuisopnames. Patiënten en naasten ervaren daarmee een waardiger afscheid, terwijl de zorgkosten niet stijgen. Dat blijkt uit onderzoek van Palliatieve Zorg Nederland (PZNL) waarin patiëntdata van […]

Rotterdam 21,5 hectare groen rijker
januari 24, 2022
In vier jaar tijd 20 hectare extra groen in de stad. Dat doel stelde dit college zich in 2018 met het actieprogramma Rotterdam gaat voor groen. Op de teller staat inmiddels 21,5 hectare extra groen voor de stad (ruim 29 voetbalvelden). Hiermee is het doel van het college ruimschoots gehaald. Veel extra groen is te vinden […]

Rotterdam wint de Bloomberg Philanthropies’ Mayors Challenge met marktplaats voor sociaal ondernemers Rikx
januari 24, 2022
Rotterdam wordt Champion City en krijgt $1 miljoen om Rikx verder te ontwikkelen en te verspreiden naar andere steden, nationaal en internationaal. Met de digitale marktplaats voor sociaal ondernemers maakt Rikx initiatieven mogelijk die kansarme Rotterdammers opleiden en naar werk begeleiden. Het innovatieve financieringsmodel is erkend door Bloomberg Philanthropies, die Rikx beloont met 1 miljoen […]

Geef 2022 een kickstart met een gezonde levensstijl
januari 18, 2022
Ga actief aan de slag en maak dit jaar je goede voornemens waar op het gebied van gezond eten en voldoende bewegen. De Havery Coaches van The Consumers gaan je daarbij helpen met persoonlijke voedings- en bewegingsadviezen. Veel inspiratie vind je ook op Instagram bij @haveryoats en @theconsumers. Havery en The Consumers zijn een partnership aangegaan om mensen […]

Scolioscoop curve: eerste zelftest voor scoliose patiënten
januari 17, 2022
“Hoe gaat het met mijn rug?” Dat is een vraag die scoliose patiënten, ouders, artsen, fysiotherapeuten en wij hebben. Daarom zijn we al sinds 2018 bezig met het ontwikkelen van scoliose screening hulpmiddelen. We zijn daarom ook erg trots dat de Scolioscoop Curve de eerste zelftest is voor Scoliose patiënten om thuis de rug te […]

Ziekenhuis Rivierenland start met immunotherapie bij longkanker
januari 12, 2022
Patiënten met een bepaalde vorm van longkanker kunnen voor immunotherapie nu terecht in hun eigen ziekenhuis in Tiel. Afreizen naar het St. Antonius Ziekenhuis in Nieuwegein is daardoor niet altijd meer nodig. De afdeling Longgeneeskunde voldoet sinds 1 januari aan alle specifieke eisen om zelf patiënten immunotherapie te mogen geven. Bij een behandeling met immunotherapie […]

Alternatief voor miljoenen plastic tandpasta tubes – HappySoaps introduceert de allereerste 100% plasticvrije tandpasta tabs binnen Europa
januari 12, 2022
alternatief voor miljoenen plastic tandpasta tubes happysoaps introduceert de allereerste 100% plasticvrije tandpasta tabs binnen europa. Apeldoorn, 12 januari 2022 Happysoaps, het grootste 100% plasticvrije verzorgingsmerk van Nederland komt met een compleet nieuwe productlijn: tandpasta tabs. hiermee gaat Happysoaps de strijd aan met de tubes tandpasta (in plastic verpakt en waarvan de pasta veelal microplastics […]

Wetenschapsagenda 11 – 14 januari
januari 11, 2022
Chiara Jongerius: Gaze in medical consultations | measurement, associations and mechanisms Donderdag 13 januari 2022Promotie (UvA), 16:00 u, Agnietenkapel Jongerius onderzocht het oogcontact tussen arts en patiënt. De aanleiding voor dit promotieonderzoek waren zorgen over het toenemend gebruik van de computer tijdens consulten. Dit zou de kwaliteit van het contact tussen arts en patiënt, en […]

Neuspoliepen opereren beter dan alleen medicijnen geven
januari 10, 2022
Opereren bij neuspoliepen geeft een beter effect dan alleen behandelen met medicijnen. Dit blijkt uit de eerste grote wetenschappelijke studie waarin deze twee behandelingen zijn vergeleken in 11 Nederlandse ziekenhuizen onder leiding van Amsterdam UMC. De resultaten zijn gepubliceerd in The Lancet Respiratory Medicine. Neuspoliepen, goedaardige zwellingen van het neusslijmvlies als gevolg van een chronische ontsteking, […]

REMINDER: VERPLAATSING DigiDeal010 van 16 december naar donderdag 20 januari
januari 10, 2022
Ontwikkel de maatschappelijke en economische business case van jouw zorginnovatie Verplaatsing DigiDeal010 naar donderdag 20 januariGeachte deelnemer van het DigiDeal010 event, Ten eerste, de beste wensen voor 2022!!Zoals we eerder hebben laten weten, vindt het DigiDeal010 event op 20 januari van 08.00 – 09.30 plaats. Uiteraard ben je dan ook weer van harte uitgenodigd! Jouw […]

Groene Hart Ziekenhuis vestigt geboorterecord met 2.279 bevallingen
januari 10, 2022
In het Groene Hart Ziekenhuis zijn in het afgelopen jaar 2279 baby’s geboren. Daarmee is er een geboorterecord gevestigd in het Goudse ziekenhuis. In 2020 werden er nog 2103 baby’s geboren in het GHZ, dat zijn er 176 minder dan in 2021. De laatste jaren ziet het ziekenhuis een enorme toename in het aantal bevallingen. […]

VieCuri spoort aan tot boosterprik om zorg draaiende te houden
januari 10, 2022
De druk op de ziekenhuizen blijft hoog. Hoe meer mensen gevaccineerd en geboosterd zijn, hoe minder kans op ernstige complicaties en ziekenhuisopnames. VieCuri wil mensen motiveren om zo snel mogelijk de boosterprik te laten zetten om de zorg draaiende te houden. Opkomst Omikron Noord-Limburg is vanaf het begin van de pandemie één van de zwaarst […]

Nieuwe voorzitter raad van toezicht ETZ
januari 7, 2022
Drs. D. W. (David) Voetelink is benoemd tot nieuwe voorzitter van de raad van toezicht van het ETZ (Elisabeth-TweeSteden Ziekenhuis) in Tilburg. Met ingang van 1 januari 2022 volgt hij mr. H.M.C.M. (Hein) van Oorschot op. Hein van Oorschot maakt al ruim 11 jaar onderdeel uit van de raad van toezicht, waarvan twee jaar voorzitter, […]

Waarom trager ademen het beste goede voornemen van 2022 is
januari 7, 2022
Je kunt je voornemen in het nieuwe jaar dagelijks naar de sportschool te gaan, alle chips en alcohol uit huis te verbannen en het stof van je meditatiekussen te vegen. En ja, dat is allemaal heilzaam. Toch heeft dit alleen zin als je ook aandacht besteedt aan je ademhaling. Waarom is dat zo? De adem […]

PERSBERICHT: Nul blinde ogen in 2022 Grote impact vuurwerkverbod op oogletsel
januari 5, 2022
Nijmegen, 5 januari 2022 – Niemand is dit jaar blind door vuurwerk geworden. Dat is in veertien jaar registreren van oogletsels door vuurwerk nooit eerder gebeurd. Hiermee is bewezen dat een landelijk verbod op consumentenvuurwerk werkt. En gecontinueerd dient te worden. De beroepsvereniging van oogartsen (NOG) blijft achter haar standpunt staan dat consumentenvuurwerk gevaarlijk is […]

Persbericht: Vuurwerkmanifest steunt nieuwe Vuurwerkwet
januari 4, 2022
Rotterdam, 4 januari 2022 – Het Nationale Vuurwerkmanifest ondersteunt de initiatiefwet van GroenLinks en Partij voor de Dieren voor een algemeen en permanent consumentenvuurwerkverbod in Nederland. Een te groot aantal mensen – waarvan de helft omstander – loopt letsel door consumentenvuurwerk op. De afgelopen twee jaar is dit door de (tijdelijke) vuurwerkverboden significant minder geworden. Daarom vinden GroenLinks, Partij voor […]

‘Goede voornemens? Denk ook hieraan!’ zegt de uroloog
januari 3, 2022
Plas niet te vaak, niet te weinig en pas op voor een dikke buik Na een feestelijke decembermaand gaan we in januari massaal weer met een gezonde leefstijl aan de slag. ‘En dat is maar goed ook, ’ vertelt dr. Paul Kil, uroloog en medisch directeur bij Andros Clinics, ‘want een gezonde leefstijl kan veel […]

Basalt en Groene Hart Ziekenhuis intensiveren samenwerking in Goudse regio
januari 3, 2022
De poliklinische revalidatiezorg in het Groene Hart Ziekenhuis (GHZ) is vanaf 1 januari 2022 overgenomen door Basalt. Hiermee breiden Basalt en het GHZ hun samenwerking verder uit. Na een eerdere intensivering van de samenwerking met het Haga Ziekenhuis, het Alrijne ziekenhuis en het LangeLand Ziekenhuis is het GHZ het vierde ziekenhuis in Zuid-Holland dat de […]

Maasstad Ziekenhuis trekt financiering van 100 miljoen euro aan voor verbouwingen en innovaties
januari 3, 2022
Goede vooruitzichten, een duidelijke strategie voor de toekomst en positieve resultaten uit het verleden, hebben ervoor gezorgd dat het Maasstad Ziekenhuis een financiering van 100 miljoen toegekend krijgt voor 2021-2025. Het geld gaat onder andere gebruikt worden voor de verbouwing van de Spoedeisende Hulp, de afdelingen Neonatologie en Verloskunde én voor (versnelde) innovaties die noodzakelijk […]

PERSBERICHT HET OOGZIEKENHUIS ROTTERDAM: TWEE VUURWERKSLACHTOFFERS IN HET OOGZIEKENHUIS ROTTERDAM
januari 3, 2022
Rotterdam, 1 januari 2022 – Tijdens afgelopen nacht zijn slechts twee vuurwerkslachtoffers met oogletsel bij Het Oogziekenhuis Rotterdam binnengebracht. Het letsel is bij beide patiënten niet blijvend. Beide patiënten waren omstander en staken zelf geen vuurwerk af.Mogelijk worden nog wel slachtoffers uit andere regio’s bij het ziekenhuis binnengebracht, maar het is zeer onwaarschijnlijk dat dit […]

Door prehabilitatie herstel je sneller en beter na een operatie
december 28, 2021
Patiënten die trainen voor en na een ingrijpende operatie, is dat niet een beetje gek? Toch is dit in Ziekenhuis Nij Smellinghe in Drachten de normaalste zaak van de wereld. Want uit onderzoek blijkt dat een patiënt de kans op complicaties tot wel 50% kan verminderen als hij fysiek en mentaal fit(ter) is. En de […]

Zorgcontractering 2022, stand van zaken VieCuri
december 23, 2021
Door de coronapandemie staat de ziekenhuiszorg wereldwijd al twee jaar onder druk. Dat is bij VieCuri in extreme mate het geval. Naar verwachting heeft de coronapandemie ook in 2022 weer vergaande (financiële) gevolgen voor het ziekenhuis. Desondanks heeft VieCuri met de meeste zorgverzekeraars goede uitgangspunten bereikt voor de zorg in 2022. Dat geldt helaas niet […]

Liever thuis dan in het ziekenhuis
december 23, 2021
Thuis ziekenhuiszorg ontvangen heeft een vlucht genomen met de thuismonitoring van patiënten met Covid-19. Het Jeroen Bosch Ziekenhuis (JBZ) startte er in 2018 al mee voor patiënten met hartfalen en COPD, met het idee dat thuismonitoring de eigen regie van patiënten zal vergroten. Mede daardoor en door de intensieve samenwerking in het zorgnetwerk, kon snel […]

EUROPEAN ROBOTICS FORUM 2022
december 23, 2021
EUROPEAN ROBOTICS FORUM 2022 It is with great pleasure that we welcome you to the European Robotics Forum 2022 in one modern, easily reachable, spectacular city: Rotterdam, the Netherlands. The European Robotics Forum 2022 (ERF2022), the most influential meeting of the robotics community in Europe, will be held from 28 – 30 June in Rotterdam, […]

Maasstad Ziekenhuis en verzekeraars tonen lef met ‘waardegedreven’ zorgcontract
december 23, 2021
Het Maasstad Ziekenhuis heeft met zijn vier grootste verzekeraars* een contract afgesloten waarin de kwaliteit van zorg centraal staat. Dat heeft voor 2022 geresulteerd in het ‘waardegedreven’ zorgcontract. Uitgangspunt is dat het ziekenhuis zoveel mogelijk waarde toevoegt aan de kwaliteit van leven van patiënten. Einddoel is toegankelijke en betaalbare zorg. Het model Tot nu toe […]

Water summit global development
december 22, 2021
Join us on 15 March 2022 for the “Water Summit for Global Development 2022” in the TU Delft Aula. We invite researchers, practitioners, policy makers, students, and volunteers to discuss how multidisciplinary science, technology, policy and innovation can improve access to water, and how we can achieve this together. Theme – Catching Up With Urbanisation […]

Vegetarische Blended Diet receptenbundel voor kinderen met sondevoeding
december 21, 2021
Voor kinderen die industriële sondevoeding niet goed kunnen verdragen is Blended Diet een alternatief. Bij Blended Diet maakt men gebruik van een zeer fijn gepureerde maaltijd van gewone voedingsmiddelen, die zó vloeibaar is dat deze via een sonde kan worden toegediend. In december 2020 verscheen de eerste receptenbundel Blended Diet van het Jeroen Bosch Ziekenhuis. […]

Bestuurder Bertjo Renzenbrink neemt afscheid van Rijndam Revalidatie
december 21, 2021
Bertjo Renzenbrink is teruggetreden als bestuurder bij Rijndam Revalidatie. De Raad van Toezicht van Rijndam is gestart met de werving voor een opvolger.Gemeenschappelijke passie“Ruim 4 jaar heb ik met veel plezier invulling mogen gegeven aan de koers van Rijndam”, vertelt Bertjo Renzenbrink. “Ik spreek mijn dank en bijzondere waardering uit voor de samenwerking in de […]

Democratic Republic of the Congo declares Ebola outbreak over
december 20, 2021
Brazzaville/Kinshasa – The Ebola outbreak that erupted in the Democratic Republic of the Congo’s North Kivu Province in October – the second in 2021 – was today declared over, the national health authorities announced after no new cases were reported at the end of a 42-day countdown, or two incubation periods after the last confirmed case […]

NWO-Veni van 280.000 euro voor 89 onderzoekers
december 20, 2021
NWO heeft 89 veelbelovende jonge wetenschappers uit de wetenschapsdomeinen ENW en ZonMw een Veni-financiering van maximaal 280.000 euro toegekend. Hiermee kunnen de laureaten gedurende drie jaar hun eigen onderzoeksideeën verder ontwikkelen. De Veni-laureaten gaan onder andere onderzoek doen naar het vertragen van Parkinson door lichaamsbeweging, de fysische aard van radioflitsen, de opwarming van het klimaat […]

Stichting Lezen en Schrijven:?“Mooie plannen in het coalitieakkoord; nu tijd voor de uitvoering”
december 20, 2021
In de plannen van het nieuwe kabinet is veel aandacht voor het voorkomen van taalachterstanden en de aanpak van laaggeletterdheid. Dat leest Stichting Lezen en Schrijven in het nieuwe coalitieakkoord.?Ook willen de politieke partijen ervoor zorgen dat dienstverlening door de overheid begrijpelijk is voor iedereen en ervoor zorgen dat iedereen ook digitaal mee kan doen. Stichting Lezen en?Schrijven vindt het?nu de hoogste tijd om de plannen uit te voeren.?? Geke?van Velzen, directeur-bestuurder Stichting Lezen en Schrijven:“Wij zijn blij?dat er op verschillende terreinen aandacht in de?kabinetsplannen is?voor het aanpakken van laaggeletterdheid. […]

Eindelijk een suikertaks en btw-verlaging op groente en fruit
december 15, 2021
Jarenlange campagne foodwatch succesvol Amsterdam, 15 december 2021 – Met het ‘Offensief voor onze gezondheid’ heeft foodwatch de politieke partijen opgeroepen eindelijk wettelijke en financiële maatregelen voor een gezonde leefomgeving te gaan vastleggen in het nieuwe regeerakkoord. Deze campagne, waar een jarenlange strijd aan voorafgaat, heeft eindelijk vruchten afgeworpen. Uit het nieuwe coalitieakkoord blijkt dat er een suikertaks, […]

NWO, KNAW en UNL: bedreigingen wetenschappers volstrekt onacceptabel
december 15, 2021
De bedreigingen aan het adres van wetenschappers maken een volwaardig debat over omstreden kwesties onmogelijk. Zij tasten de persoonlijke veiligheid van onze onderzoekers aan, die hun kennis ten dienste stellen aan het publieke debat, en brengen daarmee schade toe aan onze kennissamenleving. De Nederlandse Organisatie voor Wetenschappelijk Onderzoek (NWO), de Koninklijke Nederlandse Akademie van Wetenschappen […]

Spaarne Gasthuis behaalt niveau zilver van Milieuthermometer Zorg
december 15, 2021
Op naar een duurzaam ziekenhuis van de toekomst Het Spaarne Gasthuis is trots te kunnen vertellen dat wij van het Milieu Platform Zorg het zilveren niveau van de Milieuthermometer hebben ontvangen! Milieuthermometer ZorgDit betekent dat het Spaarne Gasthuis op het gebied van duurzaamheid het afgelopen jaar weer flinke stappen heeft gezet, en daarmee goed op weg is om […]

Germany | Health~Holland Lounge Altenpflege Trade Fair
december 15, 2021
Germany | Health~Holland Lounge Altenpflege Trade Fair April 26, 2022 – April 28, 2022 The Altenpflege Fair in Essen is the leading trade fair for the care industry and an annual must-attend event for all those responsible for inpatient and outpatient care for the elderly. The Altenpflege reflects all facets of the care industry: services and products for care […]

Colombia | Life Sciences & Health Trade Mission
december 15, 2021
Colombia | Life Sciences & Health Trade Mission February 21, 2022 – February 24, 2022 Interested in taking your business to the next level in the Colombian healthcare market? Join the trade mission on Life Sciences and Health. This trade mission, which will take place from 21-24 February 2022 in Bogotá and Cali, offers the perfect opportunity […]

Switzerland | Life Sciences & Health Trade Mission Digital Health
december 15, 2021
Interested in doing business in the Swiss healthcare market? Join the trade mission on Life Sciences and Health. This trade mission, which will take place from 2-4 February 2022 in the German-speaking region of Switzerland, provides excellent opportunities to meet new and relevant contacts and shed light on current developments in the Swiss healthcare system. Registration […]

UAE | Health Mission Dubai Expo
december 15, 2021
UAE | Health Mission Dubai Expo January 23, 2022 – January 25, 2022 From 23 – 25 January 2022 the Netherlands Consulate in Dubai, RVO.nl and the Task Force Health Care (TFHC) will organize a health mission to the Dubai Expo 2020 and Arab Health. Dubai is hosting the World Expo 2020 which is running from October […]

The United States | Round table session California
december 15, 2021
Health~Holland, the Consulate General in San Francisco, the Netherlands Business Support Office (NBSO) in Los Angeles and the Task Force Health Care (TFHC) have the pleasure of inviting you to the Health~Holland ‘Digital Round Tables | California’ on Tuesday, January 18th, 2022. Location: OnlineWhen: Tuesday, January 18th (16.30 – 18.00 NL / 07.30 – 09.00 CA) You can register here! What to […]

Designing for Healthcare | Health~Holland Digital meet-up
december 15, 2021
In the field of Creative Designing for Healthcare, two Dutch Topsectors meet Life Sciences and Health, and Creative industries. More and more Healthcare organisations are discovering the added value of creative design to address the many challenges they face. On the other hand, when designing for this complex domain, the creative industry need access to […]

The United States | Health~Holland Digital Reconnect
december 15, 2021
Reflecting on 2021 and looking forward to 2022 The United States officially reopened their borders for vaccinated travellers from Europe. This represents a great step for Dutch-American trade relationships and signifies the ability to start organizing physical activities towards the United States again! While travel may have been difficult this past year, plenty has still […]

Webinar Mentaal fit na corona: omgaan met gedachten
december 15, 2021
Op maandag 20 december van 19.30-20.30 uur verzorgt Indigo preventie een webinar Mentaal fit na corona: omgaan met gedachten. Dit webinar is speciaal voor Rotterdammers die door alle coronaperikelen last hebben stress, onzekerheid, angst of somberheid. In dit Webinar worden twee effectieve manieren van omgaan met gedachten besproken. De basisprincipes van cognitieve gedragstherapie en Acceptance and Commitment Therapie […]

Ieder kind een eigen JBZ-kinderpaspoort
december 15, 2021
Vanaf vandaag, vrijdag 10 december, krijgen alle kinderen die naar het Jeroen Bosch Ziekenhuis komen een eigen JBZ-Kinderpaspoort. Dit paspoort is in samenwerking met de KinderRaad van het ziekenhuis gemaakt. Wij vinden het als ziekenhuis namelijk erg belangrijk dat kinderen meedenken. Om diezelfde reden hebben wij de Kidsreporters Den Bosch gevraagd om alle kinderen in […]

Brief aan patiënten en inwoners van de regio
december 15, 2021
Namens de raad van bestuur en het MSCK van het Spaarne Gasthuis Op dit moment verloopt de zorg en nazorg in ons ziekenhuis anders dan normaal. Net als alle ziekenhuizen in Nederland moeten wij bepaalde operaties en behandelingen uitstellen. Maar ook afspraken op de polikliniek worden soms afgezegd of uitgesteld. En voor de mensen die […]

Giftige minerale oliën aangetroffen in voedingsproducten in verschillende Europese landen
december 15, 2021
foodwatch: EU moet nultolerantieregel invoeren Uit laboratoriumtests in opdracht van foodwatch blijkt dat er in heel Europa nog steeds producten in de schappen liggen die verontreinigd zijn met giftige aromatische minerale olie (MOAH). Foodwatch eist een nultolerantieregel voor MOAH-verontreiniging in alle levensmiddelencategorieën in de EU.Onder meer Knorr-bouillonblokjes (Unilever) en Cruesli Kids Chocolate van Quaker (PepsiCo) werden positief […]

Online bijeenkomst extra voorlichting voor zwangeren over corona-vaccinatie
december 13, 2021
Bij zwangere vrouwen en vrouwen met een kinderwens bestaat veel onzekerheid over de gevolgen van een corona-vaccinatie. Door alle berichten is het moeilijk om te bepalen wat de juiste keuze is. Het Ikazia Ziekenhuis organiseert daarom een webinar over kinderwens, zwangerschap en corona-vaccinatie. Het doel van het webinar is om informatie te geven over de […]

Unieke oplossing voor kinderen met lui oog
december 13, 2021
Een lui oog komt bij kinderen veel voor. Het oog kan wel zien, maar wordt niet (of minder goed) gebruikt, waardoor het andere oog het overneemt. De standaardbehandeling: het ‘goede’ oog afplakken om zo het luie oog te trainen. Ook Christina Engels uit Wijchen kreeg dit advies van de oogarts. Het pleisters plakken werd echter […]

Amsterdam UMC sluit zich aan bij de vaccinatie-Twijfellijn
december 13, 2021
Vanaf maandag 13 december sluit Amsterdam UMC zich aan bij de ‘Vaccinatie-twijfellijn’. Mensen met vragen en aarzelingen over vaccinaties kunnen bij deze telefoonservice terecht voor verantwoorde informatie. De Vaccinatie Twijfeltelefoon schaalt wegens het enorme succes op en wordt een landelijke telefoonlijn. De universitaire ziekenhuizen in Amsterdam, Utrecht, Maastricht en Nijmegen slaan de handen ineen en […]

Gebruikte stempotloden worden kunstwerk over laaggeletterdheid
december 13, 2021
De 90.000 stempotloden die in het kunstwerk te zien zijn, staan symbool voor de naar schatting 90.000 Rotterdammers die moeite hebben met lezen en schrijven. Zondag 12 december onthult wethouder Judith Bokhove van Mobiliteit, jeugd en taal het kunstwerk, samen met kunstenares Christine Saalfeld. Het kunstwerk dat ‘Talascoop’ is gedoopt, komt te staan op het […]

Toegankelijke themakisten helpen leerlingen met een visuele beperking om meer te lezen
december 13, 2021
Den Haag, 8 december 2021 – Voelen, luisteren, leren en vooral lezen. Deze combinatie staat centraal bij de eerste toegankelijke themakisten voor basisschoolleerlingen met een visuele beperking. De themakisten zijn ontwikkeld voor cluster-1-scholen om het lezen door leerlingen die niet of slecht kunnen zien te bevorderen. Elke themakist bevat een boek en verschillende spel- en […]

Museum Het Schip wint RAAK Stimuleringsprijs 2021
december 13, 2021
Museum Het Schip in Amsterdam wint € 30.000,- om tentoonstellingen, workshops en rondleidingen multizintuiglijk aan te bieden aan mensen met een visuele beperking. Dit plan kreeg de meeste stemmen van het Nederlandse publiek en ontvangt daarom de eerste prijs van de RAAK Stimuleringsprijs 2021. “Sociale gelijkheid stond hoog in het vaandel bij de architecten van […]

Historische daling Rotterdamse CO2-uitstoot
december 13, 2021
Rotterdam maakt werk van de lokale klimaataanpak. Niet zonder succes. In de afgelopen vier jaar heeft de stad ruim één miljoen ton CO2 gereduceerd. De tot voor kort jaarlijkse stijging van CO2-uitstoot is voor het eerst sinds de Tweede Wereldoorlog omgebogen in een dalende trend. Een daling die zich volgens de prognoses van milieudienst DCMR […]

Bril op maat voor mensen met een verstandelijke beperking
december 8, 2021
Mensen met een verstandelijke beperking hebben vaker moeite met zien. Een deel van deze doelgroep heeft ook nog eens een afwijkende vorm van de schedel en/of het gezicht. Een gewone bril is dan geen goede oplossing. Philadelphia Zorg werkt daarom sinds kort samen met Maatbril. Tanja Baack, beleidsadviseur van Philadelphia’s Horen en Zien-team, vertelt waarom […]

Extra voorlichting voor zwangeren over coronavaccinatie
december 7, 2021
Bij zwangere vrouwen en vrouwen met een kinderwens bestaat veel onzekerheid over de gevolgen van een coronavaccinatie. In de media verschijnen dagelijks verschillende berichten en ook in de spreekkamer merken de gynaecologen en verloskundigen de twijfel. Daarom is het Jeroen Bosch Ziekenhuis deze week gestart met een brede communicatiecampagne. Doel van de campagne is om […]

Tijdelijk vuurwerkverbod geen oplossing voor mensen met hulphond
december 6, 2021
KNGF Geleidehonden wil permanent vuurwerkverbod KNGF Geleidehonden betreurt de tijdelijkheid van het vuurwerkverbod dat het kabinet afgelopen weekend aankondigde. Twee derde van de mensen met een KNGF-hond is namelijk het slachtoffer van vuurwerkknallen tijdens het werken met de hond. Dat blijkt uit onderzoek van KNGF Geleidehonden, uitgevoerd door onderzoeksbureau Markteffect. Vuurwerkknallen hebben forse impact op […]

Door burgerhulpverleners hogere overlevingskans bij hartstilstand thuis
december 6, 2021
Als iemand thuis een hartstilstand krijgt, is de kans om dit te overleven met de helft gestegen door de inzet van burgerhulpverleners. Zij reanimeren het slachtoffer al voor de komst van de ambulance. Onderzoekers van Amsterdam UMC beschreven de resultaten van het ARREST- onderzoek in het tijdschrift European Heart Journal. De overlevingskans voor mensen met […]

Corona neuszelftest voldoende betrouwbaar bij verkoudheidsklachten, maar onbetrouwbaar bij afwezigheid van klachten
december 6, 2021
Recent Nederlands onderzoek heeft uitgewezen dat de onderzochte corona antigeen neuszelftest voldoende betrouwbaar is als men op het moment van testen symptomen of klachten heeft die passen bij een corona infectie, maar niet als men geen symptomen of klachten heeft. Daarnaast blijkt dat de onderzochte speekselzelftest , waarbij in een buisje moet worden gespuugd, onvoldoende […]

PET-CT biedt patiënten HMC nieuwste onderzoekstechniek dicht bij huis
december 6, 2021
Op HMC Antoniushove zijn deze week de eerste patiënten gescand met een nieuwe PET-CT. De PET-CT biedt de patiënt van HMC dichtbij extra waardevolle informatie over zijn diagnose en behandeling. Patiënten van HMC moesten tot voor kort gebruikmaken van de PET-CT van het Groene Hart Ziekenhuis in Gouda. Het besluit om een eigen PET-CT te […]

VieCuri neemt nieuw simulatiecentrum in gebruik
december 6, 2021
Ziekenhuis VieCuri opent in Venlo een nieuw simulatiecentrum waarmee zorgprofessionals worden getraind aan de hand van levensechte situaties. Niet alleen medewerkers van VieCuri kunnen hier onderwijs volgen. Ook verloskundigen, ambulancemedewerkers en huisartsen kunnen er terecht. In het simulatiecentrum trainen de medewerkers hoe te handelen in spoedeisende omstandigheden. Met hightech-poppen die kunnen ademen, blauw kunnen aanlopen […]

Het verbinden van leiders in Zorg en Welzijn
december 2, 2021
Met het platform ‘Vrouwelijke Leiders in de Zorg’ willen wij leiders in zorg en welzijn met elkaar verbinden zodat zij elkaar kunnen leren en inspireren over leiderschap en alle uitdagingen die er zijn nu en in de toekomst. Wat kan je verwachten? *ONLINE SEMINARS ?*INSPIRERENDE INTERVIEWS *SPRAAKMAKENDE ARTIKELEN *BOEIENDE ONTMOETINGEN VLidZ biedt kennis en inspiratie op […]

Nationale Dementie Congres
december 2, 2021
We kunnen het in deze tijd van corona ons bijna niet voorstellen: niet corona, niet kanker, niet obesitas, maar dementie is volksziekte nummer één in Nederland. Eén op de vijf mensen krijgt een vorm van dementie, en dementie neemt zodanig toe dat iedere Nederlander er in zijn familie of omgeving mee te maken krijgt. Tijdens […]

17 januari 2022 – Gezond & Zeker live!
december 2, 2021
Maandag 17 januari organiseert Gezond & Zeker de eerste ‘Gezond & Zeker LIVE!’. In deze interactieve talkshow praten ze je bij over de laatste inzichten rondom fysieke belasting, agressie en werkbalans in zorg en welzijn. Aan het woord komen wetenschappers, experts en ervaringsdeskundigen. Van hen krijg je praktische tips waar je de volgende dag direct […]

Nieuw boek over mensen met visuele beperking – “must read voor beleidsmakers en zorgverleners” volgens Hugo de Jong
december 2, 2021
In het nieuwe boek Gezien, leven met een visuele beperking vertellen Tweede Kamerlid Daan de Kort, tassenontwerpster Annemarie Nodelijk, de uit Syrië gevluchte Amany Shalha en 17 andere mensen met een visuele beperking vertellen hun verhaal. Het boek geeft een unieke kijk op de mogelijkheden van mensen met een visuele beperking in werk, onderwijs en deelname aan […]

360º Online voorlichting over bevallen
december 2, 2021
Hoe gaat een bevalling thuis? Hoe ziet een bevalsuite in het ziekenhuis eruit? En wat kan je verwachten als de baby er eenmaal is? Allemaal vragen die je als aanstaande ouder(s) graag beantwoord ziet voordat de baby er is. VSV Rondom Zwanger bundelde haar krachten met de JGZ Kennemerland en ontwikkelde een 360º online voorlichting […]

Noordwest start op locatie Den Helder met gezonde en duurzame voeding vanuit eigen keuken
december 1, 2021
Aantrekkelijke, gezonde en lekkere voeding in het ziekenhuis is erg belangrijk. Het draagt bij aan de kwaliteit van het verblijf en een sneller herstel van de patiënt. Daarom worden de avondmaaltijden voor patiënten op locatie Den Helder vanaf 1 december volledig zelf en op duurzame wijze bereid door onze koks. De patiënt op één […]

De rek is eruit
december 1, 2021
DEN HAAG – Het aandeel verzuim door psychische klachten blijft met 29% onverminderd hoog stelt de bedrijfsarts van ArboNed. Het CNV pleit voor een 30-urige werkweek om psychisch ziekteverzuim te verminderen. Het RIVM toont aan dat meer dan de helft van de Nederlanders te weinig beweegt. We zitten gemiddeld bijna 9 uur per dag. Daarmee […]

Rotterdams Onderwijs en Revalidatiecentrum zoekt nieuwe Vrienden
december 1, 2021
Dinsdag 30 november organiseerde Rijndam Revalidatie ‘het Innovatiefestival’ om de bouw van het nieuwe Rotterdams Onderwijs en Revalidatiecentrum (het ROeR) te vieren. Tijdens dit online festival vond de aftrap plaats voor de fondsenwerving van de Stichting Vrienden van Rijndam. Medewerkers en vrienden van de stichting werden op het festival meegenomen in de wereld van de nieuwste zorginnovaties […]

MEDICAL DELTA BRENGT ZUID-HOLLANDSE STAKEHOLDERS IN ZORGINNOVATIE BIJEEN
november 30, 2021
‘We hebben een enorm kennispotentieel, maar kunnen nóg beter samenwerken’ Medical Delta wil met technologische oplossingen duurzame zorg realiseren. De organisatie is een samenwerkingsverband van Zuid-Hollandse stakeholders op het snijvlak tussen gezondheid en technologie. ‘Met drie gerenommeerde universiteiten, twee universitair medische centra, vier hogescholen, overheden, bedrijven en zorginstellingen hebben we een uniek kennispotentieel in Zuid-Holland. […]

REVALIDEREN OP BASIS VAN JE HARTSLAG EN ADEMHALING
november 29, 2021
Ronald herstelt na een zware operatie en chemokuur met BioCheck: “Het geeft me rust dat ik bewuster bezig ben met mijn gezondheid” Ronald Dullemans heeft altijd sportief geleefd: hij voetbalde, deed aan hardlopen en racefietsen. Daarnaast had hij een druk bestaan als projectmanager bij een IT-bedrijf. Totdat hij in het voorjaar van 2019 onverwachts de […]

DigiDeal010 – Donderdag 16 december
november 24, 2021
DigiDeal010 – Donderdag 16 december Virtuele inloop: 07.45 – 08.00 Tijd: 08.00 – 09.30 Online meeting: Link ontvangt u twee dagen voor aanvang Vragen? Contact Esra, esra@philogirl.nl DigiDeal010 in het kort De DigiDeal010 is gelanceerd om de positieve ontwikkelingen op het vlak van eHealth als gevolg van Covid-19 vast te houden en zorg- en welzijnsaanbieders voor te bereiden op de […]

Rotterdam kleurt oranje als protest tegen geweld tegen vrouwen
november 24, 2021
Geweld tegen vrouwen is onacceptabel en moet stoppen. Daarom kleurt Rotterdam op donderdag 25 november 2021 opnieuw oranje. Want dan is het Orange the World-day, de internationale dag tegen geweld tegen vrouwen. Meerdere gebouwen, zoals het KPN-gebouw en het politiebureau Veilingweg, maar ook de Hofpleinfontein en de Erasmusbrug worden oranje verlicht. Op het Schouwburgplein wapperen […]

Programma webinar: Obesitas Jaaroverzicht
november 24, 2021
Obesitas Platform is een online platform dat alle informatie rondom obesitas op toegankelijke wijze beschikbaar maakt voor zorgverleners actief in obesitaszorg. Programma webinar: Obesitas Jaaroverzicht(20:00 – 21:30) Tijdens dit webinar laten we verschillende obesitasexperts aan het woord. Vanuit hun eigen expertise lichten zij het belangrijkste obesitas-gerelateerde nieuws van het jaar toe. Dat kan wetenschappelijk nieuws […]

WEER IN BALANS NA STRESSVOLLE PERIODE
november 24, 2021
Rachel de Keizer deed mee aan het Vitaliteitsprogramma van BioCheck en vond meer balans en rust na een zeer ingrijpende fase in het leven van haarzelf en haar partner. Vierentwintig is ze. Een leeftijd waarop de meeste mensen vooruit kijken en onbezorgd plannen maken voor de toekomst. Helaas ligt het voor Rachel anders. Haar echtgenoot […]

LSH010 ONTBIJT: DONDERDAG 9 DECEMBER 2021
november 22, 2021
Op donderdagochtend 9 december vindt het LSH010 ontbijt weer plaats! Het thema: Hoe valideer ik mijn zorgidee? – Van waardepropositie naar businessmodel. Hier behandelen we een LSH010 case over het innovatieprogramma ZorgTech. Datum: donderdag 9 december 2021Locatie: VirtueelTijd plenaire sessie: 8.00 – 9.00Smart sessies: 09.15 – 10.151 op 1 sessies: 9 december & 10 december PROGRAMMA LSH010 ONTBIJT 07.45 – 08.00 – INLOOP 08.00 – 08.05 […]

Maria van Hoffen: Stress and sickness absence, prediction and causal mechanisms of mental sickness absence
november 22, 2021
Vrijdag 26 november 2021Promotie (VU), 13:45 u, Aula Link naar proefschrift

Linda Bonnie: A closer look at entrustment | A study into entrustment in workplace-based medical education, with a focus on EPAs and the role of contextual factors
november 22, 2021
Vrijdag 26 november 2021Promotie (UvA), 10:00 u, AgnietenkapelLinda Bonnie: A closer look at entrustment | A study into entrustment in workplace-based medical education, with a focus on EPAs and the role of contextual factors Link naar proefschrift

Marco Haselager: From signaling to survival | Dissecting drug resistance and proliferation in CLL
november 22, 2021
Donderdag 25 november 2021Promotie (UvA), 16:00 u, AgnietenkapelLink naar proefschrift

Elizabeth Wahome: Acute HIV infection identification and PrEP eligibility, uptake and adherence among MSM followed in a HIV vaccine feasibility cohort study in coastal Kenya
november 22, 2021
Woensdag 24 november 2021Promotie (UvA), 10:00 u, Agnietenkapel Link naar proefschrift

Zhongfang Fu: Bridging the mental health gap in the digital age
november 22, 2021
Dinsdag 23 november 2021Promotie (UvA), 12:00 u, Agnietenkapel Link naar proefschrift

Niki Rensen: Parents of children with cancer: sleep, distress and quality of life
november 22, 2021
Woensdag 24 november 2021Promotie (VU), 15:45 u, Aula Elk jaar krijgen ongeveer 600 kinderen in Nederland kanker. Dit heeft een grote impact op het hele gezin en zeker ook op ouders. Ouders ervaren veel stress en vaak slaapproblemen. Stressgevoelens en slaapproblemen kunnen elkaar bovendien versterken en in stand houden. In hoeverre dit een rol speelt […]

Max Senders: Precision imaging and nanoimmunotherapy for inflammatory atherosclerosi
november 22, 2021
Woensdag 24 november 2021Promotie (UvA), 14:00 u, Aula Atherosclerotische plaques (aderverkalkingen) zijn een belangrijke oorzaak van hart- en vaatziekten. Ze kunnen uiteindelijk leiden tot een hartinfarct, een beroerte of vernauwde of afgesloten aders. De afgelopen decennia werden we ons bewust van de risico’s op hart- en vaatziekten, en is er meer aandacht gekomen voor preventie. […]

3D-geprinte kappenbril houdt zonlicht perfect tegen
november 22, 2021
José: “De kappenbril beschermt mijn ogen aan alle kanten tegen fel zonlicht. Het mooiste is dat hij lijkt op een gewone zonnebril. Voorheen zette ik altijd snel mijn bril af als er een foto werd gemaakt. Maar nu houd ik hem gewoon lekker op!” Nachtblindheid, daar begon het mee. José Hamers (59) uit Haarlem zag […]

Wat wordt het meest misleidende product van 2021?
november 22, 2021
Nominaties Gouden Windei-verkiezing bekend. Stembussen geopend. De drie genomineerden voor de elfde editie van de verkiezing voor het Gouden Windei zijn bekend. Ieder jaar organiseert voedselwaakhond? foodwatch ?deze verkiezing voor het meest misleidende voedselproduct van het jaar. Veel producenten gebruiken verborgen boodschappen of valse versiertrucs. Het Gouden Windei legt de verborgen boodschappen achter claims bloot.? Foodwatch heeft zich […]

Winnaars Rotterdamse Kinderrechten Award 2021!
november 22, 2021
Stichting JAN en Kerensa Timar zijn de winnaars geworden van de Rotterdamse Kinderrechten Award! Dit werd zaterdag 20 november jl. bekend gemaakt op het Kinderrechtenfestival in Plaswijckpark, georganiseerd door Thuis op Straat (TOS) en Unicef in samenwerking met de gemeente Rotterdam. Met het uitreiken zet de gemeente Rotterdam organisaties én personen in het zonnetje, die […]

Webinar: Samen gaan voor goede zorg voor het zieke kind in de eigen omgeving
november 19, 2021
Aan de slag met MKS: Medische Kindzorg Samenwerking In de zorg voor het kind met een zorgbehoefte en het gezin thuis is samenwerking belangrijk. Samenwerking met het kind en zijn gezin en met de betrokken professionals.Want hoe zorg je dat je weet wat kind en gezin thuis nodig (gaan) hebben? Onder welke wetgeving een kind […]

Deze week in EW: Beste ziekenhuizen en klinieken 2021
november 18, 2021
Zestig ziekenhuizen en klinieken mogen zich dit jaar winnaar noemen van het EW-onderzoek Beste ziekenhuizen en klinieken. Ze behalen de maximale score voor één van de zeven behandelingen waarvan de kwaliteit van zorg is onderzocht. Het gaat om onder meer het Elisabeth-Tweesteden Ziekenhuis in Tilburg voor het plaatsen van een heupprothese, het Alexander Monro Ziekenhuis in Bilthoven […]

Aantal nieuwe hiv-diagnoses in 2020 in Nederland opnieuw gedaald, einde van hiv in Nederland is echter nog niet in zicht
november 18, 2021
Met 411 nieuwe hiv-diagnoses in 2020 ligt Nederland goed op koers om de drie doelen uit het Nationaal Actieplan soa, hiv en seksuele gezondheid te halen. Een halvering van het aantal nieuwe hiv-diagnoses in 2022 ten opzichte van 2015 (toen 894), is in 2020 zelfs al gerealiseerd. Het tweede doel, dat stelt dat 95% van […]

ETZ onderstreept belang ziekenhuis Waalwijk
november 17, 2021
Verkenning mogelijkheden om huidige gebouw te vervangen door nieuwbouw Patiënten kunnen ook de komende jaren in locatie ETZ Waalwijk terecht voor poliklinische en niet-complexe zorg, eenvoudige diagnostiek en chronische vervolgzorg. De raad van bestuur van het ETZ (Elisabeth-TweeSteden Ziekenhuis) volgt hiermee het advies op van een interne werkgroep die in een notitie heeft vastgelegd welke […]

Tweede bevrijdingsconcert My Breath My Music
november 17, 2021
Na het grote succes van 4 juli organiseert My Breath My Music het tweede bevrijdingsconcert van dit jaar: Wish you were here. Verschillende met My Breath My Music verbonden muzikanten en huisband De Bridge treden op. Stichting My Breath My Music ontwikkelt en produceert sinds 2009 speciale muziekinstrumenten die eenvoudig en licht te bedienen zijn, […]

VieCuri verzorgt oncologische zorg aan huis
november 17, 2021
Steeds meer zorg kan verplaatst worden van het ziekenhuis naar de patiënt thuis. VieCuri verzorgt in dit kader oncologische zorg aan huis. Oncologieverpleegkundigen van VieCuri verzorgen de toediening van de geneesmiddelen. Service voor de patiënt VieCuri heeft al ervaring met het aanbieden van medische zorg aan huis. Sinds 2016 wordt er bijvoorbeeld voor bepaalde patiënten […]

Rijndam wint Revalidatie jaarprijs voor innovatieve patiëntenzorg
november 15, 2021
Rijndam wint de Revalidatie Jaarprijs met de productontwikkeling ‘Ziggy’. Deze innovatieve aanpassing aan een rolstoel maakt het mogelijk dat degene die de rolstoel duwt niet achter, maar naast de rolstoel loopt. Dit zorgt voor een betere interactie met de persoon die in de rolstoel zit. Met het winnende geldbedrag van € 20.000 gaat Rijndam samen […]

Rozijnen als ‘gezond tussendoortje’ zwaar vervuild met cocktail van bestrijdingsmiddelen.
november 15, 2021
Foodwatch roept supermarkten op maximum aan pesticiden per product te hanteren. Rozijnen worden door veel ouders gezien als gezond tussendoortje voor hun kinderen. Onderzoek van voedselwaakhond Foodwatch toont echter aan dat rozijnen in toenemende mate zwaar vervuild zijn met bestrijdingsmiddelen — tot wel 30 soorten gif per meting. HetVoedingscentrum beveelt de consumptie van rozijnen aan als gezond tussendoortje […]

Specialist Ouderengeneeskunde bij Samen Professionals
november 11, 2021
Functieomschrijving Ben jij als Specialist Ouderengeneeskunde op zoek naar een nieuwe werkomgeving? Wil jij jezelf als medisch specialist graag inzetten om cliënten de beste zorg te leveren en zoveel mogelijk hartverwarmend thuis te laten voelen? Dan zoeken wij jou!Als Specialist Ouderengeneeskunde werk je in het intramurale expertiseteam samen met een arts, GZ-psycholoog en een activiteitenbegeleider. […]

Eerste ronde Faculty of Impact over energietransitie en duurzaamheid
november 11, 2021
De eerste ronde van de Faculty of Impact richt zich op energietransitie en duurzaamheid. Potentiële kandidaten kunnen zich vanaf vandaag aanmelden. De Faculty of Impact biedt wetenschappers ondersteuning en coaching bij hun ambitie om de impact van hun onderzoek te vergroten, in de vorm van een eigen non-profit organisatie of commercieel bedrijf. Het nationaal programma […]

HEALTHY FUNDING V – INTERNATIONAL MATCHMAKING EVENT 18 NOVEMBER 2021
november 10, 2021
Do you own a Life Sciences & Health start-up or scale up and do you want to grow and/or scale up further? During Healthy Funding V we will match young, ambitious companies with an investment need 1-on-1 to relevant investors and funds. This time, Healthy Funding V is once again all about Matchmaking and the […]

LSH010 ONTBIJT: DONDERDAG 9 DECEMBER 2021
november 10, 2021
LSH010 ONTBIJT: DONDERDAG 9 DECEMBER 2021 Op donderdagochtend 9 december vindt het LSH010 ontbijt plaats. Het LSH010 ontbijt stimuleert innovatie en samenwerking in de Rotterdamse life sciences & health-sector. De netwerkbijeenkomst vindt tenminste vier keer per jaar plaats. De presentatie van een succesvolle case, vooraf te initiëren een-op-een-ontmoetingen én een lekker en gezond ontbijt zijn […]

RTV RIJNMOND: HET HART VAN ROTTERDAM – LIFE SCIENCE & HEALTH ONDERNEMERS
november 10, 2021
Met een klinische en intellectuele aanjager van medisch onderzoek als basis, zijn er steeds meer Life Science & Health ondernemers die zich rond het Erasmus MC vestigen. We spreken Berry Kriesels, oprichter van Omnigen. Zijn bedrijf onderzoekt door DNA analyse, of alvleesklierkanker patiënten baat gaan hebben bij de bestaande medicatie. Hij is een echte Rotterdammer […]

Acht aanbevelingen voor medisch-generalistische zorg gepubliceerd
november 10, 2021
Dinsdag 9 november heeft een expertgroep op het gebied van medisch-generalistische zorg (MGZ) de notitie ‘Acht aanbevelingen voor medisch-generalistische zorg’ aangeboden aan het ministerie van Volksgezondheid, Welzijn en Sport. Directeur-Generaal Langdurige Zorg Ernst van Koesveld nam de notitie namens het ministerie in ontvangst. Aanbevelingen voor toekomstbestendige MGZ MGZ is de geneeskundige zorg die huisartsen, specialisten […]

Meerderheid staat open voor nieuwe traditie bij jaarwisseling
november 9, 2021
Buurtfeest op straat populairste alternatief voor vuurwerk Zeist, 9 november 2021 – In plaats van zelf vuurwerk afsteken kunnen we ook naar een vuurwerkshow of op zoek naar andere en nieuwe tradities om feestelijk oud en nieuw te vieren. Dat vindt 56 procent van de Nederlanders. Bijna een derde vindt een georganiseerd buurtfeest op straat […]

Svenna Verhiel: Outcomes and Challenges in Ulnar-sided Wrist Surgery
november 9, 2021
Vrijdag 12 november 2021 Promotie (VU), 13:45 u, Aula Svenna Verhiel: Outcomes and Challenges in Ulnar-sided Wrist Surgery Link naar proefschrift

Melissa Stunnenberg: Abortive HIV-1 RNA in the induction of immunity
november 9, 2021
Vrijdag 12 november 2021 Promotie (UvA), 10:00 u, Agnietenkapel Melissa Stunnenberg: Abortive HIV-1 RNA in the induction of immunity | Shaping immune responses via viral sensors Link naar proefschrift

Mareen Datema: Food sensitization and allergy: defining phenotypes and their risk factors and biomarkers
november 9, 2021
Donderdag 11 november 2021 Promotie (UvA), 16:00 u, Agnietenkapel Mareen Datema: Food sensitization and allergy: defining phenotypes and their risk factors and biomarkers IgE (Immunoglobuline E) is een type antilichaam dat voorkomt bij mensen met een voedselallergie. Door te testen op IgE wordt vastgesteld of iemand een voedselallergie heeft. Toch betekent de aanwezigheid van IgE- antistoffen niet automatisch dat iemand allergisch is voor bepaalde voeding. Ook is aan de hoeveelheid gemeten IgE tniet te zien of iemand milde of ernstige klachten heeft. Om zeker te zijn van […]

Svitlana Podliesna: A quest for novel players in cardiac electrical function
november 9, 2021
Maandag 8 november 2021 Promotie (UvA), 16:00 u, Agnietenkapel Svitlana Podliesna: A quest for novel players in cardiac electrical function Link naar proefschrift

70 procent van kindervoeding in supermarkt is ongezond
november 9, 2021
Eerste gezonde, gepasteuriseerde én houdbare babyvoeding Amsterdam, maandag 8 november, 2021- In deze coronatijden is het belangrijk dat ook baby’s, peuters en kleuters bouwen aan hun immuunsysteem. Familiebedrijf Kesbeke en Chef Jasmine slaan de handen ineen en introduceren Babe pure baby food: de eerste houdbare biologische babyvoeding met 100% vitaminebehoud, die slechts een milde hittebehandeling ondergaat […]

Nieuwe “fit en vitaal formule” Huóli Lounge opent in Heerde
november 9, 2021
Heerde – Op een verantwoorde manier bewegen, sporter of niet, onder de juiste begeleiding is wat Huólì Lounge biedt: in een luxe kleinschalige setting op effectieve innovatieve wijze persoonlijke doelen behalen. Uniek is het bewegen met EMS pakken en de speciale Energie Lounge. 1 uur aanwezig zijn staat gelijk aan 2-3 uur intensief sporten. De […]

Brabants Boek Present Tijdelijk Verblijf in gesproken vorm en braille beschikbaar voor mensen met een leesbeperking.
november 9, 2021
Tilburg, 6 november 2021 – Op zaterdag 6 november is de eerste toegankelijke versie van het Brabants Boek Present Tijdelijk Verblijf gepresenteerd. De Commissaris van de Koning in Noord-Brabant Ina Adema overhandigde Tijdelijk Verblijf in braille en in gesproken vorm aan auteur Vrouwkje Tuinman en Wilma Lems, klant van Passend Lezen; de bibliotheek voor mensen met een leesbeperking. De overhandiging […]

Hoogste punt OK-complex Wilhelmina Ziekenhuis Assen bereikt
november 9, 2021
ASSEN – Het hoogste punt van het nieuwe OK-complex van het Wilhelmina Ziekenhuis Assen (WZA) is bereikt. De bescheiden viering van het hoogste punt vond woensdag plaats in de toekomstige operatiekamers. De vlag die het hoogste punt markeert, wappert op 17 meter boven het maaiveld. Na eerdere verbouwingen aan de Intensive Care, het Ouder en […]

ETZ en VGZ sluiten overeenkomst voor 2022-2026
november 9, 2021
Het ETZ (Elisabeth-TweeSteden Ziekenhuis) in Tilburg/Waalwijk en zorgverzekeraar Coöperatie VGZ sluiten opnieuw een strategisch samenwerkingsverband voor een periode van vijf jaar. Beide alliantiepartners zijn erg tevreden over de resultaten tot nu toe en zetten hun ambitie om de zorg zinniger en toekomstbestendig te organiseren graag samen voort. Hiervoor zijn meer innovaties (groot en klein) nodig. […]

Isala start met tweede Da Vinci operatierobot
november 8, 2021
Isala breidt het aantal robot-geassisteerde operaties uit en heeft daarvoor een tweede robotsysteem aangeschaft. Vanaf deze week zet Isala de robot ook in bij operaties voor dikke darmkanker, alvleesklierkanker, blaaskanker, leveroperaties en gynaecologische ingrepen. Sinds 2011 opereren artsen in Isala met de operatierobot. Isala voerde de afgelopen jaren honderden ingrepen uit met robotchirurgie, onder andere […]

Onderzoekers positief over open science, maar ook nog barrières
november 8, 2021
87% van alle onderzoekers heeft een (zeer) positieve houding over open science. Jonge wetenschappers zijn met een percentage van 94% zelfs nog enthousiaster. Maar bij de praktische uitvoering ervaren onderzoekers ook nog barrières. Dat blijkt uit een peiling in opdracht van NWO onder onderzoekers uit alle vakgebieden. De ambitie en de dagelijkse realiteit komen het […]

HERSTELD VAN COVID-19 DANKZIJ BIOCHECK
november 4, 2021
Petra Graafland (51), Klinisch chemisch analist bij het IJsselland Ziekenhuis en moeder van drie kinderen, volgde het BioCheck-programma om te herstellen van de gevolgen van COVID-19: “Met reguliere fysiotherapie kwam ik niet verder.” 1 april 2020, een datum die de Rotterdamse Petra Graafland zich nog lang zal herinneren. Het was de dag dat ze ziek […]

Bril op maat voor mensen met een verstandelijke beperking
november 4, 2021
Mensen met een verstandelijke beperking hebben vaker moeite met zien. Een deel van deze doelgroep heeft ook nog eens een afwijkende vorm van de schedel en/of het gezicht. Een gewone bril is dan geen goede oplossing. Philadelphia Zorg werkt daarom sinds kort samen met Maatbril. Tanja Baack, beleidsadviseur van Philadelphia’s Horen en Zien-team, vertelt waarom […]

Ikazia Ziekenhuis neemt nieuwe kinderafdeling in gebruik
november 3, 2021
Het Rotterdamse Ikazia Ziekenhuis opende dinsdag 2 november de deuren van een nieuwe kinderafdeling. Op deze kinderafdeling springen kleurrijke wand- en vloertekeningen van Rotterdamse iconen en dieren in het oog. Johan de Kat is manager van het Moeder en Kind Centrum in Ikazia en vertelt: “De afdeling is voor patiënten tussen de 0 en 18 […]

Opnamestop ziekenhuis VieCuri
november 3, 2021
Ziekenhuis VieCuri, met locaties in Venlo en Venray, heeft per direct een opnamestop afgekondigd. Vanwege de buitengewoon hoge aantallen patiënten (zowel regulier, covid, als patiënten die met spoed binnenkomen) in combinatie met een beperkte uitstroom en daarmee een overvol ziekenhuis, moest VieCuri vandaag, dinsdag 2 november sinds 14.10u, overgaan tot een opnamestop. Een niet alledaagse […]

Negen Medical Delta professoren gelijktijdig geïnstalleerd met dubbelbenoeming
november 3, 2021
Delft, 2 november 2021 – Vandaag zijn negen hoogleraren gelijktijdig geïnaugureerd als ‘Medical Delta hoogleraar’ bij de Universiteit Leiden, het LUMC, de TU Delft, Erasmus Universiteit en/of het Erasmus MC. Met een aanstelling bij tenminste twee van deze vijf academische instellingen combineren zij technologie en gezondheidszorg in hun hoogleraarschap. Medical Delta is een samenwerkingsverband tussen […]

Aantal zonnepanelen in Rotterdam verdrievoudigd
november 3, 2021
Het aantal zonnepanelen op de Rotterdamse daken neemt flink toe. Waar in 2018 nog 100.000 panelen werden geteld is dat aantal in drie jaar tijd verdrievoudigd naar ruim 300.000 panelen. Dit staat gelijk aan ruim 80 MegaWattpiek opgesteld vermogen, goed voor 27.840 huishoudens. De mijlpaal van 300.000 zonnepanelen werd vandaag bereikt dankzij ondermeer de bijdrage […]

LIVECAST 2021 REDISCOVERING HEALTH
november 3, 2021
Voor als je het gemist hebt: graag nodigen we jou uit voor de tweede editie van de Alles is Gezondheid LIVECAST: een blikverruimende uitzending voor alle vooruitstrevende gezondheidsprofessionals in Nederland. Rediscovering Health 2021 is het jaar van nieuwe sporen en veranderende gewoontes. We herontdekken gezondheid en leefstijl. Zoeken naar de mentale balans. En voelen dat […]

Museum Het Schip, Natuurhistorisch Museum Rotterdam en Rijksmuseum Muiderslot in de race voor de RAAK Stimuleringsprijs 2021
november 3, 2021
Welk museum heeft het beste plan voor een inclusieve museumervaring voor mensen met een visuele beperking en wint daarmee de RAAK Stimuleringsprijs 2021? Tot en met 30 november kan het grote publiek via de website stemmen op de drie kanshebbers: Museum Het Schip (Amsterdam), Natuurhistorisch Museum Rotterdam en Rijksmuseum Muiderslot (Muiden). “Tijdens de lockdown konden […]

Neurovasculair Expertisecentrum biedt excellente patiëntenzorg
november 3, 2021
Het ETZ (Elisabeth-TweeSteden Ziekenhuis) is weer een ‘topklinische’ zorgfunctie rijker. De Samenwerkende Topklinische opleidingsZiekenhuizen (STZ) heeft het ETZ bestempeld als ‘Neurovasculair Expertisecentrum’, waar vaatafwijkingen in de hersenen en het zenuwstelsel worden behandeld. Radiologen Hans Kortman en Issam Boukrab zijn zeer content met de erkenning. “Een bevestiging dat patiënten in ons centrum verzekerd zijn van hooggespecialiseerde […]

Met buitengewone tips fit de herfst door
oktober 28, 2021
De komende maanden krijg je de beste tips uit ons netwerk voor een gezond leven en om lekker in je vel te zitten. Zowel fysiek als mentaal. De campagne is deze maand gestart met de Buitenpsychologen; Irina & Christel. Samen geven ze wandeltherapie in de natuur en delen tips waar iedereen wat aan heeft. Juist […]

Unieke oplossing voor kinderen met lui oog
oktober 28, 2021
Een lui oog komt bij kinderen veel voor. Het oog kan wel zien, maar wordt niet (of minder goed) gebruikt, waardoor het andere oog het overneemt. De standaardbehandeling: het ‘goede’ oog afplakken om zo het luie oog te trainen. Ook Christina Engels uit Wijchen kreeg dit advies van de oogarts. Het pleisters plakken werd echter […]

Ook na corona blijven we videobellen met de oogarts
oktober 27, 2021
Een consult met de oogarts via videobellen is een blijvertje, ook na corona. Over deze stelling gaan professionals en ervaringsdeskundigen met elkaar in gesprek tijdens het slotwebinar van het online Oogcongres 2021 op maandagavond 8 november. In coronatijd was het vaak noodzaak mensen met een oogprobleem op afstand te begeleiden. Uit onderzoek blijkt dat dit […]

Muziek aan Bed in het IJsselland Ziekenhuis
oktober 26, 2021
Hoe waardevol muziek kan zijn… Het kan zo fijn zijn om even afleiding te hebben tijdens een ziekenhuisopname. Daarom is het IJsselland gestart met Muziek aan Bed. Donderdag 21 oktober kwamen twee cellisten voor het eerst naar het ziekenhuis om muziek te spelen voor de patiënten. Dat was een groot succes. Veel patiënten genoten van […]

Veel misverstanden over prostaatkanker
oktober 26, 2021
Feit is dat 3.000 mannen overlijden per jaar Het is bijna november oftewel Movember, de maand die in het teken van prostaatkanker staat. En die aandacht voor de prostaat is hard nodig, volgens professor Frans Debruyne van het Andros Prostaatkankercentrum. Want over prostaatkanker bestaat veel verwarring. Hij zet de drie grootste misverstanden op een rij. […]

Nieuwe beademingsapparaten preciezer en veiliger voor patiënten
oktober 26, 2021
ASSEN – Sinds deze maand gebruikt de operatieafdeling van het Wilhelmina Ziekenhuis Assen (WZA) nieuwe, zeer geavanceerde anesthesie-beademingsapparatuur. Deze apparaten gaan zuiniger om met anesthesiegassen, wat bijdraagt aan minder uitstoot van broeikasgassen. Ook voor patiënten is de nieuwe apparatuur een verbetering. “Met deze beademingsapparatuur kunnen we nog preciezer en veiliger de patiënt beademen. Dat is […]

Ook in Spaarne Gasthuis aandacht voor bloedserieus probleem
oktober 26, 2021
Iedere vrouw met hevig bloedverlies tijdens de menstruatie heeft een verhaal. Een bloedserieus verhaal. Dat hoor je alleen zelden en dat is raar. Menorragie is namelijk een medische aandoening die nogal wat impact heeft: lichamelijk, psychisch en sociaal. Toch gaat bijna de helft van de vrouwen nog altijd niet naar de huisarts. Iedere vrouw met […]

D-THINK HEALTH COURSE – 24 March 2022
oktober 25, 2021
D-THINK HEALTH COURSE Do you want to learn how to innovate in healthcare? REGISTER now for the D-THINK HEALTH course 3! Healthcare organisations from previous editions are already implementing the learned innovative design thinking tools and are innovating their organisations! “The D-Think Workshop was an excellent experience. I loved the hands-on exercises and the fantastic […]

WZA en Interzorg ondertekenen overeenkomst medicijnresten in afvalwater
oktober 21, 2021
ASSEN – Minder medicijnresten in het afvalwater: dat is het doel van het convenant ‘Netwerk Medicijnresten Noord-Nederland’. Tijdens de Week van het Water tekenen ook het Wilhelmina Ziekenhuis Assen (WZA) en Interzorg Noord-Nederland dit convenant. Het is onderdeel van de ‘Green Deal Zorg 2.0, afspraken over duurzame zorg in een gezonde toekomst’, die beide zorgorganisaties al eerder ondertekenden. […]

Martini Ziekenhuis loopt landelijk voorop in de nieuwe endoscopische wervelkolomtechniek
oktober 20, 2021
Het Martini Ziekenhuis is afgelopen week als eerste ziekenhuis van Nederland gestart met endoscopische nekoperaties. Patiënten met een nekhernia kunnen bij het Martini Ziekenhuis voortaan geholpen worden met een minimaal invasieve operatie. De behandeling is minder ingrijpend voor patiënt en patiënten herstellen veel sneller van de operatie. Bij een operatie voor een nekhernia wordt vaak […]

D-THINK HEALTH COURSE: BINNEN TWEE WEKEN EFFECTIEF LEREN INNOVEREN
oktober 19, 2021
‘GGZ Delfland heeft dankzij onze cursus VR succesvol geïmplementeerd’ Hoe implementeer je een innovatie binnen de gezondheidszorg? Het is een uitdaging waar veel organisaties tegenaan lopen. Tijdens de D-THINK HEALTH COURSE leren deelnemers door middel van design thinking effectief te innoveren. ‘Na twee weken snap je hoe je innovaties effectief kunt toepassen,’ zegt docent Tessa […]

Ikazia Ziekenhuis start met Centering Zwangerschap
oktober 18, 2021
De komst van een baby brengt veel veranderingen en vragen met zich mee. Niet alleen gezondheidsvragen maar ook allerlei praktische vragen. Daarom is het Rotterdamse Ikazia Ziekenhuis gestart met CenteringZwangerschap (ook bekend als CenteringPregnancy). Dit is een groepsprogramma waarin alle informatie rondom zwangerschap, de bevalling en de eerste babytijd samenkomt. Het unieke aan CenteringZwangerschap is […]

Noordwest start met nieuwbouw fase 1 op locatie Alkmaar
oktober 18, 2021
Noordwest Ziekenhuisgroep gaat van start met de aanleg van nieuwbouw fase 1 op het terrein van hoofdlocatie Alkmaar. De eerste werkzaamheden bestaan uit de realisatie van de bouwkuip, met daarin de fundering voor het ziekenhuisgebouw en de 1-laagse ondergrondse parkeergarage. Op 15 oktober 2021 contracteerde Noordwest hiervoor aannemingsbedrijf K_Dekker bouw & infra b.v. uit Warmenhuizen. […]

Zes basisscholen intensiveren armoedeaanpak
oktober 18, 2021
Om nog meer Rotterdammers in armoede met jonge kinderen te bereiken start op zes basisscholen een proef met een medewerker kansengelijkheid. Deze medewerker traint leerkrachten om signalen te herkennen en gaat met ouders in gesprek over de mogelijkheden om hun financiële situatie te verbeteren en te helpen bij het aanvragen van kindgebonden regelingen. Daarnaast loopt er […]

Succesvol onderzoek naar verkorte anti-bloedplaatjestherapie
oktober 14, 2021
Peter Smits, cardioloog in het Maasstad Ziekenhuis, heeft de afgelopen vier jaar als hoofdonderzoeker gewerkt aan een onderzoek dat heeft bewezen wat de juiste duur is van anti-bloedplaatjestherapie voor hoog bloedingsrisico patiënten na een dotterbehandeling. Uit het onderzoek blijkt dat bloedplaatjesremmers aanzienlijk korter kunnen worden toegediend. Het onderzoek is na kennisgeving op het Europees Cardiologie […]

Oproep huisartsen en ziekenhuis in borstkankermaand: ‘goed kijken’
oktober 13, 2021
Borstkanker is vaak goed te behandelen, als je tijdig doorhebt dat er ‘iets niet klopt’. Een bobbeltje, verkleuring of verharding kan een teken zijn van een tumor in de borst. Vroeger was de oproep aan vrouwen om elke maand aan de borsten te voelen of er een knobbeltje zat. Tegenwoordig is het motto: ‘goed kijken’. […]

Ikazia breidt digitale zorg uit met de Thuismeten app
oktober 12, 2021
Het Ikazia Ziekenhuis breidt vanaf oktober de digitale zorg bij het specialisme cardiologie uit met de Thuismeten app van Luscii. Het Rotterdamse ziekenhuis werkt al enige tijd met verschillende apps om zorg op afstand te kunnen verlenen en de informatievoorziening beter bij de patiënt aan te laten sluiten. Met de Thuismeten app gaat Ikazia patiënten […]

LIVECAST 2021: REDISCOVERING HEALTH
oktober 11, 2021
Graag nodigen we jou uit voor de tweede editie van de Alles is Gezondheid LIVECAST: een blikverruimende uitzending voor alle vooruitstrevende gezondheidsprofessionals in Nederland. DIRECT AANMELDEN Rediscovering Health 2021 is het jaar van nieuwe sporen en veranderende gewoontes. We herontdekken gezondheid en leefstijl. Zoeken naar de mentale balans. En voelen dat vitaliteit aan kracht wint. […]

Kinderen hebben meer psychische problemen sinds de coronapandemie
oktober 11, 2021
Tijdens de coronapandemie voelden kinderen en jongeren zich angstiger en somberder. Dit blijkt uit onderzoek van een Nederlands consortium in 2020. Projectleider Tinca Polderman en onderzoeker bij Kinder- en jeugdpsychiatrie van Amsterdam UMC: “De data geven aan dat meer jongeren ondersteuning of behandeling nodig hebben.” De resultaten van het onderzoek zijn vandaag als voorpublicatie gepubliceerd. Ouders van […]

Patiënt in palliatieve fase ervaart grote informatiekloof
oktober 11, 2021
Naar schatting heeft zo’n 70 procent van alle mensen die jaarlijks overlijdt behoefte aan palliatieve zorg. Uit onderzoek blijkt echter dat veel mensen niet precies weten wat deze zorg inhoudt en er veel behoefte is aan informatie over kwaliteit van leven, ondersteunende zorg en het levenseinde. De vernieuwde website overpalliatievezorg.nl, die is opgezet door de […]

Witte kleurstof E171 potentieel kankerverwekkend
oktober 11, 2021
De Europese Commissie en de lidstaten zijn het er eindelijk over eens: er komt een verbod op het additief ’titaniumdioxide’ of E171 in alle voedingsmiddelen in de Europese Unie. De jarenlange campagne van voedselwaakhond foodwatch om het omstreden additief uit voeding te halen heeft vruchten afgeworpen. Producenten gebruiken E171 om levensmiddelen een witte kleur of glans […]

Ingang ETZ Elisabeth kleurt blauw en roze
oktober 7, 2021
Jaarlijks overlijden in Nederland ongeveer 1.200 baby’s tijdens de zwangerschap en rond de geboorte. Het ETZ (Elisabeth-TweeSteden Ziekenhuis) vraagt aandacht voor de gevolgen van babysterfte door de hoofdingang van locatie ETZ Elisabeth een week lang blauw en roze te verlichten.Het ziekenhuis in Tilburg levert zo een bijdrage aan de Baby Loss Awareness Week. Onder het […]

De meest voorkomende vorm van kanker bij mannen boven de 45
oktober 7, 2021
November is movember! Dé maand waarin wereldwijd aandacht wordt gevraagd voor prostaatkanker, teelbalkanker en de gezondheid van de man in het algemeen. Prostaatcentrum Noord-Nederland(pcnn.nl) besteedt op 17 november specifiek aandacht aan prostaatkanker met een publiekslezing voor patiënten en overige geïnteresseerden. ‘Prostaatkanker is de meest voorkomende vorm van kanker bij mannen ouder dan 45 jaar. Daarom […]

Rotterdam. Sterker door alle Rotterdammers
oktober 6, 2021
College eert stadsgenoten op 3 containers met 123.000 Rotterdamse voornamen Rotterdam sleept zich door de coronacrisis heen dankzij zijn bewoners. Met die gedachte is de campagne ‘Rotterdam. Sterker door alle Rotterdammers’ gestart. Gisteren zijn in het centrum van de stad drie containers geplaatst met daarop de 123.000 unieke voornamen van Rotterdammers. Drie monumenten om Rotterdammers […]

HIV-expertisecentrum ETZ krijgt STZ-erkenning
oktober 6, 2021
Het ETZ (Elisabeth-TweeSteden Ziekenhuis) kan de twaalfde ’topklinische’ functie noteren. De Samenwerkende Topklinische opleidingsZiekenhuizen (STZ) heeft het ETZ bestempeld als ‘HIV-expertisecentrum Midden- en West-Brabant’. Het HIV-team is bijzonder trots op deze nieuwe STZ-erkenning. Om als ziekenhuis een STZ-erkenning te krijgen, moet je aan een aantal – strenge – criteria voldoen. Zo moet het specialisme een […]

Wat je ook rijdt, stop altijd!
oktober 5, 2021
Oogvereniging roept jonge bestuurders op te stoppen voor de witte stok Utrecht, 5 oktober 2021 – Onder het motto ‘Wat je ook rijdt, stop altijd!’ lanceert de Oogvereniging, belangen- en patiëntenorganisatie voor mensen met een oogaandoening, vrijdag 15 oktober op de Internationale Dag van de Witte Stok, de campagne Stop voor de Witte Stok!. In deze […]

Verbouw locatie Den Helder start met nieuwe gevel
oktober 4, 2021
Maandag 4 oktober start Noordwest met de vernieuwing en verduurzaming van de gevel van de hoofdlocatie in Den Helder. Het Noord-Hollandse bouwbedrijf Ooijevaar voert de werkzaamheden uit. Het vernieuwen van de gevel betekent de start van de complete verbouwing van het ziekenhuis, waarmee Noordwest de zorg voor de regio Kop van Noord-Holland verder toekomstbestendig maakt. […]

Bestaand medicijn verbetert prikkelverwerking bij kinderen met autisme
oktober 4, 2021
Een veilig medicijn tegen hoge bloeddruk helpt kinderen met autisme prikkels beter te verwerken; een studie van Amsterdam UMC bewijst dit. Daarnaast ontwikkelden de onderzoekers een algoritme dat helpt voorspellen voor welke kinderen dit middel werkt. “Deze methode brengt een eerste behandeling op maat in de kinder- en jeugdpsychiatrie”, aldus hoofdonderzoeker Hilgo Bruining. Het onderzoek is […]

Hulp voor (aanstaande) ouders om te stoppen met roken
oktober 4, 2021
Elk kind heeft het recht om rookvrij op te groeien. Om (aanstaande) ouders maximaal te ondersteunen om te stoppen met roken, is de ‘Taskforce Rookvrije Start Noord-Limburg’ opgericht. Deze maand, ‘Stoptober’, start een proef om (aanstaande) ouders door te verwijzen naar de huisarts voor hulp bij het stoppen. Uniek in deze aanpak is dat in […]

Amsterdamse ouderen profiteren van wetenschap Amsterdam UMC
september 30, 2021
UMC heeft samen met de Amsterdamse Coalitie ouderen een kennisagenda ouderen opgesteld. Doel is om de zorg voor ouderen in de stad te verbeteren. De kennisagenda koppelt wetenschappelijke kennis aan de zorgvraagstukken voor ouderen in de stad. Het is een groot thema in elk wetenschappelijk instituut: hoe zorg je ervoor dat de samenleving profiteert van […]

Fitter de operatie in met behulp van de app Fit4SurgeryTV
september 30, 2021
Het onderzoeksprogramma Fit4surgeryTV is van start gegaan bij Noordwest. Met Fit4SurgeryTV onderzoeken we het effect van prehabilitatie bij patiënten van 70 jaar en ouder die onder behandeling zijn voor darmkanker. Het programma helpt patiënten om zo fit mogelijk te worden voordat de operatie plaatsvindt. Noordwest heeft een app ontwikkeld om de patiënten tijdens de vier […]

Voedingsindustrie lobbyt tegen verplichte Nutri-Score
september 29, 2021
Foodwatch voert actie in Brussel tegen lobbygroep FoodDrinkEurope Voedselwaakhond foodwatch heeft de lobbyclub van de voedingsindustrie FoodDrinkEurope opgeroepen om te stoppen met de strijd tegen een verplicht voedselkeuzelogo op voedselverpakkingen. De voedingsindustrie lobbyt al meer dan 15 jaar tegen een helder en verplicht logo. Foodwatch roept op tot verplichte invoering van de Nutri-Score, zowel in Nederland als […]

Onveilige oversteekplaats noopt Oogvereniging tot hoger beroep tegen gemeente Kerkrade
september 29, 2021
Utrecht, juli 2021 – Stel je eens voor: je bent blind of slechtziend en je komt aan op een station waar je de bus wilt nemen naar de eindbestemming. Terwijl je met je stok de geleidelijn volgt bots je frontaal op een lantaarnpaal. En om de weg over te steken naar de bushalte moet je […]

Ziekenhuis Rivierenland behandelt samen met NOK patiënten met overgewicht
september 29, 2021
Ziekenhuis Rivierenland gaat in samenwerking met de Nederlandse Obesitas Kliniek (NOK) vanaf eind oktober bariatrische zorg leveren. Dit is de behandeling van patiënten met ernstig overgewicht (obesitas). In eerste instantie doet Ziekenhuis Rivierenland dit voor patiënten die op de wachtlijst staan van de NOK. De NOK doet de behandeling van de patiënten in het voor- en natraject. In de toekomst richt het […]

New Awareness Day Launched to Raise Global Awareness of Wolfram Syndrome – 1st
september 29, 2021
Wolfram Syndrome UK (WSUK) are collaborating with other Wolfram Syndrome Patient Organisations around the world for the first ever Wolfram Syndrome Global Awareness Day on 1st October 2021. This day will be the 23rd anniversary of the publication of the paper by the late Dr Alan Permutt from Washington University Hospital, St Louis, which first […]

Noordwest locatie Alkmaar duurzaam verwarmd via warmtenet
september 27, 2021
De Alkmaarse hoofdlocatie van Noordwest Ziekenhuisgroep is aangesloten op het warmtenet van HVC. Eerder werden Huize Westerlicht en de Labotheek al aangesloten en de geplande nieuwbouw van Noordwest krijgt ook een aansluiting. De warmte is afkomstig van een lokale warmtebron: de bio-energiecentrale van HVC, 3,4 km verderop. De aansluitingen betekenen een enorme verduurzaming van de […]

Ontmoeten is begroeten, wel zonder hand in ziekenhuis Rivierenland
september 27, 2021
In Ziekenhuis Rivierenland vindt een (officiële) begroeting voortaan zonder handen schudden plaats. Voor een aantal patiëntengroepen was dit al gebruikelijk, omdat zij een verlaagde weerstand hebben en door het schudden van handen lopen ze een extra risico. Ook door de coronapandemie was het handen schudden tijdelijk stopgezet. Ziekenhuis Rivierenland wil nu graag doorpakken en met […]

200 Rotterdammers met diabetes type 2 gezocht
september 27, 2021
· Lancering leefstijlprogramma ‘Diabetes in actie – editie 010’ · Unieke combinatie tussen technologie, leefstijlcoaching, beweging en zorg Rotterdam, 16 september 2021 – 200 Rotterdammers met diabetes type 2 krijgen de kans om de komende zeven maanden tijd hun gezondheid te verbeteren. MiGuide, Gezond op Zuid, Rotterdam Sportsupport en de gemeente Rotterdam ontwikkelden het nieuwe leefstijlprogramma ‘Diabetes […]

Patiënten met kanker fitter de behandeling in
september 27, 2021
Samen in Beweging! Een fitte patiënt herstelt beter na een behandeling en kan zo sneller zijn of haar dagelijks leven weer oppakken. Vanuit deze overtuiging bieden het Revalidatiecentrum Tolbrug, de Vughtse sportclub Prins Hendrik en het Jeroen Bosch Ziekenhuis een beweegaanbod op maat aan. Vooralsnog alleen aan patiënten met kanker maar de wens is het […]

Brabantse ziekenhuizen leiden samen meer zorgverleners op
september 27, 2021
Negen Brabantse ziekenhuizen slaan de handen ineen om samen meer zorgmedewerkers op te leiden én meer medewerkers te behouden voor de zorg. Er is een actieprogramma opgesteld gericht op verpleegkundige vervolg- én medische ondersteunende opleidingen. Concreet betekent dit dat er 10% meer wordt opgeleid en dat er minimaal 10% meer medewerkers behouden worden. Een regionale […]

Supermarkten willen nationale leeftijdsgrens energiedrankjes
september 23, 2021
Meerdere supers vragen wetgeving na oproep foodwatch Na gezondheidsproblemen bij jongeren door de consumptie van energiedrankjes en een alarm van kinderartsen, werd in 2018 onderhandeld over leeftijdsrestricties aan de kassa van supermarkten. Dit heeft vier jaar later echter weinig tot geen resultaten opgeleverd – op een leeftijdsgrens tot 14 jaar voor het kopen van energiedrankjes […]

KPN kiest voor duurzaam partnerschap met Dutch Health Hub
september 14, 2021
Utrecht, 14 september 2021. KPN Health, digitale partner van de zorgsector, kiest voor een duurzaam marketingpartnership met de Dutch Health Hub, het recent opgerichte kennis- en innovatieplatform dat een motor wil zijn voor toekomstbestendige zorg. KPN en de Dutch Health Hub zetten zich beide in voor een innovatieve digitaliseringsslag in de zorg en dat is […]

HIHR and EIT Health sign memorandum of understanding to combine start-up – investor platforms in Benelux
september 14, 2021
Healthy Ideas, Healthy Returns (HIHR) and EIT Health (part of the European Institute of Innovation and Technology) have signed a Memorandum of Understanding to facilitate collaboration in identifying and supporting promising early-stage start-up initiatives in the health and life sciences sector in Belgium, the Netherlands and Luxembourg (Benelux) by connecting them with potential investors and corporates. […]

Patiëntenportaal Ziekenhuis Rivierenland biedt meer mogelijkheden
september 14, 2021
MijnZR, het patiëntenportaal van Ziekenhuis Rivierenland, biedt nu nog meer mogelijkheden om je persoonlijke en medische gegevens in te zien en in contact te komen met de zorgverleners in het ziekenhuis. Onder het motto ‘Gebruik je MijnZR al?’ roept het ziekenhuis patiënten op om van deze mogelijkheden gebruik te maken. MijnZR bestaat bijna twee jaar. […]

“ESSM does it better”
september 10, 2021
oin the European Society for Sexual Medicine (ESSM) and the Dutch Society for Sexology (NVVS) for the ESSM Congress in Rotterdam, February 17–19, 2022. Visit congress website ESSM 2022 brings together scientists and healthcare professionals involved with sexual medicine from all around the world. We will put together a scientific program designed to provide attendees with […]

LSH010 ONTBIJT: DONDERDAG 9 DECEMBER 2021
september 10, 2021
LSH010 ONTBIJT: DONDERDAG 9 DECEMBER 2021 Op donderdagochtend 9 december vindt het LSH010 ontbijt plaats. Het LSH010 ontbijt stimuleert innovatie en samenwerking in de Rotterdamse life sciences & health-sector. De netwerkbijeenkomst vindt tenminste vier keer per jaar plaats. De presentatie van een succesvolle case, vooraf te initiëren een-op-een-ontmoetingen én een lekker en gezond ontbijt zijn […]

The foremost life sciences business network event in the Netherlands
september 10, 2021
The Netherlands is home to 2,900 innovative Life Sciences businesses, including 420 biopharmaceutical companies, and the European Medicines Agency, making it one of the most concentrated Life Sciences and Health clusters in the world. About 770 clinical trials are currently active in the Netherlands and the country boasts a competitive international business climate which is […]

HEALTHY FUNDING V – INTERNATIONAL MATCHMAKING EVENT 18 NOVEMBER 2021
september 10, 2021
Do you own a Life Sciences & Health start-up or scale up and do you want to grow and/or scale up further? During Healthy Funding V we will match young, ambitious companies with an investment need 1-on-1 to relevant investors and funds. This time, Healthy Funding V is once again all about Matchmaking and the […]

Medical Delta Conference 2 November 2021
september 10, 2021
Theme: ‘MedTech Solutions for a Healthier Tomorrow’ The health & technology ecosystem of the delta region and beyond will come together on Tuesday 2 November during the Medical Delta Conference 2021. In addition to an interesting substantive program, the nine new appointed Medical Delta professors will give their inaugural lectures. Program 14:30-15:00 – Check-in with […]

DRIVE 2021
september 10, 2021
Design Research & Innovation Festival DRIVE komt er weer aan! Net als vorig jaar strijkt het Design Research & Innovation Festival dit jaar neer in De Effenaar, tijdens de Dutch Design Week. En net als vorig jaar maken we er – samen met Design United – een hybride en interactief evenement van, waar jij vanuit huis bij […]

Health-RI, geared up to accelerate
september 10, 2021
Join us at our live meeting at Jaarbeurs Media Plaza in Utrecht to contribute to a national health data infrastructure for research and innovation. Save the date: Tuesday, October 5th 2021, The Dutch cabinet has selected Health-RI’s National Growth Fund proposal for a national health data infrastructure. Now, Health-RI is making preparations to quickly take the necessary steps forward. Our journey along the Growth Fund trajectory will start on Tuesday October 5th at the Health-RI Accelerator meeting in Utrecht. We […]

WORLD OF HEALTH CARE 28, 29 & 30 SEPTEMBER 2021
september 10, 2021
The Covid-19 pandemic has clearly demonstrated a need to transform both the organization and delivery of health care on a global level. Of course, it also revealed the ingenuity and resilience of health care workers and business leaders, who met 2020’s global health care challenges head-on with new, sustainable solutions. From improving organization efficiency and […]

TRAINING AGILE UX: LEIDERSCHAP EN INNOVATIE
september 10, 2021
Komen ideeën niet snel genoeg tot uitvoering? Door alle kansen en veranderingen is het lastig om focus op innovatie aan te brengen. In deze training leer je hoe je exploratief onderzoek kunt toepassen en hoogwaardige digitale klantervaringen kunt realiseren. Locatie: Rotterdam, Amsterdam of onlineDatum: 27 & 28 september, 1 & 2 november of 13 & 14 decemberDuur: 2 […]

(R)EVOLUTION 25 september t/m 2 oktober
september 9, 2021
Laten we er niet om heen draaien: sinds de uitbraak van het coronavirus is niets meer zoals het was. Het is zoeken naar nieuw perspectief. Een nieuwe wereld. Een nieuwe identiteit. Een nieuwe toekomst. Deze tijd vraagt flexibiliteit van ons als samenleving, veerkracht van ons als mens en een nieuwe blik op onze toekomst. Want […]

PITCH Masterclass by pitch coach David Beckett
september 9, 2021
– 24 September 2021 Do you own a Life Sciences & Health startup or scale up and do you want to grow and/or scale up further? Then register now for Healthy Funding V on November 18! www.healthyfunding.nl. Healthy Funding is also organizing several masterclasses: the first one is planned September 24 – from 10.00 – 12.00 […]

SCIENCE HOTEL, 24 september
september 9, 2021
Een avond vol wetenschap! ‘(R)EVOLUTION: Veerkracht in tijden van COVID’, de tweede tentoonstelling van Science Gallery Rotterdam opent tijdens ‘De Europese Nacht van de Onderzoeker’. Volg het online programma van verrassende presentaties door wetenschappers of boek een tour door de tentoonstelling met onze mediators. Het leven is niet zonder risico’s, dat is de afgelopen tijd […]

Onco-connect geeft gerust gevoel tijdens chemokuur
september 9, 2021
Het Wilhelmina Ziekenhuis Assen (WZA) lanceert donderdag 9 september de tweede versie van het thuismeetprogramma Onco-Connect. Deze versie 2.0 is persoonlijker in gebruik en beter afgestemd op de behoefte van de gebruiker. “Twee verschillende gebruikers zullen andere informatie via de app krijgen omdat ze verschillende antwoorden geven op de vragen in de app. Zo is […]

EANO Meeting 25 t/m 26 september
september 9, 2021
Dear friends and colleagues, As the European Association of Neuro-Oncology’s (EANO) top priority is the safety and health of members, meeting participants, speakers, sponsors, exhibitors and suppliers the EANO board has decided that the EANO 2021 Meeting and Educational Day will be held virtually due to the COVID-19 pandemic. The EANO Congress in Rotterdam, NL […]

TOPX SUMMIT 2021
september 9, 2021
A career development & empowerment summit for ambitious women in Life Sciences On 22-23 September 2021, the first TOPX Summit takes place in ECC Leiden, the Netherlands. During these two days you will get to meet and learn from some of the most inspiring and successful female leaders in the Life Sciences Sector. The programme, organised by […]

Upstream Festival 2021
september 9, 2021
MEET THE FRONTRUNNERS OF THE NEXT ECONOMY From 20 to 24 September 2021 the Rotterdam Metropolitan area will again transform into the place where startups, scale-ups, investors, bold corporates, policy makers and students come together to make a positive impact in the world. Upstream provides access to capital, new markets and talent for entrepreneurs who […]

LSH010 ONTBIJT: DONDERDAG 16 SEPTEMBER 2021
september 9, 2021
Op donderdagochtend 16 september vindt het LSH010 ontbijt weer plaats! Dit keer staat het ontbijt in het teken van: Innovaties in de multidisciplinaire (diabetes)patiëntenzorg. Met een mooie innovatieve case over Diabeteszorg uit het Rotterdamse ecosysteem: MiGuide! Ook deze keer kijken we weer vanuit verschillende perspectieven naar deze case: vanuit het bedrijf (MiGuide), vanuit de investeerder (Healthy.Capital) en vanuit de zorg […]

Arbeidsmarktcongres: Missie zorg 010, de zorg voor altijd anders
september 9, 2021
De zorg voor altijd anders. Hoe sorteren we voor op de toekomst met de uitdagingen van vandaag? Op donderdag 16 september zetten we met elkaar onze missie voort tijdens het arbeidsmarktcongres van deRotterdamseZorg. De sleutelrol in de transitie van de zorg heb jij en met elkaar richten we ons op de gezamenlijke maatschappelijke opgave van […]

Nieuwe nationale strategie voor grootschalige wetenschappelijke infrastructuur
september 8, 2021
Investering van 200 miljoen euro voor fundament nieuw en innovatief onderzoek Utrecht, 8 september 2021 Minister van Engelshoven heeft de nieuwe Roadmap Grootschalige Wetenschappelijke Infrastructuur 2021 in ontvangst genomen. Deze Roadmap is bedoeld om strategische keuzes te maken voor investeringen in vernieuwende onderzoeksinfrastructuur. In de nieuwe Roadmap presenteren negen Groepen (met inhoudelijke, thematische of technische […]

Ikazia Ziekenhuis vraagt hele maand september extra aandacht voor laaggeletterdheid
september 8, 2021
Deze week is het De Week van Lezen en Schrijven en wordt landelijk aandacht gevraagd voor laaggeletterdheid. Het Ikazia Ziekenhuis in Rotterdam- Zuid besteedt dit jaar de hele maand september extra aandacht aan dit thema. Tijdens deze maand gaan zorgverleners met elkaar in gesprek: hoe herken je een laaggeletterde patiënt? Wat doe je als je […]

Tweeduizendste bevalling in het Ikazia Ziekenhuis
september 7, 2021
Op maandag 6 september werden meneer en mevrouw Sobaci trotse ouders van een prachtige dochter: Duâ Alina. Met de komst van baby Duâ Alina viert het Rotterdamse Ikazia Ziekenhuis haar tweeduizendste bevalling van dit jaar. Het gezin werd verrast met een knuffel, een kinderstoeltje en een bos bloemen. Mevrouw en meneer Sobaci uit Spijkenisse konden […]

Software helpt ETZ-radiologen bij stellen juiste diagnose
AI-toepassing ‘ziet’ breuken op röntgenfoto’s
september 7, 2021
Heeft de patiënt een botbreuk? Voor het beantwoorden van deze vraag worden dagelijks in het ETZ (Elisabeth-TweeSteden Ziekenhuis) circa honderd röntgenfoto’s gemaakt. De Tilburgse radiologen maken nu – als proef – gebruik van artificiële intelligentie (AI) voor het stellen van de juiste diagnose. De kunstmatige intelligentie-toepassing heet BoneView, een primeur voor Nederland. “We zijn het […]

Dalende trend CO2-uitstoot in Rotterdam zet verder door
september 7, 2021
De dalende trend in de uitstoot van CO2 in Rotterdam zet verder door. Dat blijkt uit de CO2-monitor 2020, die vandaag is gepubliceerd door milieudienst DCMR. Uit metingen van de Rotterdamse uitstootcijfers blijkt dat de totale Rotterdamse CO2-uitstoot in 2020 3,0 Mton is gedaald ten opzichte van 2019. Dit is een daling van 10% ten […]

Humoristisch, vrolijk en informatief: Geleidehond Yoko leidt lezers door de wereld van blinden en slechtzienden
september 7, 2021
Op 11 september 2021 verschijnt ‘Geleidehond Yoko’ als full-colourboek, e-book, audioboek en Daisyboek*, geschreven en voorgelezen door Annemiek van Munster. Vanuit het standpunt van haar geleidehond beschrijft Annemiek in ‘Geleidehond Yoko’ op humoristische en liefdevolle wijze welke obstakels zij samen letterlijk, maar ook figuurlijk overwinnen. Sinds 2019 beschrijft Van Munster ‘namens’ haar geleidehond Yoko op […]

Uitdeelactie ijsjes voor kinderen in het Groene Hart Ziekenhuis
september 7, 2021
Met dit heerlijke nazomerweer kunnen patiëntjes in het Groene Hart Ziekenhuis wel een verfrissend ijsje gebruiken. Vandaag deelden David’s Gelato en St. Vrienden van het GHZ bij het GHZ heerlijke ijsjes uit aan kinderen en hun ouders. In juli organiseerden de Vriendenstichting en David’s Gelato een speciale actie op de Goudse Markt. Veel Gouwenaren kochten […]

Ikazia breidt spreekuren uit
september 7, 2021
Het Rotterdamse Ikazia Ziekenhuis breidt het aantal spreekuren uit. Zo start op maandag 6 september een sportletselspreekuur waarbij meerdere specialismen betrokken zijn, zoals traumachirurgie, orthopedie, radiologie en fysiotherapie. Orthopedie richt zich ook op een enkel/voetpolikliniek en op een elleboogpolikliniek. Het doel hiervan is dat mensen sneller gezien en geholpen worden op één centrale plek in […]

Verpleegkundig onderzoekers bewijzen hun meerwaarde
september 7, 2021
Verpleegkundig onderzoekers hebben grote meerwaarde voor de patiënt, de afdeling, de organisatie en de verpleegkundige beroepsgroep, zo blijkt uit recent onderzoek. ‘Deze nieuwe functie is niet meer weg te denken uit ons ziekenhuis’, benadrukt Ina Kuper, lid van de Raad van Bestuur van Isala. Zij pleit voor verdere professionalisering en een nieuwe stap in de […]

“Epilepsiepatiënten krijgen de gespecialiseerde zorg van Kempenhaeghe nu ook in het JBZ.”
september 7, 2021
Volwassen epilepsiepatiënten uit regio ’s-Hertogenbosch hoeven niet meer naar epilepsie expertisecentrum Kempenhaeghe in Heeze of Oosterhout. Kempenhaeghe Neuroloog Laura de Ceuster houdt sinds 1 september 2021 spreekuur in het Jeroen Bosch Ziekenhuis. Volwassen patiënten met epilepsie krijgen zo in het JBZ de zorg die ze nodig hebben, dichtbij huis. De samenwerking tussen het JBZ en […]

Van dans tot DNA tijdens online Oogcongres 2021
september 7, 2021
6 maandagavonden vanaf 6 september Utrecht, 2 september 2021 – Dit jaar zijn in Nederland de eerste patiënten behandeld met gentherapie. Een webinar over deze en andere revolutionaire behandelingen in de oogheelkunde door prof. dr. Rob Collin (Radboudumc) vormt de aftrap van het online Oogcongres 2021. Vanaf 6 september kunnen mensen met een oogaandoening en […]

Start nomineren voor Rotterdamse Kinderrechten Award 2021!
augustus 31, 2021
Vanaf woensdag 1 september 2021 kunnen Rotterdammers weer personen en organisaties nomineren voor de Rotterdamse Kinderrechten Award. Deze reikt de gemeente Rotterdam voor de vijfde keer uit. Dit jaar op zaterdag 20 november, tijdens het Kinderrechtenfestival in het Plaswijckpark. Met het uitreiken ervan vraagt Rotterdam aandacht voor de rechten van het kind. De gemeente zet […]

Ziekenhuis Rivierenland en Helpdesk Digitale Zorg bieden digitale ondersteuning aan patiënten
augustus 31, 2021
Digitale zorg of ‘zorg op afstand’ wordt steeds gewoner. Om patiënten van Ziekenhuis Rivierenland hierbij te helpen, is de Helpdesk Digitale Zorg beschikbaar. Daar kunnen mensen vanaf 1 september terecht met al hun vragen over het gebruik van het patiëntenportaal MijnZR, beeldbellen via BeterDichtbij of andere digitale hulpmiddelen van Ziekenhuis Rivierenland. Wendy Bosboom, lid Raad […]

‘Op safari’ tijdens maagonderzoek met ‘virtual reality’ in CWZ
augustus 26, 2021
Het Canisius Wilhelmina Ziekenhuis (CWZ) Nijmegen start een unieke studie naar het gebruik virtual reality (VR) als afleiding bij patiënten die een kijkonderzoek van de maag (gastroscopie) ondergaan. CWZ is het eerste ziekenhuis in Nederland dat VR op deze manier toepast. Meer comfort voor patiëntVoor patiënten is een kijkonderzoek van de maag niet fijn. Medisch psychologen […]

Metabolisme verandert met de leeftijd, maar niet precies wanneer we dat verwachten
augustus 23, 2021
Een internationaal team van wetenschappers, onder wie de Maastrichtse hoogleraar Klaas Westerterp, heeft voor het eerst nauwkeurig de metabole hoogte- en dieptepunten van het leven in kaart gebracht, van geboorte tot ouderdom. Er zijn veel fysiologische veranderingen die gepaard gaan met opgroeien en ouder worden, denk aan de puberteit of de menopauze. Uit deze nieuwe studie […]

Opluchting bij vrouwen omdat er eindelijk een behandeling is voor onbegrepen klachten van pijn op de borst
augustus 23, 2021
Als je last hebt van pijn op de borst, vermoeidheid en kortademigheid, wordt er al snel gedacht dat er iets mis is met het hart. In meer dan de helft van de gevallen wordt er echter geen oorzaak gevonden. Het gevolg? Zo’n 60.000 mensen in Nederland lopen rond met klachten zonder dat er iets aan […]

GET PLENISHED!
augustus 12, 2021
Met deze nieuwe vegan notendrankVanaf deze week is in Nederland een nieuwe heerlijke vegan notendrank in het (online) supermarktschap verkrijgbaar. Plenish wordt gemaakt van slechts 3 ingrediënten; noten, water en zout. De gezonde drink bevat verder geen enkele toevoeging en het notengehalte is veel hoger dan in andere vergelijkbare producten. Bovendien wordt Plenish zowel biologisch als […]

Grote subsidie Máxima MC voor onderzoek naar 24/7 monitoring zwangere vrouwen
augustus 11, 2021
Máxima MC (MMC) heeft drie miljoen euro subsidie ontvangen om zijn topspecialistische functie op het gebied van de geboortezorg verder te versterken. Met deze subsidie van ZonMw kan grootschalig onderzoek worden gestart naar het toepassen van elektrofysiologisch monitoren. Deze techniek, die is ontwikkeld in samenwerking met de Technische Universiteit Eindhoven (TU/e), maakt het mogelijk om […]

IJsjes, sesam, dressings: giftig ethyleenoxide is nog altijd overal
juli 29, 2021
Sinds vorig jaar zijn er in Nederland en Europa duizenden partijen voedingsmiddelen en voedselgrondstoffen teruggeroepen. Ze zijn verontreinigd met ethyleenoxide. Dit giftige ontsmettingsmiddel is kankerverwekkend, mutageen en schadelijk voor voortplantingsorganen. De stof wordt nog steeds in te hoge concentraties in voedingsmiddelen aangetroffen. Mede door druk van voedselwaakhond foodwatch heeft de Europese Commissie tot een grote terughaalactie […]

Gezonde game helpt patiënten de juiste keuzes te maken
juli 28, 2021
Het Maasstad Ziekenhuis heeft in samenwerking met NBD Biblion een informatief online spel ontwikkeld over gezonde voeding. Via deze zogenaamde ‘serious game’ krijgen patiënten met diabetes mellitus type 2 (ook wel suikerziekte genoemd) en mensen die een risico lopen om deze ziekte te krijgen informatie over wat gezonde keuzes zijn. In Nederland hebben 1,1 miljoen […]

Last van muggen? Sla ze plat en maak een foto!
juli 28, 2021
Rotterdam, 26 juli 2021 – Vanaf deze zomer kan iedereen in Europa via de Mosquito Alert app foto’s van muggen, muggenbeten en muggenbroedplaatsen insturen. Het doel is om met hulp van burgers de huidige verspreiding van inheemse muggen nauwkeurig in kaart te brengen en zo te voorspellen in welke gebieden in Nederland, en de rest […]

Acht bevlogen Rotterdammers in Klankbordgroep voor burgemeester
juli 28, 2021
Afgelopen januari is de derde ambtstermijn ingegaan van burgemeester Aboutaleb. In Meer maatwerk en wederzijds vertrouwen heeft hij aangegeven welke accenten hij daarin wil leggen. Hij kondigde o.a. een klankbordgroep aan van kritische denkers van divers pluimage met wie hij zeker twee maal per jaar om de tafel wil om te praten over de stad […]

Hersentumoren opsporen met een eenvoudige urinetest
juli 22, 2021
Een urine- of bloedtest om te checken of een hersentumor terugkomt: mogelijk is dat in de toekomst voor patiënten de vervanging van de gebruikelijke driemaandelijkse MRI-scans. Onderzoekers van Amsterdam UMC en de universiteit van Cambridge ontwikkelden twee testen hiervoor. Hun bevindingen zijn vandaag gepubliceerd in het wetenschappelijke blad EMBO Molecular Medicine. Wanneer bij patiënten een […]

Menskracht voor Zuid
juli 21, 2021
Bestrijden van armoede bij bewoners in Rotterdam Zuid, meer aandacht voor vervoer binnen en naar het gebied en bewoners beter betrekken: op deze thema’s wil de gemeente als partner en financier de komende 10 jaar extra inzetten in het Nationaal Programma Rotterdam Zuid. De extra inzet komt boven op de oorspronkelijke pijlers van het programma, […]

NWO-Vidi van 800.000 euro voor 78 ervaren onderzoekers
juli 16, 2021
De Nederlandse Organisatie voor Wetenschappelijk Onderzoek (NWO) heeft 78 ervaren onderzoekers een Vidi-financiering van 800.000 euro toegekend. Hiermee kunnen zij de komende vijf jaar een eigen, vernieuwende onderzoekslijn ontwikkelen en een onderzoeksgroep opzetten. De laureaten gaan met het geldbedrag onder andere onderzoeken hoe ons zelfbeeld ons geheugen vervormt en zo tot slechtere financiële beslissingen leidt. De Vidi […]

Bloeddrukcontroles en leefstijladvies op afstand vanuit het Maasstad Ziekenhuis
juli 16, 2021
Na het succesvol op afstand controleren van patiënten die met het coronavirus in het Maasstad Ziekenhuis hebben gelegen, breidt het ziekenhuis thuismonitoring in de zorg voor patiënten verder uit. Patiënten die voor een (acute) hoge bloeddruk worden behandeld in het Maasstad Ziekenhuis, kunnen steeds vaker thuis zelf hun bloeddruk meten en via een app ter […]

“Wat loop je nou te stoken?!” Campagne tegen rookoverlast door BBQ
juli 16, 2021
Met het zomerweer in aantocht, zetten veel mensen weer gezellig de BBQ aan. Maar niet iedereen is zich bewust van de nadelige effecten voor de luchtkwaliteit en gezondheid. Daarom start de gemeente deze week met de zomercampagne ‘Wat loop je nou te stoken?!’ In humoristische filmpjes geeft cabaretier Richard Groenendijk tips over buurvriendelijk stoken om rookoverlast te […]

Ruim 100 bewoners op Zuid van start met meten luchtkwaliteit
juli 16, 2021
Oproep aan kabinet: investeer in schone lucht Ruim 100 bewoners in Rotterdam Zuid zijn gestart met het meten van de luchtkwaliteit in hun eigen straat en buurt. De metingen maken onderdeel uit van het ‘citizen science’ project van de gemeente Rotterdam waarbij Rotterdammers gedurende twee jaar zelf de luchtkwaliteit meten en data aanleveren. Bewoners worden […]

Zo gezond is zwemmen voor je: ‘Je hele lichaam is in beweging’
juli 16, 2021
Wanneer het deze zomer te warm wordt om te gaan hardlopen of fietsen, kan zwemmen uitkomst bieden. Een frisse duik nemen heeft bovendien voordelen voor je gezondheid. Ook als je kampt met overgewicht of een handicap. “Het is een hele eenvoudige manier om je conditie op bouwen”, vertelt sportarts Els van den Eede. Na fitness, hardlopen, […]
Onderzoek naar inspanningsafhankelijke pijnsyndromen onderbeen
juli 12, 2021
Hoe kunnen inspanningsafhankelijke pijnsyndromen van het onderbeen sneller herkend en behandeld worden? Met haar promotieonderzoek in Máxima MC (MMC) hoopt Aniek van Zantvoort hier een bijdrage aan te leveren. Op basis van de onderzoeksresultaten ontwikkelde ze onder meer een voorspellingsmodel om artsen te helpen bij het stellen van de diagnose van één van deze aandoeningen: […]

PATH lanceert documentaire om stigma roze wolk te doorbreken
juli 12, 2021
De geboorte van een kind wordt bijna altijd gekoppeld aan blijdschap en een roze wolk. Maar helaas is dit niet bij iedereen zo na een zwangerschap of een bevalling. Ongeveer 20% van de moeders die net een baby hebben gekregen, krijgt namelijk last van mentale problemen, waar nauwelijks over gepraat wordt. Om het gesprek hierover […]

Covid-patiënten beademen met lage druk is betere zorg
juli 12, 2021
Het is beter om de longen van covid-patiënten aan de beademing niet constant onder een hoge druk te houden. Dat blijkt uit de resultaten van de PRoVENT-covid studie, die zijn gepubliceerd in het European Journal of Anesthesiology. Van 933 covid-patiënten in 22 Nederlandse ziekenhuizen werden er tijdens de eerste golf van de pandemie 674 met lage […]

Suikermaxdag: kinderen overschrijden nu al jaarlijkse suikerlimiet
juli 12, 2021
Populaire kinderdrankjes duwen allerjongsten snel over hun suikermaximumVrijdag 9 juli is de eerste ‘Suikermaxdag’ van 2021: voor kinderen van 4 tot 8 jaar. Kleine kinderen hebben nu al hun maximale jaarhoeveelheid suikers bereikt, gebaseerd op het advies van de Wereldgezondheidsorganisatie. Volgens de WHO mag maximaal 10% van je dagelijkse hoeveelheid calorieën uit vrije suikers (dit […]

Solán de Cabras en RAWBITE komen met speciale Pink Ribbon producten
juli 12, 2021
Oktober is Pink Ribbon maand maar toch ontving de fondsenwerver vorige week al een cheque ter waarde van 10.000 euro. Bickery Food Group, de distributeur van Solán de Cabras mineraalwater en RAWBITE snacks gaf alvast een voorzetje. Met de verkoop van de elegante roze flesjes en de repen met Pink Ribbon logo moet minimaal dit […]

Dialysepatiënt MMC kan voortaan dichtbij huis dialyseren
juli 12, 2021
Een primeur in de regio: Máxima MC en dialysecentrum Dianet hebben een dialysehub opgezet in zorgcentrum Valkenhof. De dialysehub maakt het voor patiënten van Máxima MC (MMC) mogelijk om dichter bij huis te dialyseren. Dialysebehandelingen zijn vaak ingrijpend en tijdrovend. Patiënten komen hiervoor meestal drie dagen per week, vier uur per dag naar het ziekenhuis. […]

Koop een ijsje en steun kinderen in het Groene Hart Ziekenhuis
juli 8, 2021
Op 10 en 11 juli kan je genieten van een heerlijk ijsje bij David’s Gelato in Gouda en tegelijk ook kinderen in het Groene Hart Ziekenhuis een geluksmomentje bezorgen. En op zaterdag komt ook een speciale bezoeker langs! Op 10 en 11 juli steun je met de aankoop van een ijsje óók kinderen in het […]

Polikliniek Kralingen officieel geopend door Tamara van Ark, demissionair minister voor Medische Zorg en Sport
juli 5, 2021
Op 1 juli 2021 is de nieuwe Polikliniek Kralingen van het IJsselland Ziekenhuis officieel en feestelijk geopend door demissionair minister voor Medische Zorg en Sport, Tamara van Ark. De polikliniek is gevestigd in verpleeghuis en revalidatiecentrum Pniël van Lelie zorggroep in Rotterdam Kralingen. Tamara van Ark knipte het openingslint door. Dit deed zij samen met […]

Kijktip: Campagne voor meer gezondheid: #hoedan
juli 5, 2021
Op dinsdag 13 juli 2021 (van 11.00 – 12.00 uur) organiseert Alles is Gezondheid met The Pando Network een webinar over de vraag hoe je gezondheid kan stimuleren met (lokale) campagnes en community building. Overal in Nederland werken publieke en private partijen samen om meer gezondheid te creëren voor wijken, dorpen, steden en regio’s. Het […]

Lancering nieuwe patiëntengroep voor mensen met sterke bijziendheid
juli 5, 2021
Utrecht, 1 juli 2021 – Heb je een brilsterkte van -6 of meer? Dan heb je hoge myopie, oftewel sterke bijziendheid. Steeds meer mensen in Nederland hebben hiermee te maken, met alle risico’s van dien. Op 5 juli 2021 lanceert de Oogvereniging daarom de nieuwe patiëntengroep Hoge Myopie. Overal ter wereld zien we bijziendheid (myopie) […]

Menstruatieproducten voor Rotterdammers met laag inkomen
juli 5, 2021
Rotterdammers met een laag inkomen kunnen vanaf 1 juli ook maandverband, tampons en inlegkruisjes aanschaffen via het Jeugdtegoed op de Rotterdampas. Jongeren kunnen deze producten bij de Hema kopen en afrekenen via het tegoed dat de gemeente op de Rotterdampas stort. Aanleiding hiervoor is de motie ingediend door Duygu Yildirim van de PvdA over menstruatiearmoede in februari […]

Stevigere samenwerking tussen Noordwest, Starlet en regionale huisartsen
juni 29, 2021
Vanaf 29 juni 2021 kunnen huisartsen uit de Kop van Noord-Holland en Noord-Kennemerland hun patiënten via het digitale platform ZorgDomein verwijzen naar medisch specialisten binnen Noordwest. Daarnaast kunnen zij diagnostisch onderzoek aanvragen bij de afdeling radiologie en de laboratoria van Noordwest en Starlet. Dit is een belangrijke stap in de digitalisering van zorgpaden in de […]

Subacute Zorgstraat voor kwetsbare ouderen in het Maasstad Ziekenhuis
juni 29, 2021
Kwetsbare oudere patiënten die in een crisissituatie dreigen te komen, kunnen vanaf nu terecht bij de Subacute Zorgstraat in het Maasstad Ziekenhuis. Deze samenwerking tussen Aafje, PIT 010 en de Geriatrie poli van het Maasstad Ziekenhuis heeft als doel kwetsbare ouderen langer in de thuissituatie te laten wonen. Door deze samenwerking kan een bezoek aan […]

Covid-19 de meest gemelde beroepsziekte in 2020
juni 23, 2021
De meest gemelde beroepsziekte in 2020 is covid-19, ofwel besmetting met het coronavirus in de werksituatie. Het aantal nieuwe gevallen per 100.000 werknemers lag naar schatting op 128. Maar ook beroepsgebonden psychische aandoeningen (78 per 100.000) en aandoeningen aan het houding- en bewegingsapparaat (30 per 100.000) komen veel voor. De meldingen van beroepsziekten zijn het […]

EARTH Water stopt volledig met plastic flesjes
juni 22, 2021
En kiest voor Tetra Top® kartonnen fles met plantaardig plastic van Tetra Pak Na 14 jaar stopt EARTH Water – met het gebruik van plastic flesjes voor het verpakken van haar water. Het gaat in totaal om 5 miljoen plastic flesjes per jaar, verantwoordelijk voor 50 procent van de verkoop van EARTH. Gelijktijdig levert EARTH […]

Nieuw onderzoek naar combinaties met Janssen-vaccin
juni 21, 2021
Vier UMC’s onderzoeken of een tweede vaccinatie na eerste Janssen-vaccinatie nuttig is Vier UMC’s gaan in de SWITCH-studie onderzoeken of een tweede coronavaccinatie na een eerste Janssen-vaccinatie nuttig is. Ze gaan in dit onderzoek medewerkers die hun eerste shot Janssen reeds hebben ontvangen een tweede maal vaccineren met het Janssen, Pfizer of Moderna vaccin. Bij […]

Lancering nieuwe mobile learning tool
juni 18, 2021
Makkelijker en effectiever kennis delen met een nieuwe leerinnovatie: WisbitsLeren wordt leuker en toegankelijker: kleine brokjes kennis delen in uiteenlopende vormenGeen externe ontwikkelaar meer nodig: Wisbits geeft de autonomie terug aan de ondernemer Op 17 juni 2021 is tijdens het virtuele Rotterdamse LSH010 innovatieontbijt de leerinnovatie Wisbits met een feestelijke aankondiging gelanceerd. Hoe vang je de schat aan kennis […]

One in 100 deaths is by suicide
juni 18, 2021
WHO guidance to help the world reach the target of reducing suicide rate by one-third by 2030 Suicide remains one of the leading causes of death worldwide, according to WHO’s latest estimates, published today in “Suicide worldwide in 2019”. Every year, more people die as a result of suicide than HIV, malaria or breast cancer – […]

Oogvereniging richt steunpunt op voor nieuwkomers met een visuele beperking
juni 17, 2021
Utrecht, 17 juni 2021 – In een gammele boot de oversteek maken naar Europa, in een vreemd land een hondsmoeilijke taal leren: vluchten is voor iedereen een overlevingsslag, en al helemaal voor vluchtelingen met een visuele beperking. Op 20 juni, de Internationale Dag van de Vluchteling, lanceert de Oogvereniging een speciaal steunpunt. “Voor nieuwkomers met […]

Zuidoost-Brabantse ziekenhuizen realiseren digitale snelweg voor uitwisselen radiologische onderzoeken
juni 17, 2021
Bij de zorg voor patiënten zijn steeds vaker meerdere zorgverleners betrokken uit verschillende ziekenhuizen in de regio. Het is hierbij van groot belang dat alle relevante patiëntgegevens direct voor hen beschikbaar zijn. Door het realiseren van een ‘digitale snelweg’ tussen Máxima MC, het Catharina Ziekenhuis en het St. Anna Ziekenhuis is het nu mogelijk om […]

23 sportverenigingen krijgen vernieuwd sportcomplex
juni 16, 2021
De komende tien jaar gaat de gemeente Rotterdam de sportcomplexen van 23 verenigingen vernieuwen of renoveren. Rotterdam heeft hiervoor ruim 60 miljoen gereserveerd. Tijdens de feestelijke opening van het sportjaar in september wordt toegelicht om welke buitensportcomplexen het gaat. Al een langere periode lukt het veel verenigingen niet meer om zelfstandig de bouw van kleedkamers […]

Eerst Herstelpolikliniek in Nederland voor hulp na depressie
juni 16, 2021
Vandaag start Amsterdam UMC de Herstelpolikliniek Depressie voor de behandeling van mensen die slechts deels zijn opgeknapt van een depressie. Deze patiënten houden na een depressie ondanks een goede behandeling toch nog klachten waarmee ze nu nog nergens terecht kunnen. Amsterdam UMC gaat als eerste instelling in Nederland deze hulp bieden. Jaarlijks kampen ongeveer […]

Isala zet Virtual Reality in om ouderenmishandeling te leren herkennen
juni 15, 2021
De cijfers liegen er niet om. 1 op de 20 thuiswonende ouderen van 65 jaar en ouder krijgt ooit te maken met ouderenmishandeling. Financieel misbruik komt het meeste voor, gevolgd door psychische en lichamelijke mishandeling. Omdat dit thuis achter de voordeur gebeurt, is het lastig te herkennen. ‘En toch kan het wel, als je weet […]

Organisatie netwerkzorg in de regio: gezamenlijke doelen & betrokken patiënten
juni 15, 2021
Het organiseren van integrale zorg is onlosmakelijk verbonden met samenwerking in de regio en in netwerkverbanden. Dit brengt diverse uitdagingen met zich mee. Want hoe speel je als zorg- en hulpverleners goed op elkaar in en hoe leer je elkaar vertrouwen? Maar ook: hoe doorbreek je de grenzen van organisaties en wetgeving? Dit jaar organiseert […]

3Dprint: Toekomstbeeld gezondheid en zorg in 2030
juni 15, 2021
10 juni, 2021 Hoe ziet de toekomst van gezondheid en zorg er in 2030 uit voor Rotterdammers? Deze vraag staat centraal in ons toekomstbeeld van gezondheid en zorg: de 3Dprint. Lees meer over de zorgbehoeften van inwoners, over de uitdagingen in de organisatie van zorg en maak kennis met de zorgprofessional van de toekomst. Met […]

LSH010 ontbijt op donderdag 17 juni 2021
juni 15, 2021
Op donderdagochtend 17 juni vindt het volgende LSH010 ontbijt weer plaats! De ontbijtsessie staat deze keer in het teken van: DNA sequencing & gepersonaliseerde behandelingen in de zorg. Met Berry Kriesels & Prof. Dr. Casper van Eijck & Ruud van Raak Wil jij meer weten over hoe een algoritme hét verschil gaat maken bij patiënten met […]

Hoe bewijs je dat een innovatie ook werkelijk doelmatig is?
juni 15, 2021
Hoe bewijs je dat een innovatie ook werkelijk doelmatig is? Dat is een vraag die actueel is voor iedereen die bezig met innoveren in de zorg. Maar hoe toon je nu aan dat een innovatie doelmatig is? Nu we in Rotterdam veel subsidieprogramma’s, waaronder de Digideal010, hebben lopen lijkt het een goed moment om dé specialist op dit […]

Meer leerlingen doen fietsexamen
juni 14, 2021
Tijdens de eerste dag hebben 195 kinderen het fietsexamen afgelegd. Wethouder Judith Bokhove van Mobiliteit, jeugd en taal was bij de aftrap van de examens met 19 leerlingen van basisschool De Harbour Bilingual. Die school in Delfshaven was de eerste school in Rotterdam die dit jaar het fietsexamen deed. Tot 7 juli doen nog 63 […]

Nieuwe hoogleraar wil medische data internationaal toegankelijker maken voor onderzoek
juni 11, 2021
Digitale medische data zijn wereldwijd niet gelijk beschikbaar. Zo beschikken Europa en de Verenigde Staten over veel data, terwijl Afrikaanse landen hier nauwelijks toegang toe hebben. Hoogleraar Mirjam van Reisen pleit voor internationaal toegankelijkere data voor onderzoek. Dat wil ze bereiken door FAIR-data. Door samen met partners digitale gezondheidstoepassingen te ontwikkelen wil ze goede zorg, […]

Zes LUMC-onderzoeksprojecten ontvangen financiering uit ZonMw Open Competitie
juni 11, 2021
Zes onderzoeksprojecten die (deels) worden uitgevoerd in het Leids Universitair Medisch Centrum (LUMC) ontvangen ieder een subsidie van maximaal 750.000 euro uit het programma: ZonMw Open Competitie. Het geld wordt in Leiden onder andere ingezet voor onderzoek naar tumorafweer met weefsel t-cellen en voor een studie naar de invloed van genen als de biologische basis […]

Online workshop mini-Health Technology Assessment – Hoe bewijs je dat een innovatie ook werkelijk doelmatig is?
juni 11, 2021
Hoe bewijs je dat een innovatie ook werkelijk doelmatig is? Dat is een vraag die actueel is voor iedereen die bezig met innoveren in de zorg. Maar hoe toon je nu aan dat een innovatie doelmatig is? Nu we in Rotterdam veel subsidieprogramma’s, waaronder de Digideal010, hebben lopen lijkt het een goed moment om dé specialist op dit […]

‘Aanpassingen in koffieconsumptie kan mogelijk de kwaliteit van leven van dementiepatiënten verbeteren’
juni 11, 2021
Cafeïne wordt al eeuwenlang gebruikt, het verbetert je stemming, vermindert vermoeidheid en verhoogt alertheid. Hoewel de effecten van cafeïne uitgebreid zijn onderzocht bij gezonde volwassenen, is minder bekend over hoe het de gedragssymptomen kan beïnvloeden bij patiënten met dementie. Als specialist ouderengeneeskunde ouderengeneeskunde n.p. heeft Michelle Kromhout haar onderzoek gericht op het onderzoeken van deze […]

Wetenschappelijke waarheden herzien
juni 11, 2021
Medische kennis moet altijd ter discussie staan. Dat is volgens LUMC-onderzoeker en arts Ype de Jong de essentie van wetenschappelijke vooruitgang. In zijn zoektocht om de gezondheidszorg op maat bij hart- en vaatziekten vooruit te helpen, onderzocht De Jong risicomodellen die momenteel worden geadviseerd door internationale richtlijnen. De studie, gepubliceerd in het wetenschappelijke tijdschrift European […]

Vernieuwd Willem-Alexander Kinderziekenhuis organiseert 18 juni Kindercongres ‘It’s a Kind of Magic’
juni 11, 2021
Het Willem-Alexander Kinderziekenhuis (WAKZ), het kinderziekenhuis van het Leids Universitair Medisch Centrum, is de afgelopen jaren grondig verbouwd om een zo kindvriendelijk mogelijke omgeving te creëren. De afdelingen Bos, Duin, Stad, Strand, Neonatologie en het Geboortehuis Leiden vormen nu samen één van de meest moderne en kindvriendelijke kinderziekenhuizen van Nederland. Op 18 juni vindt de officiële […]

Rotterdam blijft fors investeren ondanks Corona crisis
juni 9, 2021
Het college van Rotterdam investeert 114 miljoen om mensen aan het werk te houden en de economie te stimuleren. Ondanks dat de impact van de coronacrisis groot is, verhoogt de gemeente de gemeentelijke belastingen niet. Ook wordt er niet bezuinigd in de stad, schrijft het college van burgemeester en wethouders in de voorjaarsnota aan de […]

Patiënt en reumatoloog beslissen samen over behandeling
juni 9, 2021
De afdeling Reumatologie van het Maasstad Ziekenhuis heeft een dashboard ontwikkeld waarmee artsen en patiënten samen beslissingen kunnen nemen over de behandeling. “Via de gegevens in het dashboard krijgt de patiënt niet alleen meer inzicht in het eigen ziekteverloop, maar ook meer regie over de behandeling”, zegt Angelique Weel, reumatoloog in het Maasstad Ziekenhuis. Op […]

@ease opent vestiging op VU Campus Uilenstede
juni 9, 2021
Amsterdam, 9 juni 2021 Op woensdag 9 juni opent Vinod Subramaniam, rector magnificus van Vrije Universiteit Amsterdam, om 11 uur op feestelijke digitale wijze de deuren van een nieuwe vestiging van @ease. De vestiging is in De Kas op de VU Campus Uilenstede, Uilenstede 346B. Subramaniam: “Gratis en anoniem kunnen jongeren en studenten hier binnenlopen […]

Eindelijk weer optredens My Breath My Music
juni 7, 2021
Rotterdam, 30 mei 2021 Op zondag 4 juli is het dan eindelijk zover! My Breath My Music organiseert voor het eerst sinds lange tijd weer een concert: Unchained Melody. Verschillende met My Breath My Music verbonden muzikanten en huisband De Bridge treden op. Bovendien schuift DJ Elroy aan en dan is het altijd feest! Vanwege […]

GHZ sluit corona-afdeling en versoepelt maatregelen
juni 7, 2021
Ook in het Groene Hart Ziekenhuis (GHZ) neemt het aantal coronapatiënten snel af. Dit betekent dat de corona-afdelingen gesloten kunnen worden. Daarnaast is het mogelijk om enkele maatregelen te versoepelen, waardoor er bijvoorbeeld vaker bezoek toegestaan is. Maar liefst anderhalf jaar hebben diverse artsen, verpleegkundigen en andere medewerkers zich volledig ingezet voor de coronazorg. Nu […]

Draag een eclipsbril tijdens de zonsverduistering
juni 7, 2021
Amsterdam, 7 juni 2021 – Op donderdag 10 juni vindt er een zonsverduistering plaats. Ook in Nederland kunnen we deze gedeeltelijk waarnemen. Het onbeschermd kijken naar een zonsverduistering kan echter ernstige schade aan je ogen veroorzaken. Maatbril voert daarom een informatieve campagne over de zonsverduistering. Tevens zijn er nog 15 gratis eclipsbrillen aan te vragen specifiek voor […]

Herziening normen voor fiets- en kinderhelmen
juni 7, 2021
De Europese Commissie heeft verzocht om twee geharmoniseerde normen voor fietshelmen te herzien om daarmee invulling te kunnen geven aan Verordening (EU) 2016/425 – Persoonlijke beschermingsmiddelen. NEN organiseert een informatiebijeenkomst voor de Nederlandse belanghebbenden om hen te informeren over het initiatief en input van de deelnemers te verkrijgen. De herziening geldt voor NEN-EN 1078:2012+A1:2012 (Helmen voor fietsers […]

Eindelijk weer optredens My Breath My Music
juni 4, 2021
Rotterdam, 30 mei 2021 Op zondag 4 juli is het dan eindelijk zover! My Breath My Music organiseert voor het eerst sinds lange tijd weer een concert: Unchained Melody. Verschillende met My Breath My Music verbonden muzikanten en huisband De Bridge treden op. Bovendien schuift DJ Elroy aan en dan is het altijd feest! Vanwege […]

Rotterdamse Luchtclub telt ruim 400 leden
juni 3, 2021
Al meer dan 400 Rotterdammers hebben zich aangemeld voor de Luchtclub. Ze gaan de gemeente helpen om de luchtkwaliteit in hun straat te meten. Dinsdag overhandigde wethouder Arno Bonte de eerste fijnstofsensor aan Rob Oosterlee in Rozenburg. De andere leden van de Luchtclub ontvangen de sensoren in de komende weken. De Luchtclub is een ‘citizen […]

Valsspelende cellen leiden tot darmkanker
juni 3, 2021
Cellen met bepaalde mutaties gaan bijzonder geraffineerd te werk om het ontstaan van kanker te bevorderen. Dit hebben onderzoekers van Amsterdam UMC ontdekt. Ze zijn erin geslaagd het duivelse mechanisme te ontrafelen hoe cellen in de darmen erin slagen uit te groeien tot tumoren. Ze schrijven erover in Nature van 2 juni. “Het is een nieuw trucje”, […]

Techniek zelfrijdende auto lost discussie cardiologen op
juni 3, 2021
Eindhoven, 02 juni 2021 – Cardiologen van het Catharina Hart- en Vaatcentrum hebben door het inzetten van kunstmatige intelligentie een einde gemaakt aan een langlopende discussie onder cardiologen. Hun onderzoek heeft uitgewezen dat het gebruik van het medicijn adenosine bij het bepalen of een vernauwing in een kransslagader wel of niet gedotterd moet worden, van […]

Dotterbehandeling met op afstand bestuurbare robot
juni 3, 2021
In het Maasstad Ziekenhuis zijn de eerste patiënten gedotterd met behulp van de R-One hartkatheterisatie robot van de Franse firma Robocath. Met deze robot kan de interventie cardioloog op de millimeter nauwkeurig een stent plaatsen, zonder zelf in aanraking te komen met schadelijke röntgenstralen die nodig zijn bij de ingreep. Het Maasstad Ziekenhuis is één […]

De Doelen krijgt een groen, biodivers dak met waterberging
juni 1, 2021
Grootste multifunctionele dak op gemeentelijk rijksmonument Op Congres- en concertgebouw de Doelen wordt het platte dak van 2.581m² bedekt met een grote variatie aan groen. Er komt ook een systeem voor waterberging met een capaciteit van 300m³, dat zorgt voor opvang van water. Het is de eerste keer dat een groot gemeentelijk gebouw en rijksmonument […]

The Seventy-fourth World Health Assembly closes
juni 1, 2021
More than 30 resolutions and decisions were adopted at this year’s World Health Assembly in diferent areas of public health: decisions on diabetes, disabilities, ending violence against children, eye care, HIV, hepatitis and sexually transmitted infections, local production of medicines, malaria, neglected tropical diseases, noncommunicable diseases, nursing and midwifery, oral health, social determinants of health […]

Risico voor moeder en kind bij inleiden bevalling zonder medische indicatie
juni 1, 2021
Wereldwijd kiezen steeds meer vrouwen voor het inleiden van een bevalling voordat de baby volledig voldragen is. Ook als moeder en kind gezond zijn en er dus geen medische reden is. Onderzoek van Amsterdam UMC/Academie Verloskunde Amsterdam Groningen (AVAG), vandaag gepubliceerd in British Medical Journal Open, wijst uit dat kinderen op korte en langere termijn […]

MIMETAS opent een centrum voor fenotype screeningen
mei 31, 2021
Datum: Donderdag, 27 mei 2021Tijd: 09:00 Essay van het grootste gerapporteerde orgaan op een chip ooit uitgevoerd Leiden, Nederland, 27 mei 2021 – MIMETAS, de wereldwijde leider in menselijke organen chip modellen, heeft zojuist zijn fenotype screening centrum geopend. Het centrum faciliteert grootschalige screeningcampagnes op organen chips, een krachtige technologie die de menselijke fysiologische relevantie […]

Positieve gezondheid integreren in je ondersteuning ”Leefstijl eerst”
mei 31, 2021
Al jaren neemt het aantal kinderen dat jeugdhulp ontvangt toe. De meest recente cijfers laten zien dat 1 op de 7 kinderen jeugdhulp krijgt en dat de kinderen in jeugdhulp steeds jonger worden. Een ander feit is dat we steeds ongezonder gaan leven. Hoe dit met elkaar in verband staat leer je in deze training. Datum: woensdag 15 september 2021Tijd: 9:30 – […]

Persbericht – ISO initiatief tot normalisatie E-sports en online gaming industrie
mei 31, 2021
Competitief online gaming is de afgelopen decennia gegroeid van niche hobby tot miljarden-industrie van globale omvang. Deze groei gaat gepaard met uitdagingen op het gebied van onder andere E-sports cultuur, toernooien, diversiteit en speler identificatie. NEN onderzoekt of Nederlandse belanghebbenden interesse hebben in normalisatie op het gebied van online gaming en E-sports, of zij zich […]

Slimme technologie als wapen tegen kindersterfte in Afrika
mei 27, 2021
Artsen hebben een slim en levensreddend monitoringssysteem ontwikkeld dat alarm slaat als de gezondheid van een kind op de kinderafdeling verslechtert. Het is bedoeld voor ziekenhuizen in lage-inkomenslanden die niet over de kennis of middelen beschikken om bestaande, dure apparaten hiervoor te gebruiken. Hiervoor hebben de onderzoekers onlangs financiële steun gekregen van het EDCTP-programma van […]

Wetenschapsagenda Amsterdam UMC 25 t/m 28 mei 2021
mei 26, 2021
Dinsdag 25 meiPromotie (VU), 11.45 uur aulaLemonitsa Mammatas: PET-beeldvorming voor gepersonaliseerde behandeling bij kanker Kanker is de belangrijkste doodsoorzaak na hart- en vaatziekten in Europa en heeft zeer grote impact op patiënten, hun dierbaren en de maatschappij: ieder jaar krijgen meer dan 3 miljoen patiënten deze diagnose en sterven 1,7 miljoen mensen als gevolg hiervan. […]

81% van de Nederlanders kent gevolgen hoge bloeddruk niet
mei 26, 2021
Uit jaarlijks onderzoek van de Hartstichting blijkt dat slechts 19% van alle Nederlanders weet dat een hoge bloeddruk het risico op hart- en vaatziekten, zoals een hartinfarct of beroerte, verhoogt. Ook weet ruim een kwart van de Nederlanders niet dat je meestal niets van een hoge bloeddruk voelt. Vanaf je 40ste jaarlijks je bloeddruk meten […]

Grote subsidie om kunstmatige intelligentie uitlegbaar te maken aan artsen
mei 26, 2021
Op basis van data kan kunstmatige intelligentie voorspellen welke behandeling het beste is voor een individuele patiënt. Maar omdat de techniek achter deze voorspellingen soms moeilijk te begrijpen is voor artsen, wordt deze veelbelovende toepassing nog niet zo vaak gebruikt in het ziekenhuis. Onderzoekers van het Leids Universitair Medisch Centrum (LUMC), Amsterdam UMC en het […]

Rode Kruis start voorlichtingscampagne over corona voor anderstaligen
mei 26, 2021
Het Rode Kruis is gestart met een voorlichtingscampagne over corona voor mensen die niet of nauwelijks Nederlands spreken. Via speciaal ontworpen webpagina’s wordt betrouwbare informatie gedeeld over coronapreventie, testen en vaccins. “Iedereen in Nederland heeft recht op een vaccin. Maar niet iedereen krijgt dezelfde informatie. Op deze manier proberen we betrouwbare informatie toegankelijk te maken […]

Subsidie voor inheemse planten
mei 26, 2021
Wie inheemse plantensoorten in de tuin plant, helpt de biodiversiteit in de stad. Daarom kunnen Rotterdammers voor inheemse planten, kruiden, heesters, struiken en bomen subsidie krijgen. Een inheemse plant is een plant die van nature ergens voorkomt. Insecten en andere dieren zijn vaak afhankelijk van inheemse plantensoorten voor voedsel, veiligheid en voortplantingsplekken. De insecten, zoals […]

Onderzoek: één op de twintig vrouwen drinkt tijdens vroege zwangerschap
mei 26, 2021
Eén op de twintig vrouwen drinkt alcohol tijdens de vroege zwangerschap. Dat blijkt uit onderzoek van het Erasmus MC. Een speciaal ontwikkelde PEth-test kan in bloed tot twee weken terugzien of er alcohol is gebruikt. Gynaecologen en kinderartsen vinden dit zorgelijk: ‘Ook één glas wijn is niet goed als je zwanger bent.’ In het onderzoek, […]

BUSINESS OPPORTUNITIES IN EHEALTH – WEBINARS IN QATAR AND UAE, ORGANIZED BY NETHERLANDS EMBASSIES IN THE GCC
mei 25, 2021
You are cordially invited to two country specific webinars in Qatar and UAE on business opportunities in eHealth, organized by Netherlands Embassies and the Regional Business Development Team in the GCC. The webinar on eHealth opportunities in Qatar will take place on Monday 7th of June at 10:00 am Dutch time. Kindly register your interest through […]

Toenemende behoefte aan meditatie en retraites
mei 25, 2021
Mensen hebben in toenemende mate behoefte aan een retraite. Deze trend is al enkele jaren waarneembaar, maar nu tijdens de corona-situatie lijkt deze behoefte nog veel sterker te zijn. Zo wordt er op het woord retraite ongeveer 3600 keer per maand gezocht en daarnaast ook nog op honderden woordencombinaties waar het woord retraite ook in […]

Een derde bijzonder hoogleraren voeding WUR nog altijd niet transparant over nevenfuncties
mei 25, 2021
Amsterdam, 25 mei 2021: Een half jaar na een onderzoek van voedselwaakhond foodwatch naar de transparantie over nevenwerkzaamheden van bijzonder hoogleraren voeding aan Wageningen University & Research (WUR), blijkt uit een nieuw rapport van foodwatch dat nog steeds één derde niet aan de gedragsregels voldoet. Nadat foodwatch eerder blootlegde dat 46% van de bijzonder hoogleraren voeding […]

Long working hours increasing deaths from heart disease and stroke: WHO, ILO
mei 25, 2021
Long working hours led to 745 000 deaths from stroke and ischemic heart disease in 2016, a 29 per cent increase since 2000, according to the latest estimates by the World Health Organization and the International Labour Organization published in Environment International today. In a first global analysis of the loss of life and health associated with […]

SARSLIVA-studie levert krachtig bewijs
mei 21, 2021
Fijn is het niet, zo’n wattenstaafje diep de neus en keel in. De kans is groot dat dit straks ook niet meer nodig is, want de uitkomsten van een grootscheepse ‘speeksel-studie’ onder leiding van het Spaarne Gasthuis in samenwerking met Streeklaboratorium Haarlem, GGD Kennemerland en het RIVM bieden hoop voor een veel prettiger alternatief: spugen. […]

Waarom is kaas niet vegetarisch?
mei 21, 2021
Kaas is er in alle soorten en maten. Jong, oud, dik en dun. Maar ook: vegetarisch. Kaas wordt namelijk niet alleen gemaakt van het dierlijke product melk, maar ook met een stukje van het dier zelf. Dat maakt de meeste kaas niet-vegetarisch. Kaas wordt gemaakt van melk – meestal koemelk, geitenmelk of schapenmelk. Voor boerenkaas […]

Lancering thuismeet app voor IBD patiënten
mei 21, 2021
Franciscus Gasthuis & Vlietland lanceert op Wereld IBD dag samen met het Jeroen Bosch Ziekenhuis en OLVG een thuismeet app voor patiënten met Inflammatory Bowel Disease (IBD). IBD is een chronische darmontstekingsziekte waar ruim 90.000 Nederlanders mee kampen. Een op maat gemaakte versie van de Luscii thuismeet app moet patiënten meer regie over hun ziekteverloop geven, […]

AI voorspelt het risico op longkanker
mei 21, 2021
Een AI-algoritme kan nauwkeurig het risico voorspellen dat longknobbeltjes, gevonden op CT-scans tijdens longscreening, zullen uitgroeien tot tumoren. Dat schrijven onderzoekers van het Radboudumc in Radiology. Longkanker is bij zowel mannen als vrouwen de belangrijkste doodsoorzaak door kanker en veroorzaakt bijna 25 procent van alle sterfte door kanker. Screening van mensen met een verhoogd risico op […]

Grote subsidie voor baanbrekend onderzoek met elektronenmicroscopie
mei 21, 2021
Het Radboudumc en de Radboud Universiteit gaan samen met de universiteiten van Leiden en Amsterdam met behulp van elektronenmicroscopie op zoek naar nieuwe inzichten en aanknopingspunten voor de ontwikkeling van betere geneesmiddelen. Voor het opzetten van de hiertoe benodigde faciliteiten ontvangen Nico Sommerdijk en collega’s zowel een NWO Groot subsidie van twee 1,5 miljoen euro, naast een […]

White Ribbon Tour 21 mei: aandacht voor longkanker
mei 20, 2021
“Iedereen met longen kan longkanker krijgen en niemand verdient longkanker” Rotterdam, 17 mei 2021 – Op vrijdag 21 mei 2021 fietsen en wandelenlongkankerpatiënten, naasten, nabestaanden, longartsen, verpleegkundigen, arts-onderzoekers, studenten en andere enthousiaste deelnemers “The White RibbonTour” om het witte lint voor longkanker door te geven. Dit initiatief wordtondersteund door de patiëntenorganisatie Longkanker Nederland en deNederlandse […]

Beurs ZieZo-online voor blinden en slechtzienden
mei 20, 2021
In Nederland zijn ongeveer 300.000 mensen blind of slechtziend. Het invullen van je leven met een visuele beperking kan een zoektocht zijn. De ZieZo-beurs is al jaren dé plek waar organisaties gerelateerd aan low-vision zich presenteren. Bezoekers maken kennis met een uitgebreid aanbod aan hulpmiddelen, patiëntenverenigingen, belangenverenigingen, diensten en zorgorganisaties rondom wonen. Dit jaar vindt op zaterdag […]

Kan ik stoppen met antidepressiva?
mei 20, 2021
Meer dan een miljoen mensen in Nederland slikken antidepressiva. Een groot aantal van hen om een terugval te voorkomen na herstel van een depressie. Uit onderzoek blijkt dat bepaalde psychologische interventies als Preventieve Cognitieve Therapie (PCT) en Mindfulness-Based Cognitieve Therapie (MBCT) een goed alternatief zijn voor antidepressiva. Dit onderzoek, onder leiding van Claudi Bockting, hoogleraar […]

Impact en (on)begrip bij IBD
mei 20, 2021
Maak je ziekte bespreekbaar: open je blik Op woensdag 19 mei is het Wereld IBD Dag. Op deze dag wordt wereldwijd aandacht gevraagd voor de chronische darmontstekingsziekten colitis ulcerosa en de ziekte van Crohn. In Nederland kampen zo’n 90.000 mensen hiermee. Deze ziekten – ook wel Inflammatory Bowel Disease (IBD) genoemd – zijn zeer ingrijpend. […]

Creeër een fitte (thuis)plek webinar
mei 20, 2021
Dit is onze manier om een steentje bij te dragen in deze corona tijd, om de verhoogde werkdruk wat te verlagen. Merk dat je last krijgt van je rug? Omdat die keukenstoel toch echt wel anders is dan die ergonomische stoel op kantoor.Je werkt meer uren per dag, omdat je tussendoor boodschappen hebt gedaan.Maar misschien […]

Webinar: Allianties en (regio)netwerken: hoe dan?
mei 20, 2021
Op donderdag 10 juni 2021 organiseert Alles is Gezondheid met de Alliantie Kinderarmoede en het platform WEL in Flevoland een webinar over de vraag hoe we door publiek-private samenwerking kunnen bijdragen aan preventie, gezondheid en welzijn. In de wereld van gezondheid en welzijn kom je ze steeds vaker tegen: publiek-private allianties, collectieven, partnerschappen, lokale coalities en regionetwerken die over […]

Maak een einde aan het kooien van 300 miljoen boerderijdieren in de EU
mei 19, 2021
Foodwatch: ‘Commissaris voor Handel Dombrovskis moet aanpassingsmaatregelen aan de grens initiëren’ Brussel/Amsterdam/Berlijn/Parijs, 19 mei 2021 – De Europese consumentenorganisatie foodwatch roept de Europese Commissie op een einde te maken aan het kooien van alle landbouwdieren in Europa en ervoor te zorgen dat het EU-handelsbeleid dit verbod ondersteunt. Foodwatch lanceert vandaag een campagnepetitie gericht aan EU-commissaris voor […]

Dutch Health Hub agendeert, activeert en versnelt verbetering in zorg en life sciences
mei 18, 2021
Utrecht, dinsdag 18 mei 2021 – De Koninklijke Jaarbeurs heeft vandaag de Dutch Health Hub gelanceerd, aan het begin van de eerste editie van de Dutch Health Week. De hub is een nieuwe plek waar professionals en organisaties uit zorg en life sciences elkaar ontmoeten, ideeën uitwisselen, inspiratie en kennis opdoen, leren, samenwerken, innoveren en […]

Meer Rotterdamse kinderen spelen buiten met flexibele plein programmering
mei 18, 2021
Vanaf 2022 gaan veel meer kinderen op veel meer plekken onder begeleiding buitenspelen in Rotterdam. Door flexibele pleinprogrammering in héél de stad kunnen wekelijks minimaal 15.000 kinderen buitenspelen op de minimaal 70 pleinen waar kinderwerk actief wordt. Buiten spelen is belangrijk voor kinderen. Daarom maakt de gemeente Rotterdam extra geld vrij zodat niet 5.000 kinderen […]

Promotiekalender Amsterdam UMC 17-22 mei 2021
mei 17, 2021
Dinsdag 18 mei Promotie (VU), 09.45 uur online Margriet Kwint: radiotherapie verbeteren voor lokaal gevorderd niet kleincellige vorm van longkanker In Nederland krijgen jaarlijks meer dan 13.000 patiënten de diagnose longkanker. Ongeveer 25% van de patiënten heeft een lokaal gevorderd niet kleincellige vorm van longkanker (LA-NSCLC). De standaardbehandeling voor dit stadium van de ziekte is gelijktijdige chemotherapie en […]

Let’s improve health together, Dutch Health Week
mei 17, 2021
Morgen start de Dutch Health Week | Ben je er klaar voor? 18 t/m 21 mei 2021 | Dutch Health Week De transformatie naar duurzame en toekomstbestendige zorg en een gezonde samenleving is omvangrijk. De uitdagingen waarmee we geconfronteerd worden zijn enorm en complex. Hoe kunnen we met elkaar samenwerken en de transformatie borgen? Laat […]

Maasstad Ziekenhuis kijkt met trots terug op 2020
mei 17, 2021
Het Maasstad ziekenhuis sluit het door corona gedomineerd jaar af met een positief financieel resultaat van € 8,4 miljoen. “Ondanks niet voorziene uitgaven door corona, minder geleverde reguliere zorg en extra investeringen hebben we 2020 met een positief financieel resultaat kunnen afsluiten. Het is een dubbel gevoel, maar we kunnen hier met z’n allen trots […]

Extra service Noordwest ‘Online aanmelden voor afspraak’
mei 11, 2021
Alkmaar/Den Helder, 11 mei 2021 Patiënten van Noordwest kunnen zich vanaf dinsdag 11 mei thuis online aanmelden voor hun afspraak bij Noordwest. Zij gebruiken hiervoor het patiëntenportaal Mijn Noordwest. Dit is een extra service voor onze patiënten waarmee we de doorstroming bij de ingangen van het ziekenhuis bevorderen. Extra service ‘Online aanmelden is een mooie […]

Betere behandeling ernstig zieke covid-patiënten in zicht
mei 11, 2021
Onderzoekers van Amsterdam UMC hebben ontdekt waarom sommige patiënten ernstig ziek worden na een infectie met het coronavirus. Deze patiënten blijken veel afwijkende antistoffen te produceren, die een extreme en schadelijke ontstekingsreactie opwekken. De onderzoekers hebben een medicijn op het oog waarmee ze deze ontspoorde afweerreactie kunnen tegengaan, om zo ernstig zieke covid-patiënten op de […]

Verpleegkundigen aan het roer? Betere zorg!
mei 11, 2021
Verpleegkundigen die collega’s inspireren, open staan voor innovaties en invloed hebben op de patiëntenzorg en de strategische koers van het ziekenhuis. In organisaties waar verpleegkundigen hiervoor de ruimte nemen en krijgen, is de zorg beter, blijkt uit onderzoek van het Erasmus MC. Een paar jaar geleden stond onderzoeker Linda den Breejen – de Hooge nog […]

Doe de MARIO-check!
mei 11, 2021
Kinderen van ouders met psychische problemen hebben het in deze tijden van Covid extra zwaar. Het MARIO consortium, bestaande uit 5 universitaire centra, onderzoekt of deze kinderen kunnen worden geholpen met een online hulpprogramma om hun veerkracht te verbeteren. Nederland telt naar schatting 400.000 kinderen van ouders met psychische problemen (KOPP), variërend van stemmingswisselingen, tot […]

Eerste succesvolle DCD-hartdonaties in Nederland
mei 11, 2021
Artsen van het Erasmus MC, UMC Utrecht en UMC Groningen hebben de eerste DCD-hartdonatie-procedures in Nederland uitgevoerd. Het stilstaande hart van een overleden donor wordt buiten het lichaam in een machine geplaatst waar het weer gaat kloppen na toevoer van zuurstof en bloed. Vervolgens wordt het hart getransplanteerd. Hartdonatie was voorheen alleen mogelijk bij een […]

Leiding geven aan nieuwe bloedvaten
mei 11, 2021
Onderzoekers van Amsterdam UMC hebben ontdekt hoe bepaalde cellen communiceren tijdens de vorming van nieuwe bloedvaten. Zij publiceren vandaag hierover in het toptijdschrift Nature Communications. Ons lichaam maakt op drie momenten nieuwe bloedvaten aan: tijdens de embryonale ontwikkeling, bij de bloedvoorziening van weefsels en tijdens de groei van tumoren. Als zo’n bloedvat zich vormt, bewegen […]

Slimme schoen helpt blinden en slechtzienden veilig over straat
mei 11, 2021
Computerwetenschappers van de TU Graz hebben een op een camera gebaseerd AI-beeldherkenningssysteem voor een schoen ontwikkeld dat blinden en slechtzienden waarschuwt voor obstakels. Mensen met een visuele beperking weten vaak op een bewonderenswaardige manier de weg te vinden in een voor hen onbekende omgeving. Aan de hand van wat zij voelen met hun wandelstok en […]

Wetenschapsagenda Amsterdam UMC 10 t/m 12 mei 2021
mei 10, 2021
Maandag 10 mei Promotie (VU), 13.45 u, onlineAdinda Mieras: Goede keuze voor behandeling in laatste levensfase Adinda Mieras onderzocht de doelen van patiënten met uitgezaaide longkanker en hun artsen bij het starten van een systemische behandeling in de laatste levensfase. Deze behandelingen kunnen symptomen verminderen en het leven verlengen maar hebben ook veel bijwerkingen en hinderen patiënten […]

Medisch futuroloog Bertalan Meskó opent Dutch Health Week
mei 7, 2021
Utrecht, 7 mei 2021 – Medisch futuroloog dr. Bertalan Meskó opent op dinsdag 18 mei de eerste editie van de Dutch Health Week, het grootste online evenement voor de gezondheidszorg in 2021. Meskó is de directeur van het Medical Futurist Institute, dat analyseert hoe en wanneer de nieuwste technologieën werkelijkheid kunnen worden in gezondheidszorg en […]

Ode aan alle assistentiehonden
mei 7, 2021
in Nederland van kleinkunstduo Carlie Spruijt en Eva Opperman ‘Het allermooiste in mijn bestaan, is jouw leven liefde geven’ Onvoorstelbaar. Dat was de allereerste reactie van het Carlie Spruijt en Eva Opperman toen ze het verhaal van MS-patiënt Anita en haar assistentiehond Butler hoorden. Het greep het kleinkunstduo aan en inspireerde hen tot het schrijven […]

Alcohollobby houdt eerlijkere etiketten decennia tegen
mei 6, 2021
AMSTERDAM 6 mei 2021 – Alcoholische dranken – vooral wijn, likeur en sterke drank – zijn qua ingrediënten en voedingswaarden moeilijk te doorgronden door consumenten. Sterker: ze staan nu helemaal niet op het etiket. Alleen het alcoholpercentage en eventueel aanwezige allergenen staan verplicht op de verpakking. Voedselwaakhond foodwatch vindt dat vreemd en heeft onderzocht hoe […]

ETZ-verpleegkundigen werken ook op de ambulance
mei 6, 2021
Spoedeisende Hulp-verpleegkundige Jantina Wijnakker heeft deze week haar diploma als ambulanceverpleegkundige ontvangen. Daardoor is ze nu bevoegd haar baan op de afdeling Spoedeisende Hulp van het ETZ (Elisabeth-TweeSteden Ziekenhuis) te combineren met het werken op de ambulance van de RAV (Regionale Ambulancevoorziening) Brabant-Midden-West-Noord. Jantina (31): “Die combinatie bevalt mij heel goed. Ik kan patiënten op […]

Experts gezocht voor Europees certificatieschema voor fitnesscentra
mei 5, 2021
De afgelopen jaren heeft de fitness sector hard gewerkt aan het opstellen van Europese normen. In deze normen worden onder andere eisen gesteld aan het veilige en hygiënische uitbaten van, en het toezicht op fitnesscentra. Sinds het begin van de corona pandemie is het des te belangrijker om naleving van dergelijke eisen zichtbaar aan te […]

Nieuwe hoogleraar Catharina Ziekenhuis: Beginnende slokdarmkanker is steeds vaker orgaansparend te behandelen
mei 5, 2021
Eindhoven, 04 mei 2021| Maag-darm-leverarts oncoloog prof. dr. Erik Schoon is de veertiende hoogleraar binnen de muren van het Catharina Ziekenhuis. Schoon bekleedt de leerstoel ‘Nieuwe technologie ten behoeve van diagnostiek en behandeling in de endoscopische oncologie’ aan de Universiteit Maastricht. Hij gaat zich als hoogleraar inzetten om het opsporen en behandelen van vroege tumoren […]

Wetenschapsagenda Amsterdam UMC 4 t/m 7 mei 2021
mei 5, 2021
Dinsdag 4 mei Promotie (UvA), 12.00 u, AgnietenkapelTill Zimmer: Oxidatieve stress bij epilepsie Epilepsie is een neurologische ziekte die wereldwijd ongeveer 65 miljoen mensen treft. De ziekte heeft veel oorzaken: ze kan genetisch zijn of ontstaan na een acuut hersenletsel door een ongeluk of een beroerte. Soms helpen medicijnen, maar bij meer dan dertig procent van […]

Onderzoekers parkinson bundelen krachten in Nederland
mei 3, 2021
Deze nieuwe beroepsvereniging van Parkinson Onderzoekers sluit zich aan bij de recent opgerichte Parkinson Alliantie Nederland; Samen versnellen! Parkinson is de snelst groeiende hersenziekte ter wereld! De persoonlijke en maatschappelijke impact van deze progressieve ziekte is niet alleen ongekend, ze is bij velen ook nog onbekend. Er zijn veel onderzoekers werkzaam op het terrein van […]

Wetenschappers: breng coronaproblematiek samen met jongeren in kaart
april 30, 2021
4 op de 10 jongeren tussen de 16 en 24 jaar zit in een kwetsbare situatie. Niet omdat zij zelf lichamelijke of psychische klachten hebben, maar omdat ze zichzelf belangrijke ervaringen ontzeggen vanwege verantwoordelijkheidsbesef naar kwetsbare gezinsleden. Zij ervaren meer last van de coronacrisis en rapporteren vaker psychische klachten, zoals angst en depressie, dan niet-kwetsbare […]

Ronald Giphart overhandigt debuut van zeer slechtziende Corné Hermans (12) uit Leiden
april 29, 2021
Utrecht – Op 28 april werd de zeer slechtziende Corné Hermans (12) verrast met een persoonlijke overhandiging van zijn debuut ‘Pak het bot!’, door Oogfonds-ambassadeur Ronald Giphart. Corné wil niets liever dan schrijver worden, maar heeft momenteel nog maar 20 procent zicht als gevolg van de oogziekte van Stargardt. Hij hoopt dat er in de […]

Dak Rotterdam Ahoy vormt bron van duurzame energie
april 29, 2021
Het zonnedak van Ahoy is uitgebreid en vormt voortaan een bron van zonne-energie. Wethouder Arno Bonte, Eneco CEO As Tempelman en Ahoy-directeur Jolanda Jansen hebben het zonnedak in gebruik genomen. Dit gebeurde door het plaatsen van het laatste zonnepaneel op het dak van het nieuwe Rotterdam Ahoy Convention Centre (RACC) en muziek/theaterzaal RTM Stage. In […]

Catharina Ziekenhuis plaatst eerste onderhuidse bluetooth-hartmonitor
april 29, 2021
Eindhoven, 29 april 2021 | In het Catharina Ziekenhuis in Eindhoven is de eerste patiënt van Nederland geïmplanteerd met een nieuwe onderhuidse Bluetooth-hartmonitor. Cardioloog Tim Simmers plaatste het innovatieve apparaatje, dat gekoppeld is aan de mobiele telefoon van de patiënt. “We kunnen over een langere periode de prestaties van het hart van de patiënt op […]

Unilever werkt aan speciale deodorant voor mensen met handicap
april 28, 2021
Unilever werkt aan de naar eigen zeggen eerste deodorant ter wereld die is ontworpen voor mensen met een handicap. Het was- en levensmiddelenconcern heeft een speciaal deoflesje ontworpen dat ook te gebruiken moet zijn door mensen die bijvoorbeeld niet hun volledige armfunctie hebben. Volgens het bedrijf zijn er wereldwijd heel veel mensen die er baat […]

In beweging dankzij Sportimpuls
april 28, 2021
Bij de Dansfabriek in Nieuwegein dansen de ouderen niet op oubollige nummers, maar juist op pittige muziek. Ze krijgen ook serieus les. ‘Ik zeg altijd: op donderdagochtend ben ik voor niemand thuis. Dan ga ik naar de dansschool’, vertelt Bep van Kouwen in een interview in het digitale magazine over Sportimpuls. Toen ze zich op de […]

Wetenschapsagenda 26 t/m 30 april 2021
april 28, 2021
Vrijdag 30 april 2021Promotie (UvA), 11.00 u, online Anika Bongaarts: Meer zicht op SEGA-hersentumoren Bongaarts onderzocht de oorzaken van de ontwikkeling en groei van SEGA’s, hersentumoren die bijna uitsluitend voorkomen bij patiënten met TSC, een erfelijke ziekte die veroorzaakt wordt door een mutatie in het TSC1- of TSC2-gen. Ze bestudeerde deze tumoren en keek naar de (epi)genetische […]

Fatsoenlijke prijs voor opnieuw geregistreerde medicijnen
april 28, 2021
Onderzoekers van Medicijn voor de Maatschappij (Amsterdam UMC) en Zorginstituut Nederland ontwikkelden een rekenmodel waarmee zij een realistische prijs kunnen berekenen voor medicijnen die opnieuw in de markt worden gezet. Het model is toegepast op het medicijn mexiletine. Dat wordt al vele jaren gebruikt voor hartziektes, maar is door een fabrikant opnieuw geregistreerd voor toepassing […]

DB-connect lanceert laagdrempelige e-learning over doofblindheid
april 23, 2021
DB-connect heeft een e-learning ontwikkeld over doofblindheid met de titel Als ogen én oren het niet goed doen, wat doe je dan? De e-learning is bedoeld voor iedereen die nog niet bekend is met doofblindheid en te maken heeft of krijgt met mensen uit deze doelgroep. DB-connect is het landelijk informatiepunt voor vragen over beperkt […]

Noordwest opent nieuwe polikliniek Oncologisch centrum
april 22, 2021
Noordwest Ziekenhuisgroep heeft op locatie Alkmaar een nieuwe polikliniek van Noordwest Oncologisch centrum geopend. Hier wordt oncologische topzorg geboden in een persoonlijke en warme sfeer. Alle poliklinische oncologische zorg wordt in de nieuwe polikliniek op één plek aangeboden aan de patiënt. Huiselijke uitstraling Op de polikliniek worden vele oncologische spreekuren gehouden, zijn multidisciplinaire spreekuren mogelijk en […]

Parel ZonMw voor platform kindenonderzoek.nl
april 22, 2021
Kunnen kinderen eigenlijk meebeslissen over onderzoeksdeelname? En worden kinderen goed genoeg geïnformeerd daarover? Wat is de beste manier om kinderen te helpen om zo’n beslissing te nemen? Op 15 april ontving een team van onderzoekers bestaande uit Ronella Grootens (LUMC), Mira Staphorst, Irma Hein en Hans van Goudoever (Amsterdam UMC) een ZonMw Parel voor hun […]

Kinderboek om in gesprek te gaan over epilepsie
april 22, 2021
Spiedi is een mooi voorlichtingsboek om met kinderen in gesprek te gaan over epilepsie. Op verzoek van auteur Theo Heisen hebben ambulant begeleiders van het LWOE een flinke stapel boeken aan kinderneuroloog Jikke-Mien Niermeijer en verpleegkundig specialist Nicole Damen van het ETZ overhandigd. Het boek is bedoeld voor alle kinderen die te maken krijgen met […]

Sander de Kramer vindt meer dan 100 werkgevers met een sociaal hart
april 22, 2021
Samen met WSP Rijnmond heeft televisiemaker Sander de Kramer meer dan 100 grote en kleine bedrijven met een sociaal hart in regio Rijnmond gevonden. Het gaat om werkgevers die mensen met een afstand tot de arbeidsmarkt voor langere tijd aan werk willen helpen. Op donderdag 22 april tekenden 40 werkgevers de intentieverklaring voor de campagne […]

Baby’s krijgen na streptokokkeninfectie later vaker problemen
april 22, 2021
Baby’s die in de eerste maanden na hun geboorte een groep-B-streptokokkeninfectie (GBS) oplopen, zoals meningitis (hersenvliesontsteking), kunnen hiervan de rest van hun leven nadelige effecten ondervinden. Zo hebben ze een verhoogde kans op neurologische ontwikkelingsstoornissen. Dat blijkt uit onderzoek vandaag gepubliceerd in The Lancet Child & Adolescent Health. Groep-B-streptokokken zijn bacteriën die in de darmen of […]

Hersenstimulatie met nieuwe elektroden nog effectiever voor Parkinson-patiënten
april 20, 2021
Neurochirurgen ETZ implanteren als eerste in Benelux nieuwe vinding Medtronic Neurochirurgen in het ETZ hebben als eerste in de Benelux een nieuwe generatie elektroden in het hoofd van een Parkinsonpatiënt geïmplanteerd, waarmee stroom heel gericht naar de te behandelen plek kan worden gestuurd. “De ‘diepe hersenstimulatie’ heeft daardoor voortaan nog meer effect, met minder bijwerkingen.” Neurochirurg […]

Wetenschapsagenda Amsterdam UMC 19-23 april 2021
april 19, 2021
Dinsdag 20 aprilPromotie (UvA),15.00 u, online Emma Beeldman: Gedragsveranderingen bij ALS Beeldman heeft cognitieve stoornissen en gedragsveranderingen onderzocht bij patiënten met ALS (amyotrofische laterale sclerose). Ze wilde weten welke gedragsveranderingen het vaakste voorkomen, hoe die patiënten gescreend kunnen worden op gedragsverandering en motorische stoornissen en of het verloop daarvan progressief is. Ook heeft ze bepaald wat de […]

Je eetgewoontes zijn slecht voor het milieu
april 19, 2021
April 19, 2021 Maar deze twee simpele veranderingen kunnen helpen. Wat eten we vanavond? Op een planeet die wordt geteisterd door stijgende zeeën, uitdijende woestijnen, afnemende biodiversiteit en hetere temperaturen, is dat een lastige vraag om te beantwoorden. De voedselproductie is verantwoordelijk voor ruwweg een kwart van de broeikasgasemissies in de wereld, en wetenschappers zijn […]

Direct geven van meerdere medicijnen werkt beter tegen reuma
april 19, 2021
19 april 2021 Reumapatiënten hebben geen slechtere levensverwachting dan mensen zonder deze ziekte. Tenminste, als de ontstekingen die gepaard gaan met deze aandoening snel en voortdurend worden onderdrukt met de juiste medicijnen. Dat is de uitkomst van een tienjarig onderzoek dat het Leids Universitair Medisch Centrum (LUMC) coördineerde. Dit onderzoek is onlangs gepubliceerd in het medisch vakblad […]

Eindhovense corona-uitvinding gaat internationaal
april 19, 2021
Eindhoven, 19 april 2021 | Als een patiënt wordt opgenomen in het Catharina Ziekenhuis moet zo snel mogelijk worden vastgesteld of de patiënt COVID-19 heeft of niet. Naast een PCR-sneltest gebruikt het ziekenhuis hiervoor sinds de eerste golf vorig jaar ook de zogenoemde CoLab-score. De CoLab-score wordt berekend op grond van de veranderingen die het […]

Damaging diets and dangerous water – Episode 5
april 16, 2021
This fifth episode of the Health emergency of climate change series will explore climate change’s effect on our food and water, and the impact that human consumption is having on the planet. This episode will look at food and water-related diseases which are aggravated by climate change, how the food we eat contributes to greenhouse gas emissions and […]

Hazardous temperatures and cardiac health – Episode 4 – Cardiology
april 16, 2021
Discover the role of health professionals in the climate change emergency. This fourth episode of the Health emergency of climate change series will explore the links between climate change and cardiovascular health. The increase in extreme heat events, temperature variability, and air pollution as a result of climate change has a detrimental impact on cardiovascular health around the […]

Health DigiBooster Smart Hospitals
april 15, 2021
Smart hospitals intent to provide valuable services to achieve better patient care but what infrastructure and smart features are needed to re-design, connect and redefine the delivery of care? Oulu Health Digi Booster facilitates collaboration between Finnish and Dutch smart hospitals to contribute to the fast growing needs of the health care sector and give […]

Kinderfiets over? Lever ‘m in en maak een kind blij
april 15, 2021
Rotterdam en ANWB starten inleveractie voor kinderfietsen Elk kind een eigen fiets. Voor vele kinderen in Rotterdam is dat helaas niet vanzelfsprekend door de financiële thuissituatie. En dat moet anders. Gemeente Rotterdam en ANWB starten daarom vanaf vandaag met een lokale inleveractie voor kinderfietsen. En daarom de oproep aan de stad. Heb jij één of […]

Bloedend leed bestrijden
april 15, 2021
Gynaecoloog Velja Mijatovic is de eerste hoogleraar Endometriose in Nederland. Deze aandoening, waarbij het baarmoederslijmvlies buiten de baarmoeder ‘verdwaalt’, treft vooral jonge vrouwen. Zij hebben veel buikpijn en vaak vruchtbaarheidsproblemen. De nieuwe hoogleraar gaat zich inzetten voor meer onderzoek en betere behandeling van deze aandoening. “Er zijn hoopvolle innovaties in de behandeling van endometriose.” Deze […]

Rotterdam lanceert Luchtclub in strijd tegen luchtvervuiling
april 14, 2021
Woensdag heeft wethouder Arno Bonte (Duurzaamheid) de Luchtclub gelanceerd. Rotterdammers die lid worden van de Luchtclub krijgen een sensor om zelf de luchtkwaliteit in hun straat te kunnen meten. Door samen te meten krijgen inwoners en de gemeente meer inzicht in de luchtkwaliteit in straten en wijken. Het gaat bij de Luchtclub niet alleen om […]

33 wetenschappers ontvangen NWO-Vici van 1,5 miljoen euro
april 14, 2021
33 vooraanstaande wetenschappers ontvangen ieder 1,5 miljoen euro van de Nederlandse Organisatie voor Wetenschappelijk Onderzoek (NWO). Met deze Vici-beurs kunnen ze de komende vijf jaar een vernieuwende onderzoekslijn ontwikkelen en een eigen onderzoeksgroep opbouwen. Vici is een van de grootste persoonsgebonden wetenschappelijke premies van Nederland en is gericht op gevorderde onderzoekers. De wetenschappers doen onderzoek […]

Meer ruimte voor de fiets
april 14, 2021
In de binnenstad van Rotterdam komen nog dit jaar 1500 tot 2000 extra plekken om je fiets te stallen. Rond de zomer komen er 1100 fietsparkeerplekken bij het Centraal Station op de Conradstraat. Daarbij komen er meer dan 200 tijdelijke plekken bij op de Karel Doormanstraat, de Kruiskade en de Westblaak. In een leegstaande winkel […]

De 10 van 010: aandacht voor biodiversiteit in Rotterdam
april 13, 2021
Zeven dieren en drie planten: zij staan dit jaar symbool voor de biodiversiteit in Rotterdam. De gemeente Rotterdam en partners in de stad hebben deze ’10 van 010’ benoemd om de biodiversiteit in de stad te verrijken. Want een rijke biodiversiteit is belangrijk voor de gezondheid en het welzijn van mensen. Steden spelen een belangrijke […]

Samenwerking voortgezet en hoger onderwijs
april 13, 2021
Gemeente Rotterdam, stichting BOOR en Hogeschool Rotterdam slaan de handen ineen voor een nieuw schoolcomplex tussen de Posthumalaan en de Laan op Zuid, in ontwikkelgebied Parkstad. De nieuwbouw moet in 2025 klaar zijn. Daarmee ontstaat een unieke samenwerking tussen voortgezet en hoger onderwijs en wordt het onderwijsaanbod op Zuid verder verrijkt. De hogeschool wil in […]

Wetenschapsagenda Amsterdam UMC 12 t/m 16 april 2021
april 12, 2021
Woensdag 14 april 2021Promotie (UvA), 11.00 u, online Simone Koole: Warme chemotherapie-spoeling verbetert overleving eierstokkanker Vrouwen met eierstokkanker die is uitgezaaid naar het buikvlies kunnen baat hebben bij een buikvlies-spoeling met verwarmde chemotherapie. Dit ontdekte Koole in een studie naar de voordelen van deze chemospoeling bij patiënten met stadium-III eierstokkanker. Ze keek daarbij naar patiënten die interval […]

Den Haag sluit zich aan bij Grand Départ-bid Rotterdam
april 9, 2021
Rotterdam en Den Haag trekken samen op om de Grand Départ van de Tour de France in 2024 of 2025 naar de Metropoolregio Rotterdam Den Haag te halen. De ambitie is om de proloog van de Tour in Rotterdam te laten verrijden, gevolgd door een etappe met start in Rotterdam en aankomst in Den Haag. […]

1500 nieuwe laadpunten voor elektrische auto’s in Rotterdam
april 8, 2021
Lage prijs Naast de beschikbaarheid van laadpalen was ook een lage prijs een belangrijk uitgangspunt in de aanbesteding. Rotterdam behoudt het vaste lage tarief van 31 cent per kWh (inclusief btw). “We willen het zo aantrekkelijk mogelijk maken voor mensen om elektrisch te rijden”, licht wethouder Arno Bonte (Duurzaamheid) toe. “Zo zorgen we voor schone lucht […]

Stap verder in samenwerking Erasmus MC en IJsselland Ziekenhuis
april 6, 2021
Voornemen fusie: de juiste zorg op de juiste plek Het Erasmus MC en het IJsselland Ziekenhuis zijn voornemens te gaan fuseren. Volgens de ziekenhuizen heeft dit voordelen voor de patiënt: zo kan de juiste zorg op de juiste plek worden geleverd. Het fusievoorstel moet worden goedgekeurd door de Autoriteit Consument & Markt (ACM). De ACM […]

Wetenschapsagenda 5 t/m 9 april 2021
april 6, 2021
Dinsdag 6 april Promotie (VU), Aula 11.45 uur, online Colin Groot: Heterogeniteit in de ziekte van Alzheimer Wat zijn de biologische en genetische factoren die ten grondslag liggen aan klinische verschillen (ook wel heterogeniteit genoemd) tussen mensen met de ziekte van Alzheimer? Groot beschrijft in zijn proefschrift de verschillende methoden om mensen op te delen […]

Groene Hart Ziekenhuis en GGD Hollands Midden onderzoeken betrouwbaarheid nieuwe gebruiksvriendelijke sneltest
april 6, 2021
Hoe sneller je weet of je corona hebt, hoe beter. En dan het liefst ook nog met een gebruiksvriendelijke test. Om dat mogelijk te maken wordt er onderzoek gedaan naar sneltesten. Daarom is het Groene Hart Ziekenhuis in samenwerking met de GGD Hollands Midden gestart met de GORAT studie. Dit is een validatiestudie van de Joysbio […]

BeterKeten cheque van € 207.000 voor longonderzoek te vroeg geboren kinderen
april 1, 2021
Ongeveer 8% van alle kinderen wordt te vroeg geboren. Te vroeg geboren kinderen hebben vaker luchtwegklachten in het eerste levensjaar en een lagere longfunctie; zij ontwikkelen op de lange termijn vaker chronische longziekten. In Franciscus Gasthuis & Vlietland, Maasstad Ziekenhuis, Albert Schweitzer ziekenhuis en Erasmus MC kunnen in de toekomst naar verwachting deze kinderen nog […]

Meer Rotterdammers kregen schuldhulp in 2020
april 1, 2021
Verdubbeling bereik jongeren Rotterdam deed twee jaar geleden een “Reset” van de schuldenaanpak. Dit werkt: het aantal Rotterdammers met problematische schulden nam de afgelopen jaren af. Van 27.000 in 2018 tot 25.000 in 2020. Meer Rotterdammers krijgen hulp, er is minder uitval, de dienstverlening is verbeterd en er zijn veel nieuwe interventies en samenwerkingen gestart. […]

Eerste editie Dutch Health Week vanuit Jaarbeurs Studio’s
maart 31, 2021
Van 18 tot en met 21 mei vindt de allereerste editie van de Dutch Health Week plaats. De Dutch Health Week is een nieuw, meerdaags online evenement waarin de toekomst van de gezondheidszorg centraal staat. Onder het motto ‘Let’s improve health together’ slaan de beurzen Zorg & ICT, Zorgtotaal en Support de handen ineen met […]

Sterker uit de crisis met innovatieve ideeën van Rotterdammers
maart 31, 2021
3 miljoen beschikbaar voor nieuwe ronde CityLab010 Voor het zevende jaar op rij zet het programma CityLab010 van de gemeente Rotterdam haar deuren open voor innovatieve ideeën van Rotterdammers. Dit jaar is ruim 3 miljoen euro beschikbaar voor initiatieven die Rotterdam sterker uit de coronacrisis helpen. Er is één doel: sterker uit de crisis komen […]

Gemeente Rotterdam kiest voor cultuur en innovatie in fabriekscomplex in M4H
maart 31, 2021
Gemeente wil ‘Kunst & Complex’ gunnen aan Team Crossing Keileweg Het plan van consortium Team Crossing Keileweg voor de voormalige fabriek aan de Keileweg 26-28, beter bekend als ‘Kunst & Complex’, is als beste uit de bus gekomen in de openbare verkoopprocedure. De gemeente heeft gekozen voor het plan dat het beste aansluit op de […]

Webinar Armoede en bestaansonzekerheid | Evenement
maart 30, 2021
8 april 2021 van 15:00-16:30 uur Een korte beschrijving: Armoede, bestaansonzekerheid en sociale ongelijkheid vormen in Nederland een hardnekkig vraagstuk dat zich voordoet in allerlei gedaanten en gezichten, zoals werkloosheid, eenzaamheid, zwakke gezondheid, dakloosheid en schulden. Het vraagstuk raakt zowel volwassenen als jongeren maar beïnvloedt eveneens het dagelijkse werk van sociaal professionals, bestuurders, beleidsmakers en […]

Verbonden met jouw te vroeg geboren baby dankzij de NeoZorg app
maart 30, 2021
Het Maasstad Ziekenhuis en het Ikazia Ziekenhuis lanceren een nieuwe app die de ouders van pasgeboren baby’s op de afdeling Neonatologie helpt bij de zorg voor hun baby. Met de NeoZorg app blijven ze, ook als ze even niet in het ziekenhuis kunnen zijn, door middel van berichten en foto’s in contact met hun baby. […]

De 10 duizendste covid-patient op IC
maart 30, 2021
Ruim een jaar na het eerste geval van corona wordt vandaag de 10 duizendste covid-patiënt opgenomen op een Nederlandse IC. Het gemiddeld aantal covid opnames per dag is momenteel 55. Dit blijkt uit de Nationale Intensive Care Evaluatie (NICE) een landelijke registratie van alle Nederlandse IC-data. Deze trieste mijlpaal geeft ook aan hoe groot de […]

AMC Promoties week 29-4 maart/april
maart 29, 2021
Hierbij een overzicht van de promoties van Amsterdam UMC tussen 29 maart en 1 april 2021. Maandag 29 maart Promotie (UvA), 14.00 uur, online Amir Kachooei: Elleboogbreuken in kaart gebracht Een breuk aan de kop van het spaakbeen is de meest voorkomende breuk rond de elleboog. Van alle elleboogletsels gaat het in 30-44 procent van de gevallen om een […]

IC op wielen rijdt ‘rondje om de aarde’
maart 29, 2021
Pre-covid reed de Mobiele Intensive Care Unit (MICU) Amsterdam zo’n tweehonderd ritjes per jaar. Nu heeft deze IC op wielen er – in nog geen zes maanden tijd – al meer dan 400 ritjes opzitten. “Afgelopen weekend tikten we de 40.075 kilometer aan, een rondje om de aarde. Alles om code zwart, waarin ziekenhuizen moeten […]

Kankertherapie kan efficiënter: beter voor patiënt, kosten én milieu
maart 29, 2021
Internist-oncoloog Stefan Sleijfer en ziekenhuisapotheker Roelof van Leeuwen van het Erasmus MC Kanker Instituut werken nauw samen om kankertherapieën doelmatiger te maken. Dat is goed voor de patiënt, maar ook voor de portemonnee van de Nederlandse maatschappij én voor het milieu. De afdeling Interne Oncologie bespaart met de inspanningen jaarlijks ongeveer 7 miljoen euro. Voorbeeld: […]

Rotterdam start campagne voor verduurzamen stad
maart 29, 2021
Op maandag 29 maart start de gemeente Rotterdam de campagne ‘Power voor Rotterdam’. Met deze campagne roept de gemeente Rotterdammers, ondernemers, scholen en sportverenigingen op om juist nu te verduurzamen. De gemeente stelt vanaf 29 maart een veelheid aan subsidies, leningen en gratis adviezen beschikbaar om daarbij te helpen. Power voor Rotterdam In de campagne […]

Zonnetje, terras én voldoende ruimte voor voetgangers met visuele beperking
maart 25, 2021
Utrecht, 23 maart 2021 – In het zonnetje op een terras zitten met een lekker drankje, daar dromen we na het lange thuis zitten allemaal wel van. Het bericht dat de terrassen in grootte mogen uitbreiden om de afstandsregels te kunnen waarborgen, biedt voor ondernemers meer mogelijkheden om op een veilige manier hun zaak te […]

Ontwikkeling Telt Festival
maart 25, 2021
18 maart 2021 Hoe zorgen we ervoor dat iedere volwassene in Nederland zich een leven lang kan blijven ontwikkelen en zelfstandig mee kan doen in onze maatschappij? Hoe zorgen we voor een positieve leercultuur en hoe vormen we sterke regionale leernetwerken? Deze en andere vragen staan centraal tijdens het driedaagse (online) Ontwikkeling Telt Festival. Het Actie […]

Training Projectmatig creëren
maart 25, 2021
Projectmatig Creëren is de meest complete projectmanagementmethode in Nederland. Wij bieden een mooie training aan voor medewerkers uit de deRotterdamseZorg organisaties die projectmatig willen leren werken.Kosten: 450,- excl. btw voor externen. Er nu een online training op maat gemaakt bestaande uit 3 dagdelen. Data: Maandag 29 maart (ochtend)Dinsdag 30 maart (ochtend)Donderdag 1 april (middag) Bron: […]

Ontdekdezorg week 2021
maart 25, 2021
Maandag 22 maart 2021 Van 22 tot en met 27 maart 2021 vindt de Ontdekdezorg week plaats. De Ontdekdezorg week wordt georganiseerd om potentiële zij-instromers en herintreders te interesseren in een baan in zorg en welzijn. Tijdens deze week kunnen zij de mogelijkheden van de sector zorg en welzijn ontdekken. Ze oriënteren zich, kunnen rondkijken […]

Opening Ontdekdezorg week 2021
maart 25, 2021
Maandag 22 maart 202116.00 uur Op maandag 22 maart om 16:00 openen we op een feestelijke manier de Ontdekdezorg week! H.M. Koningin Maxima is hierbij aanwezig. Zij gaat digitaal in gesprek met 4 herintreders/zij-instromers die vanuit een heel ander beroep de overstap hebben gemaakt naar een baan in zorg en welzijn. Daarnaast lichten we een […]

Europese norm voorkomt doping in voeding voor sporters en supplementen
maart 24, 2021
Er is een nieuwe Europese norm opgesteld met eisen aan de ontwikkeling en productie van voeding voor sporters en voedingssupplementen. Doel is om het risico op de aanwezigheid van verboden stoffen te minimaliseren. Het gaat om stoffen van de lijst van de World Anti-Doping Agency (WADA). Het gebruik van de norm leidt niet tot aanbeveling […]

Twee nieuwe ISO normen voor bepaling suikers in melk en zuivelproducten.
maart 24, 2021
Er zijn twee nieuwe ISO normen beschikbaar waarmee het gehalte van een aantal specifieke suikers in zuivelproducten kan worden bepaald. Met NEN-EN-ISO 22184 kunnen de zes belangrijkste suikers worden gemeten die van nature in zuivel voorkomen of er aan worden toegevoegd. NEN-EN-ISO 22579 is ontwikkeld voor de bepaling van fructanen in zuigelingenvoeding. NEN-EN-ISO 22184 en NEN-EN-ISO […]

Wandel tijdens je Werk-dag
maart 23, 2021
Partner Wandelnet organiseert niet de Wandel naar maar Wandel tijdens je Werk-dag. Wat in 2015 begon is nu een nationaal evenement dat op 8 april 2021 weer plaatsvindt. Tijdens de Wandel naar je Werk-dag liepen vorig jaar duizenden mensen van huis naar werk. In 2021 wordt iedereen opgeroepen om (een deel van) de afstand lopend […]

Inspiratieseminar Groene GGZ
maart 23, 2021
Datum: donderdag 8 aprilLocation: Buiten Natuur in de geestelijke gezondheidszorgOp 22 april 2021 vindt het online inspiratieseminar Groene GGZ plaats, georganiseerd door Nature For Health en IVN. Groen is gezond! Uit onderzoek blijkt dat contact met de natuur zorgt voor meer geluk en minder stress. Wil je ontdekken hoe natuur een helende werking heeft op […]

Publieksacademie Kinderarmoede Utrecht
maart 23, 2021
Datum: donderdag 1 april Time: 16:00 – 18:30 uur Location: Online Op 1 april 2021 organiseren de Armoedecoalitie Utrecht en de Alliantie Kinderarmoede samen met de schoolbesturen SPO Utrecht, PCOU Willibrord en KSU de Publieksacademie Kinderarmoede Utrecht. Centrale thema: Samenwerken rondom de school. In een (online) programma gaan lokale professionals, vrijwilligers en ervaringsdeskundigen in gesprek […]

Publieksacademie Kinderarmoede Twente
maart 23, 2021
Datum: woensdag 24 maart Time: 12:00 – 16:00 uur Location: online Helaas voor de 350 deelnemers ging de Publieksacademie Kinderarmoede Twente vanwege coronamaatregelen vorig jaar niet door. Gelukkig is er op woensdag 24 maart 2021 een (online) herkansing. Doel is om -op lokaal niveau- het thema kinderarmoede bespreekbaar te maken en de krachten te bundelen om […]

Promoties Amsterdam UMC: 22-26 maart 2021
maart 22, 2021
Hierbij ontvangt u een overzicht van de promoties van Amsterdam UMC tussen 22 en 26 maart 2021 Woensdag 24 maart Promotie (UvA), 11.00 uur, online Arnold van de Laar: Wat je van een maagverkleining mag verwachten De resultaten van een maagverkleiningsoperatie bij patiënten met ernstig overgewicht worden doorgaans beoordeeld op basis van behandeldoelen die meer […]

Eerste gentherapie bij oogheelkundig patiënt in Nederland uitgevoerd in Het Oogziekenhuis Rotterdam
maart 22, 2021
Rotterdam, 22-03-2021 – In Het Oogziekenhuis Rotterdam is de eerste netvliesoperatie met gentherapie in Nederland uitgevoerd bij een 26-jarige man. Door het toevoegen van een gezond gen kan het netvlies weer beter gaan werken. Zonder behandeling wordt deze patiënt binnen afzienbare tijd blind. De behandeling met het middel genaamd ‘voretigene neparvovec’ is ontwikkeld voor mensen […]

Droge ogen kunnen behandeld worden met serum uit donorbloed
maart 19, 2021
Mensen met extreem droge ogen kunnen serumoogdruppels krijgen, afkomstig uit het bloed. Al tientallen jaren gebeurt dat met serum dat verkregen wordt uit bloed van de patiënt zelf. Onderzoekers van het Radboudumc laten in samenwerking met bloedbank Sanquin zien dat gebruik gemaakt kan worden van serum uit donorbloed. De resultaten van hun onderzoek hiernaar zijn […]

Amerikaanse behandeling voor hersenschudding tegen het licht
maart 19, 2021
Amsterdam UMC gaat samen met UMC Groningen onderzoek doen naar de werking van de Cognitive FX-behandeling, een Amerikaanse behandeling voor langdurige klachten na een hersenschudding. Dit heeft de Hersenstichting deze week laten weten in een persbericht. Zij financieren de studie met 200.000 euro. “De CFX-behandeling is behoorlijk kostbaar”, vertelt Marsh Königs, neurowetenschapper bij Amsterdam UMC […]

NIEUWE MRI-SCANNER VOOR LOCATIE ETZ TWEESTEDEN
maart 19, 2021
Een nieuwe MRI-scanner met meer comfort voor de patiënt en haarscherpe beelden. Het ETZ (Elisabeth-TweeSteden Ziekenhuis) plaatste gisteren een hypermoderne MRI-scanner op locatie ETZ TweeSteden. Een gedeelte van de ziekenhuisgevel moest tijdelijk worden verwijderd om de scanner op zijn plek te krijgen. De nieuwe MRI-scanner – de Philips Ambition – behoort tot de jongste generatie […]

Jaarcongres Zelforganisatie
maart 18, 2021
Sommige zelforganiserende teams floreren tijdens de crisis, terwijl andere teams volledig terugvallen in oude hiërarchische patronen. Hoe komt dat? Wat kunnen we leren van de invloed van de coronacrisis op het zelforganiserend vermogen van teams en organisaties? En hoe houden we vol? Leer van de fouten, successen en dilemma’s van anderen De weg naar zelforganisatie […]

Masterclass De Kracht van Confrontatie
maart 18, 2021
U wilt als teammanager dat professionals hun verantwoordelijkheid nemen en elkaar feedback geven, in plaats naar elkaar wijzen en de boel tegenwerken. Door collega’s op een goede manier te confronteren, maakt u ruimte vrij voor betere samenwerking en nieuwe ideeën. Waarom is aanspreken dan toch zo lastig? Wanneer kiest u voor welke confrontatiemethode? Hoe doet […]

Dag van de Preventie
maart 18, 2021
Het belang van een gezonde leefstijl en preventie is door de coronacrisis eens te meer duidelijk geworden. Preventie verdient een nog prominentere plek in het zorgstelsel. Maar hoe is dit optimaal te organiseren? Helpt het om naast de zorgplicht ook een ‘gezondheidsplicht’ op te nemen in de vijf zorgwetten (Zvw, Wlz, Wmo, Jeugdzorg en Wet […]

Congres Dilemma’s in de Wet zorg en dwang
maart 18, 2021
Heeft uw organisatie de implementatie al op orde? 2020 was een overgangsjaar voor de invoering van de Wzd. Vanaf 1 januari jl. biedt de IGJ wel ruimte aan zorgaanbieders bij de uitvoering van de wet maar zal ook handhavend optreden, als de kwaliteit en veiligheid van de zorg in het geding komt. Overziet u alle […]

Lancering Dutch Health Leaders Foundation
maart 18, 2021
ROTTERDAM, 18 maart 2021 – Op 18 maart 2021 is tijdens het Rotterdamse LSH010 innovatieontbijt de Dutch Health Leaders Foundation gelanceerd. Deze stichting is opgericht om samen met zorgondernemers de implementatie van nieuwe technologieën in de gezondheidszorg te versnellen. Via de Dutch Health Leaders Foundation krijgen ondernemers eenvoudiger toegang tot een netwerk van zowel internationale […]

Zorgonderwijs vernieuwers
maart 18, 2021
Antwoord op breinbrekers in het onderwijs Let op: dit congres wordt digitaal georganiseerd. Jouw voordelen: geen reistijd veilig vanuit huis te volgen inclusief congrespakket Congres Breinbrekers in het onderwijs De coronacrisis heeft een grote impact op het zorgonderwijs. Dit heeft ook grote gevolgen voor jouw onderwijs. Hoe zet jij jouw student in zijn kracht als […]

Congres Concentratie en spreiding Acute Zorg
maart 18, 2021
In één dag inzicht in een optimale organisatie van acute zorg De acute zorg staat aan de vooravond van ingrijpende hervormingen. Het tekort aan gespecialiseerd personeel en de vergrijzing maken concentratie van spoedzorg onafwendbaar. Toch zien veel ziekenhuizen een reductie van het SEH’s niet zitten. Volgens hen toont de coronacrisis juist het belang van een […]

Breinwijs
maart 18, 2021
Veerkracht, mentale fitheid en positief beïnvloeden ‘Fit brein’, veerkracht en positief activeren: thema’s die in deze turbulente tijden aan de orde van de dag zijn. De psychische effecten van de coronacrisis worden namelijk steeds duidelijker. Depressieve klachten, angsten en stress liggen op de loer. Om hier grip op te krijgen is het belangrijk om te […]

National Health Tender Day 2021
maart 18, 2021
Sinds de decentralisatie van de zorg zijn gemeenten verantwoordelijk voor het organiseren van maatschappelijke ondersteuning van langdurig zieken, ouderen, jeugdzorg en psychische hulp. Na een lastige start wordt verbetering langzaam zichtbaar. Grip op budget en bekostiging Zorg wordt dichter bij huis georganiseerd, al blijft de totale financiering een grote uitdaging. Gemeenten proberen grip te krijgen […]

Promoties Amsterdam UMC: 15 – 19 maart 2021
maart 16, 2021
Maandag 15 maartPromotie (VU), 09.45 uur onlineMyrte Strik: Problemen handfunctie en lopen gerelateerd aan verstoord hersennetwerk bij MS Bij multiple sclerose (MS) komen stoornissen in hand- en loopfunctie vaak voor, maar niet altijd tegelijk. Om deze verschillen te verklaren, bestudeerde Myrte Strik patronen van hersenschade en communicatie tussen verschillende hersengebieden, het hersennetwerk. In haar promotieonderzoek zag […]

Patiënten van het Maasstad Ziekenhuis met infectie eerder naar huis met antibiotica-infuus
maart 16, 2021
Het Maasstad Ziekenhuis biedt patiënten die voor hun infectie langdurig antibiotica via een infuus nodig hebben de mogelijkheid om eerder uit het ziekenhuis te worden ontslagen en thuis verder te herstellen, terwijl de behandeling met antibiotica doorgaat. Door de goede samenwerking met thuiszorginstellingen Aafje, Careyn en Laurens heeft de behandeling zo minder impact op de […]

Europese wetenschappers: ‘Maak voedselkeuzelogo Nutri-Score verplicht’
maart 16, 2021
Meer dan 250 Europese wetenschappers en medische instanties roepen de Europese Commissie op om het voedselkeuzelogo Nutri-Score verplicht te maken in de EU AMSTERDAM 16 MAART 2021 – Deskundigen op het gebied van voeding en gezondheid waarschuwen tegen lobbypogingen van de voedselindustrie en een aantal EU-lidstaten om de verplichte etikettering van een nieuw voedselkeuzelogo op […]

Willemien Kastelein versterkt raad van toezicht ETZ
maart 15, 2021
Willemien Kastelein is met ingang van 1 april 2021 benoemd tot lid van de raad van toezicht van het ETZ (Elisabeth-TweeSteden Ziekenhuis) in Tilburg. Zij zet als toezichthouder haar kennis op het gebied van gezondheidsrecht voor het ziekenhuis in. Willemien Kastelein (64) beëindigt haar werkzaamheden als advocaat/partner bij Nysingh advocaten-notarissen in de marktgroep gezondheidszorg. Zij […]

Boek over geschiedenis Tilburgse ziekenhuizen
maart 15, 2021
Is Tilburg beter af met één of twee ziekenhuizen? Deze vraag staat centraal in het nieuwe boek ‘Met of tegen elkaar’. In deze 176 pagina’s omvattende uitgave is door historicus Rob Wolf het verloop van de geschiedenis van de ziekenhuizen in Tilburg vastgelegd, vanaf het einde van de Tweede Wereldoorlog tot en met de eerste coronagolf […]

NS schrapt vaste ticketservicebalies, maar breidt reisassistentieservice uit
maart 15, 2021
NS wil het aantal stations met een vaste ticketservicebalie terugbrengen van 36 naar 15. Andere servicediensten, zoals reisassistentie voor reizigers met een beperking, de OV-fiets of de StationsHuiskamer, blijven voor reizigers gewoon beschikbaar en worden zelfs uitgebreid. Steeds meer reizigers kopen hun kaartjes online, via de app of NS.nl. Reden voor de NS om te snijden […]

Mensen met visuele beperking stemmen met speciale hulpmiddelen
maart 15, 2021
Utrecht, 15 maart 2021 – Op 15, 16 en 17 maart 2021 vindt de Tweede Kamerverkiezing plaats. Hierbij telt elke stem, ook die van mensen die bijvoorbeeld door een visuele beperking het stembiljet niet kunnen lezen en niet kunnen zien welk vakje rood te kleuren. De Oogvereniging, het Ministerie van Binnenlandse Zaken en Koninkrijksrelaties, Koninklijke […]

Tweede online bariatriecafé obesitas centrum is succes
maart 9, 2021
Het Obesitas Centrum hield in februari een tweede online bariatriecafe met 14 patiënten die een bariatrische operatie (ter behandeling van overgewicht) hebben ondergaan. Tijdens het bariatriecafé deelden lotgenoten hun ervaringen en gaven elkaar tips over hoe je een gezonde leefstijl na je bariatrische operatie zo goed mogelijk kunt volhouden. Patiënten van het Obesitas Centrum hechten […]

Nieuw zorgpad voor patiënt met hypofyse tumor
maart 9, 2021
Het ETZ (Elisabeth-TweeSteden Ziekenhuis) heeft voor patiënten met een gezwel in de hypofyse de complete behandeling in een nieuw zorgpad vastgelegd. Patiënten komen daardoor sneller bij de juiste zorgverlener terecht, zonder onnodige wachttijden. Bovendien kunnen patiënten nu na de operatie één dag eerder naar huis. Zorgpad Een zorgpad richt zich op de logistiek en afstemming […]

Wetenschapsagenda AMC 8-12 maart
maart 8, 2021
Hierbij een overzicht van de promoties van Amsterdam UMC tussen 8 en 12 maart Maandag 8 maart Promotie (VU) 11.45 uur online Mirjam Stuij: Beweging in de type 2-diabeteszorg Bewegen wordt beschouwd als een ‘hoeksteen’ van de diabeteszorg. Hoe gaan mensen met type 2 diabetes om met de boodschap dat ze meer moeten gaan bewegen omdat dat […]

Pandemic & Disaster Preparedness Center gaat hoogrisicovirussen in kaart brengen
maart 8, 2021
Het Pandemic & Disaster Preparedness Center (PDPC) gaat hoogrisicovirussen in kaart brengen om een toekomstige pandemie voor te zijn. Zogenoemde wetlands rond deltasteden kunnen een oplossing zijn voor de stijgende zeespiegel door klimaatveranderingen. Maar ze verhogen ook de kans op door muggen overgebrachte ziekten, zoals virusinfecties. Dit voorbeeld laat zien dat samenwerking vanuit diverse vakgebieden […]

Hogere kans op hart- en vaatziekte na zwangerschaps-vergiftiging
maart 8, 2021
Vrouwen die tijdens hun zwangerschap last hebben van ernstige zwangerschapsvergiftiging, ofwel pre-eclampsie, hebben een grotere kans op hart- en vaatziekten later in het leven. Internist Jeanine Roeters van Lennep en gynaecoloog Hans Duvekot van het Erasmus MC pleiten ervoor om deze vrouwen in heel Nederland te volgen tot vele jaren na de bevalling. Roeters van […]

Nationale Week Zonder Vlees; Restaurant eazie bezorgt de favoriete maaltijd van De Hippe Vegetariër, de oprichtster van de NWZV.
maart 5, 2021
Maandag 8 maart start de Nationale Week Zonder Vlees, een initiatief van Isabel Boerdam, oprichtster van De Hippe Vegetariër; het grootste vegetarische platform van Nederland. Haar favoriete maaltijd kan iedereen nu proeven. Restaurant eazie bezorgt deze aan huis. Positieve impact op mens, dier en milieu De Nationale week zonder vlees loopt dit jaar van maandag 8 […]

WHO: 1 op 4 mensen zal naar verwachting gehoorproblemen hebben in 2050
maart 4, 2021
Bijna 2,5 miljard mensen ter wereld – oftewel 1 op de 4 mensen – zal in 2050 in een zekere mate last krijgen van gehoorverlies, zo waarschuwt het eerste wereldrapport over het gehoor van de Wereldgezondheidsorganisatie (WHO), dat op Wereldhoordag op 3 maart is uitgebracht. Tenminste 700 miljoen mensen zullen toegang nodig hebben tot oor- […]

Persbericht: Het Oogziekenhuis Rotterdam maakt plannen voor ontwikkeling nieuwe locatie op terrein Erasmus MC
maart 4, 2021
Het Oogziekenhuis Rotterdam is gestart met planvorming voor de bouw van een nieuwe locatie van het ziekenhuis op het terrein van het Erasmus MC. Deze locatie, waar zich de komende jaren meerdere innovatieve (zorg)organisaties vestigen, past goed bij het specialistische karakter van het ziekenhuis. Het Oogziekenhuis Rotterdam zet de komende jaren nog sterker in op […]

Vernieuwde hybride operatiekamer van het Maasstad Ziekenhuis is dé hightech operatiekamer van de toekomst
maart 3, 2021
Patiënten van het Maasstad Ziekenhuis met ernstige vaataandoeningen worden voortaan geopereerd in een gloednieuwe hypermoderne hybride operatiekamer (OK). Dankzij ingebouwde hightech röntgenapparatuur krijgen de vaatchirurg en interventieradioloog de vaten tijdens de operatie nog nauwkeuriger in beeld. Hierdoor kan de chirurg via kleine gaatjes opereren en de ingreep ook tussentijds controleren. Dit verbetert de kwaliteit van de operaties, waardoor patiënten sneller herstellen en naar huis kunnen.

Realisatie hypermoderne hybride operatiekamer Franciscus Gasthuis
maart 3, 2021
Franciscus Gasthuis & Vlietland heeft de splinternieuwe hybride operatiekamer in gebruik genomen. Deze hightech hybride operatiekamer is gerealiseerd direct aan het bestaande operatiecomplex van Franciscus Gasthuis. In deze nieuwe operatiekamer kunnen 2 ingrepen in 1 ruimte worden gedaan. Gijs Welten, vaatchirurg Franciscus Gasthuis & Vlietland: ‘Stel je hebt een motorongeluk en een situatie met interne bloedingen en […]

Coronamaatregelen isoleren ernstig slechthorenden
maart 3, 2021
Ernstig slechthorenden ervaren door de huidige coronamaatregelen veel extra gehoorproblemen. Maatregelen als het dragen van een mondkapje en afstand houden, beperken hun communicatie sterk en leiden tot een isolement voor deze groep. Ook beeldbellen dat normaalhorenden veel voordeel oplevert, biedt slechthorenden geen soelaas. Dit blijkt uit onderzoek van de afdeling KNO/audiologie van Amsterdam UMC onder […]

Foodwatch eist einde aan sponsoring EU door bedrijfsleven.
maart 3, 2021
Belangenverstrengeling hoort niet thuis bij EU-voorzitterschap Verschillende foodwatch-kantoren hebben samen met andere maatschappelijke organisaties de krachten gebundeld. De voedselwaakhond wil dat regeringen van Europese lidstaten een einde maken aan bedrijfssponsoring van de voorzitterschappen van de Raad van de Europese Unie. Amsterdam/Berlijn/Brussel/Lissabon/Parijs, 03 maart 2021 – Drie Europese maatschappelijke organisaties (foodwatch, Corporate Europe Observatory en Climáximo) hebben felle […]

Wetenschapsagenda 1-5 maart Amsterdam UMC
maart 2, 2021
Hierbij een overzicht van de promoties van Amsterdam UMC, 1 tot 5 maart. Maandag 1 maart, Promotie (UvA), 14.00 u, onlineEsmée Liem: Betere diagnostiek blaaskanker Met een nieuwe beeldvormingstechniek is het mogelijk om blaaskanker te visualiseren en ook een uitspraak te doen over de ernst van de ziekte. De arts kan de beelden zelf beoordelen maar met […]

Persaankondiging: slotbijeenkomst De Wijk aan Zet!
maart 2, 2021
Meer inspraak, middelen en mogelijkheden naar de Rotterdamse wijk Hoe zorgen we dat meer Rotterdammers kunnen meedoen, meedenken en meebeslissen? Hoe geven we meer ruimte aan de wijkdemocratie? Hoe krijgen we, kortom, de wijk aan zet? Na een maand lang stadsgesprekken te hebben gevoerd met verschillende Rotterdammers over een optimale wijkdemocratie is het tijd om […]

Wereld Glaucoomweek 2021: tijdige diagnose voorkomt gezichtsveld verlies
maart 1, 2021
Utrecht, 1 maart 2021 – Bent u 40 jaar of ouder, zit de oogaandoening glaucoom bij u in de familie, of heeft u een bril sterker dan +6 of -6? De Oogvereniging en de Optometristen Vereniging Nederland (OVN) raden u dan aan uw ogen te laten controleren op glaucoom, een oogaandoening die ongemerkt kan leiden […]

Buikgriep virus niet altijd onschuldig bij pasgeboren en jonge kinderen
maart 1, 2021
Ted van Hinsbergh heeft onderzocht wat de gevolgen van een hersenvliesontsteking door een parechovirus-infectie kunnen zijn bij pasgeboren en jonge kinderen. De studie krijgt door een publicatie in The Lancet internationale aandacht. Kinderfysiotherapeut en klinisch epidemioloog Ted van Hinsbergh dient de komende maand bij de leescommissie het proefschrift in van haar onderzoek naar de invloed van de buikgriepvirussen […]

Zilveren Kruis en Santeon werken samen aan nieuwe initiatieven ter verbetering van de zorg
maart 1, 2021
Zilveren Kruis en de Santeon ziekenhuizen, waaronder het Maasstad Ziekenhuis, gaan intensief samenwerken. De samenwerking is gericht op het verbeteren van de Nederlandse ziekenhuiszorg, waarbij de zorg doelmatiger en efficiënter wordt geleverd, de zorg waar mogelijk dichterbij de patiënt wordt georganiseerd, de patiënttevredenheid toeneemt en waarbij de zorgkosten gelijk blijven of zelfs dalen. Het digitaliseren […]

‘Ik werk graag met mensen, dat heeft bij mij altijd voorop gestaan’
februari 25, 2021
Of er veel veranderd is sinds Nick van den Eijnden veertien jaar geleden als beveiliger bij MMC kwam werken? ‘Oh ja, het was heel anders werken toen. Het ziekenhuis was nog een stuk kleiner en de werkzaamheden waren niet zo divers als nu,’ zegt Nick. Wat al die tijd hetzelfde gebleven is, is dat hij […]

Roodkapjes in Rotterdam
februari 24, 2021
De eerste mantelzorger, was dat niet Roodkapje?De Roodkapjes nemen mantelzorgers mee voor een dag zonder zorgen. En dan komen de verhalenlos! En die verhalen zijn vaak zo mooi en zo herkenbaar, die willen we je niet onthouden. Luister naarde verhalen van mensen die voor elkaar vallen, voor elkaar door het vuur gaan, van elkaar blijvenhouden. […]

Oogletsel door vuurwerk bij slechts 47 mensen
februari 22, 2021
Nijmegen, 22 februari 2021 – Deze jaarwisseling hebben slechts 47 mensen oogletsel door vuurwerk opgelopen. Het verbod op het afsteken van consumentenvuurwerk heeft dan ook gezorgd voor 75% minder oogletsels door vuurwerk dan in vergelijking met vorig jaar. De stijgende lijn van oogletsels door vuurwerk is daarmee – in ieder geval voor één jaarwisseling – […]

Goed geïnformeerd de zwangerschap door met de ZwApp+
februari 19, 2021
Als je zwanger bent, wil je het liefst zo veel mogelijk weten over de zwangerschap, de bevalling en de kraamtijd. Daarom gebruiken het Maasstad Ziekenhuis en meerdere verloskundigen en gynaecologen in Rotterdam-Zuid en omgeving sinds kort ZwApp+ om zwangeren en partners goed te informeren. In deze gratis app staat allerlei informatie, die is samengesteld en […]

Algoritme ondersteunt radiologen Elisabeth-TweeSteden Ziekenhuis, Primeur ETZ: slimme software beoordeelt longfoto’s
februari 18, 2021
Het ETZ (Elisabeth-TweeSteden Ziekenhuis) is als eerste ziekenhuis in Nederland een proef gestart met een algoritme dat longfoto’s beoordeelt. Dit kan het vak van radiologen veranderen. De eerste resultaten van het werken met de nieuwe, probleemoplossende software zijn veelbelovend. Het ziekenhuis wil weten of radiologen in de toekomst kunnen vertrouwen op de inzet van kunstmatige […]

Een nieuw uiterlijk voor MARLENE
februari 17, 2021
Recentelijk onthulde het VOG consortium het nieuwe ontwerp van Marlene appels voor haar 25ste jubileum. Uit meer dan 6.000 inzendingen kwam ‘Een nimf tussen de appelboomgaard’ van grafisch ontwerpster Francesca Cito (35) als uitverkoren uit de bus. In september jl. daagde het consortium, dat ruim 4600 appelboeren uit Zuid–Tirol-Südtirol (Italië) vertegenwoordigt, wereldwijd kunstenaars uit voor de verkiezing van het jubileumontwerp. Nog eens […]

Hoe een assistentiehond mensen met een beperking helpt
februari 16, 2021
Niets is meer vanzelfsprekend als je leeft met een beperking of langdurige ziekte. Je dagelijkse activiteiten vergen meer energie, tijd en hulp. Hoe ga je daarmee om en wat kun je doen om niet elke keer weer om hulp te hoeven vragen? Een assistentiehond kan op een hele mooie en praktische manier helpen! Een assistentiehond […]

Slechtziende allround mediamaker Annemiek van Munster schrijft boek over geleidehond
februari 16, 2021
Annemiek van Munster is een 44-jarige slechtziende allround mediamaker – ze is schrijfster, blogger, vlogger én radiomaker. Ze is slechtziend geboren, maar dit weerhoudt haar niet van het najagen van haar dromen. Dit jaar brengt zij haar derde boek uit:Geleidehond Yoko. De verhalen in het boek zijn grappig, maar hebben wel degelijk ook een serieus […]

Santeon ziekenhuizen stroomlijnen diagnostiek op het gebied van prostaatkanker
februari 16, 2021
Prostaatkanker is de meest voorkomende vorm van orgaankanker onder mannen. In 2019 kregen ongeveer 13.500 mannen in Nederland deze diagnose, waarvan bijna 20% in één van de Santeon ziekenhuizen. Sinds 2016 werken de Santeon ziekenhuizen actief samen aan het verbeteren van de zorg rondom prostaatkanker. Op een aantal onderwerpen zijn nu afspraken gemaakt om de […]

Ikazia Ziekenhuis kiest voor Vidaví, Vidaví is dé ERP-oplossing van VCD Healthcare
februari 16, 2021
Gisteren werden door het Ikazia Ziekenhuis en VCD Healthcare de handtekeningen gezet onder het definitieve contract voor de aanschaf en implementatie van de ERP-oplossing Vidaví. De opdracht was eind vorig jaar al voorlopig gegund aan VCD Healthcare en na de finetuning van de specificaties is de opdracht nu definitief. Vidaví is een totaalconcept dat de complexe inkoop, […]

Promoties Amsterdam UMC, 15-19 februari
februari 15, 2021
Hierbij ontvangt u een overzicht van de promoties van Amsterdam UMC in de week van 15 tot 19 februari 2021. Maandag 15 februari Promotie (UvA), 14.00 uur, onlineInge de Krijger: Repareren van schade aan DNA Het DNA, waarin de informatie wordt opgeslagen die elke cel nodig heeft om zijn functie uit te oefenen, moet zorgvuldig worden […]

Patiënten krijgen via het portaal meer regie over de eigen zorg, Mijlpaal: 100.000 patiënten gebruiken Mijn ETZ
februari 15, 2021
Steeds meer patiënten van het ETZ (Elisabeth-TweeSteden Ziekenhuis) gebruiken patiëntenportaal MijnETZ om vanuit huis de eigen zorg te regelen. Drie jaar na de lancering van MijnETZ is de 100.000ste gebruiker geregistreerd. Een mooie mijlpaal, vindt projectleider Femke van Wetten. “InMijnETZ kunnen patiënten grote delen van hun medisch dossier digitaal inzien.Daarmee willen we patiënten meer betrekken bij […]

Event Medical Delta Café
februari 9, 2021
De gezondheidszorg is voor meer dan 8% debet aan onze totale nationale CO2 footprint (bron: ZonMw). Hoewel dit voor een groot deel het energieverbruik in de zorg betreft, is er veel winst te behalen met afvalreductie en inzet van duurzame technieken en technologieën. Zo heeft de operatiekamer een groot aandeel in de afvalproductie. Minder afval […]

Promoties Amsterdam UMC, 8-12 februari
februari 9, 2021
Hierbij een overzicht van de promoties van Amsterdam UMC in de week van 8 tot 12 februari. Woensdag 10 februariPromotie (UvA), 11.00 uur, online Willianne Hoepel: De veiligheid-schakelaars van ons immuunsysteem Dagelijks belagen ongewenste indringers (ziekteverwekkers) zoals bacteriën en virussen ons lichaam. Antistoffen beschermen ons daartegen. Dit is een delicaat proces, want verkeerde of onjuiste activatie van […]

Rotterdam vraagt aandacht voor meisjesbesnijdenis
februari 8, 2021
Op maandag 8 februari 2021 is Rotterdam gaststad voor de nu online landelijke bijeenkomst ter gelegenheid van Zero Tolerance Day, de internationale dag tegen vrouwelijke genitale verminking (6 februari). Samen met het Centrum Jeugd en Gezin Rotterdam Rijnmond en de leden van Platform 6/2 wil de gemeente Rotterdam dat dit schadelijke, traditionele én strafbare gebruik […]

Webinar: Batenstrategie voor Gezondheid en Vitaliteit
februari 5, 2021
Op dinsdag 9 maart 2021 van 14.00-15.00 uur organiseren de Federatie voor Gezondheid en Alles is Gezondheid het verdiepende Webinar: ‘Batenstrategie voor Gezondheid en Vitaliteit: kansen voor de toekomst’. Vragen/inhoud In dit webinar gaan we in op de volgende vragen: Waarom is de verschuiving van ‘kosten naar baten’ zo belangrijk?Wat zijn kansrijke ontwikkelingen voor gezondheid […]

Koud winterweer in aantocht, meerderheid vrouwen denkt dat cranberrysap helpt tegen blaasontsteking
februari 5, 2021
Vier op de vijf vrouwen denken dat cranberrysap helpt tegen een blaasontsteking. Maar net als vitamine C en een katoenen onderbroek doet cranberrysap niets tegen de vrouwenkwaal. Komende week zakt de temperatuur tot ruim onder het vriespunt. Vrouwen hoeven zich echter geen zorgen te maken; een blaasontsteking wordt niet veroorzaakt door ‘kou onder de rok’. […]

Hoe dan? Taal en Gezondheid
februari 5, 2021
Het Kennisplatform Gelderland Geletterd organiseert in samenwerking met Alles is Gezondheid de digitale themabijeenkomst Hoe dan? Taal en Gezondheid. Programma Maurice de Greef (hoogleraar Leereffecten laagopgeleiden & laaggeletterden) en Machteld Huber (grondlegger van het gedachtengoed Positieve Gezondheid) nemen ons mee in de wereld van laaggeletterdheid en Positieve Gezondheid. Na hun inleidingen is het tijd voor […]

Webinar 18 februari over sociale basisinfrastructuren
februari 5, 2021
Op donderdagmiddag 18 februari 2021 organiseert Alles is Gezondheid met Dialoog Gemeenschapskracht een webinar over de bouwstenen van een Sociale Basisinfrastructuur in de wijk. De praktijk staat centraal. Cases uit Utrecht en Deventer laten zien hoe wijkbewoners met professionals constructief samenwerken aan gezonde gemeenschappen. Stap voor stap en met aandacht voor (alternatieve) financiering. Voor wie Bewoners- […]

Erasmus MC, Laurens en Rijndam Revalidatie ontwikkelen centrum voor revalidatiezorg
februari 5, 2021
Erasmus MC, Laurens en Rijndam Revalidatie ontwikkelen een centrum voor revalidatiezorg waarin de patiënt op één locatie de juiste revalidatiezorg krijgt. De instellingen hebben 5 februari een intentieovereenkomst getekend om de plannen hiervoor verder te ontwikkelen. De eigen identiteit en zelfstandigheid van de instellingen blijft gehandhaafd. Het centrum opent naar verwachting in 2026 zijn deuren […]

Foodwatch lanceert offensief voor gezonde voeding, nieuwe regering kan wettelijke maatregelen niet langer ontlopen
februari 5, 2021
Voedselwaakhond foodwatch eist samen met haar consumentenachterban dat politieke partijen, bij het vormen van een nieuwe regering, een gezondere voedselomgeving via wettelijke en financiële maatregelen afdwingen. Onder deze maatregelen vallen onder meer een suikertaks en een totaalverbod op ongezonde kindermarketing. Bezorgde consumenten schrijven de politieke partijen rechtstreeks aan via de e-mailactie ‘Offensief voor onze gezondheid’. Nieuw gepubliceerde […]

Wetenschapsagenda Amsterdam UMC 2-5 maart
februari 3, 2021
Hierbij een overzicht van de promoties van Amsterdam UMC in de periode 2 – 5 maart 2021 Dinsdag 2 februari 2021Promotie (UvA), 15.00 uur, online Juliette van Baal: Eierstokkanker is niet één ziekte Onderkenning van verschillende subtypen eierstokkanker is cruciaal voor het uitvoeren van wetenschappelijk onderzoek en de keuze van behandeling. Uit studies van Van Baal blijkt dat […]

Luisterpuntbibliotheek lanceert luisterboeken van #LikeMe voor kinderen met een leesbeperking
februari 1, 2021
Brussel – De muzikale Ketnet-serie #LikeMe is razend populair. De avonturen van Caro en haar vrienden verschenen eerder al in boekvorm, maar Luisterpuntbibliotheek biedt nu luisterversies van de boeken aan. Zo kunnen ook kinderen met een leesbeperking – zoals een fysieke beperking of dyslexie – genieten van de verhalen. De cast van #LikeMe las de […]

Waar ben ik? Naamloze fietspaden langs A16 krijgen een naam
februari 1, 2021
Samen met de heer Pijpker van de Fietsersbond onthulde wethouder Bokhove vandaag de naam van twee fietspaden die langs rijksweg A16 lopen. Aan de Beverwaardse zijde werd de naam Roelantpad zichtbaar toen de wethouder het doek van het naambordje haalde. De Fietsersbond Rotterdam selecteerde samen met de gemeente een aantal fietspaden die voor de navigatie […]

Rotterdam investeert ruim 93 miljoen in nieuwe gymzalen
januari 29, 2021
De gemeente Rotterdam investeert de komende vier jaar ruim 93 miljoen euro in de bouw van 55 nieuwe gymzalen voor basisscholen en middelbare scholen. Dat draagt bij aan goed bewegingsonderwijs voor Rotterdamse leerlingen. De gymzalen zijn nodig als uitbreiding en ter vervanging van oude gymzalen. Die voldoen niet meer aan de eisen van nu en […]

Behandeling van terugval bij MS kan voortaan thuis
januari 29, 2021
Bijna alle Multiple Sclerose (MS)-patiënten met een terugval in het ziekteproces, kunnen voortaan thuis worden behandeld. Zij hoeven daarvoor niet meer naar het ziekenhuis te komen, omdat het medicijn methylprednisolon nu ook in capsulevorm beschikbaar is. De meeste mensen met MS hebben een zogenoemd relapsing remitting ziektebeloop waarbij een terugval (ook wel relapse of schub genoemd) wordt […]

Tweede medicatiecontrole in het Maasstad Ziekenhuis door medicatieveiligheidssysteem
januari 29, 2021
Het Maasstad Ziekenhuis zet een medicatieveiligheidssysteem in voor het dubbelchecken van de medicatie voor patiënten. De eerste medicatiecontrole wordt door de verpleegkundige gedaan, daarna controleert het medicatieveiligheidssysteem MedEye of de juiste medicatie aan de juiste patiënt gegeven wordt. Een innovatieve manier om de medicatieveiligheid in het ziekenhuis te vergroten. Normaal wordt de tweede controle uitgevoerd […]

Burgemeester Aboutaleb presenteert plan 1000 klimaatbestendige steden aan wereldleiders
januari 27, 2021
Tijdens de Climate Adaptation Summit 2021 (CAS 2021) presenteerde burgemeester Aboutaleb het tienjaren-programma ‘1000 Cities Adapt Now’ aan wereldleiders waaronder staatshoofden Angela Merkel en Mark Rutte, Ban Ki-moon van de Global Commission on Adaptation en António Guterres, secretaris-generaal van de VN. Namens de samenwerkingspartners bood hij deze Joint Statement om klimaatadaptatie in steden wereldwijd te […]

Hersenactiviteit voorspelt effect antidepressiva
januari 27, 2021
Met het meten van de hersenactiviteit met EEG kan een psychiater beter antidepressiva voorschrijven dan op de traditionele manier van observatie en het voeren van een gesprek. Onderzoekers van Amsterdam UMC laten zien dat voorschrijven op basis van de nieuwe methode de respons op medicijnen verbetert en dat het aantal personen bijna verdubbelt bij wie […]

Wetenschapsagenda
januari 25, 2021
Hierbij een overzicht van de promoties van Amsterdam UMC in de periode 25-29 januari Maandag 25 januari 2021Promotie (VU), 11.45 uur, onlineVicky de Boer: Doelgerichte behandeling om hoofd-halskanker te voorkomen Tumoren in het hoofd-halsgebied ontstaan in het slijmvlies van mond en keel. Deze tumoren ontstaan bij het ouder worden, door roken, alcoholgebruik, maar ook door […]

ETZ start proef met meten van vitale waardes op afstand, met slimme pleister coronapatiënt continu monitoren
januari 25, 2021
Het ETZ (Elisabeth-TweeSteden Ziekenhuis) in Tilburg is gestart met het gebruik van slimme pleisters, waarmee op afstand de hartslag, ademhalingsfrequentie en temperatuur van coronapatiënten gemeten worden. Patiënten die met corona op de verpleegafdeling liggen, krijgen sinds kort een slimme pleister met sensoren opgeplakt van de verpleegkundige. “Deze pleister meet continu de ademhalingsfrequentie, temperatuur en hartslag […]

Uitkomsten pilot: OrCam MyEye helpt slechtzienden bij het zelfstandig uitvoeren van werkzaamheden
januari 22, 2021
Door het gebruik van de OrCam MyEye kunnen sommige visueel beperkten aan het werk in een reguliere baan.Meer banen geschikt voor mensen met een visuele beperking bij gebruik van de OrCam MyEye.Het gebruik van de OrCam MyEye heeft een doorslaggevende rol gehad in het opwaarderen van het dienstverband van Monique tot een vaste aanstelling en […]

Glaucoom in Beeld
januari 22, 2021
Waar staan we nu? U herinnert zich vast nog wel het benefietevenement voor Glaucoom in Beeld, dat bijna twee jaar geleden werd georganiseerd in het Louwman Museum en dat € 100.000 opbracht. De teller van de fundraisingacties kwam daarmee boven de €500.000 uit. Particulieren en bedrijven hebben toen ruimhartig gedoneerd. Gastheer Evert Louwman gaf tijdens […]

ETZ start knie- en heupoperaties weer op
januari 22, 2021
Patiënten die een nieuwe knie of heup nodig hebben, worden sinds kort weer geopereerd in het ETZ (Elisabeth-TweeSteden Ziekenhuis) in Tilburg. Na hun operatie verlaten ze het ziekenhuis en revalideren ze in behandelcentrum De Wever | De Hazelaar. “Een mooi voorbeeld van een ziekenhuis zonder muren.” Patiënten die een nieuwe knie of heup nodig hebben […]

Sociale basisinfrastructuur: voor vitale en gezonde gemeenschappen – Webinar
januari 20, 2021
Alles is Gezondheid organiseert samen met Dialoog Gemeenschapskracht een webinar (18-2-2021) over het ‘#hoedan’ van een Sociale Basisinfrastructuur in de wijk. De praktijk staat centraal. Cases uit Utrecht en Deventer laten zien hoe wijkbewoners met professionals stapsgewijs samenwerken aan gezonde gemeenschappen. Aanmelden kan hier Datum: 20 januari 2021Bronnen: Alles is gezondheid, Dialoog gemeenschapskracht

Healthy Funding IV – Matchmaking event
januari 20, 2021
Heb jij een Life Sciences & Health start-up of scale up en wil je verder groeien en/of opschalen? Tijdens Healthy Funding IV gaan we jonge, ambitieuze bedrijven met een investeringsbehoefte 1 op 1 matchen aan relevante investeerders en fondsen. Healthy Funding IV staat deze keer dan ook in het teken van Matchmaking en de focus ligt […]

Rotterdamse digitale eHealth safari
januari 20, 2021
Tijdens de maand van de Slimme Zorg Estafette nodigen wij u met veel plezier uit voor de Rotterdamse Digitale eHealth Safari, Ontbijt SPECIAL op donderdag 11 februari 2021. Rotterdam heeft meer dan 4 miljoen euro aan subsidies uit SET, PreSET, Covid-19 SET en de DigiDeal010 ontvangen. Hoe en waar wordt dit geld besteed? En hoe zorgen we ervoor dat we geen dingen […]

Digitaal Congrestival
januari 20, 2021
Ook de Rotterdamse burger wordt steeds ouder en wijzer. Dat vraagt om een duurzame investering. De gemeente Rotterdam heeft, samen met partners, alles in de steigers staan om mee te groeien met de vergrijzing. Vanuit het programma Ouder & Wijzer werken we bijna twee jaar intensief samen met heel veel partners in de stad. Ondanks […]

Maasstad Ziekenhuis opent nieuwe dialyselocatie in Hellevoetsluis
januari 18, 2021
Het Dialysecentrum van het Maasstad Ziekenhuis opent een derde locatie in de Polikliniek Het Nieuwe Weergors. De locatie Hellevoetsluis heeft twee dialyseplaatsen, waar per week acht patiënten in de regio Hellevoetsluis gebruik van kunnen maken, zodat ze dichter bij huis veilig kunnen dialyseren. In de nieuwe dialyselocatie kunnen patiënten dialyseren die in de overgang zitten […]

Polikliniek Kralingen ontvangt de eerste patiënten Zelfde artsen, nieuwe plek: Oudedijk
januari 18, 2021
15 januari 2021 zijn de eerste patiënten met een bos bloemen verwelkomd op de nieuwe polikliniek van het IJsselland Ziekenhuis in Rotterdam Kralingen. De polikliniek is gevestigd in het verpleeghuis en revalidatiecentrum Pniël van Lelie zorggroep aan de Oudedijk. Ook de medewerkers kregen op hun nieuwe werkplek een warm welkom en een traktatie van Albert […]

Wetenschapagenda Amsterdam UMC 18-22 januari
januari 18, 2021
Hierbij een overzicht van de promoties van Amsterdam UMC in de week van 18 tot 22 januari 2021 Dinsdag 19 januari 2021Promotie (UvA), 15.00 u, onlineJacqueline Oliwa: De verborgen tbc-epidemie ontmaskeren Er is dringend behoefte aan meer kennis over tuberculose (TB) bij kinderen in Kenia. Ook is meer duidelijkheid nodig over welke kinderen tbc kunnen hebben en […]

Erik Gerritsen (VWS): “Alles draait om voldoende beweging, gezonde voeding en dat wat er in je hoofd omgaat”
januari 15, 2021
Secretaris-Generaal Erik Gerritsen blijft tijdens corona fit met BioCheck Erik Gerritsen, Secretaris-Generaal van het ministerie van Volksgezondheid, Welzijn en Sport (VWS), is ondanks zijn drukke baan altijd bezig met nieuwe manieren om gezond en fit te blijven. Tijdens de eerste golf van de coronapandemie is hij gestart met het BioCheck e-Health programma, waarbij hij dagelijks […]

Het gemak van corona-proof brilmetingen
januari 15, 2021
Angela: “Cliënten vinden de brilmeting aan huis nieuw en leuk” Angela en Nadine werken als persoonlijk begeleider voor een seniorengroep bij zorginstelling Sherpa in de regio Eemland. Ze begeleiden hun cliënten bij allerlei activiteiten in het dagelijks leven, zoals koken, eten, schoonmaken en persoonlijke verzorging. Leni, Henk en Frits, drie cliënten uit de zorggroep, hadden […]

Wetenschapsagenda Amsterdam UMC 11-15 januari
januari 15, 2021
Hierbij een overzicht van de promoties van Amsterdam UMC in de week van 11 tot 15 januari. Maandag 11 januari 2021Promotie (UvA), 14.00 u, onlineGuido Mazzinari: Verbeteren van zorg bij operaties met narcose Perioperatieve geneeskunde richt zich op de zorg aan patiënten vóór, tijdens en na een operatie onder narcose. Binnen dit vakgebied gaat veel aandacht […]

Catharina Ziekenhuis neemt tweede PET-CT scanner in gebruik
januari 15, 2021
Eindhoven, 14 januari 2021 | Het Catharina Ziekenhuis heeft opnieuw een belangrijke stap gezet in de behandeling voor patiënten met kanker en hartaandoeningen. Het ziekenhuis heeft een tweede hypermoderne PET-CT scanner van Siemens in gebruik genomen. “In ons ziekenhuis behandelen we een groot aantal kanker- en hart- en vaatpatiënten. Daardoor zien we de vraag naar […]

Koninklijke Visio biedt gratis e-learning voor begeleiding van slechtziende mensen bij creatieve activiteiten
januari 13, 2021
Landelijk, 13 januari 2021 Een kunstdocent of activiteitenbegeleider overkomt het soms. Daar staat opeens iemand met een visuele beperking bij de cursus om mee te doen. Natuurlijk wil iedereen deze persoon graag helpen maar hoe pak je dat het beste aan? Koninklijke Visio biedt een gratis e-learning onder de naam Creatief Beeldend (z)onder de loep. […]

Slechtziende topskiester Maaike Bennink gaat voor goud
januari 11, 2021
De 42-jarige Maaike Bennink uit Den Bosch is 14 jaar geleden binnen één dag slechtziend geworden door een ontsteking aan twee oogzenuwen. Haar wereld stond op zijn kop, ze moest haar beroep als verpleegkundige opgeven en kon niet meer sporten zoals vroeger. Nu is zij de eerste Nederlandse slechtziende (2% zicht) internationale slalom skiester met Paralympische ambitie. Dat doet ze met […]

Slechtziende Yves (11) uit Hellevoetsluis kan lezen dankzij stervoetballer Lionel Messi
januari 11, 2021
De 11-jarige Yves uit Hellevoetsluis heeft voor zijn geboorte een herseninfarct gekregen. Hierdoor is hij slechtziend en aan één kant verlamd geboren. Zijn vermogen om te lezen is ernstig beperkt, maar door een apparaatje van OrCam, een bedrijf waar niemand minder dan stervoetballer Lionel Messi ambassadeur van is, kan hij nu helemaal zelfstandig zijn schoolboeken […]

Het Oogziekenhuis Rotterdam opent Optometristencentrum
januari 11, 2021
Rotterdam, 7 januari 2021 – Vandaag heeft Het Oogziekenhuis Rotterdam met trots een Optometristencentrum geopend aan het Haringvliet 72 in Rotterdam. Oogheelkundige patiënten die de specialistische zorg van de oogarts niet meer nodig hebben, worden voortaan door een gespecialiseerde optometrist in dit centrum gezien. Hierdoor zijn deze patiënten gegarandeerd van efficiënte, kwalitatief goede zorg op […]

Nudging’ in mobiele app helpt consument mogelijk bij gezondere keuzes
januari 8, 2021
Eerste resultaat samenwerking Nakko en Tilburg University Nakko en Tilburg University zijn een samenwerking aangegaan voor onderzoek naar klantkeuzes in het aankoopproces. De eerste inmiddels afgeronde onderzoeken richtten zich op de vraag of de consument voor en tijdens het boodschappen doen gestimuleerd kan worden om gezondere keuzes te maken. Lees meer Bronnen: Nakko University, Tilburg […]

Maasstad Ziekenhuis vaccineert eerste IC-verpleegkundigen
januari 8, 2021
Het Maasstad Ziekenhuis is vanochtend gestart met de vaccinatie van de verpleegkundigen van de Intensive Care (IC) afdeling met het corona-vaccin van Pfizer/BioNTech. De komende dagen worden ongeveer 500 medewerkers gevaccineerd bij wie uitval direct leidt tot verlies aan capaciteit van coronazorg, zoals IC-verpleegkundigen. Daarnaast vaccineert het ziekenhuis ook zo’n 200 zorgmedewerkers van hulpdiensten die […]

Nieuwe geavanceerde fitnessapparatuur bij Rijndam
januari 8, 2021
De locatie Westersingel van Rijndam beschikt sinds december over een geheel vernieuwde fitnessruimte. De oude apparatuur is vervangen voor de nieuwste fitnessapparatuur van Technogym: een slim systeem dat zich aanpast aan het energieniveau van de revalidatiepatiënten. Via cloud-opslag kunnen de gegevens met een app worden ingezien. De sportruimte is volledig aangepast en opgeknapt zodat de […]

Franciscus onderzoek toont relatie grote buikomtrek en ongunstig beloop bij Covid-19
januari 8, 2021
Niet iedereen met overgewicht loopt extra risico bij een besmetting met Covid-19. Vooral een grote buikomtrek is riskant. Minder belangrijk is vet rond de heupen. Dat blijkt uit recent onderzoek in Franciscus Gasthuis & Vlietland. Dat is een extra motivatie om in het nieuwe jaar af te vallen. ´De plaats waar het vet zit is […]

Wetenschappelijk onderzoek Cariben krijgt impuls van ruim 7 miljoen euro
januari 8, 2021
Minister van Engelshoven van Onderwijs, Cultuur en Wetenschap maakte tijdens het Ministeriële Vierlandenoverleg Onderwijs, Cultuur en Wetenschap bekend dat er ruim 7 miljoen euro is toegekend aan twee projecten binnen het NWO programma Caribisch Onderzoek. De nadruk binnen deze financieringsronde ligt op structuurversterking van het kennissysteem en inbedding van wetenschappelijk onderzoek in het Caribische gedeelte […]

Braillepluim 2021 gaat naar wandelroute op de Veluwe
januari 4, 2021
Staatsbosbeheer krijgt de braillepluim 2021. Dat maakte Vereniging Onbeperkt Lezen bekend op 4 januari. Staatsbosbeheer maakte samen met Dedicon een wandelroute voor blinden en slechtzienden rond de schaapskooi te Hoog Buurlo op de Veluwe. Vereniging Onbeperkt Lezen vindt daarom dat Staatsbosbeheer de braillepluim verdient. De wandelroute in de omgeving van Apeldoorn is een van de […]

Gentherapie voor zeldzame oogziekte vergoed
december 28, 2020
Patiënten met een specifieke erfelijke netvliesaandoening kunnen volgend jaar behandeld worden met gentherapie. Dit heeft minister Van Ark van Medische Zorg eind december besloten na prijsonderhandelingen. Het Oogziekenhuis in Rotterdam, Amsterdam UMC en Radboudumc mogen deze nieuwe behandeling gaan uitvoeren. Het is de eerste keer in Nederland dat gentherapie wordt vergoed. De therapie is bedoeld […]

Healthy Funding IV event
december 28, 2020
Op donderdag 4 februari aanstaande vindt Healthy Funding IV plaats – de vierde in een reeks succesvolle events gehost door Life Sciences & Health 010 – het LSH cluster van de gemeente Rotterdam. Healthy Funding IV staat deze keer in het teken van Matchmaking (met inderdaad een hoofdletter M) en de focus ligt op het […]

Werkbezoek Tamara van Ark, minister voor Medische zorg en Sport aan IJsselland Ziekenhuis en Rode Kruis
december 23, 2020
Donderdag 19 december jl. bracht Tamara van Ark, minister voor Medische Zorg en Sport van het Ministerie van VWS, een kort werkbezoek aan het IJsselland Ziekenhuis. Tijdens haar bezoek heeft ze meegelopen op de COVID verpleegafdeling en buiten bij de hoofdingang gesproken met vrijwilligers van het Rode Kruis. Minister van Ark verbleef circa een uur […]

Wegwerp cystoscoop biedt veel voordelen Nederlandse primeur voor urologen ETZ
december 23, 2020
De urologen van het ETZ (Elisabeth-TweeSteden Ziekenhuis) in Tilburg zetten voortaan flexibele cystoscopen in die direct na eenmalig gebruik worden weggegooid. In plaats van te worden gereinigd. Een primeur voor Nederland. “Het inwendig onderzoek met deze moderne cystoscopen is minder vervelend voor de patiënt.” Een cystoscoop is een dunne, holle buis met verlichting en een lens […]

Nieuwe tussenvoorzieningen en een Rotterdams ouderenpakket, een duurzame investering in de Rotterdamse ouderenzorg
december 23, 2020
Over tien jaar telt Nederland ruim twee miljoen mensen van 75 jaar en ouder. Ook Rotterdam wordt steeds ouder. Dat vraagt om een duurzame investering ín de ouderenzorg. De gemeente Rotterdam heeft alles in de steigers staan om mee te groeien met de vergrijzing. De stad investeert in nieuwe tussenvoorzieningen zodat Rotterdamse ouderen langer zelfstandig […]

Rotterdam start campagne tegen rookoverlast, Wat loop je nou te stoken?!
december 21, 2020
Op maandag 21 december start de campagne “Wat loop je nou te stoken?!”. Met deze campagne wil de gemeente Rotterdammers bewust maken van de effecten die houtkachels, open haarden en vuurkorven hebben op de luchtkwaliteit en gezondheid. In humoristische filmpjes geeft de campagne tips over verantwoord stoken en het voorkomen van overlast. Houtrook is vooral […]

Een twee- of driejarige die veel beweegt en gezond eet, heeft een grote kans dat later als volwassene ook te doen. Want juist bij peuters zijn smaakvoorkeur en motoriek volop in ontwikkeling. De aanpak SuperFIT stimuleert daarom gezonde gewoontes op het peuterdagverblijf én thuis.
december 18, 2020
Een woensdagochtend in november 9 uur, het is een gezellige boel bij peuteropvang Ieniemienie in Sittard. De klas is in herfstsferen. Een slinger van blaadjes aan een staalblauwe muur, bij de poppenhoek een parasol als een reuzevliegenzwam: rood met witte stippen. De ouders zijn weer uitgezwaaid, pakweg twaalf peuters kruipen over de grond met blokken, […]

Rotterdam krijgt steeds meer groen, 10 van de 20 hectare extra groen bereikt
december 18, 2020
Rotterdam krijgt steeds meer groen; de afgelopen twee jaar is hier hard aan gewerkt. Het doel is 20 hectare extra groen in de periode 2018-2022. Op dit moment staat de teller op 10,8 hectare, dit staat gelijk aan ruim 20 voetbalvelden. De komende periode gaat de vergroening door. De hectares zijn te vinden op daken […]

Betere overleving hartstilstand als ook brandweer, politie en burgerhulpverleners reanimeren
december 16, 2020
De kans een hartstilstand buiten het ziekenhuis te overleven, stijgt met bijna een factor drie als ook brandweer, politie of burgerhulpverleners (de First Responders), na een oproep van de alarmcentrale, gaan reanimeren. Dit meldt Amsterdam UMC in een studie die vandaag in The Lancet Regional Health Europe verschijnt. In Nederland is de hulp aan mensen die een […]

Kenniscoalitie: stabiele groei investeringen in onderzoek en innovatie noodzakelijk 3% BBP voor onderzoek en innovatie in 2030 haalbaar
december 14, 2020
Voor de komende tien jaar stelt de Kenniscoalitie aan het kabinet voor om de investeringen in onderzoek en innovatie jaarlijks te laten groeien met 300 tot 380 miljoen euro. Dit stabiele groeipad is noodzakelijk om in Europa bij te blijven als competitieve kenniseconomie. Landen als Denemarken en Duitsland investeren al jaren fors meer dan Nederland. […]

Noord-Hollandse ziekenhuizen starten digitale beeldenuitwisseling
december 14, 2020
Noord-Hollandse ziekenhuizen starten met digitale beeldenuitwisseling. Noordwest Ziekenhuisgroep wisselt uit met Amsterdam UMC en het Antoni van Leeuwenhoek. Zorgverleners in deze ziekenhuizen hebben nu direct inzage in de medische beeldvorming én beeldverslagen van hun patiënten bij behandeling in de andere ziekenhuizen. Dit draagt bij aan snelle en veilige patiëntenzorg. Snelle en veilige patiëntenzorg Het uitwisselen […]

Bespreek inleiding bij 41 weken met vrouwen die hun eerste kind krijgen
december 9, 2020
Het beleid in Nederland is om bij een normaal verlopende zwangerschap de baring bij 42 weken in te leiden. Bij een eerste kind zijn er nieuwe aanwijzingen om te overwegen dit bij 41 weken te doen. Dit blijkt uit onderzoek van de afdeling Verloskunde van Amsterdam UMC in samenwerking met Radboudumc en het Zweedse Sahlgrenska […]

Erasmus MC Foundation – Daniel den Hoed Fonds start publiekscampagne: Laat kankeronderzoek niet lijden onder corona
december 9, 2020
Het Daniel den Hoed Fonds start deze week met de campagne: We moeten doorgaan! Laat kankeronderzoek niet lijden onder corona. Met deze campagne, die wordt gesteund door burgemeester Ahmed Aboutaleb en bestuursvoorzitter Ernst Kuipers van het Erasmus MC, wil het fonds iedereen oproepen om kankeronderzoek in het Erasmus MC te steunen. Jaarlijks organiseert de Erasmus […]

Internationaal kwaliteitskeurmerk voor ziekenhuis Kwaliteit en veiligheid patiëntenzorg ETZ op orde
december 7, 2020
Het ETZ (Elisabeth-TweeSteden Ziekenhuis) laat op vaste tijden de kwaliteit en veiligheid van de in Tilburg en Waalwijk geboden patiëntenzorg controleren. Dat is onlangs weer gedaan door het externe bureau Qualicor Europe (voorheen NIAZ). Uitkomst van de toets is dat het ETZ voldoet aan alle internationale kwaliteitseisen. In november werd het ETZ bezocht door externe […]

Altijd en overal Elektronische boeken lezen
december 4, 2020
Uitbreiding collectie voor kinderen met een visuele beperking met 450 Elektronische boeken. Den Haag, 17 november 2020.- Kinderen met een visuele beperking kunnen vanaf nu ook Elektronische boeken via Bibliotheekservice Passend Lezen lenen dankzij een samenwerking en met financiële steun van de Koninklijke Bibliotheek, het Bartiméus Fonds en Fonds XL. Elektronische boeken zijn digitale tekstboeken, […]

Stuur een lichtpuntje aan patiënten in het Groene Hart Ziekenhuis
december 3, 2020
De feestdagen doorbrengen in het ziekenhuis is nooit fijn, maar in deze bijzondere tijden is het extra pittig. Niet alleen voor patiënten, maar voor ons allemaal geldt dat we minder bezoek mogen ontvangen en dat we de kerstdagen waarschijnlijk niet met de hele familie kunnen doorbrengen. Daarom is St. Vrienden van het Groene Hart Ziekenhuis […]

ETZ en zorgverzekeraar CZ vormen ‘Duurzame Coalitie’
december 3, 2020
Het Elisabeth-TweeSteden Ziekenhuis (ETZ) en zorgverzekeraar CZ vormen samen een zogenoemde ‘Duurzame Coalitie’. Dat is in een overeenkomst vastgelegd, waarbij is afgesproken dat de samenwerking de komende vijf jaar wordt geïntensiveerd. Belangrijke basis is het bieden van ‘de juiste zorg op de juiste plek’. Waarbij beide partijen hetzelfde willen: goede zorg voor patiënten. De coronacrisis […]

Cliëntenraad Noordwest Ziekenhuisgroep organiseert webinar over artrose
december 1, 2020
Wilt u meer weten over artrose? De cliëntenraad van Noordwest Ziekenhuisgroep organiseert op donderdagavond 10 december een webinar voor de inwoners van Noord-Holland Noord over artrose. De orthopeden van het Noordwest Orthopedisch Centrum informeren u over:– wat artrose is en hoe je het herkent;– wat je er (preventief) zelf tegen kunt doen;– wat de verschillende behandelmethoden nu […]

Vervroegd ontslag coronapatiënten uit Noordwest Ziekenhuisgroep
december 1, 2020
Noordwest Ziekenhuisgroep heeft in korte tijd samen met huisartsen en thuiszorgorganisaties de zorg thuis voor COVID-patiënten vormgegeven. Door deze samenwerking kunnen stabiele COVID-patiënten die herstellende zijn, maar nog wel afhankelijk zijn van zuurstof, voortaan enkele dagen eerder naar huis dan tot nu toe gemiddeld mogelijk was. Zorg in thuisomgeving Patiënten die aan de beterende hand […]

Bevallen in het bad van Geboortehuis Maas
december 1, 2020
Het is een wens van veel zwangere vrouwen: bevallen in bad. Die wens kan nu in vervulling gaan in Geboortehuis Maas, want op de afdeling Verloskunde van het Maasstad Ziekenhuis staat sinds kort een opblaasbaar bad klaar voor poliklinische bevallingen. “Wij zijn heel blij en trots dat we nu badbevallingen kunnen aanbieden”, zegt Josine van […]

Catharina Ziekenhuis neemt gecombineerde sneltest in gebruik
december 1, 2020
Eindhoven, 01 december 2020 – Op de Spoedeisende Hulp van het Catharina Ziekenhuis krijgt iedereen die met coronasymptomen wordt opgenomen in het ziekenhuis vanaf deze week een snelle PCR-test die in twintig minuten duidelijkheid geeft over drie virussen: het coronavirus en Influenza A en B; de twee virussen die de griep veroorzaken. De monsters van […]

NWO komt met nieuw financieringsinstrument om Open Science te stimuleren
december 1, 2020
‘Open Science Fund’ volgende stap in erkennen en waarderen Den Haag, 1 december De Nederlandse Organisatie voor Wetenschappelijk Onderzoek (NWO) lanceert het ‘Open Science Fund’, een nieuw financieringsinstrument dat bedoeld is om Open Science een impuls te geven. Via het programma kunnen projecten financieel worden ondersteund op het brede terrein van Open Science, bijvoorbeeld projecten […]

Verdraaide darm? Minder operaties door verbeterde scantechniek
november 26, 2020
Eindhoven, 26 november 2020 – Het Catharina Ziekenhuis in Eindhoven is erin geslaagd om obesitaspatiënten die als gevolg van een bypass-operatie onverklaarbare buikpijn krijgen, sneller en beter te diagnosticeren. Na een maagverkleining komt ongeveer 13 procent van de geopereerde patiënten op de eerste hulp of op de polikliniek met klachten die lijken op een verdraaiing […]

Percentage corona-antistoffen gelijk bij grootste bevolkingsgroepen in Amsterdam
november 20, 2020
Amsterdammers met een Turkse, Marokkaanse of Surinaamse afkomst hebben vrijwel net zo vaak covid-19 antistoffen in het bloed als Amsterdammers van Nederlandse komaf. Alleen bij de -kleinere- groep Ghanezen ligt dit percentage hoger. Dat zegt Karien Stronks, hoogleraar public health van Amsterdam UMC. Zij leidt samen met hoogleraren Maria Prins en Charles Agyemang het onderzoek […]

Promoties Amsterdam UMC 20 november
november 18, 2020
Vrijdag 20 novemberPromotie (VU), Aula, 13.45 uurRenske Bosman: Langetermijnmonitoring van gebruikers van antidepressiva In Nederland krijgt één op de vijf volwassenen een angststoornis. Mensen hebben vaak langdurig klachten. De effecten van behandeling (CGT, antidepressiva) houden bij sommige patiënten niet lang aan, terwijl je dat wel zou willen. Bosman onderzocht de langetermijnprognose van angststoornissen. Ze laat […]

Promoties Amsterdam UMC 19 november
november 18, 2020
Donderdag 19 novemberPromotie (UvA), 10.00 uur, AgnietenkapelMalon van den Hof: Wat hiv doet met de hersenen van kinderen Als kinderen in Nederland met een aangeboren hiv-infectie langdurig worden behandeld met effectieve medicijnen, verloopt hun hersenontwikkeling in de puberteit grotendeels normaal, zowel wat betreft de structuur als de functie. Desondanks blijven er verschillen met de hersenen […]

Promotie Amsterdam UMC 18 november
november 18, 2020
Woensdag 18 novemberPromotie (UvA), 10.00 uur, AgnietenkapelJeroen de Groof: Slokdarmkanker nog eerder ontdekken Een Barrett slokdarm is een aandoening waarbij de binnenbekleding van het onderste deel van de slokdarm beschadigd raakt door terugstromend maagzuur. Hierdoor verandert het slijmvlies van de slokdarmwand. Patiënten met een Barrett slokdarm hebben een verhoogd risico op het ontwikkelen van slokdarmkanker. […]

Promoties Amsterdam UMC 17 November
november 18, 2020
Dinsdag 17 novemberPromotie (VU), 9.45 uur (online bijeenkomst)Ilse Louwerse: Beslismodel kan verzekeringsartsen helpen Mensen die werken hebben meestal een betere gezondheid, zowel fysiek als psychisch, dan mensen zonder betaald werk. Wanneer iemand na langdurige ziekte weer voorzichtig aan het werk gaat, heeft dat vaak een positief effect op het ziekteverloop. Om een inschatting te kunnen […]

Promotie amsterdam UMC 16 November
november 18, 2020
Maandag 16 novemberPromotie (VU), Aula, 11.45 uurJudith Vloothuis-De Boone: Minder angst na beroerte door oefenen met een naaste Mensen met een beroerte herstellen beter als ze intensief oefenen. In het huidige revalidatieprogramma is dat lang niet altijd mogelijk, onder andere door een tekort aan zorgpersoneel. Onderzoekers van Amsterdam UMC en Reade hebben daarom het CARE4STROKE-programma […]

Wandelen en fietsen langs rivieren in Rotterdam populairder
november 17, 2020
omnibusenquête 2020 Steeds meer Rotterdammers ontdekken de rivieren in en om de stad. Bijna de helft van Rotterdammers recreëert langs de Rotte en ruim 1 op de 3 Rotterdammers bezoekt weleens de Nieuwe Maas. Dat blijkt uit de Omnibusenquête 2020. Vooral de Rotte is dit jaar weer populairder geworden onder de Rotterdammers. Het bezoek steeg […]

Coronavirus veroorzaakt schade aan ademspier bij ernstig zieken
november 17, 2020
Coronapatiënten hebben vaak last van benauwdheid en zuurstoftekort. Uit een studie van Amsterdam UMC, gepubliceerd in JAMA Internal Medicine, blijkt dat het coronavirus het middenrif, de belangrijkste ademspier, beschadigt. “We zagen bij zeer zieke COVID-19-patiënten een ontstekingsreactie en bindweefselvorming in de ademspier”, aldus fysioloog Coen Ottenheijm. De onderzoeksgroep vergeleek zesentwintig COVID-19-patiënten met tien NON-COVID-19-patiënten, allen waren […]

Patiënt minder snel naar ziekenhuis door digitaal consult
november 17, 2020
Huisartsen in de regio Midden-Brabant kunnen voortaan digitaal een medische vraag over een patiënt stellen aan de specialisten in het ETZ (Elisabeth-TweeSteden Ziekenhuis). Hierdoor hoeven minder patiënten naar het ziekenhuis en krijgen ze toch de juiste behandeling. Het Digitaal Advies Consult (DAC) biedt de ongeveer 160 bij RCH aangesloten huisartsenpraktijken in de regio de mogelijkheid […]

Nominaties Gouden Windei 2020 bekend: Appelsientje, Be-Kind, Nutella, Philadelphia & Zonnatura
november 17, 2020
Verkiezing voor meest misleidende voedings-product van het jaar gestart De publieksverkiezing van voedselwaakhond foodwatch voor het meest misleidende voedselproduct,? het Gouden Windei, is van start gegaan. De vijf genomineerde voedingsproducten van 2020 zijn, in willekeurige volgorde: Nutella Cups (Ferrero), Philadelphia truffel (Mondel?z), Zonnatura Groene thee Açai (Wessanen), ?Appelsientje Vers geperst sinaasappel (Riedel) en Be-Kind Protein (Mars).? Foodwatch maakt dit bekend in de uitzending van het tv-programma Kassa op zaterdag 14 november om 19.05 uur op NPO1. […]

Satelliet | Gezond Verkoopt webinar
november 13, 2020
Gezond eten en drinken is in trek. Zolang het maar aantrekkelijk gepresenteerd wordt. Binnen de Satelliet Gezond Verkoopt leren voedselaanbieders van elkaar én van experts hoe ze consumenten en bezoekers kunnen verleiden tot het maken van gezonde en verantwoorde keuzes. Door kennis te delen, maar vooral ook door samen doelen te stellen en te doen. […]

Kick-off – Satelliet | Mentaal Gezond webinar
november 13, 2020
Relatief veel Rotterdammers ervaren gevoelens van machteloosheid, onrust, depressie of angst. Bovendien gaan deze gevoelens vaak samen met problemen op verschillende levensgebieden, zoals geld, werk, opleiding of opvoeding en gezin. Geen enkele Rotterdammer hoeft langdurig uit te vallen of aan de kant te staan door mentale problemen. Binnen de Satelliet Mentaal Gezond delen we kennis […]

DigiDeal010 webinar
november 13, 2020
Op 1 december aanstaande gaat een nieuwe DigiDeal010-subsidieronde van start. Zorg- en welzijnsaanbieders met een contractrelatie met de gemeente in het kader van de wmo, welzijn of jeugdhulp kunnen inschrijven op de subsidie en zijn van harte uitgenodigd. De sessies vinden plaats op 18 november en 2 december. Tijdens de 2 sessies informeren wij u […]

Rotterdam eerste gaststad reizende expositie tegen huiselijk geweld
november 12, 2020
Vanaf 12 november tot en met 8 december 2020 is op het Kruisplein de reizende expositie Wij…Doorbreken de cirkel van geweld te zien. Deze bestaat uit een dertigtal portretten van mensen – waaronder Rotterdammers – die te maken kregen met o.a. huiselijk geweld, seksueel misbruik en kindermishandeling. Ze poseren samen met diegenen die hen het […]

BerkelBike maakt hard fietsen met verlamde benen mogelijk op Cybathlon
november 12, 2020
Paralympische sport en technologie vinden elkaar in de vierjaarlijkse Cybathlon: een evenement dat dit weekend zijn tweede editie beleeft. Dat wordt vanwege de corona-pandemie noodgedwongen een online editie. Eén van zes sporten die onderdeel uitmaakt van de Cybathlon 2020 Global Edition is FES-fietsen. Daarbij worden de verlamde beenspieren van door dwarslaesies getroffen sporters geactiveerd middels […]

OrCam Technologies onderdeel van Red Carpet TV Show 2020 Rotterdam Partners
november 10, 2020
Op 2 november hebben de gemeente Rotterdam en Rotterdam Partners de Red Carpet TV Show 2020 georganiseerd. De TV Show werd live uitgezonden vanuit Rotterdam. Tijdens deze uitzending kregen nieuwe internationale bedrijven een officieel welkom in Rotterdam. Hiernaast deelden verschillende internationale bedrijven en ondernemers uit de regio Rotterdam hun inspirerende innovaties met de wereld, waaronder […]

Pacemaker zonder tandenborstel in Catharina Ziekenhuis
november 10, 2020
Eindhoven, 10 november 2020 – Steeds meer hartpatiënten die een pacemaker of een ICD* krijgen in het Catharina Hart- en Vaatcentrum mogen dezelfde dag naar huis. Het gaat inmiddels om 60 procent van de patiënten. Uit cijfers van zorgverzekeraar VGZ blijkt dat in het Catharina Ziekenhuis veruit de meeste dagbehandelingen van Nederland plaatsvinden bij patiënten […]

GEZOND010 WEBINAR ‘EEN JAAR GEZOND010: HET AKKOORD’
november 5, 2020
In december 2019 hebben we gezamenlijk Gezond010: het akkoord ondertekend, omdat wij als partners van de stad het maken van gezonde keuzes makkelijker willen maken, gezond gedrag willen stimuleren en daarnaast willen bouwen aan een gezonde omgeving voor élke Rotterdammer! Deze ambities zijn de basis voor de verdere uitwerking en uitvoering van het akkoord voor […]

DIGIDEAL010 – GEZOND010
november 5, 2020
Afgelopen zomer is de Digideal010 door meer dan 70 partners uit de stad ondertekend. Op 1 december aanstaande gaat een nieuwe DigiDeal010-subsidieronde van start. Graag nodigen wij u als partner daarvoor uit. Om alle partners van de DigiDeal010 optimaal voor te bereiden op deze subsidieronde, organiseert de gemeente Rotterdam twee kennis- en inspiratiesessies. De sessies […]

eNose voorspelt overlevingskans ondervoede kinderen
november 5, 2020
Amsterdam, 5 november 2020De eNose (elektronische neus) kan de kans op overlijden van ernstig ondervoede kinderen vrij nauwkeurig voorspellen. Dat concluderen kinderartsen Wieger Voskuijl en Tim de Meij van Amsterdam UMC na onderzoek dat vandaag is gepubliceerd in Scientific Reports, het online tijdschrift van Nature Research. Volgens de artsen kan de eNose in de toekomst leiden tot […]

Mark Tuitert houdt thuiszitters fit tijdens corona
november 5, 2020
PERSBERICHT Mark Tuitert houdt thuiszitters fit tijdens corona AMSTERDAM, 5 NOVEMBER 2020 – Oud top-schaatser Mark Tuitert wil thuiszitters fit en gezond houden tijdens de tweede coronagolf. Samen met andere sporters zoals celeb trainer Carlos Lens en kickboxer Remy Bonjasky geeft hij online beweegsessies om mensen van hun zitvlees af te krijgen. De topsporters doen dit in […]

NWO-Veni van 250.000 euro voor 161 onderzoekers
november 5, 2020
NWO heeft 161 veelbelovende jonge wetenschappers een Veni-financiering van maximaal 250.000 euro toegekend. Hiermee kunnen de laureaten gedurende drie jaar hun eigen onderzoeksideeën verder ontwikkelen. De Veni-laureaten gaan onder andere onderzoek doen naar de impact van sociale netwerken op democratie, de ontwikkeling van een biosensor die bijdraagt aan het profileren van vingersporen en schonere waterstofproductie […]

NWO-Vidi van 800.000 euro voor 81 ervaren onderzoekers
november 4, 2020
De Nederlandse Organisatie voor Wetenschappelijk Onderzoek (NWO) heeft 81 ervaren onderzoekers een Vidi-financiering van 800.000 euro toegekend. Hiermee kunnen zij de komende vijf jaar een eigen, vernieuwende onderzoekslijn ontwikkelen en een onderzoeksgroep opzetten. De laureaten gaan met het geldbedrag onder andere onderzoeken welke computermodellen bijdragen aan een betere onderbouwing van beleidsbeslissingen voor klimaataanpassingen. De Vidi […]

FINANCIEEL RESULTAAT ONDER DRUK, WAARDERING PATIËNTEN EN CLIËNTEN STIJGT
november 4, 2020
Binnen alle deelsectoren van de zorg staan de marges van zorginstellingen onder druk. Ondanks een verslechtering van het resultaat is de waardering van cliënten blijvend hoog. De patiënttevredenheid laat zelfs in alle deelsectoren een stijging zien ten opzichte van het voorgaande jaar. Ook de solvabiliteit is voor alle deelsectoren de laatste jaren sterk verbeterd. Het […]

Nederlandse exoot op je bord
november 4, 2020
Stramproy, 2 november 2020. Vanaf vandaag is een echte Koningsoesterzwam uit eigen land in de supermarkt verkrijgbaar. Deze paddenstoel kennen we als geïmporteerde versie onder de naam Eryngii en is perfect als alternatief voor vlees in gerechten. De lokale teelt levert niet alleen een stevig, goed houdbaar en zeer smakelijk product, maar zorgt ook voor een […]
Promoties UvA 6 November
november 4, 2020
Vrijdag 6 novemberPromotie (UvA), 10.00 uur, AgnietenkapelFrancesca Aglialoro: De rijping van rode bloedcellen reguleren Transfusie van rode bloedcellen is de oudste en meest geavanceerde vorm van celtherapie. Ondanks dat bloedtransfusies inmiddels behoorlijk geavanceerd zijn, is een transfusie niet zonder risico’s zoals immuunreacties of het doorgeven van ziekten via het bloed. Het is daarom belangrijk om […]

Promoties UVA 5 November
november 4, 2020
Donderdag 5 novemberPromotie (UvA), 10.00 uur, AgnietenkapelFay Sanders: Platen en schroeven in voeten en enkels gewoon laten zitten Het standaard verwijderen van eerder ingebrachte implantaten (zoals platen en schroeven) uit voeten en enkels is niet altijd nodig. Dit voorkomt onnodige operaties en eventuele bijkomende complicaties. Dit concludeert Sanders in haar proefschrift over voet- en enkeloperaties […]

Promoties VU -UVA 4 November
november 4, 2020
Woensdag 4 november Promotie (VU), Aula, 9.45 uurRobbert Schouten: Angst en depressie klachten komen veel voor bij patiënten met nierziekten Patiënten met eindstadium nierfalen hebben vaak veel lichamelijke en psychische klachten. Zowel de nierziekte zelf als de intensieve dialyse zorgen voor een verminderde kwaliteit van leven, veel ziekenhuisopnames en hoge sterfte.Het onderzoek van Schouten laat zien […]

Promotie UVA 3 November
november 4, 2020
Dinsdag 3 novemberPromotie (UvA), 15.00 uur, online Majid Tarahomi: Beter kweekmedium voor menselijk embryoHet medium waarin een embryo wordt gekweekt voor terugplaatsing, beïnvloedt de ivf-behandeling en de gezondheid van het kind dat na die behandeling wordt geboren. Tarahomi heeft onderzocht of ivf effectiever en veiliger kan, door te kijken naar het medium (de stof) waarin […]

Promotie VU 2 November
november 4, 2020
Maandag 2 novemberPromotie (VU), Aula, 11.45 uurElisa de Koning: Effect vitamine D op ouderen De Koning onderzocht de relatie tussen vitamine D en het emotioneel en lichamelijk functioneren van ouderen. Depressieve klachten en verminderd lichamelijk functioneren komen vaak voor op oudere leeftijd. Daarnaast heeft ongeveer 50% van de ouderen een lage vitamine D-spiegel. Vitamine D […]

Zorg op afstand bij corona patiënten Maasstad Ziekenhuis succesvol
november 4, 2020
Het op afstand monitoren van patiënten die met COVID-19 in het Maasstad Ziekenhuis hebben gelegen is een succes. In totaal konden de afgelopen tijd meer dan 40 corona patiënten eerder naar huis, omdat hun gezondheid via een speciale app op afstand gecontroleerd kan worden. Met behulp van de app geven de patiënten vanuit huis dagelijks […]

Levensechte training met virtuele coronapatiënt voor verpleegkundigen van MMC
oktober 30, 2020
MMC biedt mixed reality-training om verpleegkundigen voor te bereiden op behandeling coronapatiënt Verpleegkundigen van Máxima MC (MMC) kunnen, dankzij een samenwerking met ASML, een realistische scenariotraining van een coronapatiënt volgen met behulp van mixed reality. Door het dragen van een speciale bril met HoloPatient-software lijkt de patiënt levensecht in de kamer van de verpleegkundige aanwezig […]

Onderzoek moet afbouw antidepressiva verbeteren
oktober 28, 2020
Hoe bouw je het gebruik van antidepressiva veilig af en zonder al te grote problemen? Dat is een vraag die veel patiënten en behandelaars bezighoudt. Met de subsidie van ZonMw van anderhalf miljoen euro gaan Amsterdam UMC en Radboudumc hiernaar onderzoek doen. Dit TAPER-AD onderzoek is wereldwijd de eerste grote studie die twee methodes van […]

Basisschool in Kleiwegkwartier stimuleert fietsen en lopen met verkeersexperiment
oktober 27, 2020
Rotterdam wil het verkeer rondom basisscholen in de stad veiliger maken en start maandag 26 oktober met een tweede experiment Veilige Schoolomgeving bij de Bergse Zonnebloem in het Kleiwegkwartier. De straat voor de school wordt tijdens haal- en brengmomenten tijdelijk afgesloten voor autoverkeer. Zo krijgen kinderen die naar school fietsen en lopen meer ruimte en […]

Adrz voert voorlopig minder geplande operaties uit
oktober 27, 2020
Vanaf dinsdag 27 oktober 2020 voert Adrz minder geplande operaties uit. Dit besluit is genomen op basis van regionale besluiten van het ROAZ (Regionaal Overleg Acute Zorgketen). Door minder operaties uit te voeren kan Adrz de zorg voor het toenemend aantal patiënten die besmet zijn met COVID-19 blijven voortzetten. Alle poliklinische zorg gaat nog wel […]

Online module ‘Op adem na borstkanker’ landelijk beschikbaar
oktober 27, 2020
Rotterdam – De zelfhulpmodule ‘Op adem na borstkanker’ is vanaf nu beschikbaar in de online omgeving ‘Mijn Optimale Ondersteuning bij Kanker (OOK) van Stichting OOK. De zelfhulpmodule is voor vrouwen in Nederland die de behandeling van borstkanker achter de rug hebben. De module is ontwikkeld in samenwerking met het Radboudumc, Borstkankervereniging Nederland en Karify. In […]

Specialisten ontwikkelen leefstijlprogramma om hart- en vaatziekten te voorkomen
oktober 27, 2020
Eindhoven, 26 oktober 2020 | Het Nederlandse Hart Netwerk bestaande uit huisartsenpraktijken en de vier ziekenhuizen uit de regio Zuidoost-Brabant hebben samen met de TU/e een leefstijlprogramma ontwikkeld. Met de webapp kunnen mensen met een verhoogde kans op een hartziekte hun levensstijl verbeteren. Met de data die de app oplevert, gaan wetenschappers van de TU/e […]

Interventieaanpak voor stress, schulden en roken werkt
oktober 21, 2020
Minder stress is minder roken Een interventieaanpak onder ruim 200 volwassen Rotterdammers, die in het dagelijks leven moeite hebben met rondkomen en gezondheidsklachten ervaren, laat veelbelovende resultaten zien. Deelnemers aan het programma Grip en Gezondheid ervaren aantoonbaar minder stress en nicotineafhankelijkheid. Het programma is ontwikkeld door de GGZ-instellingen Indigo Rijnmond en Avant Sanare in samenwerking […]

Promoties UvA en VU 22 oktober
oktober 20, 2020
Vrijdag 23 oktoberPromotie (VU), Aula, 09.45 uurWieke Kremer: Baarmoederhalskanker detecteren met methyleringstestUit het onderzoek van Wieke Kremer blijkt dat screening met een nieuwe test (een methyleringstest), al dan niet gecombineerd met een HPV-test, een gevoelige en specifieke manier is om voorloperstadia van baarmoederhalskanker te detecteren. Vrijdag 23 oktoberPromotie (VU), Aula, 11.45 uurAnne Dinaux: Chirurgie bij de multimodale […]

Promoties UvA en VU 22 oktober
oktober 20, 2020
Donderdag 22 oktoberPromotie (UvA), Agnietenkapel, 10.00 uurNina Steutel: Maag-darmaandoeningen bij kleine kinderenFunctionele maag-darmaandoeningen komen veel voor bij Europese zuigelingen en peuters. Dit is een van de conclusies in het proefschrift van Steutel, waarin zij ingaat op diverse aspecten van dit veelvoorkomend probleem op de kinderleeftijd. Zij onderzocht de prevalentie met gegevens van jonge kinderen uit […]

Promoties UvA en VU 21 oktober
oktober 19, 2020
Woensdag 21 oktoberPromotie (VU), Aula, 11.45 uurNatalija Bogunovic: De rol van gladde spiercellen bij aorta-aneurysma’sNatalija Bogunovic onderzocht de rol van gladde spiercellen bij de ontwikkeling van aorta-aneurysma’s (het verwijden van bloedvaten met risico op scheuren). Doel is om beter te begrijpen hoe aneurysma’s ontstaan, om zo nieuwe medicatie te ontwikkelen.Link naar proefschrift Woensdag 21 oktoberPromotie (UvA), […]

Promoties UvA en VU 20 oktober
oktober 19, 2020
Dinsdag 20 oktoberPromotie (VU), Aula, 11.45 uur Bob Berndsen: Combinatietherapie voor behandeling van kankerBob Berndsen onderzoekt optimale combinaties van doelgerichte medicijnen. Hij zag dat een combinatietherapie van Dasatinib, Erlotinib en Axitinib, bedoeld voor nierkankercellen, erg actief bleek in meerdere colorectaal-carcinoommodellen. Hiervoor is een fase 1 klinische studie ontworpen om de veiligheid van deze combinatietherapie te evalueren in […]

Psychische aandoeningen veruit de meest gemelde beroepsziekten
oktober 19, 2020
De meest gemelde beroepsziekten zijn in 2019, net als in 2018, psychische aandoeningen, zoals burnout, overspanning, depressie en posttraumatische stress stoornis. Het gaat naar schatting om 78 nieuwe gevallen per 100 duizend werknemers. Dit blijkt uit ‘Beroepsziekten in Cijfers 2020’ van het Nederlands Centrum voor Beroepsziekten (NCvB), Public and Occupational Health, Amsterdam UMC, dat vandaag […]

Deze maand is Joris Persoon het Maatje van de Maand!
oktober 19, 2020
Joris Persoon is een vrolijke jongen en heeft altijd energie voor tien! Hij woont samen met zijn vader, moeder, broertje Sjors (11) en zusje Elena (8). Joris is 13 jaar en volgt Voortgezet Speciaal Onderwijs aan de Herman Broerenschool in Naaldwijk. Hier krijgt hij in een klas met zeven andere kinderen veel begeleiding en ondersteuning, […]

Kappenbril tegen extreme lichtgevoeligheid
oktober 19, 2020
Erna Fransen heeft meerdere oogaandoeningen, waardoor er sprake is van een ernstige vorm van fotofobie. Zo is licht en reflectie van licht erg pijnlijk. Dit levert haar een reeks aan klachten op: hoofdpijn, misselijkheid, duizeligheid en in het ergste geval algehele malaise. Na haar jarenlange zoektocht naar een oplossing tegen haar lichtgevoeligheid, kwam ze in […]

Digitale coach houdt thuiszitters fit tijdens corona
oktober 19, 2020
AMSTERDAM, 19 OKTOBER 2020 – Een digitale coach moet thuiszitters fit en gezond houden tijdens de tweede coronagolf. De online buddy geeft persoonlijke begeleiding, voedingsadviezen en zet topsporter Mark Tuitert en personal celeb trainer Carlos Lens in om mensen van hun zitvlees af te krijgen. Het is een initiatief van Salland Zorgverzekeringen uit Deventer en […]

ASM 2020: From wildlife market to wild financial market
oktober 19, 2020
For a topic for the NCOH Annual Scientific Meeting 29 October 2020, only one option was possible: what lessons can, so far, be learned from the SARS-CoV-2 pandemic? Time & date: Thursday 29 October 2020, 14:00 – 17:00 h Registration: register here. The wet market in Wuhan, China, called the Huanan Seafood Wholesale Market, is believed to […]

Coronamaatregelen maken jongeren angstiger en somberder
oktober 19, 2020
Nederlandse kinderen voelen zich minder gezond en hebben vaker last van angst en somberheid door de coronamaatregelen. Dat blijkt uit onderzoek tijdens de eerste lockdown door een team onderzoekers van het Emma Kinderziekenhuis van Amsterdam UMC. Arne Popma, hoogleraar kinder- en jeugdpsychiatrie riep vandaag in het tv-programma Buitenhof op om de mentale gezondheid van de […]

ETZ stapt over op digitaal doktersrecept
oktober 15, 2020
Patiënten krijgen niet langer een doktersrecept op papier mee na een bezoek aan het ETZ (Elisabeth-TweeSteden Ziekenhuis). Recepten voor medicijnen worden voortaan digitaal naar apotheken gestuurd. “Het digitaal versturen van recepten naar apotheken biedt veel voordelen”, zegt ziekenhuisapotheker Bjorn Brassé. “Allereerst een kortere wachttijd voor de patiënt. Bovendien kunnen recepten niet meer kwijtraken en komen ze eerder […]

ETZ breidt mogelijkheden patiëntenportaal uit
oktober 14, 2020
Patiënten kunnen voortaan zelf kiezen wanneer zij de uitslag van hun onderzoek willen inzien. Het ETZ (Elisabeth-TweeSteden Ziekenhuis) biedt deze mogelijkheid aan in patiëntenportaal MijnETZ. Het ETZ geeft patiënten toegang tot hun medisch ziekenhuisdossier via patiëntenportaal MijnETZ. Daarmee wil het ziekenhuis patiënten meer betrekken bij hun behandeling in het ziekenhuis. Bijna 95.000 patiënten maken gebruik […]

Patrick van Luijk nieuwe ambassadeur van Van der Valk Vitaal!
oktober 14, 2020
Partner bij BioCheck Patrick van Luijk is vanaf heden de nieuwe ambassadeur bij Van der Valk Vitaal! De hotels Van der Valk Vitaal bieden een breed scala aan vitaliteitsdiensten voor iedereen die aan zijn of haar gezondheid wilt werken. Van der Valk Vitaal heeft verschillende locaties waar specialisten zoals psychologen, fysiotherapeuten en personal trainers klaar […]

BioCheck bereikt mijlpaal: 100.000 metingen
oktober 14, 2020
Sinds de opening van onze eerste locatie hebben we een bijzondere mijlpaal bereikt: 100.000metingen die inzicht geven in stressklachten en herstelvermogen. Daar zijn Patrick van Luijk en Stansvan der Poel natuurlijk enorm trots op! BioCheck biedt inzichten op basis van data om op een innovatieve manier mensen die kampen metklachten van (chronische) vermoeidheid, stress en […]

DA DROGIST GAAT SAMENWERKEN MET BIOCHECK
oktober 14, 2020
Check je stress en vermoeidheid online: persoonlijk advies Rotterdam, 25 september 2020 – Drogisterijketen DA gaat samenwerken met het Rotterdamseherstel- en vitaliteitscentrum BioCheck van de Rotterdamse topsprinter en voormalig Olympisch atleet Patrick van Luijk en longfunctieanalist Stans van der Poel. De drogisterijketen brengt zijn GezondheidsChecks daarmee naar een nieuw level: consumenten kunnen vanaf vandaag, de […]

Verplichting dragen mondneusmasker in Adrz
oktober 14, 2020
Vanaf dinsdag 13 oktober geldt de verplichting voor het dragen van een mondneusmaskers voor iedereen die naar een van onze Adrz locaties komt. Deze draagplicht geldt voor iedereen vanaf 13 jaar, patiënten, eventuele begeleiders, bezoekers, medewerkers en vrijwilligers. De mondneusmaskers worden gedragen in alle openbare ruimtes van het ziekenhuis en kunnen afgedaan worden bij het […]

Promoties VU- UvA 16 oktober
oktober 14, 2020
Vrijdag 16 oktober Promotie (VUmc), 11.45 uur, Aula VUAlwin Zweerink: Onderzoek naar pacemakertherapie Alwin Zweerink onderzocht Cardiale Resynchronisatietherapie (CRT), een veel toegepaste pacemakertherapie voor patiënten met hartfalen. Bij een derde van de patiënten treedt hierna geen verbetering op in benauwdheidsklachten of fysieke conditie, dit zijn de zogenaamde “non-responders”. Zweerink richt zich op twee strategieën om de […]

Promoties UV-UvA 15 oktober
oktober 14, 2020
Donderdag 15 oktoberPromotie (UvA), 10.00 u, OnlineAttila Csala: Analyseren van biomedische gegevens op moleculair niveau In het biomedisch onderzoek is het gebruikelijk om gegevens te verzamelen die biologische functies meten van een organisme. Op moleculair niveau betekent dit dat cellen en weefsels kunnen worden beschreven aan de hand van gegevens zoals het genoom. Door het […]

Promoties UvA-VU 14 oktober
oktober 14, 2020
Woensdag 14 oktober Promotie (VUmc), 15:45 uur, Aula VU Janine de Snoo-Trimp: Moreel beraad onderzocht Moreel beraad is een vorm van ethiekondersteuning waarbij zorgprofessionals met elkaar in dialoog gaan over een moreel lastige situatie. Er is een Europese vragenlijst ontwikkeld om de uitkomsten van moreel beraad in kaart te brengen. Janine de Snoo deed onderzoek naar deze […]

Promotie UvA 13 oktober
oktober 14, 2020
Dinsdag 13 oktoberPromotie (UvA), 12.00 u, AgnietenkapelTiffany Timmer: IJzerverlies bij bloeddonatie Donors verliezen met het geven van circa een halve liter bloed ongeveer 250 mg aan ijzer. Daardoor zijn zij, vooral degenen die frequent doneren, vatbaar voor ijzergebrek. Er zijn selectiecriteria om de gezondheid van donors (bijvoorbeeld ijzergebrek) en de kwaliteit van bloedproducten te waarborgen. […]

Primeur Brabantse ziekenhuizen in borstkankerchirurgie: patient gebaat bij ‘rijstkorrel’ in de tumor
oktober 14, 2020
Tilburg, 14 oktober 2020 – Als eerste ziekenhuizen hebben het Jeroen Bosch Ziekenhuis (JBZ) in Den Bosch en het Elisabeth-TweeSteden Ziekenhuis (ETZ) in Tilburg de revolutionair nieuwe lokalisatie-techniek Pintuition gebruikt bij borstsparende operaties. Door een tumor in de borst te markeren met een magnetische marker zo groot als een rijstkorrel, kunnen patiënten patiëntvriendelijker en efficiënter […]

promoties UvA-VU 12 oktober
oktober 14, 2020
Maandag 12 oktoberPromotie (UvA), 14.00 u, OnlineNoemi Vanerio: Onderzoek in vasculaire bioreactoren Vasculaire bioreactoren bestaan uit een geïsoleerd geconserveerd bloedvat (van geslachte dieren). Ze worden gebruikt om vaatziekten te onderzoeken en voor het testen van nieuwe behandelingen. Ondanks hun potentieel heeft het gebruik hiervan nog geen belangrijke plek verworven. Dit proefschrift wil het gebruik van […]

Hart & Hormonen – Fit de overgang in
oktober 13, 2020
Op Wereld Menopauzedag, 18 Oktober 2020, verschijnt Hart & Hormonen – Fit de overgang in. Waarom is het zo belangrijk om fit de overgang in te gaan en hier al rond je 40e mee te beginnen? Waar moet je op letten om gezond ouder te worden? Wat is de relatie tussen overgangsklachten en hart- en […]

Kans op beroerte aanzienlijk kleiner in Catharina Ziekenhuis door gebruik nieuwe techniek
oktober 13, 2020
Eindhoven, 13 oktober 2020 – De interventieradiologen van het Catharina Ziekenhuis hebben als eerste in Nederland een nieuwe techniek gebruikt voor het plaatsen van een stent in eenvernauwde halsslagader. “Groot voordeel van deze nieuwe techniek is dat de kans op een beroerte aanzienlijk afneemt tijdens de behandeling. Een ontwikkeling die een dotterbehandeling in dehalsslagader voor […]

Bijna 40% van de fietsers herkent oversteekgebaar witte stok niet
oktober 13, 2020
50 jaar Dag van de Witte Stok Van Nederlandse fietsers herkent bijna 40 procent het oversteekgebaar niet, wanneer iemand met een witte stok wil gaan oversteken. Een geheven stok is het signaal aan medeweggebruikers dat iemand met een visuele beperking over wil steken, hiermee als het ware een eigen zebrapad creërend. Van de jongeren herkent […]

Food Fit Focus
oktober 12, 2020
Een gezonde lifestyle zonder gedoe! Je hoeft niet vijf keer in de week naar de sportschool om er goed uit te zien. En je hoeft ook niet elke dag vegan te eten om af te vallen. Maar wat dan wel? Hoe zorg je ervoor dat je er goed uit blijft zien, dat je gezond eet, […]

Rookvrije zone leidt tot minder rokers
oktober 9, 2020
Vorig jaar wees Rotterdam als een van de eerste gemeenten in Nederland een rookvrije zone in de openbare ruimte aan. Alle organisaties gelegen binnen het gebied rondom het Erasmus MC en Hogeschool Rotterdam sloegen de handen ineen om zo actief bij te dragen aan een Rookvrije Generatie. Een jaar na dato is de pilot afgerond […]

Lancering samenwerking Bibliotheek Rotterdam en OrCam Technologies
oktober 9, 2020
Bibliotheek Rotterdam toegankelijker voor blinden en slechtzienden met behulp van artificial intelligence Rotterdam – 8 oktober 2020 – 8 oktober is het World Sight Day: de dag waarop wereldwijd aandacht wordt besteed aan vermijdbare blind-en slechtziendheid. OrCam Technologies, tech-bedrijf uit Israël, gaat vanaf heden samenwerken met de Bibliotheek Rotterdam als onderdeel van haar Europese Toegankelijkheidsproject. Theo Kemperman, directeur […]

Artrose Gezond lanceert eerste webinar op Wereld Reuma Dag
oktober 8, 2020
Online voorlichting over artrose op 12 oktober 2020Maandag 12 oktober is het Wereld Reuma Dag. Op die dag is op de website Artrose Gezond, een nieuw initiatief van Erasmus MC, het eerste webinar te volgen over de reumatische aandoening artrose. Hoogleraar ‘Artrose’ Sita Bierma – Zeinstra en huisarts Jurgen Damen beantwoorden veelgestelde vragen en leggen […]

Noordwest Ziekenhuisgroep brengt lied uit om stil te staan bij het coronavirus
oktober 7, 2020
In kader van nationale corona-bezinningsdag hebben medewerken van Noordwest Ziekenhuisgroep een lied geschreven en opgenomen. De reden is om, samen met collega’s en (ex-)patiënten, op een gepaste manier stil te staan bij de impact van het coronavirus op de samenleving. Het lied Het lied is in samenwerking met Popup Choir uitgevoerd door medewerkers van Noordwest. […]

Marcel Levi nieuwe voorzitter NWO
oktober 6, 2020
Den Haag, 6 oktober 2020 Prof.dr. Marcel Levi wordt per 1 april 2021 voorzitter van de Nederlandse Organisatie voor Wetenschappelijk Onderzoek (NWO.) Hij volgt in die functie Stan Gielen op, die met pensioen gaat. Levi is nu nog CEO van University College London Hospitals (UCLH) en hoogleraar en klinisch decaan van University College London. Minister […]

Wetenschapsagenda Amsterdam UMC 9 oktober
oktober 6, 2020
Vrijdag 9 oktoberPromotie (UvA), Agnietenkapel, 13.00 uMarieke de Roo: Betere beeldvorming bij breuk handwortelbeentjes De menselijke pols bevat acht handwortelbeentjes. Eén daarvan, het zogenoemde scafoïd, speelt een sleutelrol in de stabiliteit van het gewricht. Een scafoïd-breuk komt veel voor en als de genezing ervan mislukt, ontstaat artrose die leidt tot een ineenstorting van de botjes […]

Wetenschapsagenda Amsterdam UMC 8 oktober
oktober 6, 2020
Donderdag 8 oktoberPromotie (UvA), Agnietenkapel, 10.00 uDewi van Harskamp: Onderzoek naar aangeboren stofwisselingsziekten met tracers Tracers zijn stabiele stoffen die van nature in het lichaam voorkomen. Hiermee is het mogelijk om onderzoek te doen naar de stofwisseling in levende mensen. De tracers worden toegediend en hun aanwezigheid wordt daarna gemeten in adem, urine of bloed. […]

Wetenschapsagenda Amsterdam UMC 6 oktober
oktober 6, 2020
Dinsdag 6 oktober Promotie (VU), online, 9.45 Eveline Li: De suikerachtige moleculen van het immuunsysteem Je immuunsysteem spoort continue ziekteverwekkers op in het lichaam en ruimt deze op. Daarnaast controleert je immuunsysteem ook de gezonde cellen en ruimt deze op wanneer zij niet goed meer werken. Alle cellen zijn aan de buitenkant versierd met een code van […]

Wetenschapsagenda Amsterdam UMC 5 oktober
oktober 6, 2020
Maandag 5 oktoberPromotie (VU), Aula, 11.45 uurDinja Kruger: Behandeling op maat bij hormoongevoelige borstkanker Kruger doet onderzoek naar hormoongevoelige borstkanker. Steeds meer vrouwen overleven de ziekte door een aanvullende behandeling met medicijnen afgestemd op het type borstkanker. Vrouwen met hormoongevoelige borstkanker kunnen bijvoorbeeld behandeld worden met hormoontherapie. Desondanks heeft niet elke vrouw een betere kans […]

Noordwest Ziekenhuisgroep neemt deel aan onderzoek effect tuberculose-vaccin tegen gevolgen coronavirus bij kwetsbare ouderen
oktober 2, 2020
In Nederland is een grote studie gestart in 23 ziekenhuizen, waaronder alle UMC’s en de Santeon topklinische ziekenhuizen, die gaat onderzoeken of het vaccin tegen tuberculose (het BCG-vaccin) bescherming biedt tegen de gevolgen van een infectie met het coronavirus bij kwetsbare ouderen. Noordwest Ziekenhuisgroep is één van de deelnemende ziekenhuizen aan de studie, die wordt gecoördineerd […]

Maasstad Ziekenhuis breidt Intensive Care uit
oktober 2, 2020
De capaciteit van de Intensive Care (IC) afdeling van het Maasstad Ziekenhuis is uitgebreid naar 27 bedden. De afgelopen twee maanden is de IC grondig verbouwd om zo extra IC-bedden te creëren voor coronapatiënten. Daarnaast is er intern een opleiding gestart om verpleegkundigen van andere afdelingen op te leiden tot IC-assisterend verpleegkundigen/ondersteuners als het nodig […]

Adrz ondersteunt landelijk advies mondkapjes
oktober 2, 2020
Vanaf morgen, vrijdag 2 oktober 2020, vraagt Adrz alle patiënten en eventuele begeleiders die één van de locaties bezoeken een mondkapje te dragen in de publieke ruimtes én als 1,5 meter afstand houden niet mogelijk is. Het ziekenhuis volgt hiermee het landelijke advies van de overheid. Onder publieke ruimtes vallen gangen, trappenhuizen, wachtkamers en de […]

Rotterdam pakt door in de strijd tegen eenzaamheid
oktober 1, 2020
Rotterdam pakt door in de strijd tegen eenzaamheid. De gemeente slaat samen met tientallen welzijnsinstanties de handen ineen om succesvolle maatschappelijke initiatieven, waaronder de sociale hulpdienst corona, te behouden en waar mogelijk uit te breiden. “Juist nu is het belangrijk om extra naar elkaar om te kijken en te doen wat nodig is voor onze ouderen […]

HART & HORMONEN
september 30, 2020
Fit de overgang in Waarom is het zo belangrijk om fit de overgang in te gaan en hier al rond je 40e mee te beginnen? Waar moet je op letten om gezond ouder te worden? Wat is de relatie tussen overgangsklachten en hart- en vaatziekten? Wat zijn je risicofactoren en hoe verander je ze? Waarom […]

PostNL en gemeente Rotterdam samen tegen eenzaamheid
september 30, 2020
Aftrap Week tegen Eenzaamheid PostNL is in samenwerking met de gemeente Rotterdam een pilot gestart voor het melden van eenzaamheid in de Rotterdamse wijk Schiebroek-Hillegersberg. 15 speciaal geïnstrueerde pakketbezorgers van PostNL kunnen vanaf nu op vrijwillige basis melding maken wanneer zij tijdens hun bezorgronde eenzame Rotterdammers signaleren. Melding maken is mogelijk via een sms of […]

Chemotherapie buitenspel bij teruggekeerde leukemie
september 29, 2020
Een nieuw medicijn zet chemotherapie definitief buitenspel bij leukemiepatiënten bij wie de kanker is teruggekeerd. Dat het middel succesvol is, bleek al twee jaar geleden. Nu is het bewijs geleverd dat Venetoclax ook op een langere termijn van vier jaar veel beter scoort dan de chemotherapie die tot nu toe werd gegeven.Als gevolg van dit […]

Promoties VU 2 oktober
september 29, 2020
Vrijdag 2 oktober, 09:45 (Aula, VU)Promotie Sanne van Woerden Hillige (Locatie: VU) Lastige jongens, lastige keuzesHet proefschrift van Sanne Hillige richt zich op jongeren in een Justitiële Jeugdinstelling. Jongeren die hier verblijven, zijn erg verschillend qua achtergrond, levensverhaal, persoonlijkheid en krachten. Wel kennen ze één overeenkomst: complexe problemen op meerdere vlakken. We weten dat behandeling bij […]

Promoties VU 1 oktober
september 29, 2020
Donderdag 1 oktober, 13:45 (Aula, VU)Promotie Myron Best (Locatie: VU) Vroegtijdig kanker ontdekken in druppel bloedMyron Best onderzocht het ontdekken van kanker via bloed, zogenaamde ‘liquid biopsies’. Bloedplaatjes zijn celfragmenten in het bloed die betrokken zijn bij het stollingsproces en de aanzet geven tot wondgenezing. Recent is ontdekt dat bloedplaatjes een rol spelen bij de progressie […]

Promoties VU 30 september
september 29, 2020
Woensdag september, 10:00 (Agnietenkapel)Promotie Abigail Beane (Locatie: UVA) Organisatie van zorg in landen met lage en midden inkomensSlechte kwaliteit van de zorg is wereldwijd een belangrijke oorzaak van overmatige sterfte. Het kopiëren van de manier waarop de zorg is georganiseerd in landen met een hoog inkomen, werkt niet goed in landen waar de middelen minder toereikend […]

Promoties VU 29 september
september 29, 2020
Dinsdag 29 september, 15:00 (Agnietenkapel)Promotie Robin Detering (Locatie: UVA) Trends in de behandeling van kanker aan rectum Detering heeft gekeken of er over de tijd en per ziekenhuis trends zijn in de behandeling en zorg aan patiënten met kanker aan het rectum, het laatste deel van de dikke darm. Hij constateert dat per ziekenhuis de behandeling […]

Promoties VU 28 september
september 29, 2020
Maandag 28 september, 13:45 (Aula VU)Promotie Tim Moors (Locatie: VUmc) Bepaalde eiwitvarianten sterk verhoogd bij Parkinson De ziekte van Parkinson is een slopende en momenteel ongeneeslijke neurologische ziekte. Voor de ontwikkeling van medicijnen om deze ziekte stoppen of afremmen is een betere kennis nodig van onderliggende mechanismen. Een belangrijk kenmerk van de ziekte van Parkinson […]

Mooier en sneller herstel na zwaar oogtrauma nu mogelijk in Rotterdam.
september 28, 2020
Het Oogziekenhuis Rotterdam implanteert als eerste ziekenhuis in Nederland een nieuwe type iris-kunstlensprothese. Het Oogziekenhuis Rotterdam heeft vandaag als eerste ziekenhuis in Nederland succesvol een ‘reper irisprothese met geïntegreerde intraouclaire lens’ geïmplanteerd. Deze prothese vervangt in één keer zowel de iris als de ooglens. De iris regelt de hoeveelheid licht die in het oog terechtkomt. […]

Rotterdams MKB gaat digitaal de crisis te te lijf
september 28, 2020
Gemeente start betaalbaar trainingsaanbod voor online ondernemerschap Van winkeliers tot kappers, van sportschoolhouders tot horecaondernemers: Rotterdamse MKB’ers kunnen vanaf 29 september trainingen volgen om hun bedrijf ook online een extra impuls te geven. De gemeente Rotterdam biedt samen met marketingplatform Frankwatching betaalbare trainingen aan om ondernemers te stimuleren hun digitale vaardigheden uit te breiden. Door […]

Rotterdamse start-up BioCheck gaat samenwerken met DA drogist
september 25, 2020
Rotterdam, 25 september 2020 – Drogisterijketen DA gaat samenwerken met het Rotterdamse herstel- en vitaliteitscentrum BioCheck van de Rotterdamse topsprinter en voormalig Olympisch atleet Patrick van Luijk en longfunctieanalist Stans van der Poel. De drogisterijketen brengt zijn GezondheidsChecks daarmee naar een nieuw level: consumenten kunnen vanaf vandaag, de Dag van de Vitaliteit – met behulp […]

Mooier en sneller herstel na zwaar oogtrauma nu mogelijk in Rotterdam
september 25, 2020
Rotterdam 25 september 2020 – Het Oogziekenhuis Rotterdam heeft vandaag als eerste ziekenhuis in Nederland succesvol een ‘REPER irisprothese met geïntegreerde intraoculaire lens’ geïmplanteerd. Deze prothese vervangt in één keer zowel de iris als de ooglens.De iris regelt de hoeveelheid licht die in het oog terechtkomt. Patiënten met een beschadigde iris door oogtrauma of met […]

Zeeuwse ziekenhuizen doen het goed
september 25, 2020
De Zeeuwse ziekenhuizen Adrz en ZorgSaam scoren met de Hospital Standardised Mortality Ratio (HSMR) over 2019 beide lager dan het landelijk gemiddelde van 100. Een score van 80 voor Adrz en 98 voor ZorgSaam geeft aan dat de ziekenhuizen de kwaliteit van zorg goed op orde hebben. Een mooie opsteker voor de regio en een goed […]

Welbevinden van verpleeghuisbewoners lijkt niet aangetast door lockdown.
september 25, 2020
De sluiting van de verpleeghuizen dit voorjaar heeft geen negatieve gevolgen gehad op stemming, cognitie en dagelijks functioneren van de bewoners. Zo ervaarden bewoners tijdens de lockdown niet meer depressieve gevoelens of angst dan een vergelijkbare groep bewoners in dezelfde periode een jaar eerder. Het aantal conflicten op de afdelingen en de hoeveelheid voorgeschreven rustgevende […]

Suiker groeimotor voor kanker
september 24, 2020
AMSTERDAM, 23 SEPTEMBER 2020 – Het alledaagse voedingsingrediënt suiker blijkt van grote invloed bij het ontstaan, genezen en voorkomen van kanker. Eén blikje frisdrank of glas vruchtensap per dag verhoogt het risico op kanker, met name borstkanker. Deze conclusie trekt de Nederlandse medicus William Cortvriendt in zijn nieuwe boek Kankervrij op basis van recente wetenschappelijke […]

Bypassoperatie zonder open borstkas
september 24, 2020
AMT Medical ontvangt 10 miljoen euro om ELANA™-innovatie op de markt te zetten. Ede, Nederland, 23 September 2020 – Het bedrijf Advanced Medical Technologies (AMT) ontvangt 10 miljoen euro van regionaal ontwikkelfonds Oost NL, NextGen Ventures, Utrecht Holdings en aan subsidies om de nieuwe ELANA HEART-technologie verder te ontwikkelen. Met deze technologie is het niet […]

Aftrap proeftuinen Gezond Gewicht
september 23, 2020
Rotterdam koploper in nieuwe landelijke aanpak overgewicht In bijzijn van staatssecretaris Paul Blokhuis, wethouder Sven de Langen en PON-voorzitter Liesbeth van Rossum (hoogleraar en internist Erasmus MC) is gisteren het startsein gegeven voor twee nieuwe proeftuinen Gezond Gewicht in de Rotterdamse wijken Beverwaard en Oude Westen/Delfshaven. De proeftuinen vormen een effectieve ketenaanpak die Rotterdammers met […]

Cultuurplan 2021-2024: meer cultuur voor Rotterdammers
september 22, 2020
In het gloednieuwe Theater Zuidplein presenteerde wethouder Said Kasmi (Onderwijs, Cultuur & Toerisme) vanmiddag het Cultuurplan 2021-2024. In grote lijnen neemt het college het advies van de Rotterdamse Raad voor Kunst en Cultuur over. In de komende vier jaar krijgen 94 culturele instellingen subsidie. Twintig instellingen zijn nieuw op de lijst en veertien groeien door. […]

CETA: Mogelijk toch verboden hormoonvlees op de Europese markt.
september 22, 2020
Uit een audit door voedseldeskundigen van de Europese Commissie blijkt dat het risico op de import van verboden hormoonvlees uit Canada aanzienlijk is. De bewering van de Nederlandse overheid en de Europese Commissie dat het vrijhandelsverdrag CETA en de daaruit voortvloeiende verhoogde import van vlees uit Canada niet zal leiden tot hormoonvlees is niet gebaseerd […]

Aftrap Social Trial Rotterdam
september 22, 2020
Doen wat nodig is voor mensen met dementie. Dat gebeurt vandaag op Wereld Alzheimer Dag en dat is ook het vertrekpunt van de Social Trial Rotterdam. Een experimentele methodiek voor het verbeteren van de kwaliteit van leven van mensen met dementie en hun naasten. Afgelopen weekend vond in bijzijn van wethouder Sven de Langen (Volksgezondheid, […]

Wetenschapskalender Amsterdam UMC 21-25 september
september 22, 2020
Maandag 21 septemberPromotie (VU), Aula, 13.45 uurJessica van der Zande: Patiënten met Lewy body dementie Van der Zande deed aanvullend onderzoek bij dementie met Lewy bodies. Dementie met Lewy bodies wordt gekenmerkt door visuele hallucinaties, wisselende aandacht, slaapstoornissen en problemen met bewegen. De diagnose is tijdens het leven moeilijk te stellen door de variatie in […]

ReumaNederland en VoedingLeeft ontwikkelen leefstijlbehandeling voor reuma
september 16, 2020
In Nederland is er nog steeds te weinig aandacht voor leefstijlprogramma’s voor chronisch zieken, terwijl internationaal steeds meer duidelijk wordt dat het aanpassen van de levensstijl van de chronisch zieke een positief effect kan hebben op de ziektelast hiervan. De komende maanden wordt het programma door ReumaNederland en VoedingLeeft samen met ervaringsdeskundigen, onderzoekers en zorgverleners […]

Rotterdam investeert in sportcentrum met zwembad en 100 woningen op Zuid
september 16, 2020
Sporten, ontmoeten en wonen onder één dak in ‘Huis op Zuid’ Rotterdam investeert in een groot sport– en zwemcentrum op Zuid. De kosten voor dit ‘Huis op Zuid’ aan de Laan op Zuid en de Brede Hilleweg bedragen 33 miljoen euro. De bouw moet in 2021 beginnen en in 2022 klaar zijn. Naast het sportcentrum […]

Promoties UMC 18 September
september 15, 2020
Vrijdag 18 september, 11.00 uurPromotie Merle Stellingwerf (locatie AMC)Blindedarmverwijdering helpt bij chronische darmontstekingHet verwijderen van de blindedarm vermindert het aantal keren dat artsen de dikke darm moeten weghalen met 84 procent. Bijna de helft van patiënten met een chronische darmontsteking colitis ulcurosa (CU) melden een verbetering na deze ingreep. Een kwart van deze patiënten was […]

Promoties UMC 17 september
september 15, 2020
Donderdag 17 september, 13.00 uur (Agnietenkapel)Promotie Patricia van Velzen (locatie AMC) Antibiotica verlengen periodes tussen longaanvallen bij COPD nietChronische obstructieve longziekte (COPD) is een veel voorkomende ziekte die wordt gekenmerkt door klachten van de luchtwegen en een onomkeerbare verstoring van de luchtstroom. De meeste patiënten met COPD ervaren af en toe exacerbaties: een tijdelijke verergering van […]

Promotie UMC 16 September
september 15, 2020
Woensdag 16 september, 13.00 u (Agnietenkapel)Promotie Marjolein van den Boogert (locatie AMC)Genen oorzaak van afwijkingen in cholesterolIn grote genetische studies is een relatie gevonden tussen varianten in genen die coderen voor enzymen in de eiwit glycosylering en cholesterolstoornissen en hart- en vaatziekten. In dit proefschrift heeft Van den Boogert de cholesterolhuishouding van patiënten met congenitale […]

Promoties UMC 14 September
september 15, 2020
Maandag 14 september, 11.45 uur (Aula VU)Promotie Arjen Smits (locatie VUmc)Oorzaken en behandeling van ruggenwervel breukenEen ruggenwervelbreuk is een ernstig letsel dat verregaande gevolgen kan hebben, de oorzaak is meestal ernstig ongeval. Het is niet bekend hoe vaak in Nederland een ruggenwervelbreuk precies voorkomt, bij wie en door welke oorzaak. Promovendus Arjen Smits wilde meer […]

Kinderen veiliger naar school door nieuw verkeers experiment in Bloemhof
september 15, 2020
Rotterdam wil het verkeer rondom basisscholen in de stad veiliger maken en startte gisteren met het experiment Veilige Schoolomgeving bij de Theresiaschool in Bloemhof. Hier wordt tijdelijk de snelheid voor auto’s verlaagd van 50 naar 30 km/h en wordt het oversteken voor kinderen makkelijker en veiliger gemaakt. Deze nieuwe verkeerssituatie wordt voor vier maanden getest. […]

Kortdurend beschermd tegen volgende coronavirus-infectie
september 15, 2020
Eén jaar na een coronavirus-infectie en misschien eerder, kunnen mensen opnieuw besmet raken met hetzelfde virus. Waarschijnlijk geldt dit ook voor het nieuwe coronavirus SARS-CoV-2. Dit concluderen onderzoekers van Amsterdam UMC in een artikel dat vandaag gepubliceerd is in het wetenschappelijke tijdschrift Nature Medicine. Wetenschappers van Amsterdam UMC onderzochten hoelang het duurt voordat iemand opnieuw besmet […]

Boek lancering ‘Overleven als ondernemer’
september 14, 2020
Op zaterdag 26 september vindt de officiële boekpresentatie in Rotterdam plaats van Overleven als ondernemer – Worstelingen van een vrouwelijke ondernemer van Noëlla de Jager. Het nu al door lokale vakgenoten bejubelde boek reikt (startende) ondernemers 138 pagina’s aan ervaring die De Jager in 10 jaar, als eigenaar van de eerst opgerichte Rotterdamse flexwerkplek voor vrouwelijke professionals, heeft opgedaan. Daarbij […]

Survey results: impact and response to the COVID-19 crisis in the European Life Sciences sector
september 14, 2020
20th of May 2020, Utrecht – This month ttopstart has interviewed 50 European life sciences companies on how they are impacted by and have responded to the COVID-19 crisis. In the report the results are discussed and translated into recommendations. Jasper Levink, director of ttopstart: “Whereas some life sciences companies seem to benefit from the pandemic, many […]

Stichting Lezen en Schrijven lanceert nieuwe campagne
september 11, 2020
Stichting Lezen en Schrijven lanceert op 7 september de Wereldwijde Dag van de Alfabetisering haar nieuwste campagne ‘Een van deze mensen…’. De organisatie doet dat tijdens de jaarlijkse ‘Week van Lezen en Schrijven’ die op 7 september begint. Met deze campagne richt de stichting zich op het herkennen van signalen van laaggeletterdheid. In Nederland hebben […]

9de Jaarcongres: ‘De Week van Arts en Leefstijl’.
september 11, 2020
Een spectaculair virtueel event dat op maandagavond 21 september om 20.00 uur wordt geopend door staatssecretaris Paul Blokhuis. Met een verscheidenheid aan onderwerpen en sprekers waaronder Erik Scherder, Pim Assendelft, Liesbeth van Rossum, Carina Hilders, Bas van de Goor en Marian Kaljouw. Daarnaast zijn er netwerkbijeenkomsten, ronde tafel gesprekken, posterpresentaties en een Virtueel Leefstijlplein waar bedrijven en organisaties op het gebied van […]

Messi tech-ambassadeur voor blinden en slechtzienden
september 10, 2020
Lionel Messi is de nieuwe ambassadeur van OrCam Technologies en gaat zich wereldwijd inzetten om de levens van blinden en slechtzienden toegankelijker te maken met behulp van technologie gebaseerd op Artificial Intelligence. Rotterdam – 9 september 2020 – OrCam Technologies, de leider in Artificial Intelligence wearables voor blinden en slechtzienden heeft vandaag aangekondigd dat Lionel Messi, […]

Sociale basisinfrastructuur
september 10, 2020
Bewoners willen steeds vaker zelf een bijdrage leveren aan gezondheid in hun buurt, dorp of wijk. In veel wijken zijn buurtinitiatieven, sociaal ondernemers, professionals, gemeenten en zorgverzekeraars al bezig met het organiseren ‘van onderop’, iedereen vanuit zijn eigen perspectief. Afgelopen maanden is onder andere door GezondNL, Dialoog Gemeenschapskracht en diverse partners gewerkt aan de vraag: ‘hoe kunnen […]

Stichting Lezen en Schrijven lanceert nieuwe campagne
september 7, 2020
Stichting Lezen en Schrijven lanceert morgen op de Wereldwijde Dag van de Alfabetisering haar nieuwste campagne ‘Een van deze mensen…’. De organisatie doet dat tijdens de jaarlijkse ‘Week van Lezen en Schrijven’ die vandaag begint. Met deze campagne richt de stichting zich op het herkennen van signalen van laaggeletterdheid. In Nederland hebben 2,5 miljoen mensen […]

Eeuwenoud medicijn verlaagt kans op nieuwe hart- of vaatziekte bij hartpatiënten met 30%
september 4, 2020
Een ontstekingsremmend medicijn dat al eeuwen wordt gebruikt voor jicht, blijkt hart- en vaatziekten te voorkomen bij patiënten die ooit een hartinfarct hebben gehad of last hebben van vernauwde kransslagaders. Een lage dosis van het medicijn Colchicine verlaagt de kans hierop met 30%. Deze veelbelovende ontdekking presenteren de LoDoCo2 onderzoekers afgelopen maandag op het (virtuele) […]

Staatssecretaris Blokhuis: vooralsnog geen suikertaks
september 4, 2020
Ondanks positief onderzoek naar suikertaks, wint de industrie Staatssecretaris van Volksgezondheid, Paul Blokhuis, heeft de Tweede Kamer in een brief laten weten dat er voorlopig geen suikertaks komt in Nederland. Dit concludeert Blokhuis na de resultaten van het onderzoek dat hij naar een suikertaks heeft laten uitvoeren. Elif Stepman, campagneleider bij voedselwaakhond foodwatch: “Een bizarre conclusie, aangezien het […]

Bij nieuwe corona-uitbraak in verpleeghuis is snelle diagnose essentieel
september 2, 2020
“Het is zeer onwenselijk als verpleeghuizen bij een nieuwe coronagolf opnieuw de deuren moeten sluiten”, zeggen hoogleraar Acute Ouderenzorg Bianca Buurman en hoogleraar ouderengeneeskunde Cees Hertogh van Amsterdam UMC. Zij deden de afgelopen maanden onderzoek in diverse verpleeghuizen om erachter te komen wat aan een uitbraak voorafging en hoe het kon gebeuren dat zoveel verpleeghuisbewoners […]

Start nomineren voor Rotterdamse Kinderrechten Award
september 2, 2020
Vanaf 2 september t/m 9 oktober 2020 kan iedereen weer mensen en organisaties nomineren die vrijwillig goede dingen doen voor kinderen in de gebieden van Rotterdam. Genomineerden maken dan kans op de Rotterdamse Kinderrechten Award. Deze prijs wordt door de gemeente Rotterdam uitgereikt aan het begin van de Week Tegen Kindermishandeling in november. Met het […]

Kick Off proeftuin gezond gewicht
augustus 31, 2020
Het Partnerschap Overgewicht Nederland (PON) en de Gemeente Rotterdam werken samen met verschillende partners aan de ontwikkeling van een ketenaanpak Gezond Gewicht voor volwassenen. Het doel van deze aanpak is dat volwassenen met overgewicht/obesitas doelmatig en effectief worden begeleid naar passend ondersteuningsaanbod of zorg. In Rotterdam wordt in de proeftuin Gezond Gewicht in verschillende wijken aan […]

Corona nu en straks
augustus 31, 2020
Online wetenschapsfestival – 10 september – 15.30 – 16.30 Drie wetenschappers van Amsterdam UMC kijken terug én vooruit in tijden van corona. Tijdens de online versie van het jaarlijkse Wetenschapsfestival bespreken ze de ontwikkelingen in coronawetenschap. Hoe hebben ‘we’ het tot nu toe gedaan en wat hebben we al geleerd over covid-19? Welke onderzoeken lopen […]

Uitnodiging – Medical Delta Café
augustus 28, 2020
Het is ons een groot genoegen u uit te nodigen voor het Medical Delta Café op 8 oktober aanstaande. Veiligheidsvoorschriften voor medische- en gezondheidsinnovaties maken dat het soms jaren duurt voordat een innovatieve oplossing de zorgmarkt betreedt. De coronagolf in het voorjaar liet zien dat die tijd er soms niet is. E-Health toepassingen werden versneld […]

Uitnodiging – Medical Delta Café
augustus 28, 2020
Het is ons een groot genoegen u uit te nodigen voor het Medical Delta Café op 8 oktober aanstaande. Veiligheidsvoorschriften voor medische- en gezondheidsinnovaties maken dat het soms jaren duurt voordat een innovatieve oplossing de zorgmarkt betreedt. De coronagolf in het voorjaar liet zien dat die tijd er soms niet is. E-Health toepassingen werden versneld […]

SpotR geeft Rotterdammers ruimte
augustus 27, 2020
Druktemeter van gemeente Rotterdam gaat testfase in De gemeente Rotterdam heeft de testversie van druktemeter SpotR gereed waarmee bewoners en bezoekers live kunnen zien hoe rustig of druk het is op openbare plekken in en rond de stad. Met SpotR kunnen mensen ondanks de huidige afstandsmaatregelen op een veilige manier winkelen, een terrasje pakken of boodschappen doen. […]

[Virtueel] LSH010 ontbijt: donderdag 10 december 2020
augustus 26, 2020
Vanwege de lopende COVID-19 pandemie vindt dit ontbijt online plaats. Het LSH010 Ontbijt stimuleert innovatie en samenwerking in de Rotterdamse life sciences & health-sector. De netwerkbijeenkomst vindt tenminste vier keer per jaar plaats in de Life Sciences & Health Hub in de Rotterdam Science Tower. De presentatie van een succesvolle case, vooraf te initiëren een-op-een-ontmoetingen […]

[Virtueel] LSH010 Ontbijt: donderdag 24 september 2020
augustus 26, 2020
Vanwege de lopende COVID-19 pandemie vindt dit ontbijt online plaats. LSH010 ontbijt: donderdag 24 september 2020 Het LSH010 Ontbijt stimuleert innovatie en samenwerking in de Rotterdamse life sciences & health-sector. De netwerkbijeenkomst vindt tenminste vier keer per jaar plaats. De presentatie van een succesvolle case, vooraf te initiëren een-op-een-ontmoetingen én een lekker en gezond ontbijt […]

Documentaire ‘Positief getest’: het ETZ in de coronacrisis
augustus 25, 2020
Première op 1 september in Euroscoop Tilburg De coronacrisis in Nederland startte op 27 februari met de eerst bewezen patiënt met covid-19 in het ETZ (Elisabeth-TweeSteden Ziekenhuis) in Tilburg. Op dinsdag 1 september gaat de 45 minuten durende documentaire in première die hierover werd gemaakt: ‘Positief getest’. Dat gebeurt om 19.30 uur in bioscoop Euroscoop […]

Onthullend rapport: Wetenschappers voor de kar van suikerindustrie
augustus 19, 2020
Wetenschappers en suikerindustrie onvoldoende transparant Uit nieuw onderzoek van foodwatch blijkt dat de Nederlandse suikerindustrie via het Kenniscentrum Suiker en Voeding (KSV) in grote lijnen dezelfde strategieën als ‘Big Tobacco’ gebruikt om de wetenschap te beïnvloeden.Negen Nederlandse wetenschappers hebben sterke banden met KSV.Alle negen wetenschappers doen publiekelijk uitingen in lijn met de belangen van de suikerindustrie: […]

Antistoffen tegen coronavirus in moedermelk
augustus 19, 2020
De moedermelk van vrouwen die een COVID-19 infectie hebben doorgemaakt, bevat antistoffen tegen het coronavirus. Dat blijkt uit onderzoek van het Emma Kinderziekenhuis van Amsterdam UMC in samenwerking met andere instituten*. De onderzoekers vertelden hierover in het tv-programma Jinek op 18 augustus. Ze gaan nu uitzoeken of de melk bruikbaar is om coronabesmettingen te voorkomen, […]

Rotterdam maakt werk van vitale en toekomstbestendige speeltuinen
augustus 13, 2020
Zo’n 56 Rotterdamse speeltuinen wordt de komende periode nieuw leven ingeblazen. Waar speeltuinverenigingen voorheen een vanzelfsprekende en sterke positie hadden in de wijk, neemt het aantal vitale speeltuinen steeds verder af. Zij hebben veelal geen vrijwilligers meer, geen bestuur en de hekken zijn vaker dicht dan open. “Dat moet anders!” zegt wethouder Sven de Langen […]

Eerste ombudsvrouw van Nederland wordt 100 jaar
augustus 12, 2020
De eerste ombudsvrouw van Nederland, Meta van Beek is gisteren 100 jaar geworden. Dit werd gisterochtend gevierd bij haar woning in Deventer. Meta ontving de felicitaties van burgemeester Ron König via een ingesproken bericht op haar Webbox, een audio-hulpmiddel voor blinden en slechtzienden. Als eerste ombudsvrouw behartigde Meta in de jaren ‘70 de belangen van […]

Europese COVID-19 richtlijn veilige en hygiënische uitbating fitnesscentra
augustus 11, 2020
Op Europees niveau wordt gestemd over het opstellen van een richtlijn voor het veilig beheren van fitnesscentra tijdens een besmettelijke uitbraak zoals COVID-19. NEN vraagt belanghebbende partijen om vóór 15 september aanstaande hun interesse in de ontwikkeling van een dergelijke richtlijn kenbaar te maken. Gedurende de eerste maanden van de COVID-19-pandemie werd op laste van […]

Waarom wandelen zo gezond voor je is
augustus 7, 2020
Ga deze zomer lekker veel wandelen! Zoek de natuur op en trek er op uit voor een fijne wandeling – het is namelijk heel goed voor je. Regelmatig wandelen kan het risico op sterfte door hartziekte verkleinen. Ook kan wandelen stress en angst helpen verminderen. In deze blog leggen we je uit hoe wandelen bijdraagt […]

Bart van de Leemput nieuwe voorzitter raad van toezicht Maasstad Ziekenhuis
augustus 5, 2020
De raad van toezicht van het Maasstad Ziekenhuis heeft met ingang van 3 augustus een nieuwe voorzitter. De heer dr. L.E.C. van de Leemput heeft het voorzitterschap overgenomen van mevrouw prof. dr. J.P. Bahlmann, die op 2 juli afscheid nam van het Maasstad Ziekenhuis. Bart van de Leemput heeft een uitgebreide staat van dienst als […]

Een afspraak bij Adrz?
juli 24, 2020
Check eerst zelf uw risico op eventuele besmetting met het coronavirus (COVID-19) Vanaf 27 juli 2020 vraagt Adrz iedereen die van plan is naar een van de Adrz locaties te komen, voorafgaand aan het bezoek, zelf na te gaan of er een eventueel risico is op besmetting met het coronavirus (COVID-19). We verwijzen daarbij naar adrz.nl/coronacheck. […]

ReumaNederland en Voeding Leeft ontwikkelen leefstijlprogramma voor reuma
juli 21, 2020
Meerjarige samenwerking voor het ontwikkelen van een effectieve leefstijlbehandeling voor reuma Samen met Voeding Leeft werkt ReumaNederland aan een leefstijlbehandeling voor meer dan 2 miljoen mensen met een reumatische aandoening in Nederland. Momenteel is er namelijk nog te weinig aandacht voor leefstijlbehandelingen voor chronisch zieken, terwijl het op internationaal niveau blijkt dat het aanpassen van […]

Gemeente Rotterdam pakt door met digitale zorg na Corona
juli 17, 2020
De opmars van eHealth in Coronatijd is enorm en dat biedt kansen, zo stelt de gemeente Rotterdam. Daarom tekenden tientallen Rotterdamse zorgaanbieders vandaag samen met zorgwethouder Sven de Langen online de DigiDeal010. Een digitaal akkoord waarin alle ondertekenaars met elkaar afspreken zich in te spannen voor een kwalitatieve uitbreiding van het digitale zorgaanbod in de stad. “Het […]

School: dé oefenplaats voor burgerschap
juli 16, 2020
Alle onderwijssectoren in Rotterdam, van voorschool tot en met hoger onderwijs, hebben gezamenlijk heldere afspraken gemaakt over burgerschap in het manifest ‘Scholen: veilige oefenplaats voor burgerschap’. Met als doel zelfverzekerde leerlingen die zich thuis voelen op school en op een constructieve manier meedoen in de maatschappij. Leraren en leerlingen zeggen met het manifest dat zij […]

Ademhalen: grotere rol voor kleine hersenen
juli 14, 2020
Van de eerste schreeuw tot de laatste zucht, ademhalen doen we ons leven lang en bijna altijd zonder daarover na te denken. Onderzoek bij muizen toont aan dat de kleine hersenen een grotere rol spelen bij de ademhaling dan neurowetenschappers tot nu toe dachten. Waar hebben onze hersenen het zo druk mee? “Onze ademhaling moet […]

Tweede selectieronde ZorgTech vouchers start na zomer
juli 14, 2020
De tweede selectieronde ZorgTech vouchers start na de zomer. Projectconsortia die technologische oplossingen willen realiseren voor de gezondheidszorg, kunnen uiterlijk 22 september een aanvraag indienen. Afhankelijk van de financieringsbehoefte is er naar verwachting ruimte voor nog zo’n vier projecten. De vouchers voorzien in het toetsen van de haalbaarheid zorginnovaties of het testen van oplossingen in […]

Ziekenhuizen laten het afgelopen jaar wederom stabiele positieve financiële ontwikkeling zien
juli 14, 2020
De financiële positie van ziekenhuizen laat ook in 2019 een verbetering zien. Het is echter de vraag of het voldoende is om de financiële consequenties van COVID-19 op te vangen. De gemiddelde solvabiliteit laat wederom een stijging zien en bedraagt nu bijna 30% (29,8%). Tevens is de liquiditeitspositie verbeterd. Het totaal aan liquide middelen is […]

Solán de Cabras steunt Pink Ribbon met roze fles
juli 10, 2020
Spaans mineraalwater krijgt een zusje Het bekende Spaanse merk Solán de Cabras verwisselt tijdelijk haar iconische blauwe fles voor een roze om Pink Ribbon te steunen. Van iedere verkochte fles stort de importeur 14 eurocent bijdrage aan de organisatie die onderzoek naar borstkanker ondersteunt. Het merk is van nature begaan met onze dagelijkse gezondheid. Het water heeft […]

Upstream Festival | 21-27 September
juli 10, 2020
Upstream – Connecting Change Makers From September 21st to September 27th, Rotterdam will transform into the stage of Upstream. From workshops and keynotes to carefully curated matchmaking events: if you consider yourself a change-maker, this is where you need to be. Sign up now! Founders, graduates, investors and corporate innovators come together to drive the […]

Een bril op maat voor afwijkende gezichtsvormen
juli 9, 2020
Bij een afwijkende gezichts- /schedelvorm, kan het lastig zijn om de juiste bril te vinden. De reguliere monturen gaan allemaal uit van gemiddelde gezichtsafmetingen. Maar ook bij mensen met een (ernstige) verstandelijke beperking kan de 3D geprinte bril een oplossing zijn. Het passen van een bril bij de reguliere opticien is meestal geen optie. Een […]

Kinderen van 4-8 jaar overschrijden nu al hun jaarlijkse suikerlimiet
juli 8, 2020
Foodwatch eist strengere aanpak kindermarketing en suikerbommen Woensdag 8 juli is de eerste ‘suikermaxdag’ van 2020: voor kinderen in de leeftijd van 4 tot 8 jaar. Kleine kinderen hebben nu al hun maximale jaarhoeveelheid suikers bereikt, gebaseerd op het advies van de Wereldgezondheidsorganisatie. Als het percentage overgewicht bij kinderen naar beneden moet, zal ook de suikerconsumptie […]

Extra lange editie Jeugdvakantieland
juli 8, 2020
Jeugdvakantieland gaat door deze zomer. Om alle Rotterdamse kinderen een zomervakantie vol fun, sport, spel en educatie te bieden duurt deze editie 4 weken in plaats van 2 weken. Van 3 tot en met 28 augustus zijn kinderen van 2 tot en met 12 jaar welkom in Rotterdam Ahoy. Na een lange periode waarin evenementen […]

Omniyou DNA kits: persoonlijk advies voor een gezonder leven
juli 7, 2020
Met de Omniyou DNA-checks van biotechnologie bedrijf Omnigen kun je jouw DNA laten analyseren voor een persoonlijk advies over voeding en sport. Deze analyses geven jou inzicht in je lichaam en kunnen je vertellen over wat het beste voor jou werkt wanneer je gezonder wilt gaan eten, meer wilt bewegen of beter wilt presteren. Hoe […]